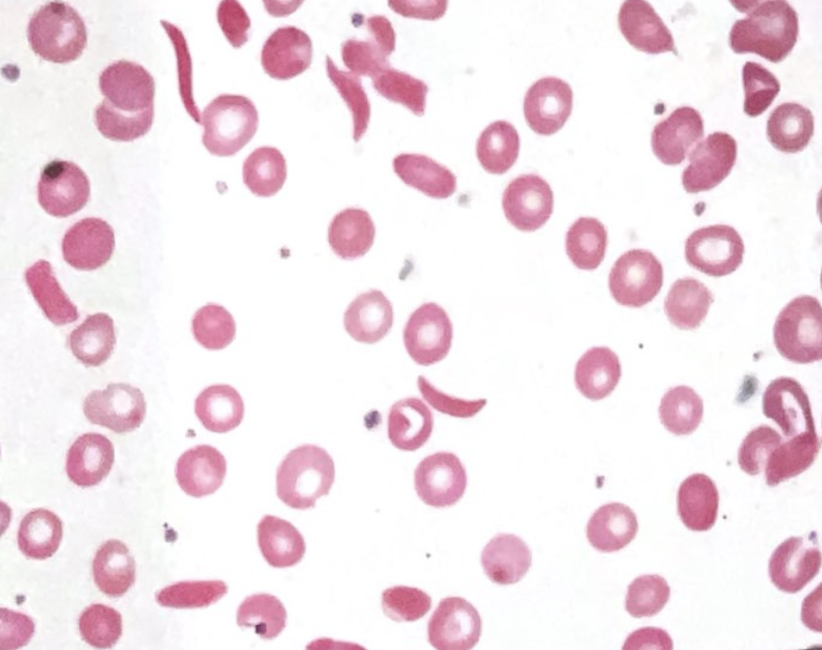
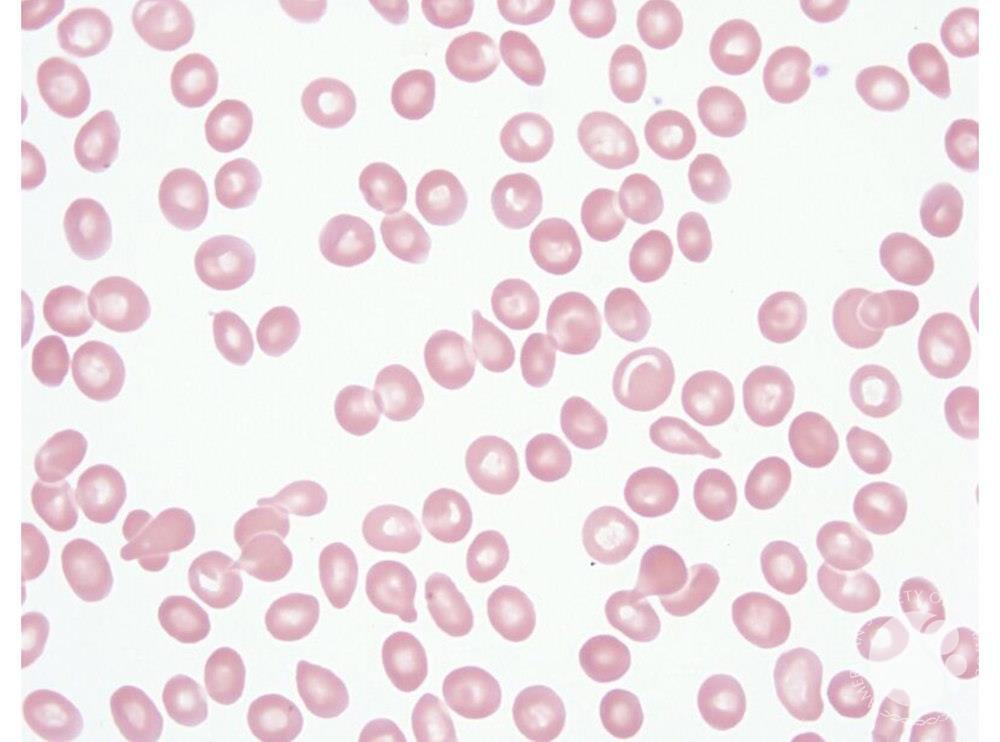
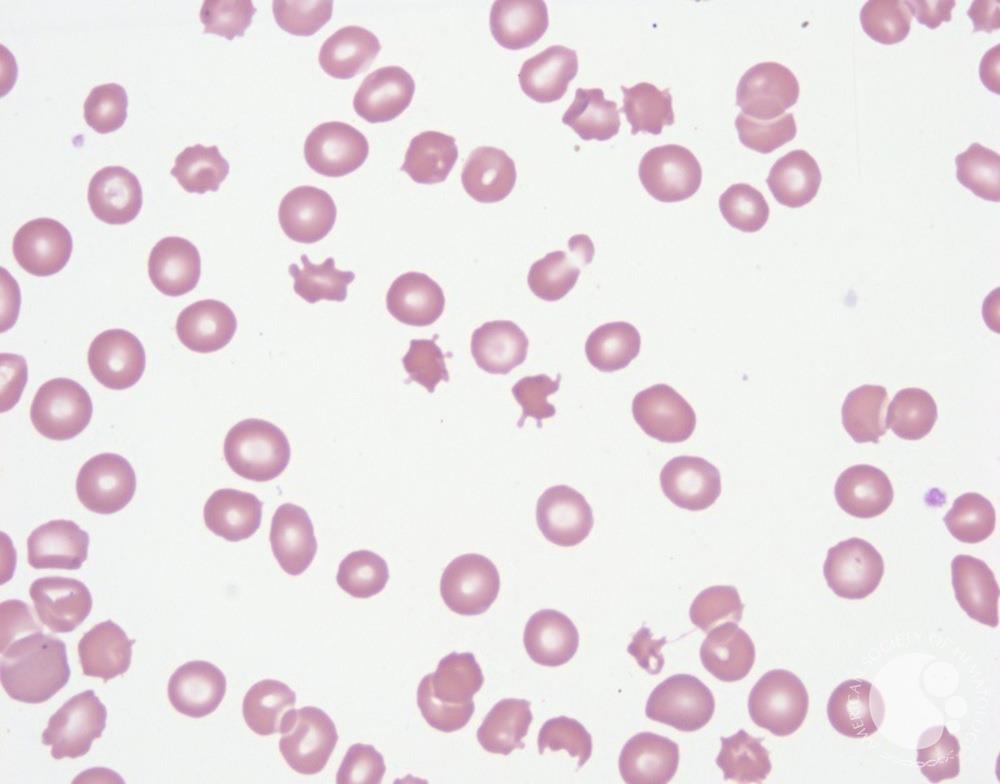
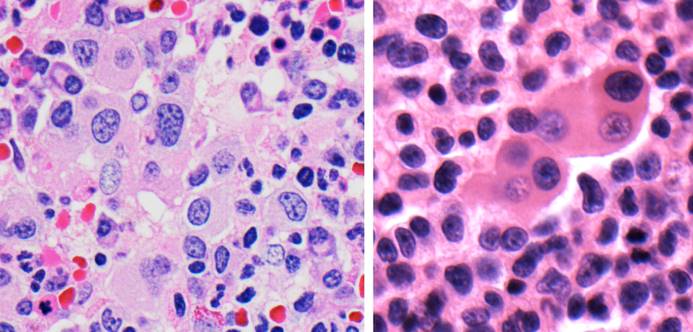
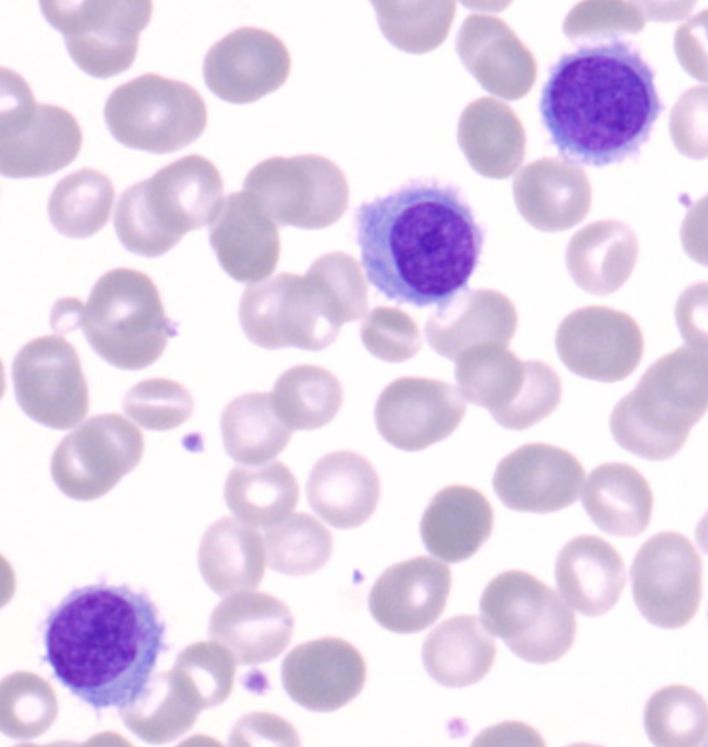
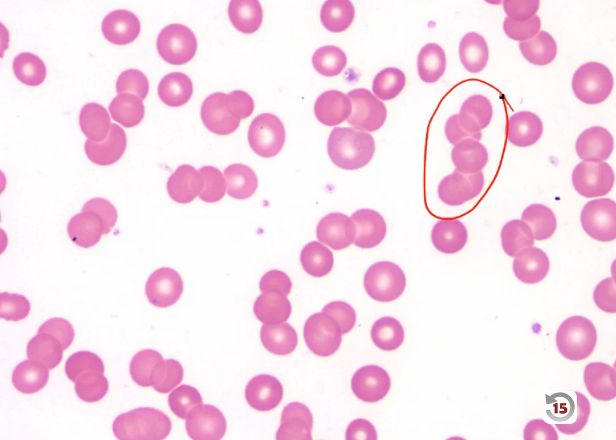
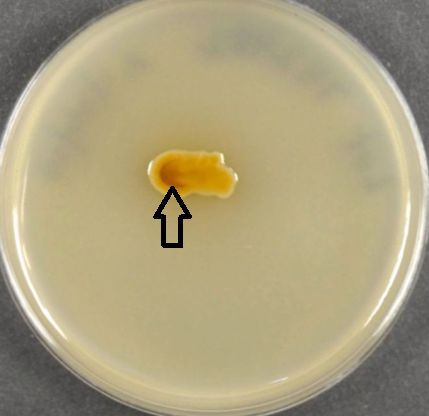
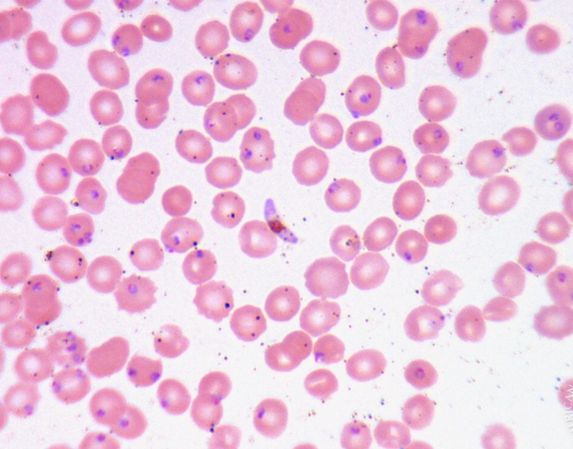
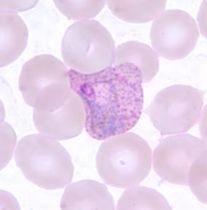
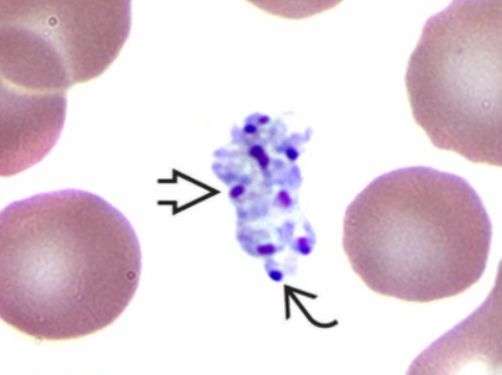

Clinical Pathology
I created these curated notes as part of my board review studying process. I thought they might be helpful for others preparing for similar exams or just looking to review clinical pathology concepts.
PART I: BLOOD BANKING AND TRANSFUSION MEDICINE
Transfusion medicine sits at the intersection of immunology, genetics, and clinical practice. Red blood cells carry hundreds of surface antigens capable of triggering immune responses, and the field developed largely from learning-often the hard way-which mismatches matter and why. This section covers the immunologic basis of blood groups, compatibility testing, component therapy, and transfusion reactions.
Chapter 1: The Immunological Basis of Blood Groups
1.1 What Are Blood Group Antigens?
Blood group antigens are molecules expressed on the surface of red blood cells that can be recognized as “foreign” by another individual’s immune system. These antigens fall into two major biochemical categories: carbohydrate antigens (like ABO) and protein antigens (like Rh, Kell, Duffy, and Kidd).
Understanding this distinction is crucial because it explains fundamental differences in how antibodies form against these antigens:
Carbohydrate antigens are found not only on red cells but throughout nature-on bacteria, plants, and food. Because of this environmental exposure, humans develop “naturally occurring” antibodies against carbohydrate antigens they lack, without ever being exposed to foreign red cells. This is why a type A person has anti-B antibodies from early childhood-they were exposed to B-like carbohydrate structures on gut bacteria and mounted an immune response.
Protein antigens, in contrast, require actual exposure to foreign red cells (through transfusion or pregnancy) before antibodies develop. A person who is Kell-negative will not have anti-Kell antibodies unless they have been previously sensitized.
1.2 The ABO Blood Group System: Foundation of Transfusion Medicine
The ABO system remains the most clinically important blood group system because ABO antibodies are: 1. Universally present when the corresponding antigen is absent 2. Capable of causing immediate, life-threatening intravascular hemolysis 3. Predominantly IgM, which efficiently activates complement
The Biochemistry of ABO
The ABO antigens are built upon a precursor structure called the H antigen. Think of the H antigen as a foundation upon which the A and B antigens are constructed. The H antigen itself is a carbohydrate chain with a terminal fucose residue, synthesized by the enzyme fucosyltransferase (encoded by the FUT1 gene, also called the H gene).
Here is the critical concept: The A and B genes encode glycosyltransferases that add additional sugars to the H antigen.
- The A gene encodes an N-acetylgalactosaminyltransferase that adds N-acetylgalactosamine to the H antigen, creating the A antigen
- The B gene encodes a galactosyltransferase that adds galactose to the H antigen, creating the B antigen
- The O gene is a null allele (due to a frameshift mutation) that produces no functional enzyme, so the H antigen remains unmodified
This means: - Type A individuals have A antigens (modified H) on their cells - Type B individuals have B antigens (modified H) on their cells - Type AB individuals have both A and B antigens - Type O individuals have only unmodified H antigen
The Bombay Phenotype: When the Foundation Is Missing
The Bombay phenotype (Oh) occurs when an individual lacks functional FUT1 gene and therefore cannot make the H antigen. Without the H antigen foundation, neither A nor B antigens can be synthesized, regardless of what ABO genes the person has inherited.
Bombay individuals have: - No A, B, or H antigens on their red cells - Anti-A, anti-B, AND anti-H antibodies in their plasma
This creates a dangerous situation: Bombay individuals can only receive blood from other Bombay donors. If given type O blood (which has abundant H antigen), they will have a severe hemolytic reaction due to their anti-H antibodies.
ABO Subgroups: When A Isn’t Just A
Not all type A individuals are created equal. The A1 and A2 subgroups represent quantitative and qualitative differences in A antigen expression:
A1 (approximately 80% of type A individuals): - Express more A antigen on their red cells - Express both A and A1 antigens (A1 is a branched form) - Strong reactions with anti-A reagents
A2 (approximately 20% of type A individuals): - Express less A antigen (approximately 25% as much) - Do not express the A1 antigen - May develop anti-A1 antibodies (found in about 1-8% of A2 individuals and 25% of A2B individuals)
The clinical significance: A2 individuals with anti-A1 can usually receive A1 blood without problems because anti-A1 is typically IgM and reacts only at cold temperatures. However, in rare cases where anti-A1 is reactive at 37°C, it can cause hemolysis.
ABO Discrepancies: When Forward and Reverse Don’t Match
In ABO typing, we perform two complementary tests: - Forward typing: Testing the patient’s red cells with known anti-A and anti-B reagents - Reverse typing: Testing the patient’s plasma with known A1 and B red cells
These should agree. When they don’t, you have an ABO discrepancy that must be resolved before transfusion.
Common causes of discrepancies include:
Extra reactions in forward typing (cells appear to type as more than one blood type): - Polyagglutination (T-activation from bacterial neuraminidase exposure) - Autoantibodies coating red cells - Recently transfused with non-identical ABO type - Rouleaux (protein coating causing stacking-seen in multiple myeloma, hyperglobulinemia)
Weak or missing reactions in forward typing: - ABO subgroups (A2, A3, Ax, etc.) - Disease states reducing antigen expression - Heavily transfused patients - Bone marrow transplant recipients (mixed field reactions during engraftment)
Extra reactions in reverse typing: - Cold autoantibodies (often anti-I) - Cold alloantibodies - Rouleaux - High-titer, low-avidity (HTLA) antibodies
Weak or missing reactions in reverse typing: - Age extremes (infants don’t make isohemagglutinins until ~4-6 months; elderly may have diminished production) - Immunocompromised patients (hypogammaglobulinemia) - Recent plasma transfusion or plasma exchange
1.3 The Rh Blood Group System: Complexity Beyond D
The Rh system is the second most important blood group system clinically and the most complex genetically, with over 50 different antigens. However, for practical purposes, five antigens matter most: D, C, c, E, and e.
Understanding Rh Genetics
The Rh antigens are encoded by two closely linked genes on chromosome 1: - RHD encodes the D antigen - RHCE encodes the C/c and E/e antigens
The D antigen is either present (Rh-positive, ~85% of Caucasians) or absent (Rh-negative, ~15% of Caucasians). There is no “d” antigen-lowercase d simply indicates the absence of D.
The C/c and E/e antigens are antithetical pairs: - C and c differ by four amino acids in the second extracellular loop of the RhCE protein - E and e differ by a single amino acid (proline vs. alanine) at position 226
Most people express both members of each antithetical pair because they inherit different RHCE alleles from each parent. For example, someone who is Ce/cE expresses all four antigens: C, c, E, and e.
The D Antigen: Why It Matters So Much
The D antigen is highly immunogenic-meaning it very effectively stimulates antibody production. Approximately 80% of D-negative individuals who receive a single D-positive red cell transfusion will develop anti-D. This makes D the most immunogenic blood group antigen after A and B.
Anti-D is: - Almost always IgG (not IgM) - Clinically significant-causes both acute and delayed hemolytic reactions - The most common cause of severe hemolytic disease of the fetus and newborn (HDFN)
Because of its clinical importance, we classify everyone as Rh-positive or Rh-negative based solely on D status, and we give RhIG (Rh immune globulin) to D-negative pregnant women to prevent sensitization.
Weak D: When D Testing Gets Complicated
Some individuals have red cells that react weakly or not at all with anti-D reagents during immediate-spin testing but react when the test is carried through the indirect antiglobulin test (IAT) phase. This is called weak D.
Weak D occurs due to: 1. Quantitative reduction in D antigen expression (fewer D antigens on each cell) 2. Caused by various RHD gene mutations that reduce but don’t eliminate D expression
The clinical significance: - Weak D individuals are generally considered D-positive for transfusion purposes (they can receive D-positive blood) - As donors, their blood is labeled D-positive - In pregnancy, weak D mothers were traditionally given RhIG to be safe, but current guidelines based on RHD genotyping may allow withholding RhIG for certain weak D types
Partial D: When D Is Missing Pieces
Partial D is fundamentally different from weak D. Partial D individuals: - Have altered D antigens missing certain epitopes (portions of the D antigen) - May make anti-D against the epitopes they lack - Can experience hemolytic reactions if transfused with D-positive blood
There are over 100 partial D types described, but some common ones include: - DVI: The most clinically significant; these individuals often make anti-D and should be considered D-negative for transfusion - DIIIa, DAR: Common in African Americans; less likely to make anti-D
The problem: Serologically, partial D often looks like weak D. Distinguishing them requires molecular (DNA) testing. Modern practice is moving toward RHD genotyping, especially in pregnant women, to make appropriate decisions about RhIG administration.
Rh Immunogenicity: The Hierarchy
Not all Rh antigens are equally immunogenic. The order from most to least immunogenic is: D > c > E > C > e
This matters clinically: - Anti-c is the second most common Rh antibody (after anti-D) and is a significant cause of HDFN - Anti-E is relatively common and usually clinically significant - Anti-C and anti-e are less common because most C-negative or e-negative individuals also lack D, and anti-D formation often overshadows these
1.4 The Kell Blood Group System: High Immunogenicity
The Kell system contains over 35 antigens, but the most important are K (Kell, K1) and k (cellano, K2).
Why Kell Matters
K is the third most immunogenic red cell antigen (after D and c). About 9% of Caucasians are K-positive; the rest are K-negative. Because K is highly immunogenic but relatively rare: - K-negative recipients are commonly exposed to K-positive blood - Anti-K formation is common after sensitization - Anti-K causes severe HDFN (and uniquely, suppresses erythropoiesis rather than just causing hemolysis)
The McLeod Phenotype: Kell and Beyond
The Kell glycoprotein is linked to the XK protein, which carries the Kx antigen and is encoded on the X chromosome. McLeod syndrome occurs when the XK gene is deleted or mutated, resulting in: - Absent Kx antigen - Markedly reduced Kell antigen expression - Acanthocytes (spiky red cells) on peripheral smear - Late-onset neurological disease (resembling chorea) - Hemolytic anemia
McLeod individuals can only receive blood from other McLeod donors-their anti-Ku + anti-Km antibodies react with all Kell-system antigens.
1.5 The Duffy Blood Group System: Malaria Resistance
The Duffy system has two principal antigens: Fy(a) and Fy(b), encoded by alleles of the ACKR1 gene (formerly DARC-Duffy Antigen Receptor for Chemokines).
The Duffy-Malaria Connection
The Duffy glycoprotein serves as a receptor for chemokines-but it was evolutionarily co-opted by Plasmodium vivax as its entry point into red blood cells. This creates a fascinating example of natural selection:
In West Africa, where P. vivax malaria was historically endemic, a promoter mutation arose that prevents Duffy expression on red cells (while maintaining expression elsewhere). Individuals with this Fy(a-b-) phenotype are: - Completely resistant to P. vivax infection - Found in up to 70% of West African populations and their descendants
This is why P. vivax malaria is rare in sub-Saharan Africa-most of the population lacks the receptor the parasite needs.
Clinical Significance of Duffy Antibodies
Anti-Fya and anti-Fyb are clinically significant antibodies: - Usually IgG, reactive at 37°C - Can cause both acute and delayed hemolytic transfusion reactions - Can cause HDFN (usually mild to moderate)
Important laboratory concept: Duffy antigens are destroyed by ficin and papain (proteolytic enzymes used in antibody identification). If an antibody reacts in the standard panel but not after enzyme treatment, and shows the Duffy pattern, it’s likely anti-Fya or anti-Fyb.
1.6 The Kidd Blood Group System: The Notorious Cause of Delayed Reactions
The Kidd system has two principal antigens: Jk(a) and Jk(b), encoded by the SLC14A1 gene (a urea transporter).
Why Kidd Antibodies Are Dangerous
Kidd antibodies are notorious in blood banking for several reasons:
They cause delayed hemolytic transfusion reactions (DHTR): The classic scenario is a patient transfused without problems, then 3-14 days later develops anemia, jaundice, and a positive DAT. Investigation reveals a new Kidd antibody.
They disappear and reappear: Anti-Jka and anti-Jkb often fall below detectable levels, only to rapidly reappear (anamnestic response) upon re-exposure to antigen-positive cells.
They show dosage: Kidd antibodies react more strongly with cells from homozygotes (Jk(a+b-) or Jk(a-b+)) than heterozygotes (Jk(a+b+)). This can cause weak or negative antibody screens if screening cells are heterozygous.
They fix complement: Kidd antibodies efficiently activate complement, which explains why DHTR from anti-Kidd often has an intravascular hemolysis component.
The clinical lesson: Always consider Kidd antibodies in patients with delayed hemolytic reactions, even if the antibody screen is negative. Historical records are crucial-if a patient had anti-Jka five years ago, assume they still have it and provide Jk(a-) blood.
1.7 Other Blood Group Systems: What You Need to Know
The MNS System
The MNS system antigens are carried on glycophorins A (M and N antigens) and B (S and s antigens). Key points:
- Anti-M: Usually naturally occurring IgM, cold-reactive, clinically insignificant. May rarely be IgG and cause HDFN.
- Anti-N: Rare and almost never clinically significant
- Anti-S and anti-s: IgG, clinically significant, can cause hemolytic reactions and HDFN
- MNS antigens are destroyed by enzymes (ficin, papain)-useful in antibody identification
The Lewis System
Lewis antigens (Le(a) and Le(b)) are unique because: - They are not synthesized by the red cell-they’re made in secretory tissue and adsorbed onto the red cell membrane from plasma - They’re not present at birth; they develop over the first two years of life - Expression depends on Lewis and Secretor gene inheritance
Lewis phenotypes and genetics: - Le(a+b-): Has Lewis gene, lacks Secretor gene - Le(a-b+): Has both Lewis and Secretor genes (Secretor converts Le(a) to Le(b)) - Le(a-b-): Lacks Lewis gene (common in Black individuals, ~30%)
Clinical significance: Anti-Lea and anti-Leb are almost always IgM, reactive only at cold temperatures, and clinically insignificant. They do not cause HDFN (IgM doesn’t cross the placenta) and rarely cause hemolytic reactions. Most blood banks consider them nuisance antibodies.
The I/i System
I and i antigens are not antithetical-they represent developmental differences in carbohydrate chain branching: - i antigen: Linear chains, predominant on fetal/cord blood cells - I antigen: Branched chains, predominant on adult cells
Anti-I is a common cold autoantibody: - Found in cold agglutinin disease (often following Mycoplasma pneumoniae infection) - IgM, reactive at cold temperatures - Clinically significant when thermal amplitude extends near 37°C
Anti-i is rare but associated with infectious mononucleosis (EBV infection).
The P1PK System
The P1 antigen is highly variable in expression. Anti-P1 is: - Usually naturally occurring IgM - Clinically insignificant (cold-reactive) - Common (found in ~30% of P1-negative individuals)
The very rare anti-PP1Pk (formerly anti-Tja) reacts with cells from 99.9% of people and is associated with early spontaneous abortions.
Chapter 2: Antibody Identification and Compatibility Testing
2.1 The Antiglobulin Test: The Foundation of Modern Blood Banking
The antiglobulin test (Coombs test) is perhaps the single most important tool in transfusion medicine. Understanding it deeply is essential.
The Principle
Human antibodies (IgG) and complement fragments (C3d) bound to red blood cells are invisible to the naked eye-they don’t directly cause agglutination. The antiglobulin test makes them visible:
Anti-human globulin (AHG) is an antibody (made in animals) directed against human IgG and/or human complement components. When AHG is added to red cells coated with IgG or C3d, it cross-links the antibodies/complement, creating visible agglutination.
Direct Antiglobulin Test (DAT)
The DAT detects antibodies or complement already bound to the patient’s red cells in vivo. The procedure: 1. Wash the patient’s red cells (to remove unbound proteins) 2. Add polyspecific AHG (contains both anti-IgG and anti-C3d) 3. If positive, test with monospecific AHG to determine what’s on the cells
Clinical interpretation of DAT results:
| DAT Result | IgG | C3d | Possible Causes |
|---|---|---|---|
| Positive | + | - | Warm autoimmune hemolytic anemia, drug-induced (methyldopa type), HDFN, alloantibody-coated cells |
| Positive | - | + | Cold agglutinin disease (IgM elutes during washing, leaves complement), some drug-induced |
| Positive | + | + | Warm AIHA, drug-induced (immune complex), some alloantibodies |
| Negative | - | - | Normal; IgM-only sensitization; low-level sensitization below test threshold |
Important nuances: - A positive DAT doesn’t always mean hemolysis is occurring-many hospitalized patients have positive DATs without hemolysis - A negative DAT doesn’t rule out immune hemolysis-some antibodies are low-affinity and wash off - Drug-induced antibodies may require special techniques (including the drug) to detect
Indirect Antiglobulin Test (IAT)
The IAT detects antibodies in the patient’s serum/plasma that bind to reagent red cells in vitro. The procedure: 1. Incubate patient serum with reagent red cells at 37°C 2. Wash cells (to remove unbound proteins) 3. Add AHG 4. Read for agglutination
The IAT is used in: - Antibody screening - Antibody identification - Crossmatching - Phenotyping with certain reagents
2.2 Antibody Screening: The First Line of Defense
Before transfusion, every patient receives an antibody screen to detect clinically significant unexpected antibodies.
The Method
The antibody screen tests patient plasma against 2-3 reagent screening cells with known antigen profiles. These cells are group O (to avoid ABO reactions) and are selected to express all common clinically significant antigens between them.
The screen is performed using IAT methodology: - Incubation at 37°C (to detect clinically significant IgG antibodies) - Addition of AHG - Reading for agglutination
Enhancement Media
To increase sensitivity, most modern screens use enhancement reagents:
LISS (Low Ionic Strength Saline): Reduces the ionic cloud around red cells, bringing antibody and antigen closer together. Increases antibody uptake, reduces incubation time.
PEG (Polyethylene Glycol): Concentrates antibodies by excluding water, forcing antibody-antigen interactions. Highly sensitive but can cause false positives; must wash before adding AHG.
Gel or solid-phase technology: Modern platforms that capture antibody-antigen reactions in a gel column or on a solid surface. More standardized and amenable to automation.
2.3 Antibody Identification: The Art of Pattern Recognition
When the antibody screen is positive, you must identify the antibody. This is both a science and an art.
The Panel
An antibody identification panel consists of 10-16 group O reagent cells with known antigen profiles. You test the patient’s plasma against each cell and record reactivity.
The Rule-Out Process
For each antigen on the panel, you can potentially “rule out” the corresponding antibody if: - At least one cell that is positive for the antigen is non-reactive with the patient’s plasma
For example, if cell #3 is K+ (Kell positive) and the patient’s plasma does not react with cell #3, you can rule out anti-K.
The standard of practice is the “rule of three”-for statistical confidence, you need: - At least 3 antigen-positive cells reacting with the plasma - At least 3 antigen-negative cells NOT reacting with the plasma
This gives statistical significance (p < 0.05) that the association is real.
Reading the Pattern
After running the panel, you look at which cells react and don’t react. You then correlate this with the antigen profile: - Which antigens are present on all reacting cells? - Which antigens are absent on non-reacting cells?
The antibody specificity should explain the reactivity pattern.
Complications in Antibody Identification
Real-world cases are often more complex:
Multiple antibodies: The patient has more than one antibody. The pattern won’t fit a single specificity. Solutions: - Selected cell panels with cells positive for one suspected antigen and negative for another - Antibody removal techniques (adsorption) to separate and identify each antibody
Dosage effect: Some antibodies (Kidd, Duffy, MNS, Rh c/C/e/E) react more strongly with cells from homozygotes. If your panel is mostly heterozygotes, you might see weak or variable reactions.
Cold antibodies interfering: Cold-reactive IgM antibodies (anti-I, anti-M, anti-Lewis) can cause positive reactions at room temperature, confusing the pattern. Solutions: - Test strictly at 37°C - Pre-warm technique - Enzyme treatment (destroys some cold-reactive antigens)
Autoantibody: If the DAT is positive and the patient appears to have a pan-reactive pattern, they may have an autoantibody. Autoantibodies coat the patient’s own cells and react with all panel cells.
Special Techniques
Enzyme treatment: Treating cells with ficin or papain: - Destroys: Duffy, MNS antigens - Enhances: Rh, Kidd, Lewis - Useful for: Unmasking Rh or Kidd antibodies behind Duffy antibodies, evaluating cold-reactive antibodies
DTT (Dithiothreitol): Denatures IgM antibodies; useful for: - Eliminating IgM cold antibodies to see underlying IgG - Note: Also destroys Kell antigens
Adsorption: Removing antibodies from serum by incubating with antigen-positive cells: - Autoadsorption: Patient’s own cells remove autoantibody, leaving alloantibodies - Differential adsorption: Selected cells remove specific alloantibodies
Elution: Recovering antibodies from the red cell surface for identification. Methods include acid elution, heat elution, and freeze-thaw elution.
2.4 Compatibility Testing: Putting It All Together
The Type and Screen
For most patients, a “type and screen” is sufficient before surgery: - ABO/Rh typing - Antibody screen
If the screen is negative and the patient has no history of antibodies, blood can be rapidly provided with an abbreviated crossmatch.
The Crossmatch
The crossmatch tests compatibility between the specific donor unit and the patient:
Immediate-spin crossmatch: Just ABO compatibility check. Appropriate only when: - Current antibody screen is negative - No history of clinically significant antibodies
Full (antiglobulin) crossmatch: Includes 37°C incubation and AHG phase. Required when: - Current antibody screen is positive - Patient has a history of clinically significant antibodies
Electronic crossmatch: Computer verification that ABO-compatible blood is selected. Requirements: - Two separate ABO/Rh typings on file (from different samples) - Current negative antibody screen - Validated computer system
The electronic crossmatch is now standard at many institutions-it’s fast and eliminates the serological crossmatch when appropriate.
Urgent Transfusion: When There’s No Time
In emergencies, uncrossmatched blood may be necessary:
O-negative red cells: The “universal donor” for red cells-no A, B, or D antigens to cause immediate hemolysis. Use for: - Unknown blood type - D-negative women of childbearing potential
O-positive red cells: Acceptable for males and post-menopausal females when O-negative is scarce
Type-specific, uncrossmatched: Once ABO/Rh is known (takes ~5 minutes), switch to type-specific blood
AB plasma: The “universal donor” for plasma-no anti-A or anti-B to cause hemolysis
Document the clinical urgency when releasing uncrossmatched blood.
Blood Product Compatibility Quick Reference
Red Blood Cell Compatibility (based on recipient’s ABO type):
| Patient Blood Type | Can Receive RBCs From |
|---|---|
| O | O only |
| A | A, O |
| B | B, O |
| AB | A, B, AB, O (universal recipient) |
Rh Consideration: Rh-negative patients should receive Rh-negative RBCs. Rh-positive patients can receive either. In emergencies, Rh-positive blood can be given to Rh-negative males and post-menopausal females when Rh-negative is unavailable.
Plasma Compatibility (opposite of RBCs-based on what antibodies the plasma contains):
| Patient Blood Type | Can Receive Plasma From |
|---|---|
| O | O, A, B, AB |
| A | A, AB |
| B | B, AB |
| AB | AB only |
Key Principle: For RBCs, you avoid giving antigens the patient has antibodies against. For plasma, you avoid giving antibodies that will attack the patient’s RBCs. This is why O is the universal RBC donor but AB is the universal plasma donor.
Chapter 3: Blood Components and Their Clinical Use
3.1 Component Preparation and Anticoagulant-Preservative Solutions
Understanding how blood components are prepared and stored is essential for understanding their clinical properties.
Whole Blood Processing
Whole blood collection yields approximately 450-500 mL of blood mixed with 63-70 mL of anticoagulant-preservative solution. From this single donation, multiple components can be prepared:
Centrifugation steps: 1. Soft spin (2000g × 3 minutes): Separates packed RBCs from platelet-rich plasma (PRP) 2. Hard spin (5000g × 5 minutes): Separates platelets from plasma 3. Cryoprecipitate preparation: Slow thawing of FFP at 1-6°C causes cold-insoluble proteins to precipitate; a second hard spin separates cryoprecipitate from cryo-poor plasma
The density hierarchy (from least to most dense): Plasma < Platelets < Lymphocytes < Monocytes < Neutrophils < Red cells. This is why centrifugation effectively separates components.
Anticoagulant-Preservative Solutions
Traditional solutions (used alone):
| Solution | Key Features | RBC Shelf Life |
|---|---|---|
| CPD | Citrate + Phosphate + Dextrose | 21 days |
| CP2D | Double dextrose compared to CPD | 21 days |
| CPDA-1 | CPD + Adenine | 35 days |
The role of each component: - Citrate: Anticoagulant-chelates calcium to prevent clotting - Phosphate: Buffer-maintains pH to support glycolysis - Dextrose: Fuel-metabolized via glycolysis to generate ATP - Adenine: ATP precursor-directly supports ATP synthesis, extending RBC viability
Additive solutions (AS-1, AS-3, AS-5, AS-7): - Added to RBCs after plasma removal - Extend shelf life to 42 days - Allow more plasma to be harvested (better platelet and FFP yield) - Result in lower hematocrit (~55-65%) making transfusion easier
| Additive Solution | Brand Name | Key Components |
|---|---|---|
| AS-1 | Adsol | Dextrose, adenine, mannitol, NaCl |
| AS-3 | Nutricel | Dextrose, adenine, phosphate, citrate, NaCl |
| AS-5 | Optisol | Similar to AS-1, less mannitol |
| AS-7 | SOLX | Newer formulation with improved RBC recovery |
Mannitol in AS-1 and AS-5 serves as a membrane stabilizer, reducing hemolysis during storage.
Quality Control Standards for Blood Components
| Component | Quality Control Requirement |
|---|---|
| RBCs (additive solution) | Hct ≤80%; ≥75% recovery at 24 hours post-transfusion |
| Leukoreduced RBCs | <5 × 10^6 WBCs; retain ≥85% original RBCs |
| Apheresis platelets | ≥3 × 10^11 platelets; pH ≥6.2 at outdate |
| Whole blood platelets | ≥5.5 × 10^10 platelets per unit; pH ≥6.2 |
| FFP | All clotting factors ≥1 IU/mL |
| Cryoprecipitate | ≥80 IU Factor VIII; ≥150 mg fibrinogen per unit |
| Irradiated products | 25 Gy to center; ≥15 Gy at all points |
3.2 Red Blood Cell Products
The Storage Lesion
During storage, red cells undergo progressive changes-the “storage lesion”:
- Decreased 2,3-DPG: Shifts the oxygen dissociation curve left, reducing oxygen delivery. Levels recover within 12-24 hours post-transfusion.
- Decreased ATP: Compromises membrane integrity
- Increased potassium: RBCs leak K+ as the Na-K-ATPase fails. Fresh units have ~4 mEq/L supernatant K+; 42-day units may have 40-50 mEq/L
- Decreased pH: Lactate accumulates from anaerobic glycolysis
- Microvesicle formation: Membrane blebs form
- Increased free hemoglobin: Cellular lysis releases hemoglobin
Clinical relevance: - Neonates and massive transfusion patients may be affected by high K+ and low pH - Most changes are rapidly reversed after transfusion in stable patients - There’s ongoing debate about whether “fresh” blood improves outcomes; current evidence doesn’t support routine use of only fresh units
Modified RBC Products
Leukoreduced RBCs: Contains <5 × 10^6 white blood cells (>99.9% reduction)
How it’s made: Filtration through specialized filters during collection (prestorage) or before transfusion
Benefits: - Reduces febrile non-hemolytic transfusion reactions (caused by WBC cytokines and recipient anti-HLA antibodies) - Reduces HLA alloimmunization (important for patients who may need platelet transfusions or transplant) - Reduces CMV transmission (CMV lives in WBCs; leukoreduction is considered “CMV-safe”)
Currently, over 90% of RBCs in the US are universally leukoreduced.
Irradiated RBCs: Exposed to 25-50 Gy gamma radiation
Purpose: Prevents transfusion-associated graft-versus-host disease (TA-GVHD)
How it works: Inactivates donor T-lymphocytes that could engraft and attack the recipient’s tissues
Indications: - Immunocompromised recipients (congenital immunodeficiency, hematologic malignancies, stem cell transplant) - HLA-matched or HLA-selected products - Directed donations from blood relatives - Intrauterine transfusions - Neonates (especially premature or those receiving exchange transfusion)
Side effect: Accelerates K+ leak (irradiation damages the RBC membrane). Irradiated units should ideally be used within 28 days or less.
Washed RBCs: RBCs washed with saline to remove plasma proteins
Indications: - IgA-deficient patients with anti-IgA (prevents anaphylaxis) - Severe allergic reactions not controlled by premedication - T-activated cells (washing removes plasma containing antibodies to T antigen)
Drawbacks: Time-consuming, shortens shelf life to 24 hours, results in some RBC loss
Frozen/Deglycerolized RBCs: Cryopreserved using glycerol, stored at -65°C (10-year shelf life)
Use: Storing rare blood types. After thawing and deglycerolization (washing out the glycerol), shelf life is 24 hours (open system) to 14 days (closed system).
3.3 Platelet Products
Platelet Biology Relevant to Storage
Platelets are far more delicate than red cells: - Must be stored at room temperature (20-24°C)-cold causes irreversible aggregation and shape change - Require continuous gentle agitation to allow gas exchange - Have short shelf life (5 days, extended to 7 days with pathogen reduction) - Are prone to bacterial contamination (room temperature storage allows bacterial growth)
Types of Platelet Products
Whole blood-derived platelets: Made by centrifuging whole blood donations - Platelet-rich plasma method: Soft spin to separate PRP, then hard spin to pellet platelets - Buffy coat method: Hard spin to separate buffy coat (WBCs and platelets), then light spin to separate platelets - One unit contains ~5.5 × 10^10 platelets - Usually pooled (4-6 units) to provide a therapeutic dose (~3 × 10^11 platelets)
Apheresis platelets: Collected by apheresis from a single donor - Contains ~3 × 10^11 platelets (equivalent to ~6 pooled whole blood units) - Single donor exposure - Lower bacterial contamination risk - Can be HLA-matched if needed
Platelet Transfusion Dosing
A standard adult dose (one apheresis unit or one pool) should raise the platelet count by: - Approximately 30,000-50,000/μL in a 70 kg adult - Or can be calculated as: Increment = (Platelets transfused × 0.67) / Blood volume (L)
Corrected Count Increment (CCI): Used to assess platelet transfusion response - CCI = (Post-transfusion count - Pre-transfusion count) × BSA (m²) / Platelets transfused (× 10^11) - Normal CCI at 1 hour: >7,500 - Normal CCI at 24 hours: >4,500 - Lower than expected suggests refractoriness
Platelet Refractoriness
When a patient has repeated poor platelet increments, they’re considered refractory. Causes are divided into:
Non-immune causes (more common, ~80%): - Splenomegaly (platelet sequestration) - Fever/sepsis (increased consumption) - DIC (consumption) - Medications (amphotericin B, vancomycin) - Bleeding (consumption)
Immune causes (~20%): - HLA antibodies (most common immune cause): Recipient has antibodies to donor HLA Class I antigens on platelets - HPA (Human Platelet Antigen) antibodies: Less common
Management: - For non-immune: Treat underlying cause; consider more frequent transfusions - For immune: - HLA-matched platelets (requires HLA typing and HLA-matched donor inventory) - Crossmatch-compatible platelets (test recipient serum against donor platelets) - Platelet serial ABO matching (sometimes helps)
3.4 Plasma Products
Fresh Frozen Plasma (FFP)
FFP is plasma separated from whole blood and frozen within 8 hours of collection at ≤-18°C (or within 24 hours for “PF24”).
Contents: - All coagulation factors (including V and VIII) - Fibrinogen (~200-400 mg per unit) - Plasma proteins (albumin, immunoglobulins) - Volume ~200-250 mL per unit
Clinical uses: - Replacement of multiple coagulation factors (liver disease, DIC, massive transfusion) - Reversal of warfarin (when PCC not available or contraindicated) - TTP therapeutic plasma exchange (replacement fluid) - Rare factor deficiencies without specific concentrates
Dosing: 10-20 mL/kg (typically 4-6 units in an adult) to achieve 20-30% factor activity increase
Important concept: FFP must be ABO-compatible with the recipient’s red cells: - Type A recipients can receive A or AB plasma - Type B recipients can receive B or AB plasma - Type O recipients can receive O, A, B, or AB plasma - Type AB recipients can receive only AB plasma
AB plasma is the “universal donor” for plasma because it contains no anti-A or anti-B.
Thawed plasma: FFP thawed and stored at 1-6°C for up to 5 days. Has reduced levels of factors V and VIII but is suitable for most indications.
Cryoprecipitate
Cryoprecipitate is the cold-insoluble portion of plasma that precipitates when FFP is slowly thawed at 1-6°C.
Contents (per unit): - Fibrinogen: ≥150 mg (usually ~250 mg) - Factor VIII: ≥80 IU - Factor XIII - von Willebrand factor - Fibronectin
Volume: ~15 mL per unit (small volume is an advantage for fluid-restricted patients)
Indications: - Fibrinogen replacement (hypofibrinogenemia, DIC, massive transfusion) - Target fibrinogen usually >100-150 mg/dL - Uremic bleeding (controversial; contains vWF) - Factor XIII deficiency - Previously used for hemophilia A and vWD (now use specific concentrates)
Dosing for fibrinogen replacement: - One unit raises fibrinogen ~5-10 mg/dL in a 70 kg adult - Typical dose: 10 units (one “pool”) - Expected increase: ~50-100 mg/dL
Cryoprecipitate-reduced plasma (cryo-poor plasma): Plasma remaining after cryoprecipitate is removed. Used specifically for TTP therapeutic plasma exchange (lacks large vWF multimers that might exacerbate the condition).
3.5 Other Blood Products
Granulocytes
Granulocyte transfusions are used for: - Severe neutropenia with documented infection not responding to antibiotics - Neutrophil dysfunction syndromes
Collection: Apheresis with donor stimulation (G-CSF ± steroids) to increase yield
Storage: Room temperature without agitation; 24-hour shelf life
Special considerations: - Must be irradiated (viable lymphocytes present) - Must be ABO and Rh compatible - CMV-negative or leukoreduced not possible (you’re transfusing WBCs) - Usually given daily until infection resolves or neutrophil recovery
Clinical efficacy is debated; recent trials showed modest benefit in certain settings.
Chapter 4: Transfusion Reactions
Understanding transfusion reactions requires integrating immunology, pathophysiology, and clinical medicine. Every reaction has a mechanism, and understanding that mechanism guides recognition and management.
4.1 Acute Hemolytic Transfusion Reaction (AHTR)
The Mechanism
AHTR occurs when the recipient’s antibodies destroy transfused red cells. The most common scenario is ABO incompatibility from clerical error-a unit labeled for one patient given to another.
The pathophysiology: 1. Antibody binding: Pre-existing IgM antibodies (anti-A, anti-B) bind to incompatible donor red cells 2. Complement activation: IgM efficiently activates the classical complement pathway (C1 → C4 → C2 → C3 → C5-C9) 3. Membrane attack complex: C5-C9 creates pores in the red cell membrane, causing intravascular hemolysis 4. Cytokine storm: Complement fragments (C3a, C5a) and other mediators trigger massive inflammatory response 5. End-organ effects: - Hypotension from vasodilation - DIC from procoagulant release - Acute kidney injury from hemoglobin and cytokine effects on renal vasculature
Clinical Presentation
Symptoms can begin within minutes of starting transfusion: - Fever, chills (sometimes the only sign in anesthetized patients) - Chest pain, back pain, flank pain - Hypotension - Dark urine (hemoglobinuria) - Anxiety, sense of doom - Bleeding from DIC
In anesthetized patients: Hemoglobinuria, hypotension, and diffuse bleeding may be the only signs.
Laboratory Findings
- Positive DAT (often mixed-field due to mix of patient and donor cells)
- Hemoglobinemia (pink/red plasma)
- Hemoglobinuria (pink/red urine with positive blood on dipstick but no RBCs on microscopy)
- Decreased haptoglobin (bound by free hemoglobin)
- Elevated LDH (released from lysed cells)
- Elevated indirect bilirubin (delayed, from hemoglobin metabolism)
- Elevated creatinine (acute kidney injury)
- Coagulation abnormalities (prolonged PT/aPTT, low fibrinogen, elevated D-dimer) if DIC develops
Management
- Stop the transfusion immediately
- Maintain IV access with normal saline
- Support blood pressure (fluids, vasopressors if needed)
- Maintain urine output >1 mL/kg/hr (fluids, diuretics if needed; goal is to prevent renal tubular damage from hemoglobin)
- Clerical check: Verify patient identification and unit labeling
- Send blood bank samples: Post-transfusion patient sample, the unit with attached segment, and tubing
- Monitor and treat DIC if it develops
- Anticipate and treat acute kidney injury
4.2 Delayed Hemolytic Transfusion Reaction (DHTR)
The Mechanism
DHTR occurs when a patient who was previously sensitized to a red cell antigen receives antigen-positive blood. At the time of transfusion, the antibody has waned below detectable levels. Exposure to the antigen triggers an anamnestic (memory) response:
- Memory B cells recognize the antigen
- Rapid proliferation and differentiation into plasma cells
- IgG antibody production within days
- Antibody-coated donor cells are removed primarily by the spleen (extravascular hemolysis)
Timing: 3-14 days post-transfusion (typically 5-7 days)
Common antibodies causing DHTR: - Kidd (especially Jka): The classic culprit; notorious for falling below detectable levels - Duffy (Fya) - Kell - Rh (C, c, E, e)
Clinical Presentation
Often subtle: - Falling hemoglobin or failure to achieve expected post-transfusion hemoglobin - Low-grade fever - Mild jaundice - Symptoms may be mistaken for other conditions (sepsis, bleeding)
Some patients have an intravascular component and present more dramatically (especially with Kidd antibodies).
Laboratory Findings
- Positive DAT (usually IgG; may be mixed-field)
- New alloantibody detected on antibody screen (wasn’t present before transfusion)
- Evidence of hemolysis: Elevated LDH, elevated indirect bilirubin, decreased haptoglobin
- Reticulocytosis (compensatory response)
Management
- Usually supportive; most cases are self-limited
- Transfuse if needed with antigen-negative blood
- Ensure the new antibody is documented for future transfusions
The key lesson: Maintain historical antibody records. A patient who made anti-Jka once should receive Jk(a-) blood forever, even if the current screen is negative.
4.3 Febrile Non-Hemolytic Transfusion Reaction (FNHTR)
The Mechanism
Two mechanisms contribute:
- Recipient antibodies to donor WBCs/HLA: The recipient’s anti-HLA antibodies react with donor leukocytes, causing cytokine release
- Cytokines accumulated during storage: Donor WBCs release IL-1, IL-6, IL-8, and TNF-α during storage; these are transfused and cause fever
The relative contribution depends on whether the product is leukoreduced: - Non-leukoreduced: Both mechanisms contribute - Prestorage leukoreduced: Mainly the second mechanism (fewer WBCs to make cytokines) - Leukoreduction has significantly reduced FNHTR incidence
Clinical Presentation
- Temperature rise ≥1°C (or 2°F) during or within 4 hours of transfusion
- Chills and rigors
- No hemolysis (this is the key distinguishing feature)
Differential Diagnosis
The challenge: Fever during transfusion could be: - FNHTR (benign) - AHTR (life-threatening) - Septic transfusion reaction (life-threatening) - Unrelated fever (patient’s underlying condition)
You must always consider AHTR and sepsis before diagnosing FNHTR.
Management
- Stop or slow the transfusion
- Evaluate for hemolysis (clerical check, visual inspection of plasma, DAT)
- Consider sepsis workup if clinically indicated
- Antipyretics for symptom relief
- If FNHTR is confirmed and patient needs more blood: Premedicate with acetaminophen; ensure products are leukoreduced
4.4 Allergic Reactions
Allergic reactions to transfusion range from mild urticaria to life-threatening anaphylaxis.
Mild Allergic Reactions (Urticaria)
Mechanism: IgE-mediated reaction to plasma proteins
Presentation: - Urticaria (hives) - Pruritus - No respiratory or cardiovascular compromise
Management: - May slow or stop transfusion - Antihistamines (diphenhydramine) - If symptoms resolve after antihistamine, may cautiously resume transfusion - For patients with recurrent urticarial reactions: Premedicate with antihistamines
Anaphylactic Reactions
Mechanism: Multiple possible causes: - IgA deficiency with anti-IgA: The classic teaching. Patients who completely lack IgA can make antibodies (IgG or IgE class) against IgA. When transfused with IgA-containing products, severe anaphylaxis can occur. - Other plasma protein antibodies: Anti-haptoglobin, anti-C4, etc. - IgE to other allergens in donor plasma
Presentation: - Rapid onset after starting transfusion (often within minutes) - Hypotension, bronchospasm, stridor - May have urticaria and angioedema - Can be fatal
Management: - Stop transfusion immediately - Epinephrine (first-line for anaphylaxis) - Maintain airway (intubation if needed) - IV fluids for hypotension - Antihistamines, steroids as adjuncts - Workup: Check IgA level and anti-IgA
Prevention for confirmed IgA deficiency with anti-IgA: - Washed cellular products (removes plasma) - Plasma products from IgA-deficient donors (rare; maintained in special registries)
4.6 Transfusion-Associated Circulatory Overload (TACO)
The Mechanism
TACO is straightforward: giving more volume than the cardiovascular system can handle. It’s cardiogenic pulmonary edema from transfusion.
Risk factors: - Advanced age - Pre-existing cardiac dysfunction - Renal failure - Small body size - Rapid transfusion rate - Large volume transfused
TACO is increasingly recognized as possibly the most common serious transfusion reaction, especially in elderly hospitalized patients.
Clinical Presentation
- Onset during or within 6 hours of transfusion
- Dyspnea, orthopnea
- Bilateral pulmonary edema
- Elevated blood pressure (unlike TRALI)
- Elevated jugular venous pressure
- Elevated BNP (typically >3 times baseline or >500 pg/mL)
Management
- Stop or slow transfusion
- Upright positioning
- Supplemental oxygen
- Diuretics (furosemide)
Prevention
- Transfuse slowly (1-2 mL/kg/hr for at-risk patients)
- Consider one unit at a time with reassessment
- Diuretic between units if needed
- Avoid unnecessary transfusions
4.7 Transfusion-Associated Graft-versus-Host Disease (TA-GVHD)
The Mechanism
TA-GVHD occurs when viable donor T-lymphocytes in a blood product engraft in the recipient and mount an immune attack against the recipient’s tissues.
Normally, the recipient’s immune system would recognize and destroy donor lymphocytes. TA-GVHD occurs when: - The recipient is severely immunocompromised (can’t reject donor cells), OR - The donor is homozygous for an HLA haplotype that the recipient is heterozygous for (recipient immune system sees donor cells as “self”)
The second scenario is why directed donations from blood relatives are risky: a parent or child often shares an HLA haplotype.
Clinical Presentation
Onset: 4-30 days post-transfusion (typically 8-10 days)
Classic features: - Rash (erythematous, often starting on face and trunk, can progress to desquamation) - Hepatitis (elevated transaminases, hyperbilirubinemia) - Diarrhea (watery, may be bloody) - Bone marrow aplasia: This is what makes TA-GVHD different from transplant GVHD and what makes it almost uniformly fatal
The bone marrow aplasia occurs because the donor T-cells attack the recipient’s hematopoietic stem cells (which, unlike in transplant GVHD, are recipient-origin and thus targets).
Prognosis
Mortality: >90%. Most patients die from infection secondary to pancytopenia.
There is no effective treatment. Prevention is critical.
Prevention
Irradiation of cellular blood products inactivates T-lymphocytes (requires 25-50 Gy).
Indications for irradiation: - Intrauterine transfusions - Exchange transfusions in neonates - Premature infants - Congenital immunodeficiency syndromes - Hematologic malignancies (especially Hodgkin lymphoma) - Recipients of hematopoietic stem cell transplants (before engraftment and often long-term) - Patients receiving purine analogs (fludarabine, cladribine) or other immunosuppressive chemotherapy - HLA-matched or HLA-selected products - Directed donations from blood relatives - Patients receiving granulocyte transfusions
4.8 Septic Transfusion Reactions
The Mechanism
Bacterial contamination of blood products can cause severe sepsis when transfused.
Sources of contamination: - Donor bacteremia (asymptomatic at time of donation) - Skin flora introduced during phlebotomy - Environmental contamination during processing
Risk varies by product: - Platelets: Highest risk (stored at room temperature, which allows bacterial growth) - RBCs: Lower risk (stored cold; but certain organisms like Yersinia grow at 4°C) - Plasma: Lowest risk (frozen)
Common organisms: - Platelets: Skin flora (Staphylococcus, Streptococcus, Propionibacterium) and Gram-negatives - RBCs: Gram-negatives that grow at cold temperatures-Yersinia enterocolitica (classic board answer), Serratia, Pseudomonas
Clinical Presentation
- High fever (often >39°C)
- Rigors
- Hypotension (may be severe, septic shock)
- Tachycardia
- May have nausea, vomiting
- Symptoms often begin during or immediately after transfusion
Workup and Management
- Stop transfusion
- Blood cultures from patient AND from the product bag
- Gram stain of product
- Broad-spectrum antibiotics immediately (don’t wait for culture results)
- Supportive care for sepsis
Prevention
- Diversion pouches: First 30-40 mL of collection (most likely to contain skin flora) is diverted into a separate pouch not used for transfusion
- Bacterial testing of platelets: Culture-based or rapid detection methods
- Visual inspection of products before transfusion (discoloration, clumps, hemolysis)
- Limiting platelet storage duration
- Pathogen reduction technology: Treats platelets with UV light and photosensitizers to inactivate bacteria (and viruses)
4.9 Post-Transfusion Purpura (PTP)
The Mechanism
PTP is a rare but severe reaction occurring 5-12 days after transfusion, characterized by sudden, profound thrombocytopenia.
The patient (usually a multiparous woman or previously transfused individual) has antibodies to a platelet-specific antigen they lack-most commonly HPA-1a (formerly PlA1).
The paradox: The patient’s own platelets are HPA-1a negative, so why do they get destroyed?
Several theories: - Innocent bystander: Soluble HPA-1a antigen in transfused plasma adsorbs onto recipient platelets, which are then destroyed by anti-HPA-1a - Cross-reactive antibodies: Anti-HPA-1a somehow cross-reacts with an epitope on HPA-1a negative platelets - Autoantibody induction: Exposure triggers an autoantibody
Clinical Presentation
- Severe thrombocytopenia (often <10,000/μL)
- Purpura, petechiae
- May have mucosal bleeding, intracranial hemorrhage
- Self-limited (usually resolves in 1-4 weeks if patient survives)
Diagnosis
- Platelet-specific antibodies detected (anti-HPA-1a most common)
- Patient’s own platelets type negative for the corresponding antigen
Management
- High-dose IVIG (first-line; usually effective within days)
- Plasma exchange (if IVIG fails)
- Platelet transfusions are generally ineffective (transfused platelets are also destroyed)
- HPA-1a negative platelets may be tried if available
Chapter 5: Hemolytic Disease of the Fetus and Newborn (HDFN)
5.1 The Pathophysiology
HDFN occurs when maternal IgG alloantibodies cross the placenta and destroy fetal red blood cells. This requires:
- The mother is alloimmunized (has IgG antibodies to a red cell antigen she lacks)
- The fetus inherits the corresponding antigen from the father
- The maternal IgG crosses the placenta (IgG is the only immunoglobulin class that crosses; IgM does not)
- Maternal antibody binds fetal red cells
- Antibody-coated fetal red cells are destroyed (primarily in the fetal spleen)
The consequences depend on severity: - Mild: Hyperbilirubinemia requiring phototherapy - Moderate: Significant anemia, hydrops fetalis (extramedullary hematopoiesis causes hepatosplenomegaly; severe anemia causes high-output cardiac failure) - Severe: Fetal or neonatal death
5.2 Causes of HDFN
Anti-D (Rh HDFN)
Before RhIG prophylaxis, anti-D was the leading cause of severe HDFN, causing thousands of fetal and neonatal deaths annually.
Why D is so problematic: - Highly immunogenic (80% of D-negative individuals exposed to D-positive blood make anti-D) - Approximately 15% of Caucasians are D-negative, so mismatched pregnancies are common - Anti-D is almost always IgG
With RhIG prophylaxis, Rh HDFN has become rare, but still occurs when: - RhIG is not given or is given inadequately - Massive fetomaternal hemorrhage exceeds RhIG coverage - Alloimmunization occurred before RhIG was available
Anti-K (Kell HDFN)
Anti-K causes HDFN by a unique mechanism: in addition to hemolysis, anti-K suppresses fetal erythropoiesis. This is because Kell antigen is expressed on early erythroid progenitors.
Implications: - Anemia may be more severe than predicted by antibody titer or bilirubin - Reticulocyte count may be inappropriately low - Amniocentesis for bilirubin (ΔOD450) underestimates severity
Other Antibodies
- Anti-c: Can cause severe HDFN; second most common cause after anti-D
- Anti-E: Usually causes mild HDFN
- Anti-Fya, anti-Fyb: Can cause moderate HDFN
- Anti-Jka, anti-Jkb: Usually mild if any HDFN
ABO HDFN
ABO incompatibility between mother and fetus is very common (about 20% of pregnancies), but ABO HDFN is usually mild because: - A and B antigens are not fully developed on fetal red cells - Anti-A and anti-B are mostly IgM (don’t cross placenta); the IgG component is relatively weak - A and B antigens are widely distributed in tissues (not just red cells), so antibody is “absorbed” by other tissues
ABO HDFN: - Most common cause of HDFN overall (but most cases are mild) - Typically presents as neonatal jaundice requiring phototherapy - Rarely requires exchange transfusion - Can occur in the first pregnancy (unlike Rh HDFN, which usually requires prior sensitization) - DAT may be only weakly positive or negative (low antibody density on cells)
5.3 Prevention of Rh HDFN: RhIG
Rh immune globulin (RhIG) is one of the great success stories of modern medicine. It prevents Rh sensitization through a mechanism called antibody-mediated immune suppression-when passively administered anti-D coats fetal D-positive cells in the maternal circulation, those cells are cleared before they can stimulate the maternal immune system.
Timing of Administration
Antepartum (routine): - At 28 weeks gestation (covers the period when fetomaternal hemorrhage becomes more common)
Postpartum: - Within 72 hours of delivery of a D-positive or D-unknown infant - Can be given up to 28 days with some benefit, though earlier is better
After sensitizing events: - Amniocentesis, chorionic villus sampling - Abdominal trauma - External cephalic version - Miscarriage, ectopic pregnancy, abortion - Antepartum hemorrhage
Dosing
Standard dose: 300 μg (1500 IU) of RhIG
This covers approximately 15 mL of fetal red cells (30 mL of whole blood).
For larger fetomaternal hemorrhage (FMH), additional doses are needed.
Quantifying Fetomaternal Hemorrhage
Rosette test: Qualitative screen for FMH >10 mL fetal red cells. Uses anti-D to agglutinate D-positive fetal cells among D-negative maternal cells, forming rosettes around indicator D-positive cells.
If rosette screen is positive, quantify with:
Kleihauer-Betke (acid elution) test: Based on the principle that fetal hemoglobin (HbF) is resistant to acid elution, while adult hemoglobin (HbA) is not. - A maternal blood smear is treated with acid - Adult RBCs appear as “ghosts” (hemoglobin washed out) - Fetal RBCs remain pink (HbF retained) - Count fetal cells per maternal cells and calculate: - % fetal cells × maternal blood volume = volume of fetal blood - Divide by 30 mL to get number of RhIG doses needed
Flow cytometry: More precise method using anti-HbF antibodies. Increasingly used for FMH quantification.
5.4 Management of the Alloimmunized Pregnancy
Antibody Monitoring
Once alloimmunization is detected: - Determine antibody specificity and titer - Determine the father’s antigen status and zygosity (is the fetus at risk?) - If father is antigen-negative: Fetus is not at risk - If father is homozygous positive: Fetus is definitely at risk - If father is heterozygous: 50% chance fetus is at risk → consider fetal testing - Cell-free fetal DNA testing can determine fetal antigen status from maternal blood
Titer Monitoring
If the fetus is at risk: - Monitor antibody titers every 2-4 weeks - “Critical titer” (varies by laboratory, typically 16-32): Above this level, significant HDFN is possible - Below critical titer: Continue monitoring - At or above critical titer: Move to MCA Doppler monitoring
Fetal Monitoring
Middle Cerebral Artery (MCA) Doppler: Non-invasive assessment of fetal anemia - In anemic fetuses, cardiac output increases (to compensate) and blood viscosity decreases, resulting in increased blood flow velocity - MCA peak systolic velocity >1.5 MoM (multiples of the median for gestational age) suggests moderate to severe anemia - Serial MCA Doppler measurements guide decision-making about intervention
Amniocentesis: Historical method using ΔOD450 (optical density deviation at 450nm, indicating bilirubin level). Now largely replaced by MCA Doppler.
Fetal Intervention
Intrauterine transfusion (IUT): Direct transfusion of red cells to the fetus - Usually intravascular (into umbilical vein under ultrasound guidance) - Uses O-negative (or antigen-negative), irradiated, CMV-safe, leukoreduced, fresh RBCs - Hematocrit targeted to be high (80-85%) since volume is limited - May need to be repeated every 1-3 weeks until delivery
5.5 Neonatal Management
Assessment at Birth
- Cord blood: ABO/Rh type, DAT, hemoglobin/hematocrit, bilirubin
- Evaluate for hydrops (edema, ascites, pleural effusions)
Treatment of Hyperbilirubinemia
Phototherapy: First-line treatment - Blue light (wavelength 460-490 nm) converts unconjugated bilirubin to water-soluble photoisomers that can be excreted without conjugation - Threshold for treatment depends on gestational age, age in hours, and risk factors
Exchange transfusion: For severe cases unresponsive to phototherapy, or when bilirubin levels approach dangerous thresholds - Removes antibody-coated red cells, free antibody, and bilirubin - Replaces with antigen-negative, compatible red cells - Usually “double volume exchange” (twice the infant’s blood volume, ~170 mL/kg) - Uses O-negative (or specifically antigen-negative), irradiated, CMV-safe red cells
IVIG: May reduce need for exchange transfusion by blocking Fc receptors on macrophages, reducing hemolysis
5.6 Neonatal Alloimmune Thrombocytopenia (NAIT)
NAIT is the platelet equivalent of HDFN-maternal antibodies against fetal platelet antigens cause fetal/neonatal thrombocytopenia. However, there are critical differences that make NAIT more dangerous in some ways.
Pathophysiology
The mechanism parallels HDFN: 1. The fetus inherits a platelet antigen from the father that the mother lacks 2. Fetomaternal hemorrhage exposes the mother to fetal platelets 3. The mother develops IgG antibodies against the foreign platelet antigen 4. Maternal IgG crosses the placenta and destroys fetal platelets
The critical difference from HDFN: NAIT often affects the FIRST pregnancy. Unlike Rh HDFN, which requires prior sensitization, the amount of fetal platelets reaching maternal circulation during pregnancy is sufficient to cause sensitization and antibody production within the same pregnancy. About 50% of NAIT cases occur in first pregnancies.
The HPA System
Human Platelet Antigens (HPAs) are polymorphisms in platelet membrane glycoproteins. The most important are:
| Antigen | Glycoprotein | Clinical Significance |
|---|---|---|
| HPA-1a (PlA1) | GPIIIa (integrin β3) | Causes ~80% of NAIT cases |
| HPA-1b (PlA2) | GPIIIa | Antithetical to HPA-1a |
| HPA-5b (Bra) | GPIa (integrin α2) | Second most common cause |
| HPA-3a | GPIIb | Less common |
| HPA-4a | GPIIIa | Rare |
HPA-1a incompatibility is the classic scenario: - Mother is HPA-1a negative (HPA-1b/1b)-about 2% of Caucasians - Father is HPA-1a positive - Fetus inherits HPA-1a from father - Mother makes anti-HPA-1a
Clinical Presentation
Fetal/neonatal thrombocytopenia: Can be severe (<20,000/μL)
Intracranial hemorrhage (ICH): The devastating complication - Occurs in 10-20% of NAIT cases with severe thrombocytopenia - Can occur in utero (unlike HDFN, where severe anemia is the main fetal risk) - Leads to death or permanent neurological damage - ICH can occur as early as 16-20 weeks gestation
Petechiae, purpura, bleeding: At birth
Unlike HDFN: There is no readily available screening test or prophylaxis equivalent to RhIG. NAIT is usually diagnosed AFTER an affected baby is born.
Diagnosis
Clinical suspicion: Unexplained neonatal thrombocytopenia, especially if severe and in an otherwise healthy full-term infant
Laboratory confirmation: - Maternal platelet antigen typing (HPA genotyping) - Paternal platelet antigen typing - Detection of maternal anti-platelet antibodies (MAIPA-monoclonal antibody immobilization of platelet antigens) - Confirmation of incompatibility between maternal and fetal platelet types
Differential diagnosis: - Neonatal sepsis - Congenital infection (TORCH) - Maternal ITP (autoantibodies, not alloantibodies; affects mother too) - Congenital thrombocytopenia syndromes
Management
Affected neonate: - Platelet transfusion: Ideally with HPA-compatible platelets (antigen-negative for the implicated antigen) - If HPA-typed platelets unavailable, random donor platelets may provide partial, temporary increment - Maternal platelets can be washed (to remove antibody-containing plasma) and irradiated-they lack the offending antigen - IVIG: May raise platelet count by blocking Fc receptors on macrophages
Subsequent pregnancies (recurrence risk 75-90% with 50% chance of more severe disease): - Fetal blood sampling to monitor platelet count (high-risk procedure) - Maternal IVIG during pregnancy (may improve fetal platelet count) - Intrauterine platelet transfusions if severe thrombocytopenia - Early delivery if severe, to enable postnatal treatment - Cesarean section may be recommended to avoid birth trauma if platelet count is very low
Key Differences: NAIT vs. HDFN
| Feature | NAIT | HDFN |
|---|---|---|
| Target cells | Platelets | Red blood cells |
| Most common antibody | Anti-HPA-1a | Anti-D |
| First pregnancy affected | Yes (~50%) | Rarely (requires prior sensitization) |
| In utero bleeding risk | High (ICH) | Low |
| Prophylaxis available | No | Yes (RhIG) |
| Screening | Not routine | Routine (blood type) |
| Severity in subsequent pregnancies | Often worse | Often worse |
Chapter 6: Autoimmune Hemolytic Anemia (AIHA)
Before discussing the specific types of AIHA, it’s essential to understand how to distinguish intravascular from extravascular hemolysis in the laboratory-a distinction that has direct clinical implications.
Laboratory Differentiation of Hemolysis Types
| Finding | Intravascular Hemolysis | Extravascular Hemolysis |
|---|---|---|
| Primary site | Bloodstream (complement-mediated) | Spleen/liver (RES macrophages) |
| Haptoglobin | ↓↓ (absent-saturated by free Hgb) | ↓ (moderate decrease) |
| LDH | ↑↑ (marked elevation) | ↑ (moderate elevation) |
| Indirect bilirubin | ↑ | ↑ |
| Hemoglobinemia | Present (pink/red plasma) | Absent |
| Hemoglobinuria | Present (dark urine, + blood dipstick, no RBCs) | Absent |
| Hemosiderinuria | Present (late finding) | Absent |
| Spherocytes | Variable | Often present (from partial phagocytosis) |
Clinical correlation: Intravascular hemolysis releases free hemoglobin directly into plasma, which saturates haptoglobin (causing it to disappear), is filtered by kidneys (hemoglobinuria), and can cause renal tubular injury. Extravascular hemolysis occurs when macrophages remove antibody-coated or damaged cells intact; the hemoglobin is metabolized inside cells to bilirubin, never reaching plasma as free hemoglobin.
6.1 Warm Autoimmune Hemolytic Anemia

Pathophysiology
In warm AIHA, the patient’s immune system produces IgG autoantibodies that bind to their own red blood cells at body temperature (37°C). These antibody-coated red cells are recognized by Fcγ receptors on splenic macrophages and destroyed-primarily through partial phagocytosis, which creates spherocytes.
Why are spherocytes formed? When a macrophage “bites” a piece of antibody-coated red cell membrane but the cell escapes, the remaining cell has reduced surface area but the same volume. It becomes spherical-the shape with the lowest surface area-to-volume ratio. These spherocytes are rigid and become trapped in the splenic cords, leading to further destruction.
Causes
- Primary (idiopathic): ~50% of cases; no underlying cause identified
- Secondary:
- Lymphoproliferative disorders (CLL, lymphoma)
- Autoimmune diseases (SLE, rheumatoid arthritis)
- Drugs (methyldopa, fludarabine)
- Infections
Laboratory Findings
- Evidence of hemolysis: ↓ Hgb, ↑ reticulocytes, ↑ LDH, ↑ indirect bilirubin, ↓ haptoglobin
- Spherocytes on peripheral smear
- DAT positive: Usually IgG positive (±C3)
- Antibody screen and panel may be positive (autoantibody reacts with all cells)
Blood Bank Challenges
Finding compatible blood for warm AIHA patients can be difficult: - Autoantibody may react with all cells in the antibody screen - Must rule out underlying alloantibodies (patients with AIHA often have alloantibodies from prior transfusions) - Use autoadsorption or alloadsorption to remove autoantibody and unmask alloantibodies
Autoadsorption: Patient’s own cells (warmed to elute autoantibody, then used to adsorb remaining autoantibody from serum). Cannot be used if patient was recently transfused.
Alloadsorption: R1R1, R2R2, and rr cells used to adsorb autoantibody while preserving alloantibodies of those specificities.
Treatment
- Corticosteroids: First-line; prednisone 1-1.5 mg/kg/day
- Rituximab: Anti-CD20; often second-line
- Splenectomy: Removes primary site of red cell destruction
- Immunosuppressants: Azathioprine, mycophenolate, etc.
- Transfusion: When needed, give “least incompatible” blood; don’t withhold blood for life-threatening anemia because you can’t find compatible blood
6.2 Cold Agglutinin Disease (CAD)

Pathophysiology
In CAD, the patient has IgM autoantibodies (cold agglutinins) that bind to red cells at temperatures below body temperature. The classic antibody is anti-I, which binds to the I antigen (a carbohydrate structure on adult red cells).
The mechanism of hemolysis: 1. Blood flows through cool peripheral tissues (fingers, toes, ears, nose) 2. IgM binds to red cells in the cold and activates complement (C1 through C3) 3. Blood returns to warm central circulation; IgM dissociates (poor binding at 37°C) 4. Complement activation stops at C3b (regulatory proteins prevent progression to MAC) 5. C3b-coated red cells are recognized by complement receptors on hepatic macrophages 6. Red cells are destroyed in the liver (extravascular hemolysis) or converted to spherocytes 7. Some intravascular hemolysis occurs if complement proceeds to C5-9
Causes
- Primary: Clonal B-cell disorder producing monoclonal IgM cold agglutinin
- Secondary:
- Mycoplasma pneumoniae infection (produces anti-I; typically polyclonal, transient)
- EBV infection (may produce anti-i, targeting fetal-type antigen)
- Lymphoproliferative disorders
Laboratory Findings
- DAT: C3d positive, IgG negative (IgM dissociates during washing)
- May see red cell agglutination at room temperature (must warm sample to get accurate CBC)
- Cold agglutinin titer (significant if ≥64 at 4°C)
- Thermal amplitude (temperature range of reactivity) determines clinical significance-wider amplitude = worse disease
Blood Bank Challenges
Cold agglutinins interfere with testing: - May cause ABO discrepancies (agglutination in reverse typing) - May cause positive antibody screen at room temperature
Solutions: - Keep samples warm (37°C) - Pre-warm technique for crossmatching - Identify underlying alloantibodies using pre-warmed or enzyme-treated cells
Treatment
- Avoid cold exposure (most important)
- Corticosteroids are usually ineffective
- Rituximab (targets the B-cell clone)
- Splenectomy is not helpful (destruction is primarily hepatic)
- Complement inhibitors (sutimlimab) recently approved
- Transfuse through blood warmer if needed
6.3 Paroxysmal Cold Hemoglobinuria (PCH)
Pathophysiology
PCH is caused by the Donath-Landsteiner antibody, an unusual IgG that binds red cells at cold temperatures, fixes complement, and causes intravascular hemolysis when blood warms.
The antibody has anti-P specificity (reacts with P antigen, present on nearly everyone’s red cells).
The biphasic nature: 1. In cold (peripheral circulation): IgG antibody binds red cells and fixes complement through C3 2. Blood warms (central circulation): Complement cascade proceeds to MAC, causing intravascular hemolysis
Why doesn’t the IgG stay bound? The Donath-Landsteiner antibody has very low affinity at warm temperatures and rapidly dissociates.
Clinical Context
PCH occurs in two settings: 1. Children following viral infections (most cases today)-typically self-limited 2. Adults with syphilis (historical association; rare today)
Laboratory Findings
- DAT: C3d positive only (similar to CAD)
- Donath-Landsteiner test: Demonstrates biphasic hemolysis
- Incubate patient serum with red cells at 4°C (antibody binds, fixes complement)
- Warm to 37°C (lysis occurs)
- Control tubes at only 4°C or only 37°C do not lyse
Treatment
- Usually supportive; self-limited in children
- Keep patient warm
- Transfusion if needed (difficult to find P-negative blood; use standard compatible blood through warmer)
6.4 Drug-Induced Hemolytic Anemia
Drugs can cause a positive DAT and hemolytic anemia through several mechanisms:
Drug Adsorption (Hapten) Mechanism
- Classic example: Penicillin
- Drug binds tightly to red cell membrane
- Antibody is directed against the drug (not the red cell)
- Only drug-coated cells are destroyed
- DAT: IgG positive
- Requires high-dose drug therapy
- Resolves when drug is stopped
Immune Complex (Innocent Bystander) Mechanism
- Examples: Quinidine, quinine, certain NSAIDs
- Drug-antibody immune complexes form in plasma
- Complexes bind to red cells and activate complement
- DAT: Usually C3 positive (IgG may be positive too)
- Can cause severe intravascular hemolysis
- Low drug doses can trigger reaction
Autoantibody Induction
- Classic example: Methyldopa (also fludarabine, procainamide)
- Drug induces true autoantibodies (not drug-dependent)
- Autoantibodies react with red cells even without drug present
- DAT: IgG positive
- Mechanism unknown (possibly alteration of self-antigens or immune dysregulation)
- Hemolysis may persist after drug is stopped (autoantibodies take time to disappear)
Membrane Modification (Non-immune)
- Examples: Cephalosporins
- Drug modifies red cell membrane to nonspecifically adsorb proteins (including immunoglobulins)
- DAT: May be positive for IgG and/or C3
- No true antibody-mediated hemolysis
- Positive DAT without hemolysis
Chapter 7: Apheresis
7.1 Principles of Apheresis
Apheresis (from Greek “to take away”) refers to procedures that separate blood components, removing one component while returning the rest to the patient/donor.
Separation Technologies
Centrifugation-based: Most common. Blood flows into a spinning bowl or channel where components separate by density: - Plasma (least dense, innermost layer) - Platelets and buffy coat (middle) - Red cells (most dense, outermost layer)
Membrane filtration: Used for plasmapheresis. Plasma passes through a membrane while cells are retained.
7.2 Therapeutic Apheresis
Therapeutic Plasma Exchange (TPE)
In TPE, the patient’s plasma is removed and replaced with a replacement fluid (albumin solution or FFP).
Mechanism of action: Removes pathogenic substances from the plasma: - Autoantibodies - Alloantibodies - Immune complexes - Paraproteins - Toxins bound to plasma proteins
Kinetics: Each plasma volume exchange removes approximately 63% of an intravascular substance. After 1-1.5 plasma volumes: - First exchange: Removes ~63% - Second exchange: Removes 63% of remaining → total 86% - Third exchange: → total 95%
However, substances re-equilibrate from extravascular space, so serial exchanges are needed.
Replacement fluids: - Albumin (5%): Preferred in most cases. Doesn’t transmit infection. Doesn’t replace coagulation factors (may need FFP if patient is bleeding or before invasive procedures). - FFP: Required for TTP (provides ADAMTS13). Used when coagulation factor replacement is needed.
Indications (ASFA Category I-first-line treatment): - TTP (Thrombotic Thrombocytopenic Purpura): Removes anti-ADAMTS13 antibodies, provides functional ADAMTS13 - Myasthenia gravis (acute exacerbation): Removes anti-acetylcholine receptor antibodies - Guillain-Barré syndrome: Removes pathogenic antibodies - ANCA-associated vasculitis (severe): Removes ANCA - Anti-GBM disease (Goodpasture): Removes anti-glomerular basement membrane antibodies - Hyperviscosity syndrome: Rapidly reduces paraprotein levels
Complications: - Citrate toxicity (hypocalcemia): Citrate used as anticoagulant binds calcium. Symptoms include paresthesias, muscle cramps, and in severe cases, arrhythmias. Treat with calcium supplementation. - Hypotension: From volume shifts. More common with FFP replacement (allergic reactions). - Coagulopathy: Removal of clotting factors (if albumin replacement used) - Allergic reactions: Especially with FFP - Line complications: Infection, thrombosis, pneumothorax
Cytapheresis Procedures
Leukapheresis: Removal of white blood cells - Indication: Hyperleukocytosis in leukemia (WBC >100,000/μL with symptoms) - Goal: Rapidly reduce WBC count while definitive chemotherapy takes effect - Symptomatic relief of leukostasis (pulmonary, neurologic)
Plateletpheresis: Removal of platelets - Indication: Symptomatic thrombocytosis (usually platelets >1 million with ischemic symptoms) - Provides temporary reduction while medications take effect
Erythrocytapheresis (Red Cell Exchange): Removal of patient’s red cells and replacement with donor red cells - Sickle cell disease: Rapidly reduces HbS percentage; first-line for acute chest syndrome, stroke - Severe malaria: Reduces parasitemia rapidly - Polycythemia vera: Alternative to phlebotomy
Photopheresis (Extracorporeal Photochemotherapy): - White cells are collected, treated with psoralen (photosensitizing agent) and UVA light, then returned - Mechanism: Induces apoptosis of treated lymphocytes, modulates immune response - Indications: Cutaneous T-cell lymphoma (mycosis fungoides/Sézary syndrome), chronic GVHD, solid organ transplant rejection
Chapter 8: Special Clinical Situations in Transfusion Medicine
8.1 Massive Transfusion
Definition: Replacement of one or more blood volumes within 24 hours (approximately 10 units of RBCs in a 70 kg adult), or transfusion of more than 4 units in one hour with ongoing bleeding.
The Pathophysiology of Coagulopathy in Massive Hemorrhage
Massive hemorrhage creates a “deadly triad” that drives coagulopathy:
Hypothermia: Blood stored at 4°C, large-volume cold crystalloid resuscitation, and exposed body cavities all lower core temperature. At 34°C, enzymatic activity of coagulation factors is reduced by ~25%; at 32°C, by ~50%. Hypothermia also impairs platelet function.
Acidosis: Tissue hypoperfusion leads to anaerobic metabolism and lactic acidosis. At pH 7.2, the activity of the Xa/Va prothrombinase complex is reduced by 50%; at pH 7.0, by 70%.
Dilution: Resuscitation with crystalloids and RBCs (which contain no plasma or platelets) dilutes the patient’s remaining clotting factors and platelets. After replacement of one blood volume (~10 units RBCs), only ~35% of original plasma and platelets remain.
These three factors compound each other-hypothermia worsens acidosis, acidosis impairs clotting, and dilution exacerbates both problems.
Trauma-induced coagulopathy: In trauma patients, coagulopathy often begins before resuscitation, driven by tissue injury, shock, and activation of the protein C pathway. This “acute coagulopathy of trauma” causes fibrinolysis and factor depletion independent of dilution.
Massive Transfusion Protocols (MTP)
Modern MTPs aim to replace blood components in ratios approximating whole blood, preventing dilutional coagulopathy:
Ratio-based approach: - Typical ratios: 1:1:1 (RBC:FFP:platelets in units) or 1:1:2 - The PROPPR trial (JAMA 2015) found 1:1:1 achieved hemostasis faster than 1:1:2, with trends toward improved survival - Practical implementation: After every 4-6 units of RBCs, give 4-6 units of plasma and 1 apheresis platelet dose
Goal-directed approach (when labs are available): - Hematocrit <30%: Transfuse RBCs - INR >1.5 or aPTT >1.5× normal: Transfuse FFP (10-15 mL/kg) - Platelets <50,000/μL: Transfuse platelets - Fibrinogen <100-150 mg/dL: Transfuse cryoprecipitate (10 units)
Adjuncts: - Tranexamic acid: Antifibrinolytic; the CRASH-2 trial showed mortality benefit in trauma patients when given within 3 hours of injury (1g IV bolus, then 1g over 8 hours) - Calcium: Citrate in blood products chelates calcium; ionized calcium <1.0 mmol/L impairs coagulation. Replace with calcium gluconate. - Warm all products: Use blood warmers to prevent exacerbating hypothermia
Complications of Massive Transfusion
Citrate toxicity and hypocalcemia: Citrate anticoagulant chelates calcium. The liver normally metabolizes citrate quickly, but in massive transfusion (especially with liver dysfunction, hypothermia, or shock), citrate accumulates. Symptoms: perioral tingling, muscle cramps, prolonged QT, hypotension. Monitor ionized calcium and replace.
Hyperkalemia: RBCs leak potassium during storage (up to 50 mEq/L supernatant K+ in a 42-day unit). Usually clinically insignificant because the volume of supernatant is small and potassium is rapidly taken up by tissues. However, in massive transfusion of older units, rapid infusion, or renal failure, hyperkalemia can occur. Risk is higher with irradiated units (accelerated K+ leak).
Metabolic alkalosis: Counterintuitively, despite the acidic pH of stored blood, massive transfusion often causes alkalosis. Citrate is metabolized to bicarbonate by the liver. Each unit of blood contains ~17 mEq of citrate, which generates bicarbonate.
8.2 Sickle Cell Disease and Transfusion
Patients with sickle cell disease require special transfusion considerations due to their unique pathophysiology and chronic transfusion needs.
Goals of Transfusion in Sickle Cell Disease
Simple transfusion: Adds normal (HbA) red cells without removing HbS cells. Increases oxygen-carrying capacity but also increases blood viscosity. Appropriate for: - Symptomatic anemia - Aplastic crisis - Splenic sequestration
Exchange transfusion (red cell exchange): Removes HbS-containing cells and replaces with normal cells. Reduces HbS percentage without increasing viscosity. Appropriate for: - Acute stroke (first-line treatment) - Acute chest syndrome (severe) - Pre-operative preparation for high-risk surgery - Chronic transfusion for stroke prevention
Target HbS percentage: - Acute stroke: <30% - Chronic stroke prevention: <30% - Pre-operative: <30% for major surgery - Acute chest syndrome: Clinician judgment
Special Considerations
Alloimmunization: Sickle cell patients have high rates of red cell alloimmunization (20-50%) due to: - Chronic transfusion exposure - Antigenic differences between primarily Caucasian donor pool and African American patient population - Inflammatory state promoting immune responses
Prevention strategies: - Prophylactic matching for Rh (C, E) and Kell antigens at minimum - Extended phenotype matching for Duffy, Kidd, and other antigens in heavily transfused patients - Use of African American donors when possible
Delayed hemolytic transfusion reaction (DHTR): More common and more severe in sickle cell patients. May present as “hyperhemolysis syndrome”-destruction of both transfused and autologous red cells, with hematocrit dropping below pre-transfusion baseline. Treatment: avoid further transfusion if possible, IVIG, steroids, possibly eculizumab.
8.3 Platelet Refractoriness
Definition: Failure to achieve expected platelet increment after transfusion. Operationally defined as corrected count increment (CCI) <7,500 at 10-60 minutes post-transfusion on two consecutive occasions.
CCI Calculation: CCI = (Post-transfusion count - Pre-transfusion count) × BSA (m²) / Platelets transfused (× 10^11)
Expected CCI at 1 hour: >7,500 (indicates platelet survival) Expected CCI at 24 hours: >4,500 (indicates platelet function)
Causes of Platelet Refractoriness
Non-immune causes (more common, ~80%): - Fever, sepsis (increased consumption) - Splenomegaly (sequestration) - DIC (consumption) - Bleeding (consumption) - Medications (amphotericin B, vancomycin) - TTP/HUS
Immune causes (~20%): - HLA alloimmunization (most common immune cause): Antibodies to HLA Class I antigens on donor platelets. Develops from pregnancy, prior transfusions with non-leukoreduced products, or transplantation. - HPA antibodies: Antibodies to platelet-specific antigens (rare) - ABO incompatibility: Contributes modestly to poor increments
Evaluation and Management
Step 1: Confirm refractoriness with ABO-identical platelets and measure CCI properly (1-hour post-transfusion count).
Step 2: Identify and treat non-immune causes (the most common causes).
Step 3: If immune cause suspected, test for HLA antibodies (panel reactive antibody, PRA).
Step 4: Management of HLA alloimmunization: - HLA-matched platelets: Match patient HLA type with donor HLA type. Graded by match quality (A = 4-antigen match; B = 3-antigen match with crossreactive group compatibility). - Crossmatch-compatible platelets: Test patient serum against donor platelets directly; use compatible units. - HLA antibody testing with single antigen beads: Identifies specific antibodies; select donors lacking those antigens.
Prevention: Universal leukoreduction significantly reduces HLA alloimmunization rates (the TRAP trial showed reduction from 13% to 3%).
Chapter 9: Infectious Disease Testing in Blood Donors
9.1 The Testing Algorithm
Every blood donation in the United States undergoes mandatory testing for:
- HIV-1/2: Antibody screening AND nucleic acid testing (NAT)
- Hepatitis B: HBsAg, anti-HBc, AND NAT
- Hepatitis C: Anti-HCV AND NAT
- HTLV-I/II: Antibody screening
- Syphilis: Serological testing (RPR or treponemal assay)
- West Nile Virus: NAT
- Zika virus: NAT (in endemic areas/periods)
- Trypanosoma cruzi (Chagas disease): Antibody screening (one-time test)
- Babesia: NAT or antibody (in endemic areas)
9.2 Nucleic Acid Testing (NAT)
NAT revolutionized blood safety by dramatically reducing the “window period”-the time between infection and detectability.
Window period comparison:
| Agent | Antibody Detection | NAT Detection |
|---|---|---|
| HIV | ~22 days | ~9 days |
| HCV | ~70 days | ~7 days |
| HBV | ~38 days (HBsAg) | ~20-25 days |
NAT methodology: - PCR or transcription-mediated amplification (TMA) - Detects viral nucleic acid directly - Can be performed on individual donations (ID-NAT) or minipools (MP-NAT) - ID-NAT is more sensitive; MP-NAT is more cost-effective
9.3 Understanding the Tests
HIV Testing
- 4th generation assay: Detects both HIV-1/2 antibodies AND p24 antigen
- NAT: Detects HIV RNA
- If screening is reactive, supplemental testing (HIV-1/2 differentiation assay) is performed
- NAT may detect acute infection before antibody develops
Hepatitis B Testing
The three-test combination is designed to catch different phases of infection: - HBsAg: Acute or chronic infection - Anti-HBc: Ever infected (current or resolved) - NAT: Detects HBV DNA; catches occult HBV infection (HBsAg negative but still viremic)
Hepatitis C Testing
- Anti-HCV: Ever infected
- NAT: Current viremia (active infection)
The combination catches both active infection (NAT positive) and window-period infections that are antibody-negative but NAT-positive.
Syphilis Testing
Blood centers use either: - Non-treponemal test (RPR): Traditional screening; may miss early infection - Treponemal test (EIA/CIA): More sensitive; used in reverse algorithm
Syphilis is treatable, and transfusion-transmitted syphilis is extremely rare (the spirochete is fragile and doesn’t survive storage), but testing remains required.
9.4 Donor Deferral and Lookback
Repeat reactive: If a donor tests reactive on repeat testing, the donation is discarded, and the donor is notified and deferred.
Supplemental testing: Determines true-positive vs. false-positive; guides donor counseling and deferral duration.
Lookback: If a donor is found positive, previous donations are traced, and recipients are notified.
Chapter 10: HLA and Platelet/Leukocyte Immunology
The HLA (Human Leukocyte Antigen) system is the human major histocompatibility complex-the most polymorphic genetic system in the body. Understanding HLA is essential for blood banking because HLA antibodies cause platelet refractoriness, TRALI, and TA-GVHD.
10.1 HLA Biology: Why It Matters
What HLA molecules do: HLA molecules present peptide antigens to T cells, enabling the adaptive immune system to recognize foreign proteins. The extreme polymorphism (thousands of alleles) evolved to ensure that the population can respond to diverse pathogens. However, this polymorphism creates problems in transfusion and transplantation-foreign HLA molecules are highly immunogenic.
Class I vs. Class II HLA molecules: This distinction has direct clinical implications.
HLA Class I (A, B, C) molecules are expressed on virtually all nucleated cells, including platelets. They present intracellular peptides (from self proteins or intracellular pathogens) to CD8+ T cells. Antibodies to Class I HLA cause platelet refractoriness because platelets express Class I.
HLA Class II (DR, DQ, DP) molecules are expressed primarily on antigen-presenting cells (dendritic cells, macrophages, B cells). They present extracellular peptides to CD4+ T cells. Class II expression can be induced on other cells during inflammation.
HLA inheritance: Each person inherits one HLA haplotype from each parent-a set of linked HLA genes on chromosome 6 that are inherited as a block. This explains why siblings have a 25% chance of being HLA-identical (sharing both haplotypes), which is critical for stem cell transplant donor selection.
10.2 HLA Antibodies: How They Form and What They Cause
Sensitizing events: HLA antibodies develop after exposure to foreign HLA antigens. The three main sensitizing events are:
Pregnancy: The fetus expresses paternal HLA antigens, which the mother’s immune system sees as foreign. About 30% of multiparous women have HLA antibodies. This is why female donors are more likely to have HLA antibodies that can cause TRALI.
Transfusion: Cellular blood products (RBCs before universal leukoreduction, platelets) expose recipients to donor HLA antigens. This is why leukoreduction reduces HLA alloimmunization.
Transplantation: Patients who reject a transplant typically develop strong HLA antibodies.
Clinical consequences of HLA antibodies:
Platelet refractoriness: Class I HLA antibodies bind to donor platelets and cause their rapid destruction. This is the most common immune cause of poor platelet increments. Management requires HLA-matched platelets (selected to be compatible with the patient’s antibodies) or crossmatch-compatible platelets.
TRALI: Donor HLA antibodies (in plasma-containing products) can bind to recipient neutrophils and trigger the pulmonary capillary leak that causes TRALI. This is why plasma is now preferentially collected from male donors or HLA antibody-negative female donors.
TA-GVHD: When the recipient cannot reject donor T cells, those T cells attack recipient tissues. The risk is highest when the donor is HLA-homozygous for a haplotype the recipient is heterozygous for-the recipient’s immune system sees the donor cells as “self.”
10.3 HLA Testing Methods
Serological typing: The historical method. Serum containing known HLA antibodies is mixed with patient lymphocytes, and cell death (via complement-dependent cytotoxicity) indicates a positive reaction. Serological typing identifies HLA antigens at the antigen level (e.g., HLA-A2) but cannot distinguish between allelic variants.
Molecular typing: DNA-based methods have replaced serology for most applications because they’re more accurate and can resolve allelic differences.
Low-resolution typing (antigen level): Identifies the antigen group (e.g., HLA-A*02). Used for platelet matching and initial transplant workup.
High-resolution typing (allele level): Identifies the specific allele (e.g., HLA-A*02:01). Required for unrelated donor hematopoietic stem cell transplantation, where even allelic mismatches increase graft-versus-host disease risk.
HLA antibody detection: Solid-phase assays (using beads coated with purified HLA molecules) have replaced complement-dependent cytotoxicity. Luminex-based single-antigen bead assays can identify antibody specificity precisely, which is essential for: - Selecting compatible platelets for refractory patients - Identifying “unacceptable antigens” for solid organ transplant candidates - Virtual crossmatching in transplantation
10.4 Clinical Applications
Platelet matching for refractory patients: When a patient has documented HLA antibodies causing platelet refractoriness:
- HLA type the patient (Class I antigens)
- Identify antibody specificities using single-antigen bead testing
- Select donors who lack the antigens the patient has antibodies against
- Alternatively, perform crossmatch testing between patient serum and potential donor platelets
TRALI mitigation: Blood centers now preferentially collect plasma from: - Male donors (never pregnant) - Female donors tested negative for HLA antibodies
This strategy has significantly reduced TRALI incidence.
Stem cell transplant donor selection: The degree of HLA matching required depends on transplant type: - Sibling donors: HLA-identical (matched at HLA-A, -B, -C, -DR) preferred - Unrelated donors: 8/8 or 10/10 allele-level match at HLA-A, -B, -C, -DRB1 (and often DQB1) - Cord blood: Can tolerate more mismatching due to naïve T cell populations
Chapter 11: Blood Bank Quality and Regulation
11.1 Regulatory Framework
FDA (Food and Drug Administration)
- Blood is regulated as a drug and a biologic
- Blood establishments must register with FDA and comply with Current Good Manufacturing Practice (cGMP)
- Reporting requirements: Deaths related to transfusion must be reported within 24 hours
- Inspects blood establishments (usually every 2 years)
AABB (formerly American Association of Blood Banks)
- Voluntary accreditation organization
- Sets standards that often exceed FDA requirements
- Accreditation requires biennial inspection
State regulations
- Some states have additional requirements (New York is notably stringent)
CLIA (Clinical Laboratory Improvement Amendments)
- Covers laboratory testing aspects of blood banking
11.2 Quality Control Requirements
Reagent QC: - Anti-A, anti-B, anti-D: Tested each day of use with known positive and negative cells - AHG: Each batch tested with IgG-sensitized cells (Coombs control cells) - Reagent red cells: Verified for expected antigen expression
Component QC: - Random sample testing to verify quality - Red cells: Hematocrit, residual WBC count (if leukoreduced) - Platelets: Platelet count, pH (must be >6.2 at outdate), residual WBC count - Plasma: Factor VIII activity, volume
Temperature monitoring: - Continuous monitoring of storage equipment - Alarms for out-of-range temperatures - Documentation of corrective action
11.3 Blood Administration Safety
Critical steps to prevent transfusion to the wrong patient:
- Positive patient identification: Two independent identifiers at sample collection and at transfusion
- Sample labeling: At bedside, immediately after collection
- Verification at transfusion: Confirm unit identification matches patient identification
- Clerical check: Most common cause of fatal transfusion reactions is clerical error (wrong blood to wrong patient)
PART II: CLINICAL CHEMISTRY AND IMMUNOPATHOLOGY
Clinical chemistry is the laboratory discipline that measures chemical substances in body fluids to aid in diagnosis, treatment, and monitoring of disease. It bridges biochemistry and clinical medicine, requiring understanding of both analytical methods and pathophysiology.
Chapter 12: Laboratory Principles and Quality Control
12.1 Pre-analytical Variables: Where Most Errors Occur
Studies consistently show that 60-70% of laboratory errors occur in the pre-analytical phase-before the sample ever reaches the analyzer. Understanding pre-analytical variables is essential.
Specimen Collection Tubes
Each tube type serves a specific purpose:
Red top (no additive): Blood clots; after centrifugation, you have serum (liquid portion without clotting factors). Used for most chemistry tests, serology.
Gold top/SST (serum separator tube): Contains clot activator and gel separator. After centrifugation, gel barrier separates serum from cells, allowing longer stability.
Light blue (sodium citrate): Anticoagulant for coagulation testing. Citrate chelates calcium, preventing clotting while preserving factor activity. The 9:1 ratio of blood to citrate is critical-underfilling or overfilling changes the ratio and affects results.
Lavender/purple (EDTA): Anticoagulant that chelates calcium. Used for CBC (preserves cell morphology) and HbA1c. Not suitable for chemistry (EDTA interferes with many assays).
Green (heparin): Anticoagulant for stat chemistry (faster since no clotting time needed) and special tests (ammonia, ionized calcium, flow cytometry).
Gray (sodium fluoride/potassium oxalate): Fluoride inhibits glycolysis, preserving glucose. Oxalate is the anticoagulant. Used for glucose and lactate.
Royal blue (trace element tube): Special low-metal tube for trace element testing. May contain EDTA or no additive depending on test.
Order of Draw
When collecting multiple tubes from a single venipuncture, the order matters to prevent additive carryover:
- Blood culture bottles (sterile)
- Light blue (citrate)-must be first anticoagulated tube; contamination with other additives affects coag results
- Red/Gold (serum)
- Green (heparin)
- Lavender (EDTA)
- Gray (fluoride)
The mnemonic: Blood Banks Require Good Lab Guidelines (Blue, Blue [culture], Red, Green, Lavender, Gray)
Hemolysis: The Most Common Preanalytical Problem
Hemolysis is the rupture of red blood cells, releasing their contents into serum/plasma.
Causes: - Traumatic blood draw (too small needle, too much vacuum, frothing) - Prolonged tourniquet time - Vigorous mixing of sample - Transport problems (extreme temperatures, pneumatic tube trauma) - In vivo hemolysis (the patient actually has hemolysis)
Effects on laboratory tests:
| Analyte | Effect of Hemolysis | Reason |
|---|---|---|
| Potassium | ↑↑↑ | RBC K+ is ~105 mEq/L (vs. 4 in plasma) |
| LDH | ↑↑↑ | High LDH concentration in RBCs |
| AST | ↑ | Moderate AST in RBCs |
| Phosphorus | ↑ | RBCs contain organic phosphates |
| Magnesium | ↑ | RBC Mg higher than plasma |
| Iron | ↑ | Hemoglobin releases iron |
| Bilirubin | Interference | Hemoglobin absorbs at similar wavelength |
Many analyzers flag hemolyzed samples using hemolysis index (H-index) based on spectrophotometric detection.
Lipemia
Lipemic samples appear turbid/milky due to high triglyceride levels (chylomicrons and VLDL).
Effects: - Light scattering interferes with spectrophotometric assays - Volume displacement can falsely lower electrolytes (in older methods using indirect ISE) - May interfere with immunoassays
Solutions: - Ultracentrifugation to separate lipid layer - Lipid-clearing agents - Dilution - Use of direct ISE for electrolytes
Icterus (Hyperbilirubinemia)
Icteric samples are yellow-orange due to elevated bilirubin.
Effects: - Spectrophotometric interference (bilirubin absorbs light at certain wavelengths) - Negative interference on creatinine (Jaffe method) - Variable interference on other assays depending on methodology
12.2 Analytical Methods
Spectrophotometry: The Workhorse
Most clinical chemistry tests are based on spectrophotometry-measuring how much light a solution absorbs at specific wavelengths.
Beer-Lambert Law: A = εbc
Where: - A = Absorbance - ε = Molar absorptivity (constant for a given substance at a given wavelength) - b = Path length (usually 1 cm) - c = Concentration
This means absorbance is directly proportional to concentration-the basis of quantitative photometric analysis.
Endpoint reactions: The reaction goes to completion, and final absorbance is measured (proportional to analyte concentration).
Kinetic (rate) reactions: The rate of absorbance change is measured. Used for enzyme assays-enzyme activity is measured by how fast it converts substrate to product.
Bichromatic analysis: Measures absorbance at two wavelengths-one specific for the analyte and one for background-reducing interference.
Ion-Selective Electrodes (ISE)
ISE measure the activity of specific ions using membranes that selectively respond to those ions.
Direct ISE: Measures ion activity in undiluted sample. Used in blood gas analyzers and point-of-care devices. Not affected by lipemia or hyperproteinemia.
Indirect ISE: Sample is diluted before measurement. Used in most chemistry analyzers. Can give falsely low electrolytes in severe lipemia or hyperproteinemia (pseudohyponatremia) because the dilution factor assumes normal water content, but lipid/protein displaces water.
Immunoassays
Immunoassays use antibody-antigen binding to detect and quantify analytes. Critical for hormones, drugs, tumor markers, and proteins at low concentrations.
Competitive immunoassay: - Limited amount of labeled analyte competes with patient analyte for antibody binding sites - More patient analyte → less labeled analyte bound → lower signal - Signal is inversely proportional to concentration - Used for small molecules (hormones, drugs)
Sandwich (non-competitive) immunoassay: - Capture antibody binds analyte - Detection antibody binds different epitope on same analyte - More analyte → more sandwiches → higher signal - Signal is directly proportional to concentration - Used for larger molecules with multiple epitopes (hCG, troponin)
The Hook Effect: In sandwich assays, extremely high analyte concentrations can saturate both antibodies independently, preventing sandwich formation. Result: falsely normal or low values. - Clinical relevance: Can occur with very high hCG (molar pregnancy) or prolactin (large prolactinoma) - Solution: Serial dilution and re-assay
Labels used: - Enzyme (ELISA, EMIT): Signal is color change from substrate conversion - Fluorescent (FPIA, DELFIA): Signal is fluorescence - Chemiluminescent (CLIA): Signal is light emission (highly sensitive) - Radioactive (RIA): Historical; rarely used now
Mass Spectrometry
Mass spectrometry has revolutionized clinical chemistry by providing high specificity and the ability to measure multiple analytes simultaneously.
Basic principle: 1. Ionization: Sample molecules are ionized (given a charge) 2. Mass analysis: Ions are separated by mass-to-charge ratio (m/z) 3. Detection: Ion abundance is measured
Ionization methods: - Electrospray ionization (ESI): Liquid sample sprayed through charged needle. Good for polar, large molecules. Commonly coupled with liquid chromatography (LC-MS). - MALDI (Matrix-Assisted Laser Desorption/Ionization): Sample embedded in matrix, laser causes desorption and ionization. Used for large molecules, microbial identification.
Mass analyzers: - Quadrupole: Four parallel rods with electric fields filter ions by m/z. Workhorse of clinical labs. - Time-of-flight (TOF): Ions accelerated through tube; lighter ions arrive faster. High resolution. - Ion trap: Ions trapped and sequentially ejected for analysis.
Tandem MS (MS/MS): Two mass analyzers in series. First analyzer selects parent ion, collision cell fragments it, second analyzer measures fragments. Extremely specific-provides structural information.
Clinical applications: - Therapeutic drug monitoring (immunosuppressants, antiretrovirals) - Toxicology (drugs of abuse confirmation) - Endocrinology (steroid hormones, vitamin D) - Newborn screening (metabolic disorders) - Microbial identification (MALDI-TOF)
12.3 Quality Control: Ensuring Reliable Results
The Purpose of QC
Laboratory QC ensures that analytical systems perform consistently and within acceptable limits. It detects errors before they affect patient results.
Internal QC: Control materials with known values run regularly alongside patient samples. Results are plotted on Levey-Jennings charts.
External QC (Proficiency Testing): Unknown samples sent by external organizations. Laboratory results are compared to peer laboratories and target values.
Levey-Jennings Charts
A Levey-Jennings chart plots QC results over time with lines indicating the mean and standard deviation limits (±1, 2, 3 SD).
Interpreting the chart: - Results should be randomly distributed around the mean - 68% within ±1 SD, 95% within ±2 SD, 99.7% within ±3 SD - Patterns suggest systematic problems
Westgard Rules
Westgard rules are a systematic way to evaluate QC data for errors:
| Rule | Description | Type of Error |
|---|---|---|
| 1:2s | One control >2 SD from mean | Warning rule (not rejection) |
| 1:3s | One control >3 SD | Random error; reject run |
| 2:2s | Two consecutive controls >2 SD same side | Systematic error (shift) |
| R:4s | One >+2 SD and one >-2 SD | Random error; reject run |
| 4:1s | Four consecutive controls >1 SD same side | Systematic error (shift) |
| 10x | Ten consecutive controls on same side of mean | Systematic error (shift) |
Random errors: Unpredictable, affect precision. Causes: Bubbles, electrical fluctuations, random pipetting errors.
Systematic errors: Affect accuracy in a consistent direction. Causes: Calibration drift, reagent deterioration, wrong standard.
Error Detection and Troubleshooting
When QC fails: 1. Don’t report patient results 2. Repeat the QC 3. If still fails, troubleshoot: - Fresh reagents - Fresh controls - Recalibrate - Maintenance 4. Document corrective action 5. Repeat QC; if passes, resume testing
12.4 Method Validation
Before implementing a new method or instrument, laboratories must validate that it performs acceptably.
Key parameters:
Precision (reproducibility): - Within-run (repeatability): Run same sample multiple times in one run - Between-run: Run same sample across different days/runs - Expressed as standard deviation (SD) or coefficient of variation (CV = SD/mean × 100%)
Accuracy: - Comparison to reference method or certified reference materials - Recovery studies (spike known amount, measure recovery) - Proficiency testing
Linearity (reportable range): - Test serial dilutions of high sample - Determine the concentration range where results are accurate and proportional
Analytical sensitivity: - Limit of blank (LoB): Highest result from a blank sample - Limit of detection (LoD): Lowest concentration reliably detected (different from blank) - Limit of quantitation (LoQ): Lowest concentration reliably measured with acceptable precision
Analytical specificity (interferences): - Test for interference from hemolysis, lipemia, icterus - Test for cross-reactivity with similar compounds
12.5 Reference Ranges
Establishing Reference Ranges
Reference ranges define the expected results in a healthy population. Proper establishment requires:
- Define the reference population: Healthy individuals; consider age, sex, ethnicity
- Sample size: Minimum 120 individuals (to calculate 90% confidence intervals for the 2.5th and 97.5th percentiles)
- Statistical analysis:
- Parametric (if data are Gaussian): Mean ± 2 SD includes 95%
- Non-parametric (most common): 2.5th to 97.5th percentile
Reference Range Considerations
- Age and sex differences (creatinine, hemoglobin, alkaline phosphatase)
- Pregnancy changes (normal “abnormal” values)
- Fasting requirements (glucose, lipids)
- Diurnal variation (cortisol, iron)
- Method-specific ranges (different assays may have different normal ranges)
Critical Values
Critical values (panic values) are results so far from normal that they indicate life-threatening conditions requiring immediate clinical action.
Examples: - Glucose <40 or >500 mg/dL - Potassium <2.5 or >6.5 mEq/L - Sodium <120 or >160 mEq/L
Requirements: - Immediate notification of caregiver - Read-back verification - Documentation of notification - Time limits (usually within 30-60 minutes)
Chapter 13: Electrolytes, Acid-Base, and Blood Gases
13.1 Sodium: The Master Electrolyte
Sodium is the primary extracellular cation and the main determinant of plasma osmolality. Disorders of sodium primarily reflect disorders of water balance.
Normal Physiology
- Plasma sodium: 136-145 mEq/L
- Total body sodium is regulated by aldosterone (controls renal sodium reabsorption)
- Plasma sodium concentration is regulated by ADH/vasopressin (controls water excretion)
The key concept: Hyponatremia is usually a problem of too much water, not too little sodium.
Hyponatremia (Sodium <136 mEq/L)
Classification by volume status:
Hypovolemic hyponatremia (low total body sodium AND water, but relatively more sodium lost): - GI losses (vomiting, diarrhea) - Renal losses (diuretics, salt-wasting nephropathy, mineralocorticoid deficiency) - Third-spacing (pancreatitis, burns)
Euvolemic hyponatremia (total body sodium normal, but excess water): - SIADH (most common cause): Inappropriate ADH secretion causes water retention - Hypothyroidism (severe) - Glucocorticoid deficiency - Psychogenic polydipsia (overwhelms renal capacity to excrete water)
Hypervolemic hyponatremia (excess total body sodium AND water, but relatively more water): - Congestive heart failure - Cirrhosis - Nephrotic syndrome - All involve “effective hypovolemia” triggering water retention
SIADH in detail: SIADH occurs when ADH is secreted independent of normal osmotic/volume stimuli. Causes: - CNS disorders (stroke, trauma, infection) - Pulmonary disease (pneumonia, especially small cell lung cancer) - Medications (SSRIs, carbamazepine, cyclophosphamide) - Tumors (ectopic ADH production-small cell lung cancer classic)
Diagnosis of SIADH: - Hyponatremia - Low serum osmolality (<280 mOsm/kg) - Inappropriately concentrated urine (>100 mOsm/kg when serum is dilute) - Elevated urine sodium (>40 mEq/L-kidneys are excreting sodium appropriately) - Euvolemic - Normal thyroid and adrenal function - No diuretic use
Pseudohyponatremia: Artifactually low sodium measurement. Occurs with: - Severe hyperlipidemia - Severe hyperproteinemia (myeloma) - Caused by the “water displacement” effect when indirect ISE is used - Not seen with direct ISE or blood gas analyzers
Symptoms of hyponatremia: Related to cerebral edema (water shifts into cells) - Mild (Na 130-135): Often asymptomatic - Moderate (Na 120-129): Nausea, headache, confusion - Severe (Na <120): Seizures, coma, death
Treatment principles: - Treat the underlying cause - Acute symptomatic: Hypertonic saline (3% NaCl) - Chronic: Gradual correction; avoid correcting faster than 8-10 mEq/L/day to prevent osmotic demyelination syndrome (central pontine myelinolysis)
Hypernatremia (Sodium >145 mEq/L)
Hypernatremia always indicates a relative deficit of water compared to sodium.
Causes:
Water loss (most common): - Insensible losses (fever, burns, tachypnea) without adequate replacement - Renal losses: - Central diabetes insipidus (lack of ADH production) - Nephrogenic diabetes insipidus (kidney resistance to ADH) - Osmotic diuresis (hyperglycemia) - GI losses without adequate replacement
Sodium gain (less common): - Hypertonic saline administration - Sodium bicarbonate administration - Salt tablets
Symptoms: Related to cerebral shrinkage - Lethargy, weakness - Seizures, coma - More severe when acute
Treatment: - Free water replacement (oral or D5W IV) - Correct underlying cause - Correct gradually to avoid cerebral edema
13.2 Potassium: The Intracellular Cation
Potassium is the primary intracellular cation (intracellular K+ ≈ 140 mEq/L vs. plasma K+ ≈ 4 mEq/L). This steep gradient is maintained by Na-K-ATPase and is critical for cell membrane potential, especially in cardiac and neuromuscular cells.
Hypokalemia (Potassium <3.5 mEq/L)
Causes:
Inadequate intake: Rare as sole cause (kidneys can conserve K+ well)
Increased losses: - GI losses (vomiting, diarrhea, nasogastric suction) - Renal losses: - Diuretics (loop, thiazide)-most common cause - Hyperaldosteronism - Renal tubular acidosis (Type I, II) - Hypomagnesemia (impairs K+ conservation)
Transcellular shift (K+ moves into cells): - Insulin administration - β-agonists (albuterol) - Alkalosis (for every 0.1 pH increase, K+ decreases ~0.4 mEq/L) - Refeeding syndrome
Clinical effects: Related to altered membrane potential - ECG changes: U waves, flattened T waves, ST depression, prolonged QT - Muscle weakness, cramps - Ileus - Rhabdomyolysis (severe cases) - Predisposition to digoxin toxicity
Treatment: - Oral KCl preferred (safer) - IV KCl for severe cases (rate limited to 10-20 mEq/hr via peripheral line) - Replace magnesium (hypomagnesemia impairs K+ repletion)
Hyperkalemia (Potassium >5.0 mEq/L)
First, rule out pseudohyperkalemia: - Hemolysis (most common): K+ leaks from lysed RBCs - Thrombocytosis (>500,000): K+ released during clotting - Leukocytosis (>100,000): Same mechanism - Fist clenching during blood draw: Muscle K+ release - Prolonged tourniquet time
True hyperkalemia causes:
Increased intake (rare unless renal excretion impaired): - Oral/IV potassium supplements - Potassium-containing medications (potassium penicillin)
Decreased excretion: - Acute or chronic kidney disease - Hypoaldosteronism (Addison’s disease, hyporeninemic hypoaldosteronism) - Medications: ACE inhibitors, ARBs, spironolactone, NSAIDs, trimethoprim
Transcellular shift (K+ moves out of cells): - Acidosis (H+ enters cells, K+ exits) - Insulin deficiency (insulin drives K+ into cells) - β-blockers - Tissue damage (rhabdomyolysis, tumor lysis, hemolysis) - Succinylcholine - Digitalis toxicity
Clinical effects: Cardiac toxicity is the major concern - ECG changes (progressive): 1. Peaked T waves (earliest) 2. Prolonged PR interval 3. Loss of P waves 4. Widened QRS 5. Sine wave pattern 6. Ventricular fibrillation/asystole
Treatment (for symptomatic or K+ >6.5 mEq/L): 1. Stabilize cardiac membrane: Calcium gluconate (immediate effect, doesn’t lower K+) 2. Shift K+ into cells: - Insulin + glucose - β-agonists (albuterol) - Sodium bicarbonate (if acidotic) 3. Remove K+ from body: - Loop diuretics (if adequate renal function) - Potassium binders (sodium polystyrene sulfonate, patiromer, sodium zirconium cyclosilicate) - Hemodialysis (definitive; for severe cases or renal failure)
13.3 Acid-Base Physiology
Understanding acid-base balance requires grasping the relationship between pH, pCO2, and bicarbonate.
Quick Reference: Primary Acid-Base Disorders
| Disorder | pH | Primary Change | Compensation |
|---|---|---|---|
| Metabolic acidosis | ↓ | ↓ HCO3- | ↓ pCO2 (hyperventilation) |
| Metabolic alkalosis | ↑ | ↑ HCO3- | ↑ pCO2 (hypoventilation) |
| Respiratory acidosis | ↓ | ↑ pCO2 | ↑ HCO3- (renal retention) |
| Respiratory alkalosis | ↑ | ↓ pCO2 | ↓ HCO3- (renal excretion) |
Systematic Approach to Acid-Base Interpretation
- Look at pH: Acidemia (<7.35) or alkalemia (>7.45)?
- Identify the primary process: Does pCO2 or HCO3- explain the pH change?
- Is compensation appropriate? Use compensation formulas
- If metabolic acidosis, calculate anion gap
- If elevated anion gap, calculate delta-delta ratio
The Henderson-Hasselbalch Equation
pH = 6.1 + log([HCO3-] / (0.03 × pCO2))
This shows that pH depends on the ratio of bicarbonate (metabolic component) to pCO2 (respiratory component).
- Metabolic processes change [HCO3-]
- Respiratory processes change pCO2
- The body compensates to normalize the ratio and pH
Compensation Rules
Respiratory compensation for metabolic disorders (fast, minutes to hours): - Metabolic acidosis → Hyperventilation → ↓ pCO2 - Winter’s formula: Expected pCO2 = 1.5 × [HCO3-] + 8 ± 2 - Metabolic alkalosis → Hypoventilation → ↑ pCO2 - Limited by hypoxemia
Metabolic compensation for respiratory disorders (slow, days): - Respiratory acidosis → Kidneys retain HCO3- - Acute: HCO3- increases 1 mEq/L per 10 mmHg rise in pCO2 - Chronic: HCO3- increases 3.5 mEq/L per 10 mmHg rise in pCO2 - Respiratory alkalosis → Kidneys excrete HCO3- - Acute: HCO3- decreases 2 mEq/L per 10 mmHg fall in pCO2 - Chronic: HCO3- decreases 5 mEq/L per 10 mmHg fall in pCO2
The Anion Gap
Anion gap = Na+ - (Cl- + HCO3-)
Normal: 8-12 mEq/L (varies by lab)
The anion gap represents unmeasured anions (primarily albumin, phosphate, sulfate, organic acids).
Elevated anion gap metabolic acidosis (MUDPILES): - Methanol (metabolized to formic acid) - Uremia (accumulated organic acids) - DKA (ketoacids: β-hydroxybutyrate, acetoacetate) - Propylene glycol (in IV medications) - Isoniazid, Iron (lactic acidosis) - Lactic acidosis (hypoperfusion, metformin) - Ethylene glycol (metabolized to glycolic and oxalic acid) - Salicylates (aspirin overdose)
Normal anion gap (hyperchloremic) metabolic acidosis: - Diarrhea (loss of HCO3-) - Renal tubular acidosis - Early renal failure - Acetazolamide - Normal saline infusion (dilutional acidosis)
Understanding the anion gap helps determine the cause of metabolic acidosis.
The Osmolal Gap
Osmolal gap = Measured osmolality - Calculated osmolality
Calculated osmolality = 2(Na+) + Glucose/18 + BUN/2.8
Normal osmolal gap: <10 mOsm/kg
Elevated osmolal gap: Indicates presence of osmotically active substances not in the formula: - Ethanol (can calculate contribution: ethanol (mg/dL) / 4.6) - Methanol - Ethylene glycol - Isopropanol - Mannitol
Clinical application: In a patient with metabolic acidosis and elevated osmolal gap, consider toxic alcohol ingestion. Early in methanol or ethylene glycol poisoning, osmolal gap is high but anion gap is normal (parent compound present but not yet metabolized). Later, osmolal gap decreases and anion gap increases (metabolites accumulate).
13.4 Blood Gas Analysis
Sample Requirements
- Arterial blood preferred (for pO2 assessment)
- Heparin anticoagulated (lithium heparin or dry balanced heparin)
- Anaerobic collection (air bubbles raise pO2, lower pCO2)
- Analyzed immediately or kept on ice (metabolism continues)
Parameters
Measured: - pH - pCO2 - pO2
Calculated: - HCO3- (from Henderson-Hasselbalch) - Base excess/deficit - Oxygen saturation (calculated from pO2 unless co-oximetry)
Oxygen Assessment
pO2: Partial pressure of oxygen in blood - Normal arterial: 80-100 mmHg (depends on age and altitude) - Hypoxemia: pO2 <60 mmHg
Oxygen saturation (SaO2): Percentage of hemoglobin saturated with oxygen - Normal: >95% - Reflects the oxygen-hemoglobin dissociation curve
The oxygen-hemoglobin dissociation curve: Sigmoidal relationship between pO2 and saturation
Factors that shift the curve: - Right shift (decreased O2 affinity, more O2 released to tissues): - Acidosis - Hyperthermia - Increased 2,3-DPG - Hypercapnia - Left shift (increased O2 affinity, less O2 released): - Alkalosis - Hypothermia - Decreased 2,3-DPG - Carbon monoxide - Fetal hemoglobin
Co-oximetry
Standard pulse oximetry and calculated saturation assume all hemoglobin is functional. Co-oximetry directly measures hemoglobin species:
- Oxyhemoglobin: Functional, carrying O2
- Deoxyhemoglobin: Functional, not carrying O2
- Carboxyhemoglobin: Hemoglobin bound to CO; cannot carry O2
- Methemoglobin: Iron oxidized to Fe3+; cannot carry O2
Clinical importance: In carbon monoxide poisoning, standard pulse oximetry reads falsely normal (reads carboxyhemoglobin as oxyhemoglobin). Co-oximetry is required for accurate assessment.
Chapter 14: Renal Function Assessment
14.1 Creatinine: The Standard Marker
Creatinine is produced from creatine in muscle at a relatively constant rate and is freely filtered by the glomerulus with minimal tubular reabsorption or secretion. This makes it a practical marker of glomerular filtration rate (GFR).
Creatinine Metabolism
- Source: Non-enzymatic conversion of creatine and creatine phosphate in muscle
- Production rate: Proportional to muscle mass (higher in young men, lower in elderly, women, malnourished)
- Elimination: Almost entirely renal (freely filtered, 10-15% tubular secretion)
Creatinine Measurement
Jaffe method (colorimetric): - Creatinine reacts with alkaline picrate to form orange-red complex - Advantages: Inexpensive, widely available - Disadvantages: Positive interference from ketones, proteins, cephalosporins; negative interference from bilirubin
Enzymatic methods: - Use creatinine-specific enzymes - More specific than Jaffe - Less interference - More expensive
Interpreting Creatinine
Critical concept: Because creatinine is related to muscle mass, a “normal” creatinine doesn’t always mean normal kidney function.
Example: An elderly woman with creatinine 1.0 mg/dL may have significantly reduced GFR because her low muscle mass produces little creatinine. A young muscular man with creatinine 1.0 mg/dL has normal GFR.
This is why we calculate or estimate GFR rather than relying on creatinine alone.
14.2 Glomerular Filtration Rate (GFR)
GFR is the volume of plasma filtered by the glomeruli per unit time (normally ~125 mL/min or ~180 L/day).
GFR Estimation Equations
Cockcroft-Gault (estimates creatinine clearance, not GFR): CrCl = [(140 - age) × weight (kg)] / [72 × creatinine] × (0.85 if female)
- Used for drug dosing (historically)
- Not standardized to body surface area
- Being replaced by CKD-EPI
MDRD (Modification of Diet in Renal Disease): - Estimates GFR standardized to 1.73 m² BSA - Uses creatinine, age, sex - Older equation; less accurate at higher GFRs
CKD-EPI (Chronic Kidney Disease Epidemiology Collaboration): - Current recommended equation - More accurate than MDRD, especially at higher GFRs - Multiple versions: creatinine-based, cystatin C-based, combined
Recent change: Race is no longer used in GFR calculations (2021 recommendation), as the previous race coefficient was based on limited data and perpetuated disparities.
Cystatin C: An Alternative Marker
Cystatin C is a cysteine protease inhibitor produced by all nucleated cells at a constant rate.
Advantages over creatinine: - Not affected by muscle mass - More accurate GFR estimation in certain populations (elderly, extremes of body size, vegetarians)
Disadvantages: - Affected by thyroid function, corticosteroid use, inflammation - More expensive - Less standardized historically (improving)
Combined creatinine-cystatin C equations provide the most accurate GFR estimates.
14.3 Blood Urea Nitrogen (BUN)
Urea is the end product of protein metabolism, synthesized in the liver’s urea cycle.
BUN Physiology
- Production: Liver converts ammonia (from amino acid deamination) to urea
- Elimination: Freely filtered by glomerulus; 40-50% is reabsorbed in the tubules
- Unlike creatinine, BUN levels are affected by many non-renal factors
BUN/Creatinine Ratio
Normal ratio: 10-20:1
Elevated ratio (>20:1): - Prerenal azotemia (dehydration, heart failure): Decreased renal perfusion → increased tubular urea reabsorption - GI bleeding: Blood in gut is digested → protein load → increased urea production - High protein intake - Catabolic states (trauma, infection, steroids)
Decreased ratio (<10:1): - Liver disease (decreased urea production) - Low protein diet - Rhabdomyolysis (disproportionate creatinine increase from muscle breakdown) - SIADH (dilutional effect on BUN)
14.4 Urinalysis: The Window to the Kidney
A complete urinalysis includes physical, chemical, and microscopic examination.
Physical Examination
Color: - Yellow (normal): Urochrome pigment - Red/brown: Blood, hemoglobin, myoglobin, beets, rifampin - Orange: Pyridium, carrots - Brown/black: Melanin, metronidazole, melanoma - Green: Pseudomonas UTI, propofol, methylene blue
Clarity/turbidity: - Clear: Normal - Cloudy: WBCs, bacteria, crystals, phosphates (normal in alkaline urine)
Specific gravity: - Normal: 1.005-1.030 - Measures urine concentration (kidney’s ability to concentrate or dilute) - Low (<1.005): Dilute urine, diabetes insipidus, water intoxication - High (>1.030): Dehydration, SIADH, contrast dye - Fixed at 1.010: Isosthenuria (loss of concentrating ability-renal tubular damage)
Chemical Examination (Dipstick)
pH: 4.5-8.0 - Acidic: Protein diet, acidosis, UTI with E. coli - Alkaline: Vegetarian diet, UTI with urease-positive organisms, stale sample (bacteria convert urea to ammonia)
Protein: - Detects primarily albumin (other proteins poorly detected) - Positive: Glomerular disease, overflow proteinuria, UTI, transient (fever, exercise) - False positive: Very alkaline urine, contamination with antiseptics - False negative: Dilute urine, non-albumin proteinuria (Bence Jones)
Glucose: - Normally not present (renal threshold ~180 mg/dL) - Positive: Diabetes mellitus, pregnancy (lowered threshold), renal glycosuria
Ketones: - Detects acetoacetate (not β-hydroxybutyrate well) - Positive: DKA, starvation, alcoholic ketoacidosis - Note: In DKA, β-hydroxybutyrate predominates-ketones may be only mildly positive initially and increase during treatment as β-hydroxybutyrate converts to acetoacetate
Blood: - Detects hemoglobin (from intact RBCs or free hemoglobin) and myoglobin - Positive blood with no RBCs on microscopy: Hemoglobinuria or myoglobinuria - False positive: Oxidizing agents, peroxidase-producing bacteria - False negative: Ascorbic acid (high doses)
Leukocyte esterase: - Enzyme from neutrophils - Positive: Pyuria (suggests UTI) - Can be positive with sterile pyuria (interstitial nephritis, TB)
Nitrite: - Produced by bacteria that reduce nitrate (most Enterobacteriaceae) - Positive: Suggests UTI with gram-negative bacteria - False negative: Gram-positive organisms, Pseudomonas (don’t reduce nitrate), dilute urine, short bladder incubation time
Bilirubin: - Conjugated (direct) bilirubin is water-soluble and can be excreted in urine - Positive: Hepatocellular disease, biliary obstruction - Unconjugated bilirubin is not water-soluble and will not appear in urine
Urobilinogen: - Product of bilirubin metabolism by gut bacteria - Normal: Small amount present (0.2-1.0 mg/dL) - Increased: Hemolysis (more bilirubin → more urobilinogen), hepatocellular disease - Absent: Complete biliary obstruction (no bilirubin reaches gut)
Microscopic Examination
Red blood cells: - Normal: 0-2/HPF - Elevated: Glomerulonephritis, stones, infection, malignancy, trauma - Dysmorphic RBCs (irregular shapes): Suggest glomerular origin (damaged passing through GBM)
White blood cells: - Normal: 0-5/HPF - Elevated: UTI, interstitial nephritis, contamination
Epithelial cells: - Squamous (vaginal/urethral): Suggest contamination - Transitional (bladder): May be normal in small numbers - Renal tubular: Suggest acute tubular necrosis
Casts (cylindrical structures formed in tubules, taking the shape of the tubule):
| Cast Type | Composition | Clinical Significance |
|---|---|---|
| Hyaline | Tamm-Horsfall protein | Normal, concentrated urine, exercise |
| RBC | RBCs | Glomerulonephritis, vasculitis |
| WBC | WBCs | Pyelonephritis, interstitial nephritis |
| Granular | Degenerating cells/protein | Many causes; “muddy brown” = ATN |
| Waxy | Degenerated granular | Chronic kidney disease, stasis |
| Broad | Any type, wide | Chronic kidney disease (dilated tubules) |
| Fatty | Lipid droplets | Nephrotic syndrome |
The presence of RBC casts is highly specific for glomerular disease-it means RBCs are originating from the glomerulus and getting trapped in protein casts in the tubules.


Crystals:
| Crystal | Appearance | Urine pH | Significance |
|---|---|---|---|
| Calcium oxalate | Envelope, dumbbell | Any | Common; ethylene glycol poisoning |
| Uric acid | Various (rhomboid, rosette) | Acidic | Gout, tumor lysis |
| Triple phosphate | Coffin lid | Alkaline | UTI with urease producer |
| Cystine | Hexagonal | Acidic | Cystinuria (always pathologic) |
| Tyrosine | Needles | Acidic | Liver disease |
| Leucine | Spheres with radial striations | Acidic | Liver disease |
| Ampicillin/Sulfa | Needle clusters | Any | Drug precipitation |


Chapter 15: Liver Function and Hepatobiliary Assessment
The liver performs hundreds of functions-synthesis, metabolism, detoxification, and excretion. “Liver function tests” (LFTs) is actually a misnomer for most of these tests; they’re better called “liver chemistries” because they primarily detect liver injury rather than measure function.
Quick Reference: Liver Test Patterns
| Pattern | AST/ALT | Alk Phos | Bilirubin | Interpretation |
|---|---|---|---|---|
| Hepatocellular | ↑↑↑ | Normal or ↑ | Variable | Hepatitis (viral, drug, autoimmune), ischemia, toxins |
| Cholestatic | Normal or ↑ | ↑↑↑ | ↑ | Biliary obstruction (stone, stricture, tumor), PBC, PSC, drug-induced |
| Infiltrative | Normal or ↑ | ↑↑ | Normal or ↑ | Granulomas, malignancy, amyloid |
AST:ALT Ratio Interpretation:
| Ratio | Suggests |
|---|---|
| <1 | Most liver diseases, viral hepatitis, NAFLD |
| >2 | Alcoholic liver disease (classic), advanced cirrhosis |
| >3 | Strongly suggests alcoholic liver disease |
Key interpretation principle: The pattern of liver test abnormalities points toward the mechanism of injury. Marked transaminase elevation with modest ALP elevation suggests hepatocellular injury (hepatitis). Marked ALP elevation with modest transaminase elevation suggests cholestasis (biliary obstruction or intrahepatic cholestasis). Mixed patterns require clinical correlation.
15.1 The Aminotransferases: Markers of Hepatocellular Injury
Aspartate Aminotransferase (AST, SGOT)
AST catalyzes the transfer of an amino group from aspartate to α-ketoglutarate, producing oxaloacetate and glutamate. It exists in two isoenzymes: mitochondrial (mAST, ~80% of hepatic AST) and cytosolic (cAST).
Tissue distribution: AST is found in many tissues in descending order: heart > liver > skeletal muscle > kidney > brain > RBCs
This widespread distribution makes AST less specific for liver disease than ALT.
Alanine Aminotransferase (ALT, SGPT)
ALT catalyzes the transfer of an amino group from alanine to α-ketoglutarate, producing pyruvate and glutamate. It’s predominantly cytosolic.
Tissue distribution: ALT is more liver-specific, with highest concentrations in liver, then kidney and small amounts in heart and muscle.
Interpreting Aminotransferase Elevations
Degree of elevation: - Mild (<3× ULN): NAFLD, chronic hepatitis B or C, hemochromatosis, medications - Moderate (3-10× ULN): Acute viral hepatitis, alcoholic hepatitis, autoimmune hepatitis - Marked (>10× ULN): Acute viral hepatitis, drug/toxin-induced (acetaminophen), ischemic hepatitis (“shock liver”), acute bile duct obstruction
The AST:ALT ratio: Provides diagnostic clues
| Ratio | Condition | Explanation |
|---|---|---|
| <1 | Viral hepatitis, NAFLD | ALT predominates in cytosol; released with membrane injury |
| >2 | Alcoholic liver disease | Alcohol depletes hepatic pyridoxal-5’-phosphate (ALT cofactor), plus mitochondrial damage releases AST |
| >1 | Cirrhosis (any cause) | Reduced ALT synthesis in cirrhotic liver |
The classic teaching: AST:ALT ratio >2 suggests alcoholic liver disease. However, this ratio can also be seen in advanced cirrhosis from any cause.
Isolated AST elevation (normal ALT): - Consider non-hepatic sources: Myocardial injury, skeletal muscle injury (rhabdomyolysis), hemolysis (RBCs contain AST) - Check CK if muscle source suspected
15.2 Alkaline Phosphatase (ALP): Marker of Cholestasis
ALP is a group of isoenzymes that hydrolyze phosphate esters at alkaline pH.
Tissue sources: - Liver (canalicular membrane of hepatocytes) - Bone (osteoblasts) - Intestine - Placenta - Kidney
Elevated ALP: Hepatic vs. Bone
When ALP is elevated, you must determine the source:
Method 1: Check GGT - GGT (gamma-glutamyl transferase) is elevated in hepatobiliary disease but NOT in bone disease - Elevated ALP + elevated GGT = hepatobiliary source - Elevated ALP + normal GGT = bone source
Hepatobiliary causes of elevated ALP: - Biliary obstruction (most marked elevations) - Primary biliary cholangitis (PBC) - Primary sclerosing cholangitis (PSC) - Infiltrative diseases (granulomatous hepatitis, metastases) - Hepatic congestion - Drug-induced cholestasis
Bone causes: - Paget’s disease (can be markedly elevated) - Bone metastases (osteoblastic > osteolytic) - Osteomalacia - Healing fractures - Normal growth in children and adolescents (growth plate activity)
15.3 Bilirubin: The Pigment of Hemoglobin Catabolism
Bilirubin Metabolism
Heme catabolism: Senescent RBCs are phagocytosed by macrophages. Heme is converted to biliverdin, then to unconjugated bilirubin.
Transport: Unconjugated bilirubin is hydrophobic and travels bound to albumin.
Hepatic uptake: Hepatocytes take up unconjugated bilirubin via specific transporters.
Conjugation: UDP-glucuronosyltransferase (UGT1A1) conjugates bilirubin with glucuronic acid, forming water-soluble conjugated bilirubin.
Excretion: Conjugated bilirubin is secreted into bile canaliculi and eventually reaches the intestine.
Intestinal fate: Gut bacteria convert conjugated bilirubin to urobilinogen. Most is excreted in feces (as stercobilin). Some is reabsorbed; small amount is excreted by kidneys.
Unconjugated (Indirect) Hyperbilirubinemia
Causes: - Increased production: Hemolysis, ineffective erythropoiesis, hematoma resorption - Decreased conjugation: - Gilbert syndrome (mild UGT1A1 deficiency; very common, benign) - Crigler-Najjar syndrome Type I (absent UGT1A1; severe) - Crigler-Najjar syndrome Type II (reduced UGT1A1; moderate)
Gilbert syndrome (affects ~5% of population): - Mild unconjugated hyperbilirubinemia (usually <3 mg/dL) - Increases with fasting, stress, illness - No liver disease, no hemolysis - Benign-requires no treatment
Conjugated (Direct) Hyperbilirubinemia
Causes: - Hepatocellular disease: Hepatitis, cirrhosis - Biliary obstruction: Stones, strictures, tumors - Inherited: - Dubin-Johnson syndrome: Defective canalicular transport; benign - Rotor syndrome: Similar but no liver pigment; benign
15.4 Tests of Hepatic Synthetic Function
Albumin
Albumin is synthesized exclusively by the liver. With a half-life of ~20 days, it reflects chronic, not acute, liver function.
Decreased albumin: - Chronic liver disease (decreased synthesis) - Nephrotic syndrome (urinary loss) - Protein-losing enteropathy - Malnutrition - Acute phase response (negative acute-phase reactant)
Prothrombin Time (PT) and INR
The liver synthesizes most coagulation factors. Factor VII has the shortest half-life (~6 hours), so PT/INR is sensitive to acute changes.
Distinguishing liver disease from vitamin K deficiency: - Give vitamin K (10 mg IV): - Vitamin K deficiency: PT corrects within 24-48 hours - Liver disease: PT does not correct
15.5 Patterns of Liver Disease
Hepatocellular Pattern
- ALT, AST markedly elevated
- ALP mildly elevated or normal
- Causes: Viral hepatitis, drug-induced, autoimmune hepatitis, ischemic hepatitis
Cholestatic Pattern
- ALP markedly elevated (often >3× ULN)
- GGT elevated
- ALT, AST mildly elevated or normal
- Causes: Biliary obstruction, PBC, PSC, drug-induced cholestasis
Chapter 16: Cardiac Biomarkers
The diagnosis of acute myocardial infarction has been transformed by cardiac biomarkers. Understanding these markers requires appreciating both their molecular biology and their clinical kinetics-when they rise, when they peak, and why they behave as they do.
16.1 Cardiac Troponins: The Gold Standard
The Biology of Troponin
The troponin complex is the master regulator of muscle contraction. It consists of three subunits that work together to control when actin and myosin can interact:
Troponin C (TnC): The calcium-binding subunit. When calcium floods into the cytoplasm during depolarization, TnC binds it and undergoes a conformational change. TnC is nearly identical in cardiac and skeletal muscle, making it useless as a cardiac-specific marker.
Troponin I (TnI): The inhibitory subunit. TnI normally holds tropomyosin in a position that blocks actin-myosin interaction. When TnC binds calcium, TnI releases its inhibition, allowing contraction. Cardiac TnI (cTnI) has a unique 31-amino-acid N-terminal extension not found in skeletal TnI-this is what makes it cardiac-specific.
Troponin T (TnT): The tropomyosin-binding subunit. TnT anchors the entire troponin complex to tropomyosin. Cardiac TnT (cTnT) also has unique sequences that distinguish it from skeletal isoforms.
The key concept is that cTnI and cTnT are expressed only in cardiac myocytes. When you detect them in the blood, you know cardiac myocytes have been damaged. This specificity is why troponin has become the cornerstone of MI diagnosis.
Why Troponin Is Released in Myocardial Injury
About 3-5% of troponin in the myocyte exists free in the cytoplasm (the “cytosolic pool”). The remaining 95%+ is bound to the contractile apparatus (the “structural pool”). This distribution explains troponin kinetics:
Early release (3-6 hours): Membrane damage allows the small cytosolic pool to leak out first. This is why troponin can be detected relatively early after MI onset.
Sustained elevation (7-14 days): As myocytes undergo necrosis, the structural pool is gradually released. The contractile apparatus must be degraded before this bound troponin can escape. This proteolytic degradation takes time, explaining why troponin remains elevated for up to two weeks after a large MI.
Peak levels (12-24 hours): The peak represents the maximum rate of release from dying myocytes, which occurs during active infarct evolution.
High-Sensitivity Troponin Assays
Traditional troponin assays could detect troponin only when levels were significantly elevated-they had detection limits around 0.01-0.04 ng/mL. High-sensitivity assays (hs-cTnI, hs-cTnT) can detect concentrations 10-100 times lower.
Why this matters clinically:
The 99th percentile upper reference limit (URL) is the threshold that defines “elevated” troponin. High-sensitivity assays can actually measure levels at this threshold with acceptable precision (CV <10%), whereas older assays often couldn’t detect anything below several times the 99th percentile.
The trade-off: With greater analytical sensitivity comes reduced clinical specificity. High-sensitivity assays detect troponin release from any cause of myocardial injury, not just acute coronary syndrome. This has forced clinicians to think more carefully about why troponin is elevated rather than just whether it is elevated.
Troponin Elevation Without Acute Coronary Syndrome
Understanding non-ACS causes of troponin elevation is essential for interpretation:
Type 2 MI (supply-demand mismatch): Conditions that increase oxygen demand (tachycardia, sepsis, anemia) or decrease supply (hypotension, respiratory failure) can cause myocardial injury without coronary plaque rupture. The troponin elevation is real-myocytes are dying-but the treatment is addressing the underlying cause, not revascularization.
Chronic elevation in structural heart disease: Heart failure patients often have chronically elevated troponin because the stressed, remodeled myocardium has ongoing low-level myocyte death. These patients need serial measurements to detect change from baseline.
Renal failure: Both cTnI and cTnT can be elevated in ESRD patients. For cTnT, this may partly reflect cross-reactivity with re-expressed skeletal TnT isoforms in uremic myopathy. For clinical purposes, higher thresholds or serial changes are more meaningful in dialysis patients.
Other important causes: Myocarditis (can cause massive elevation), pulmonary embolism (right heart strain), takotsubo cardiomyopathy, cardiac contusion, cardioversion, and even extreme exercise in trained athletes.
16.2 Natriuretic Peptides: Markers of Myocardial Wall Stress
The Biology of BNP
B-type natriuretic peptide (BNP) is synthesized primarily by ventricular myocytes in response to wall stretch. When the ventricle is volume or pressure overloaded, the mechanical stress triggers transcription of the BNP gene.
Synthesis pathway: The myocyte first produces proBNP (108 amino acids), which is cleaved by the enzyme corin into two fragments: - BNP (32 amino acids): The biologically active hormone - NT-proBNP (76 amino acids): An inactive fragment
Both are released into circulation and both can be measured clinically.
Physiologic effects of BNP: BNP is the body’s defense against volume overload. It causes: - Vasodilation (reducing afterload) - Natriuresis and diuresis (reducing preload) - Inhibition of the renin-angiotensin-aldosterone system - Inhibition of sympathetic nervous system
In heart failure, BNP levels are elevated because the heart is trying to compensate for the overloaded state-but the compensation is inadequate to overcome the disease.
BNP vs. NT-proBNP: Clinically Important Differences
Half-life: BNP has a half-life of ~20 minutes; NT-proBNP has a half-life of ~120 minutes. The longer half-life of NT-proBNP means it accumulates to higher levels and has less biological variability.
Renal clearance: NT-proBNP is cleared primarily by the kidneys. In renal failure, NT-proBNP levels rise disproportionately. BNP is cleared by multiple mechanisms (neutral endopeptidases, natriuretic peptide receptor C, renal clearance), so it is less affected by renal function.
Drug effects: Sacubitril (in sacubitril/valsartan) inhibits neprilysin, the enzyme that degrades BNP. Patients on this drug will have elevated BNP levels that don’t reflect their clinical status. NT-proBNP is not affected by sacubitril and should be used for monitoring in these patients.
Clinical Use: Ruling Out Heart Failure
The greatest utility of natriuretic peptides is their negative predictive value. In a patient presenting with dyspnea:
BNP <100 pg/mL: Heart failure is very unlikely as the cause of symptoms. The negative predictive value exceeds 95%.
NT-proBNP: Age-stratified cutoffs are used because NT-proBNP rises with age even in healthy individuals: - Age <50: <450 pg/mL rules out HF - Age 50-75: <900 pg/mL rules out HF - Age >75: <1800 pg/mL rules out HF
Important caveat: Obese patients may have lower natriuretic peptide levels than expected for their degree of heart failure. Adipose tissue expresses natriuretic peptide clearance receptors, pulling BNP out of circulation.
16.3 Other Cardiac Biomarkers
CK-MB: The Historical Standard
Before troponin, CK-MB was the biomarker of choice for MI. CK-MB is one of three creatine kinase isoenzymes (CK-MM in skeletal muscle, CK-BB in brain, CK-MB highest in heart).
Why it’s been replaced: CK-MB is not truly cardiac-specific. Skeletal muscle contains small amounts of CK-MB, so rhabdomyolysis, muscular dystrophy, and even extreme exercise can elevate CK-MB. The CK-MB/total CK ratio was used to improve specificity (ratio >5% suggesting cardiac source), but this approach is inferior to troponin.
Remaining use: CK-MB falls faster than troponin after MI (returns to baseline in 2-3 days). This makes it useful for detecting reinfarction in a patient whose troponin is already elevated from a recent MI. If troponin is still elevated from an MI three days ago, a second rise in CK-MB may indicate a new event.
Myoglobin: Too Nonspecific
Myoglobin is released early after myocardial injury (rises within 1-2 hours) but is found in all muscle tissue. It was briefly used as an early marker but has been abandoned because high-sensitivity troponin assays now provide early detection with better specificity.
Chapter 17: Lipids and Cardiovascular Risk
Lipids are hydrophobic molecules that must be transported through the aqueous bloodstream within specialized particles called lipoproteins. Understanding lipoprotein metabolism is essential because derangements in this system cause atherosclerosis-the leading cause of death worldwide.
17.1 Lipoprotein Structure and Function
The Architecture of a Lipoprotein
Every lipoprotein has the same basic structure: a hydrophobic core surrounded by an amphipathic shell.
The core contains the truly hydrophobic lipids-triglycerides and cholesteryl esters. These molecules cannot interact with water at all and must be hidden inside the particle.
The shell consists of phospholipids (with their hydrophilic heads facing outward), unesterified (free) cholesterol, and apolipoproteins. The shell makes the particle water-soluble while keeping the hydrophobic cargo sequestered inside.
Apolipoproteins are the functional components that determine what each lipoprotein does. They serve as ligands for receptors, activators for enzymes, and structural scaffolds for the particle.
The Lipoprotein Classes
Chylomicrons: The dietary lipid transport system - Made by enterocytes from absorbed dietary fat - Largest lipoproteins (80-1000 nm); make serum appear turbid when elevated - Primary apolipoprotein: ApoB-48 (a truncated form of ApoB made only in the intestine) - Function: Deliver dietary triglycerides to peripheral tissues - Remnants are taken up by the liver
VLDL (Very Low-Density Lipoprotein): The hepatic triglyceride export system - Made by hepatocytes to export endogenously synthesized triglycerides - Large particles (30-80 nm) - Primary apolipoprotein: ApoB-100 (full-length ApoB) - Function: Deliver hepatic triglycerides to peripheral tissues - Metabolized to IDL, then LDL
LDL (Low-Density Lipoprotein): The cholesterol delivery system - The end-product of VLDL metabolism after triglycerides have been removed - Medium-sized particles (20-25 nm) - Primary apolipoprotein: ApoB-100 (one per particle-this is crucial) - Rich in cholesterol because triglycerides have been depleted - Function: Deliver cholesterol to peripheral tissues - The primary atherogenic lipoprotein
HDL (High-Density Lipoprotein): The reverse cholesterol transport system - Made by liver and intestine; also formed from surface remnants of other lipoproteins - Smallest and densest particles (5-12 nm) - Primary apolipoprotein: ApoA-I - Function: Remove cholesterol from peripheral tissues and return it to the liver - Considered atheroprotective
17.2 LDL: The Central Player in Atherosclerosis
Why LDL Causes Atherosclerosis
LDL particles are small enough to penetrate the arterial endothelium and enter the intima. Once there, they become trapped in the extracellular matrix. Trapped LDL undergoes oxidation and other modifications that make it immunogenic. Modified LDL is engulfed by macrophages, which become lipid-laden “foam cells”-the hallmark of early atherosclerosis.
The key insight is that LDL particle number matters more than LDL cholesterol content. Each LDL particle has exactly one ApoB-100 molecule, so ApoB concentration directly reflects particle number. Two people with identical LDL-C may have very different cardiovascular risk if one has many small, cholesterol-depleted particles (high particle number) and the other has fewer large, cholesterol-rich particles (low particle number).
Measuring LDL Cholesterol
Direct measurement: Homogeneous assays that selectively solubilize LDL and measure its cholesterol content. Used when triglycerides are elevated.
Calculated (Friedewald equation): LDL-C = Total Cholesterol - HDL-C - (Triglycerides ÷ 5)
The “divide by 5” estimates VLDL cholesterol, assuming VLDL is 20% cholesterol by mass (so TG/5 = VLDL-C).
When Friedewald fails: - Triglycerides >400 mg/dL: The TG/VLDL-C ratio is no longer 5:1; VLDL becomes enriched with triglycerides - Non-fasting specimens: Chylomicrons are present, and the equation doesn’t account for them - Type III hyperlipoproteinemia: Abnormal VLDL remnants with different composition
The Martin-Hopkins equation is a newer calculation that uses adjustable factors based on triglyceride and non-HDL-C levels, providing more accurate LDL-C estimates across a wider range of triglyceride levels.
17.3 HDL: More Complex Than “Good Cholesterol”
The Paradox of HDL
For decades, HDL-C was considered protective based on strong epidemiological associations between high HDL-C and reduced cardiovascular events. However, drugs that raise HDL-C (niacin, CETP inhibitors) have failed to reduce cardiovascular events in clinical trials.
The current understanding is that HDL function matters more than HDL quantity. HDL performs reverse cholesterol transport, but a high HDL-C level doesn’t guarantee that these particles are functional. Dysfunctional HDL (seen in inflammation, diabetes, and chronic kidney disease) may even be pro-atherogenic.
17.4 Advanced Lipid Testing
Apolipoprotein B (ApoB)
Since every LDL, VLDL, IDL, and Lp(a) particle contains exactly one ApoB molecule, the ApoB concentration equals the total number of atherogenic particles. This makes ApoB a better predictor of cardiovascular risk than LDL-C, especially in patients with discordance between LDL-C and particle number (common in metabolic syndrome, diabetes, and hypertriglyceridemia).
Clinical use: When LDL-C is at goal but ApoB remains elevated, the patient has many small, dense LDL particles and may benefit from more aggressive therapy.
Lipoprotein(a) [Lp(a)]
Lp(a) is an LDL particle with an additional protein called apolipoprotein(a) attached to its ApoB. This apolipoprotein(a) is structurally similar to plasminogen, which may explain Lp(a)’s prothrombotic effects.
Key features: - Levels are >90% genetically determined - Not significantly affected by diet, exercise, or statins - Elevated Lp(a) is an independent cardiovascular risk factor - Associated with aortic stenosis - Can cause falsely elevated LDL-C measurements (Lp(a) cholesterol is included in LDL-C)
Who to test: Family history of premature cardiovascular disease, personal history despite controlled LDL-C, to refine risk assessment in intermediate-risk patients.
17.5 Lipid Panel Interpretation
Non-HDL Cholesterol
Non-HDL-C = Total Cholesterol - HDL-C
This simple calculation captures all atherogenic lipoproteins (LDL + VLDL + IDL + Lp(a)). It’s particularly useful when triglycerides are elevated because it doesn’t require the assumptions of the Friedewald equation. Many guidelines now use non-HDL-C as a secondary target after LDL-C.
Triglycerides: Marker vs. Cause
Elevated triglycerides are clearly associated with cardiovascular disease, but the causal relationship is debated. Very high triglycerides (>500 mg/dL) are more important for pancreatitis risk than cardiovascular risk. However, triglyceride-rich lipoproteins (VLDL, chylomicron remnants) do appear to contribute to atherosclerosis through mechanisms similar to LDL.
Chapter 18: Endocrine Function Testing
Endocrine disorders often present with nonspecific symptoms-fatigue, weight change, mood disturbance. Laboratory testing is essential for diagnosis, but interpreting endocrine tests requires understanding the feedback loops and physiological rhythms that govern hormone secretion.
18.1 Thyroid Function Testing
The Hypothalamic-Pituitary-Thyroid Axis
The thyroid axis operates through negative feedback: 1. The hypothalamus releases TRH (thyrotropin-releasing hormone) 2. TRH stimulates the anterior pituitary to release TSH (thyroid-stimulating hormone) 3. TSH stimulates the thyroid gland to produce T4 and T3 4. T4 and T3 feed back to suppress TRH and TSH release
This feedback is the key to interpreting thyroid tests. When the thyroid gland fails (primary hypothyroidism), T4 falls and the pituitary responds by dramatically increasing TSH-trying to whip a failing gland into action. When the pituitary fails (secondary hypothyroidism), TSH is low or inappropriately normal despite low T4.
Why TSH Is the Best Screening Test
TSH has an inverse log-linear relationship with free T4. This means that small changes in thyroid hormone produce large changes in TSH. If free T4 drops by 50%, TSH might increase 100-fold. This amplification makes TSH exquisitely sensitive to early thyroid dysfunction.
Primary hypothyroidism: TSH markedly elevated (often >10 mU/L), free T4 low - TSH rises before T4 falls below the reference range - “Subclinical hypothyroidism” = elevated TSH with normal T4
Primary hyperthyroidism: TSH suppressed (<0.1 mU/L), free T4 and/or T3 elevated - In Graves’ disease, stimulating antibodies activate the TSH receptor, so high thyroid hormone feeds back but can’t suppress the autonomous stimulation - T3 toxicosis: Some patients have elevated T3 with normal T4; always check T3 if TSH is suppressed and T4 is normal
Secondary (central) hypothyroidism: TSH low or inappropriately normal, free T4 low - The pituitary is damaged and can’t make TSH - TSH may even be mildly elevated (but the TSH is biologically inactive due to abnormal glycosylation) - Causes: Pituitary adenoma, surgery, radiation, Sheehan syndrome, infiltrative disease
Total vs. Free Thyroid Hormones
More than 99% of circulating T4 and T3 is bound to carrier proteins-primarily thyroxine-binding globulin (TBG), but also transthyretin (prealbumin) and albumin. Only the free (unbound) hormone is biologically active.
Total T4 measures both bound and free hormone. Changes in binding protein levels alter total T4 without changing the patient’s thyroid status: - Increased TBG (pregnancy, estrogen, hepatitis): Total T4 increases, but free T4 and TSH remain normal - Decreased TBG (nephrotic syndrome, androgens, severe illness): Total T4 decreases, but the patient is euthyroid
Free T4 is the metabolically active fraction and is preferred for clinical assessment. Modern free T4 assays are immunoassays that estimate free hormone; truly “free” measurements by equilibrium dialysis are rarely needed.
Thyroid Antibodies
Anti-thyroid peroxidase (anti-TPO): Present in ~95% of Hashimoto thyroiditis and ~75% of Graves’ disease. Indicates autoimmune thyroid disease.
Anti-thyroglobulin: Often measured alongside anti-TPO but less specific. Important because anti-Tg interferes with thyroglobulin tumor marker assays.
TSH receptor antibodies (TRAb): Can be stimulating (Graves’) or blocking (some hypothyroidism). Useful for confirming Graves’ disease and predicting neonatal thyrotoxicosis in pregnant women.
18.2 Adrenal Function Testing
Cortisol Physiology
Cortisol is the body’s primary glucocorticoid, essential for stress response, glucose homeostasis, and immune modulation. Its secretion follows a circadian rhythm-highest in the early morning (to prepare for waking) and lowest at midnight.
The hypothalamic-pituitary-adrenal (HPA) axis controls cortisol: 1. CRH from the hypothalamus stimulates ACTH release from the pituitary 2. ACTH stimulates cortisol synthesis in the adrenal cortex 3. Cortisol feeds back to suppress CRH and ACTH
Testing for Cortisol Excess (Cushing Syndrome)
The challenge in diagnosing Cushing syndrome is that cortisol varies throughout the day and increases with stress. You need tests that either exploit the circadian rhythm or test the integrity of feedback suppression.
Late-night salivary cortisol: Cortisol should be at its nadir at midnight. In Cushing syndrome, the normal circadian rhythm is lost, and midnight cortisol remains elevated. Salivary cortisol reflects free cortisol and is easily collected at home. Two elevated late-night samples are strongly suggestive.
24-hour urine free cortisol: Integrates cortisol production over the entire day, avoiding the problem of spot variability. Elevated in most cases of Cushing syndrome, but can be normal in mild or cyclic disease. False elevations occur with high fluid intake (dilutes urine, increasing collection volume).
1 mg overnight dexamethasone suppression test: Dexamethasone is a potent synthetic glucocorticoid that should suppress ACTH and therefore cortisol. Give 1 mg at 11 PM, measure serum cortisol at 8 AM the next morning. Normal response: cortisol <1.8 μg/dL. Lack of suppression suggests autonomous cortisol production. False positives occur with estrogen use (increases CBG), depression, alcoholism, and drugs that accelerate dexamethasone metabolism.
Testing for Cortisol Deficiency (Adrenal Insufficiency)
Morning cortisol: A random cortisol is useful only at extremes. Morning cortisol <3 μg/dL strongly suggests insufficiency; >18 μg/dL essentially rules it out. Values in between require dynamic testing.
Cosyntropin (ACTH) stimulation test: The gold standard for diagnosing primary adrenal insufficiency. Cosyntropin is synthetic ACTH. In a normal person, ACTH stimulates cortisol production. In primary adrenal insufficiency, the adrenals are destroyed and cannot respond.
Protocol: Administer 250 μg cosyntropin IV or IM. Measure cortisol at 0, 30, and 60 minutes. Normal response: Cortisol ≥18-20 μg/dL at 30 or 60 minutes. Abnormal response: Indicates primary adrenal insufficiency.
Limitation: The cosyntropin test may be normal in recent-onset secondary adrenal insufficiency because the adrenals haven’t yet atrophied. ACTH can still stimulate them. In suspected secondary insufficiency, measure ACTH level (should be low) and consider insulin tolerance test or metyrapone test.
18.3 Diabetes Mellitus Laboratory Diagnosis
The Pathophysiology Behind the Tests
Fasting glucose reflects hepatic glucose output. Normally, insulin suppresses gluconeogenesis overnight. In diabetes, insulin resistance or deficiency allows the liver to produce glucose unchecked.
Postprandial glucose reflects the ability to dispose of a glucose load. After eating, insulin promotes glucose uptake into muscle and fat. In diabetes, this disposal is impaired.
HbA1c reflects average glucose over 2-3 months. Glucose binds non-enzymatically to hemoglobin in proportion to its concentration. Because red blood cells live ~120 days, HbA1c integrates glucose exposure over the RBC lifespan.
Diagnostic Criteria
Any of the following, confirmed on a separate day (unless unequivocal hyperglycemia with symptoms):
| Test | Diabetes | Prediabetes |
|---|---|---|
| Fasting glucose | ≥126 mg/dL | 100-125 mg/dL (IFG) |
| 2-hour OGTT | ≥200 mg/dL | 140-199 mg/dL (IGT) |
| HbA1c | ≥6.5% | 5.7-6.4% |
| Random glucose | ≥200 mg/dL + symptoms | - |
Why fasting glucose requires confirmation: A single elevated fasting glucose could be stress hyperglycemia. Requiring confirmation on a separate day increases specificity.
HbA1c caveats: Conditions that alter RBC lifespan affect HbA1c accuracy: - Shortened RBC survival (hemolysis, blood loss, hemoglobinopathies): Falsely low HbA1c - Prolonged RBC survival (splenectomy, aplastic anemia): Falsely high HbA1c - Hemoglobin variants (HbS, HbC, HbE): May interfere depending on the assay method
18.4 Hypoglycemia Evaluation
Hypoglycemia in a non-diabetic adult is rare and demands investigation. The diagnostic approach centers on what’s happening to insulin when glucose is low.
The critical sample: When the patient is symptomatic and glucose is <50-55 mg/dL, simultaneously measure: - Glucose (confirm hypoglycemia) - Insulin (should be suppressed if hypoglycemia is appropriate) - C-peptide (marker of endogenous insulin secretion) - Proinsulin (elevated in insulinoma) - β-hydroxybutyrate (should rise when insulin is low) - Sulfonylurea/meglitinide screen
Interpretation Patterns
Insulinoma (endogenous hyperinsulinism): - Insulin: Inappropriately high (≥3 μU/mL when glucose <55) - C-peptide: Elevated (≥0.6 ng/mL)-proves insulin is endogenous - Proinsulin: Elevated (≥5 pmol/L)-insulinomas secrete excess proinsulin - β-hydroxybutyrate: Suppressed (<2.7 mmol/L)-insulin inhibits ketogenesis - Sulfonylurea screen: Negative
Exogenous insulin (factitious hypoglycemia from injected insulin): - Insulin: High - C-peptide: Suppressed (injected insulin has no C-peptide and suppresses endogenous secretion) - The mismatch between high insulin and low C-peptide is diagnostic
Sulfonylurea ingestion (accidental or factitious): - Insulin: High - C-peptide: High (sulfonylureas stimulate endogenous insulin release) - Sulfonylurea screen: Positive - This pattern mimics insulinoma; the drug screen distinguishes them
18.5 Pituitary Function Testing
Growth Hormone
GH secretion is pulsatile and undetectable most of the day, making random GH levels useless. Instead, we use stimulation tests for deficiency and suppression tests for excess.
GH deficiency testing: Insulin tolerance test (gold standard) or glucagon stimulation test. Normal response is GH >5-10 ng/mL.
Acromegaly testing: Oral glucose tolerance test. Give 75g glucose and measure GH. Normal response: GH suppresses to <1 ng/mL. In acromegaly, GH fails to suppress.
IGF-1: Because GH stimulates IGF-1 production by the liver, IGF-1 serves as an integrated marker of GH status. Elevated IGF-1 is the best screening test for acromegaly; low IGF-1 supports GH deficiency.
Chapter 19: Tumor Markers
Tumor markers are substances produced by cancer cells or by the body in response to cancer. While the concept is straightforward, their clinical application is nuanced. Very few tumor markers are useful for screening; most are valuable for monitoring treatment response and detecting recurrence.
19.1 General Principles of Tumor Marker Use
Why Most Tumor Markers Aren’t Good Screening Tests
An ideal screening test has high sensitivity (doesn’t miss cancers) and high specificity (doesn’t produce false positives). Most tumor markers fail on specificity-they’re elevated in many benign conditions.
The problem of false positives: If a marker has 95% specificity and you screen 1,000 healthy people, 50 will have false-positive results. If the cancer prevalence is 1%, only 10 of those 1,000 actually have cancer. Your positive predictive value is dismal-most people with elevated markers don’t have cancer.
The consequence: Inappropriate anxiety, unnecessary imaging, biopsies, and even surgery for benign conditions.
Appropriate Uses of Tumor Markers
Monitoring treatment response: If a marker is elevated at diagnosis and falls with treatment, rising levels suggest recurrence or progression. This is the most validated use of tumor markers.
Prognosis at diagnosis: Initial marker levels often correlate with tumor burden and prognosis.
Detecting recurrence: In patients with known cancer history, rising markers may detect recurrence before imaging.
Diagnosis in specific contexts: When a patient presents with metastatic disease of unknown primary, tumor markers can suggest the tissue of origin.
19.2 Prostate-Specific Antigen (PSA)
The Biology of PSA
PSA is a serine protease produced almost exclusively by prostatic epithelial cells. Its physiologic function is to liquefy semen. PSA is prostate-specific, not cancer-specific-any process that disrupts prostatic architecture releases PSA into the bloodstream.
Causes of elevated PSA: - Prostate cancer - Benign prostatic hyperplasia (BPH)-larger prostate = more PSA - Prostatitis (inflammation disrupts tissue) - Recent ejaculation (transient elevation) - Prostate manipulation (biopsy, surgery) - Urinary retention
PSA Forms and Ratios
PSA circulates in multiple forms: - Complexed PSA: Bound to protease inhibitors (α1-antichymotrypsin, α2-macroglobulin) - Free PSA: Unbound to any protein
Total PSA is the standard measurement (detects complexed + free PSA; α2-macroglobulin-bound PSA is not detected by most assays).
Free PSA ratio (% free PSA = free PSA / total PSA × 100): Cancer cells tend to release more complexed PSA, while BPH releases more free PSA. A low free PSA ratio (<10%) suggests cancer; a high ratio (>25%) suggests BPH. This is most useful when total PSA is in the “gray zone” (4-10 ng/mL).
PSA density (PSA / prostate volume): Adjusts for gland size. Higher density suggests cancer rather than BPH.
PSA velocity: The rate of PSA change over time. Rapidly rising PSA is more concerning than stable elevation.
The PSA Screening Controversy
PSA screening detects prostate cancer early, but many detected cancers are indolent and would never cause symptoms or death. Overdiagnosis leads to overtreatment, with attendant morbidity (incontinence, impotence) from surgery or radiation.
Current guidelines recommend shared decision-making: discuss the risks and benefits with patients aged 55-69, and offer screening to those who value early detection after understanding the tradeoffs.
19.3 Alpha-Fetoprotein (AFP)
Biology and Normal Physiology
AFP is a major serum protein of the fetus, produced by the yolk sac and fetal liver. It functions similarly to albumin. After birth, AFP levels fall rapidly, reaching adult levels (<10 ng/mL) by age 1-2 years.
Clinical Applications
Hepatocellular carcinoma (HCC): AFP is elevated in 60-80% of HCC cases. It’s used for: - Surveillance in high-risk patients (cirrhosis, chronic hepatitis B): AFP every 6 months with ultrasound - Diagnosis: AFP >400-500 ng/mL in a patient with cirrhosis and a liver mass is highly suggestive of HCC - Prognosis: Higher AFP correlates with worse outcomes - Monitoring treatment response
Important caveat: AFP is also elevated in active hepatitis and cirrhosis without cancer. The level is usually lower (<200 ng/mL), but overlap exists.
Germ cell tumors: AFP is produced by yolk sac tumor elements. In testicular cancer: - Elevated AFP indicates nonseminomatous germ cell tumor (NSGCT)-pure seminomas do not make AFP - AFP elevation with a “seminoma” on histology means there are yolk sac elements that were missed (treat as NSGCT) - Used for staging, prognosis, and monitoring
Neural tube defects: Maternal serum AFP screening (part of the quad screen) detects open neural tube defects (spina bifida, anencephaly), where AFP leaks from fetal CSF into amniotic fluid and maternal blood.
19.4 Human Chorionic Gonadotropin (hCG)
Biology
hCG is a glycoprotein hormone produced by trophoblastic tissue. It maintains the corpus luteum during early pregnancy. The molecule consists of two subunits: α (shared with LH, FSH, TSH) and β (unique to hCG).
β-hCG is what we measure-the β subunit provides specificity for hCG.
Clinical Applications
Pregnancy testing: hCG is detectable in serum ~8-11 days after conception and doubles every 48-72 hours in early normal pregnancy.
Gestational trophoblastic disease (GTD): Molar pregnancies and choriocarcinoma produce massive amounts of hCG (often >100,000 mIU/mL). hCG is used for diagnosis, staging, and monitoring. After mole evacuation, hCG is followed weekly until undetectable, then monthly to ensure no persistent disease.
Germ cell tumors: Choriocarcinoma elements in testicular or ovarian tumors produce hCG. Used similarly to AFP for staging and monitoring.
The hook effect: In sandwich immunoassays, extremely high hCG concentrations can paradoxically produce falsely low results. Excess hCG saturates both capture and detection antibodies independently, preventing sandwich formation. When molar pregnancy or choriocarcinoma is suspected clinically but hCG seems only modestly elevated, request serial dilution to unmask the true level.
19.5 CA-125
Biology
CA-125 (cancer antigen 125) is a high-molecular-weight glycoprotein expressed by coelomic epithelium derivatives, including müllerian duct-derived tissues (ovary, fallopian tube, endometrium) and mesothelial linings (pleura, pericardium, peritoneum).
Clinical Applications
Epithelial ovarian cancer: CA-125 is elevated in ~80% of advanced ovarian cancer but only ~50% of early-stage disease. This limits its utility for screening.
Monitoring known ovarian cancer: CA-125 is most valuable after diagnosis. Falling levels indicate treatment response; rising levels suggest recurrence, often before clinical or imaging evidence.
Screening controversy: CA-125 alone is not recommended for screening average-risk women. Numerous benign conditions elevate CA-125: - Endometriosis - Pelvic inflammatory disease - Menstruation - Pregnancy (first trimester) - Uterine fibroids - Cirrhosis with ascites - Heart failure - Any cause of peritoneal inflammation
Risk algorithms: Combining CA-125 with ultrasound and applying algorithms (ROCA, ROMA) improves specificity. These may have a role in high-risk women (BRCA carriers).
19.6 CA 19-9
Biology
CA 19-9 is a carbohydrate antigen (sialylated Lewis A antigen) expressed on mucin glycoproteins. It requires functional Lewis antigen to be synthesized.
Critical point: Approximately 5-10% of the population is Lewis antigen-negative (especially those of African descent) and cannot produce CA 19-9 regardless of disease state. A low CA 19-9 in these individuals means nothing.
Clinical Applications
Pancreatic adenocarcinoma: CA 19-9 is elevated in ~80% of pancreatic cancer. Used for: - Prognosis: Higher preoperative levels predict worse outcomes - Monitoring: Falling levels suggest response; rising levels suggest progression - Not recommended for screening-many benign causes of elevation
Biliary tract cancer: Also frequently elevated in cholangiocarcinoma.
Benign causes of elevation: Biliary obstruction (any cause), pancreatitis, cirrhosis, other GI malignancies. The degree of elevation is generally lower than in malignancy.
19.7 Carcinoembryonic Antigen (CEA)
Biology
CEA is an oncofetal protein normally produced during fetal development. Low levels persist in adults, particularly in smokers (smoking stimulates CEA production by bronchial epithelium).
Clinical Applications
Colorectal cancer: CEA is the primary tumor marker for CRC: - Preoperative level: Prognostic significance (higher = worse) - Post-resection monitoring: Baseline after surgery; rising CEA may detect recurrence 3-6 months before imaging - Not useful for screening-elevated in too many benign conditions (smoking, IBD, liver disease)
Other cancers: Also elevated in lung, breast, gastric, and pancreatic cancers, but not used as primary marker for these.
19.8 Thyroid Cancer Markers
Thyroglobulin (Tg): Used to monitor differentiated thyroid cancer (papillary and follicular) after thyroidectomy. Tg should be undetectable after complete tumor removal. Rising Tg indicates recurrence.
Critical caveat: Anti-thyroglobulin antibodies (present in 25% of thyroid cancer patients) interfere with Tg immunoassays, potentially causing falsely low results. Always measure anti-Tg antibodies alongside Tg.
Calcitonin: Marker for medullary thyroid carcinoma (MTC), which arises from parafollicular C cells. Used for: - Screening in MEN2 families - Monitoring after surgery - Elevated calcitonin with a thyroid nodule should raise suspicion for MTC
Chapter 20: Protein Electrophoresis and Immunofixation
Serum protein electrophoresis is one of the most interpretively rich tests in laboratory medicine. The pattern of protein bands tells a story about inflammation, liver function, renal losses, and clonal B-cell proliferation. Understanding what each band represents physiologically is the key to interpretation.
20.1 The Principles of Protein Electrophoresis
How It Works
Proteins are amphoteric molecules with both acidic and basic groups. At a given pH, each protein has a net charge determined by its amino acid composition. In an electric field, proteins migrate toward the electrode opposite to their charge.
Serum protein electrophoresis (SPEP) separates proteins in serum on an agarose gel at pH 8.6. At this pH, most serum proteins are negatively charged and migrate toward the anode (positive electrode). Proteins separate into bands based on their charge-to-mass ratio.
After separation, the gel is stained with a protein dye and scanned densitometrically to produce a tracing showing protein concentration at each position.
The Five Major Zones
Moving from anode to cathode (most to least negatively charged):
Albumin: The largest and most prominent peak, representing ~60% of total serum protein. Albumin migrates fastest because it is small and highly negatively charged at pH 8.6.
α1-globulins: The first small peak after albumin. Major components: - α1-antitrypsin (AAT): The dominant protein in this zone; an acute-phase reactant and protease inhibitor - α1-acid glycoprotein (orosomucoid): Acute-phase reactant
α2-globulins: The second small peak. Major components: - α2-macroglobulin: A very large protein that cannot pass through the glomerulus; increased when other proteins are lost - Haptoglobin: Binds free hemoglobin; acute-phase reactant - Ceruloplasmin: Copper transport protein
β-globulins: Often appears as two peaks (β1 and β2). Major components: - Transferrin: Iron transport protein; the dominant β-band protein - C3 complement: Migrates in the β region - β-lipoprotein (LDL)
γ-globulins: The most cathodal zone. Contains: - Immunoglobulins (IgG, IgA, IgM, IgD, IgE) - Because immunoglobulins are produced by many different plasma cell clones with slightly different proteins, normal γ-globulin appears as a broad, diffuse band (polyclonal)
20.2 Interpreting SPEP Patterns
The power of SPEP lies in pattern recognition. Each disease state produces a characteristic pattern.

Acute Inflammation Pattern
What you see: Decreased albumin, increased α1 and α2 globulins
Why it happens: The liver reprioritizes protein synthesis during acute inflammation. Albumin production decreases (albumin is a “negative” acute-phase reactant) while acute-phase proteins in the α1 and α2 zones increase. This shift happens within hours of an inflammatory stimulus.
Common causes: Infection, surgery, trauma, malignancy, autoimmune flares
Chronic Inflammation Pattern
What you see: Polyclonal increase in γ-globulins (broad-based elevation), often with decreased albumin
Why it happens: Chronic antigenic stimulation activates many different plasma cell clones, each producing slightly different immunoglobulins. The result is a diffuse increase across the entire γ region.
Common causes: Chronic infections (HIV, hepatitis, tuberculosis), autoimmune diseases (SLE, rheumatoid arthritis), cirrhosis
Nephrotic Syndrome Pattern
What you see: Markedly decreased albumin, increased α2-globulins, decreased γ-globulins
Why it happens: The damaged glomerulus leaks proteins based on size. Albumin (66 kDa) and immunoglobulins (150-900 kDa) are lost in urine. α2-macroglobulin (720 kDa) is too large to pass through even a damaged glomerulus, so it’s retained-and the liver actually increases its synthesis to compensate for the low oncotic pressure.
Cirrhosis Pattern
What you see: Decreased albumin, β-γ bridging (fusion of β and γ zones)
Why it happens: The cirrhotic liver produces less albumin. Meanwhile, impaired hepatic clearance of antigens from the gut allows chronic antigenic stimulation, producing polyclonal immunoglobulin elevation. The characteristic “β-γ bridging” occurs because IgA (elevated in cirrhosis) migrates in the region between β and γ, filling in the normal valley between these zones.
Monoclonal Gammopathy Pattern
What you see: A sharp, discrete spike (M-spike or M-protein) usually in the γ region, sometimes in β
Why it happens: A single clone of plasma cells has expanded and produces a single, homogeneous immunoglobulin. Because all molecules are identical, they migrate to exactly the same position, creating a sharp spike rather than a diffuse band.

Critical point: An M-spike on SPEP indicates a monoclonal protein is present but doesn’t tell you what it is. You need immunofixation to characterize it.
20.3 Immunofixation Electrophoresis (IFE)
IFE is the reflex test when SPEP shows an M-spike (or is suspicious for a small M-spike). It identifies the specific heavy chain class (IgG, IgA, IgM) and light chain type (κ or λ) of the monoclonal protein.
The Technique
Serum is applied to multiple lanes on a gel. After electrophoresis, each lane is overlaid with a different antiserum: - Anti-γ (IgG heavy chain) - Anti-α (IgA heavy chain) - Anti-μ (IgM heavy chain) - Anti-κ (kappa light chain) - Anti-λ (lambda light chain) - One lane with fixative alone (total protein reference)
The antisera precipitate their target proteins, which are then stained. A monoclonal protein appears as a discrete band in one heavy chain lane (or none, for light chain only disease) and one light chain lane.
Interpreting IFE
Example: A band appears in the anti-γ lane and the anti-κ lane at the same position. Interpretation: IgG kappa monoclonal protein.
Light chain disease: A band appears in the κ or λ lane but not in any heavy chain lane. This indicates free monoclonal light chains without attached heavy chains-seen in light chain myeloma and AL amyloidosis.
Biclonal gammopathy: Two separate bands, representing two independent clones. Can be two different immunoglobulin types or the same type at different positions.
20.4 Serum Free Light Chains
This assay measures light chains that are circulating free (unbound to heavy chains), not those incorporated into intact immunoglobulins.
Why This Test Exists
Normal plasma cells produce a slight excess of light chains over heavy chains. These free light chains are small (~25 kDa) and rapidly filtered by the glomerulus, then reabsorbed by the proximal tubule. Serum levels are normally low.
In plasma cell neoplasms, the malignant clone may produce: - Intact immunoglobulin + excess free light chains - Free light chains only (light chain myeloma) - Little or no measurable protein (nonsecretory myeloma)
Free light chain testing is more sensitive than SPEP for detecting small amounts of monoclonal light chains, especially in: - Light chain myeloma (no intact immunoglobulin to see on SPEP) - AL amyloidosis (often low levels of monoclonal protein) - Oligosecretory myeloma (minimal protein production)
The κ/λ Ratio
Polyclonal plasma cell expansion produces both κ and λ light chains in proportion, maintaining a normal ratio (~0.26-1.65, laboratory dependent).
Clonal plasma cell expansion produces either κ or λ light chains (whichever the clone happens to make), skewing the ratio: - Elevated κ/λ ratio: κ-producing clone - Decreased κ/λ ratio: λ-producing clone
Renal impairment caveat: Free light chains are cleared by the kidneys. In renal failure, both κ and λ accumulate, but κ accumulates more (it’s cleared faster normally). The reference range for patients with eGFR <60 is wider (~0.37-3.1).
20.5 Clinical Applications: Plasma Cell Dyscrasias
Multiple Myeloma
Multiple myeloma is a malignant proliferation of plasma cells producing monoclonal immunoglobulin. The diagnosis requires demonstrating clonal plasma cells AND evidence of myeloma-related organ damage or biomarkers of malignancy.
Diagnostic Criteria (IMWG):
≥10% clonal bone marrow plasma cells OR biopsy-proven plasmacytoma PLUS one or more of:
CRAB criteria (myeloma-defining organ damage): - Calcium: >11 mg/dL (or >1 mg/dL above normal) - Renal: Creatinine >2 mg/dL (or CrCl <40 mL/min) - Anemia: Hemoglobin <10 g/dL (or >2 g/dL below normal) - Bone: ≥1 lytic lesion on skeletal survey, CT, or PET-CT
SLiM criteria (biomarkers predicting progression): - Sixty: ≥60% clonal plasma cells in bone marrow - Light chain ratio: Involved/uninvolved serum free light chain ratio ≥100 - MRI: >1 focal lesion on MRI (≥5 mm)
The SLiM criteria allow treatment of “smoldering” myeloma that has high-risk features, before CRAB damage occurs.
MGUS (Monoclonal Gammopathy of Undetermined Significance)
MGUS is a premalignant condition found in ~3% of people over 50. Definition: - M-protein <3 g/dL - Clonal plasma cells <10% of bone marrow - No CRAB or SLiM criteria - No other B-cell lymphoproliferative disorder
Risk of progression: ~1% per year transform to myeloma or related disorder. Risk stratification uses M-protein size, type (IgG lower risk than non-IgG), and free light chain ratio.
Waldenström Macroglobulinemia
A lymphoplasmacytic lymphoma producing monoclonal IgM. The high molecular weight of IgM pentamers causes hyperviscosity syndrome at high concentrations (blurred vision, bleeding, neurological symptoms). SPEP shows an M-spike; IFE confirms IgM type.
Chapter 21: Toxicology
Clinical toxicology is fundamentally about understanding the relationship between drug concentration and effect. Whether assessing overdose, therapeutic drug monitoring, or workplace drug testing, the laboratory provides critical information-but only if you understand both the analytical methods and their limitations.
21.1 Principles of Drug Screening
The Two-Tier Testing System
Drug testing uses a two-tier approach: immunoassay screening followed by confirmatory testing when needed.
Immunoassay screening is designed for speed and sensitivity. Antibodies are raised against drug molecules or their metabolites. When the target drug is present in the sample, it competes with labeled drug for antibody binding, generating a measurable signal.
The trade-off: To achieve high sensitivity, immunoassays use antibodies with some degree of cross-reactivity. They detect drug classes rather than specific drugs. A positive screen means “something structurally similar to the target was detected”-not necessarily the target drug itself.
Confirmatory testing by mass spectrometry (GC-MS or LC-MS/MS) identifies the exact molecular species present. It is highly specific and legally defensible. However, it is more expensive and slower than immunoassay, so it’s reserved for confirming positive screens.
Understanding Immunoassay Cross-Reactivity
Cross-reactivity is both a feature and a bug. Some cross-reactants are clinically relevant (other drugs of abuse), while others are innocent (medications, foods).
Amphetamine immunoassays cross-react with: - Methamphetamine and MDMA (true positives) - Pseudoephedrine, phenylephrine (decongestants) - Bupropion and its metabolites - Phentermine (diet pills) - Selegiline (MAO inhibitor)
The clinical implication: A positive amphetamine screen in a patient taking Wellbutrin (bupropion) should prompt confirmatory testing before concluding they used methamphetamine.
Opiate immunoassays vary in what they detect: - Traditional “opiate” assays detect morphine and codeine well - They poorly detect synthetic opioids: fentanyl, methadone, oxycodone, buprenorphine - Many labs now use separate assays for these synthetics - False positives: Poppy seeds (contain morphine and codeine), quinolone antibiotics (some assays), rifampin
Benzodiazepine immunoassays are optimized for older benzodiazepines (diazepam, chlordiazepoxide) that metabolize to oxazepam-like compounds. They often miss: - Lorazepam (direct glucuronidation, no oxazepam metabolite) - Clonazepam (different metabolic pathway) - Alprazolam (metabolite may not cross-react well)
Cannabinoid immunoassays detect THC-COOH, the major urinary metabolite of marijuana. THC is lipophilic and accumulates in fat, then slowly releases. Heavy chronic users may test positive for weeks after last use.
Cut-off Concentrations
Immunoassays use cut-off concentrations to define “positive” and “negative.” These cut-offs are not toxicological thresholds-they’re administrative decisions balancing sensitivity against false-positive rates.
Federal workplace testing cut-offs (SAMHSA) are intentionally high to minimize false positives: - Marijuana metabolites: 50 ng/mL (screening), 15 ng/mL (confirmation) - Cocaine metabolites: 150 ng/mL (screening), 100 ng/mL (confirmation) - Opiates: 2000 ng/mL (screening), varies by compound (confirmation) - Amphetamines: 500 ng/mL (screening), 250 ng/mL (confirmation)
Clinical testing may use lower cut-offs to maximize detection. Always know your laboratory’s cut-offs when interpreting results.
21.2 Confirmation by Mass Spectrometry
Mass spectrometry identifies compounds by their mass-to-charge ratio and fragmentation patterns. It is the definitive method for drug identification.
Gas Chromatography-Mass Spectrometry (GC-MS): The historical gold standard. Sample is vaporized, separated by gas chromatography, then ionized (electron impact ionization) and analyzed by mass spectrometry. Excellent for volatile compounds. Requires derivatization for many drugs.
Liquid Chromatography-Tandem Mass Spectrometry (LC-MS/MS): Increasingly dominant. Sample stays in liquid phase, separated by LC, then analyzed by two mass spectrometers in sequence (MS/MS). More versatile than GC-MS; handles polar and high-molecular-weight compounds without derivatization.
The key advantage of mass spectrometry is specificity: each compound has a unique mass spectrum. A positive result means that specific molecule was present, not merely something that cross-reacted with an antibody.
21.3 Therapeutic Drug Monitoring
Therapeutic drug monitoring (TDM) optimizes dosing for drugs with narrow therapeutic windows-where the difference between effective and toxic concentrations is small. Understanding the pharmacokinetics, proper sampling times, and interpretation of levels is essential.
Principles of TDM
Pharmacokinetics determines how concentration changes over time: - Absorption: Rate and extent of drug reaching systemic circulation - Distribution: How drug spreads to tissues; affects volume of distribution - Metabolism: Hepatic (mainly CYP450), renal, or other biotransformation - Elimination: Clearance from the body; determines half-life
Key concepts: - Half-life: Time for concentration to decrease by 50% - Steady-state: Achieved after 4-5 half-lives; input equals output - Trough level: Lowest concentration, just before next dose - Peak level: Highest concentration, after distribution phase complete
Why some drugs need monitoring: - Narrow therapeutic index (small margin between effective and toxic) - Large interindividual variability in pharmacokinetics - Serious consequences of under- or overdosing - Concentrations correlate better with effect than doses do - Need to verify compliance or absorption
The TDM Quick Reference Table
| Drug | Therapeutic Range | Sample Timing | Key Toxicities | Notes |
|---|---|---|---|---|
| Gentamicin/Tobramycin | Peak 5-10 μg/mL; Trough <2 μg/mL | Peak: 30 min post-infusion; Trough: just before dose | Nephrotoxicity, ototoxicity | Extended-interval dosing uses random level |
| Amikacin | Peak 20-35 μg/mL; Trough <10 μg/mL | Same as above | Same as above | Higher target peaks |
| Vancomycin | Trough 10-20 μg/mL; AUC 400-600 | Trough: just before dose | Nephrotoxicity (with troughs >20) | AUC/MIC monitoring now preferred |
| Digoxin | 0.8-2.0 ng/mL (0.5-1.0 for HF) | ≥6 hours post-dose | Arrhythmias, GI, visual | Hypokalemia increases toxicity |
| Lithium | 0.6-1.2 mEq/L | 12 hours post-dose | Tremor, renal, thyroid, cardiac | Dehydration increases levels |
| Phenytoin | Total: 10-20 μg/mL; Free: 1-2 μg/mL | Trough | Ataxia, nystagmus, gingival hyperplasia | Use free level if low albumin |
| Valproic acid | 50-100 μg/mL | Trough | Hepatotoxicity, tremor, weight gain | Highly protein-bound |
| Carbamazepine | 4-12 μg/mL | Trough | Aplastic anemia, SIADH, rash | Autoinduction over 2-4 weeks |
| Phenobarbital | 15-40 μg/mL | Trough (long half-life) | Sedation, respiratory depression | Very long half-life (~100 hours) |
| Tacrolimus | 5-15 ng/mL (varies) | Trough (12 hours post-dose) | Nephrotoxicity, neurotoxicity, DM | Whole blood; CYP3A4 interactions |
| Cyclosporine | 100-400 ng/mL (varies) | Trough or C2 (2-hour) | Nephrotoxicity, HTN, tremor | Whole blood; CYP3A4 interactions |
| Sirolimus | 5-15 ng/mL (varies) | Trough | Hyperlipidemia, myelosuppression | Long half-life (~60 hours) |
| Theophylline | 10-20 μg/mL | Trough | Seizures, arrhythmias, GI | Rarely used now |
Aminoglycosides: Detailed Considerations
Mechanism of action: Bind 30S ribosomal subunit; concentration-dependent killing (higher peaks = better bacterial kill)
Toxicity mechanisms: - Nephrotoxicity: Accumulates in proximal tubule cells; causes acute tubular necrosis - Risk correlates with duration of exposure (trough levels) - Usually reversible - Ototoxicity: Damages hair cells in cochlea and vestibular apparatus - May be irreversible - Risk correlates with cumulative dose and peak levels
Traditional dosing (multiple daily doses): - Peak (30 min after infusion): Target 5-10 μg/mL (gentamicin/tobramycin) - Trough (just before next dose): Target <2 μg/mL
Extended-interval dosing (once daily): - Exploits concentration-dependent killing and post-antibiotic effect - Single high dose (5-7 mg/kg) followed by drug-free interval - Monitoring: Single random level with nomogram (Hartford nomogram) - Lower nephrotoxicity than traditional dosing (longer drug-free interval allows tubule recovery) - NOT appropriate for: endocarditis, pregnancy, severe renal impairment, burns >20% BSA
Vancomycin: The AUC/MIC Era
Traditional approach: Trough-based monitoring - Trough target 10-20 μg/mL (15-20 for serious MRSA infections) - Problem: Trough correlates with nephrotoxicity but imperfectly with efficacy
Current approach: AUC/MIC-guided dosing - AUC (area under the concentration-time curve) better predicts efficacy - Target AUC/MIC 400-600 for MRSA infections - Can be estimated from two levels (peak and trough) or Bayesian software with one level - Reduces nephrotoxicity compared to targeting high troughs
Nephrotoxicity risk factors: - Troughs >20 μg/mL - Concurrent nephrotoxins (aminoglycosides, piperacillin-tazobactam, NSAIDs, contrast) - Prolonged therapy - ICU patients, those with underlying renal disease
Digoxin: The Challenging Drug
Why monitoring is complex: - Very long half-life (36-48 hours; longer in renal impairment) - Extensive tissue binding; slow distribution phase - Symptoms of toxicity overlap with indications (arrhythmias)
Sampling time is critical: Draw level at least 6 hours (preferably 8-12 hours) after dose. Earlier sampling overestimates true steady-state concentration because the drug is still distributing.
Factors increasing toxicity at any given level: - Hypokalemia: Digoxin competes with K+ for Na-K-ATPase; low K+ increases binding and toxicity - Hypomagnesemia: Often coexists with hypokalemia; increases toxicity risk - Hypercalcemia: Sensitizes heart to digoxin - Hypothyroidism: Decreases clearance - Renal impairment: Decreases clearance (digoxin is ~70% renally eliminated)
Drug interactions: - Amiodarone, verapamil, quinidine: Increase digoxin levels (reduce digoxin dose by 50%) - Diuretics: Cause hypokalemia, increasing toxicity risk
Toxicity manifestations: - GI: Nausea, vomiting, anorexia - Visual: Yellow-green halos, photophobia - Cardiac: Almost any arrhythmia, but classically: - Increased automaticity (PVCs, atrial tachycardia) - Decreased conduction (AV block) - “Regularization” of atrial fibrillation (suggests AV nodal toxicity) - Bidirectional VT (classic but rare)
Digoxin immune Fab (Digibind): Binds free digoxin; used for life-threatening toxicity. After administration, total digoxin level becomes uninterpretable (measures bound + unbound).
Phenytoin: Nonlinear Kinetics
Unique pharmacokinetics: Phenytoin exhibits Michaelis-Menten (saturable) kinetics-as dose increases, metabolism becomes saturated, and small dose increases cause disproportionately large concentration increases. This makes dosing adjustments tricky.
Protein binding considerations: Phenytoin is ~90% bound to albumin. Only free (unbound) phenytoin is pharmacologically active.
When to measure free phenytoin: - Hypoalbuminemia (cirrhosis, nephrotic syndrome, malnutrition, critical illness) - Renal failure (uremia displaces phenytoin from albumin) - Pregnancy (altered protein binding) - Concurrent drugs that displace phenytoin (valproic acid, aspirin)
The Winter-Tozer equation: Estimates total phenytoin level that would be expected if albumin were normal:
Adjusted phenytoin = Measured phenytoin / [(0.2 × albumin) + 0.1]
For renal failure, use: Adjusted = Measured / [(0.1 × albumin) + 0.1]
Or simply measure free phenytoin level (therapeutic: 1-2 μg/mL)
Immunosuppressants: Transplant Survival Depends on TDM
Why whole blood? Tacrolimus, cyclosporine, and sirolimus concentrate in red blood cells. Measuring in whole blood (not serum/plasma) captures the true body burden.
Tacrolimus: - Mechanism: Binds FKBP12, inhibits calcineurin, blocks T-cell activation - Trough target: Varies by organ (kidney typically 5-15 ng/mL), time post-transplant (higher early), and rejection risk - Major toxicities: Nephrotoxicity (vasoconstriction), neurotoxicity (tremor, headache, seizures), new-onset diabetes - Metabolized by CYP3A4 and affected by P-glycoprotein - Levels INCREASE with: azoles, diltiazem, macrolides, grapefruit juice - Levels DECREASE with: rifampin, phenytoin, St. John’s wort
Cyclosporine: - Mechanism: Same as tacrolimus (calcineurin inhibitor) - Monitoring: Trough (C0) or 2-hour post-dose (C2, better correlates with exposure) - Major toxicities: Nephrotoxicity, hypertension, tremor, gingival hyperplasia, hirsutism - Same CYP3A4 interactions as tacrolimus
Sirolimus (rapamycin): - Mechanism: Binds FKBP12 but inhibits mTOR (not calcineurin)-antiproliferative - Very long half-life (~60 hours); takes 1-2 weeks to reach steady-state - Trough monitoring; target varies by use - Major toxicities: Hyperlipidemia, myelosuppression, impaired wound healing, interstitial pneumonitis - Often used to minimize calcineurin inhibitor exposure (to spare kidneys)
Lithium: Narrow Window and Dangerous Interactions
Therapeutic range: 0.6-1.2 mEq/L for maintenance; 1.0-1.5 mEq/L for acute mania
Sampling: Always 12 hours post-dose (standardized because of variability in absorption)
Toxicity spectrum: - Mild (1.5-2.0 mEq/L): Tremor, nausea, diarrhea, lethargy - Moderate (2.0-2.5 mEq/L): Confusion, ataxia, dysarthria, coarse tremor - Severe (>2.5 mEq/L): Seizures, coma, cardiac arrhythmias, death
Factors that increase lithium levels (all decrease renal clearance): - Dehydration/volume depletion: Any cause (vomiting, diarrhea, sweating, poor intake) - NSAIDs: Decrease renal blood flow - ACE inhibitors/ARBs: Decrease GFR - Thiazide diuretics: Increase proximal tubule lithium reabsorption (paradoxically; loop diuretics are safer) - Renal impairment: Lithium is 100% renally eliminated
Chronic lithium effects to monitor: - Nephrogenic diabetes insipidus: Lithium impairs collecting duct response to ADH; polyuria/polydipsia - Hypothyroidism: Lithium inhibits thyroid hormone release (check TSH regularly) - Chronic kidney disease: Long-term lithium can cause interstitial nephritis
21.4 Toxicology of Specific Agents
Acetaminophen (Paracetamol) Toxicity
Acetaminophen is safe at therapeutic doses but highly hepatotoxic in overdose. Understanding the mechanism is essential.
Normal metabolism: Most acetaminophen is conjugated (glucuronidation, sulfation) and excreted harmlessly. A small fraction is oxidized by CYP2E1 to NAPQI (N-acetyl-p-benzoquinone imine), a highly reactive metabolite. NAPQI is immediately conjugated with glutathione and excreted.
Overdose metabolism: Glucuronidation and sulfation pathways become saturated. More drug is shunted through CYP2E1 to NAPQI. Glutathione stores are depleted. Unconjugated NAPQI accumulates and covalently binds to hepatocyte proteins, causing cell death.
Clinical timeline: - 0-24 hours: Often asymptomatic or nonspecific (nausea, vomiting) - 24-72 hours: Transaminases rise; hepatotoxicity becomes apparent - 72-96 hours: Peak liver injury; possible liver failure, coagulopathy, encephalopathy - >96 hours: Recovery (if patient survives) or death
The Rumack-Matthew nomogram: Plots serum acetaminophen concentration against time since ingestion. A level above the treatment line indicates significant overdose risk and need for antidote. - Only valid for single acute ingestions with known time - Not valid for chronic/repeated overdoses or extended-release formulations - The original “150 line” starts at 150 μg/mL at 4 hours
Treatment: N-acetylcysteine (NAC) replenishes glutathione. Most effective if given within 8 hours of ingestion, but provides benefit even later. Oral or IV protocols available.
Salicylate (Aspirin) Toxicity
Salicylate toxicity produces a characteristic acid-base disturbance.
Mechanisms: 1. Direct respiratory center stimulation → Hyperventilation → Respiratory alkalosis (early) 2. Uncoupling of oxidative phosphorylation → Impaired ATP production → Increased lactate → Metabolic acidosis 3. Interference with carbohydrate/fat metabolism → Ketoacidosis
The result is a mixed respiratory alkalosis and metabolic acidosis. Early in poisoning, respiratory alkalosis dominates; later, metabolic acidosis takes over.
Clinical features: Tachypnea, tinnitus, altered mental status, hyperthermia, diaphoresis
Laboratory findings: - Salicylate level (>30 mg/dL significant; >100 mg/dL severe) - ABG: Mixed respiratory alkalosis/metabolic acidosis - Elevated anion gap - Hypokalemia (from renal compensation)
Treatment: Alkalinization of urine (sodium bicarbonate) enhances salicylate excretion by “ion trapping”-salicylic acid becomes ionized in alkaline urine and cannot be reabsorbed. Hemodialysis for severe cases.
Toxic Alcohols
Methanol and ethylene glycol are metabolized to toxic organic acids.
Methanol → Formaldehyde → Formic acid - Formic acid inhibits cytochrome oxidase and damages the optic nerve - Classic presentation: Visual disturbances (“snowstorm” vision), blindness - Lab: Elevated anion gap metabolic acidosis, elevated osmolal gap (early)
Ethylene glycol → Glycolaldehyde → Glycolic acid → Oxalic acid - Glycolic acid causes acidosis; oxalic acid precipitates with calcium (calcium oxalate crystals) - Classic presentation: CNS depression, then cardiopulmonary symptoms, then renal failure - Lab: Elevated anion gap metabolic acidosis, elevated osmolal gap (early), calcium oxalate crystals in urine
Key concept-the osmolal gap: Early after ingestion, the parent alcohol (methanol or ethylene glycol) is present but not yet metabolized. These alcohols are osmotically active, creating an elevated osmolal gap. As metabolism proceeds, the alcohols are converted to organic acids (which contribute to anion gap but not osmolal gap). So: - Early: High osmolal gap, normal anion gap - Late: Normal osmolal gap, high anion gap - In between: Both elevated
Treatment: Fomepizole (or ethanol) inhibits alcohol dehydrogenase, blocking metabolism of the parent alcohol to toxic metabolites. Hemodialysis removes both the alcohol and its metabolites.
Chapter 22: Newborn Screening
Newborn screening is one of public health’s greatest success stories-detecting treatable disorders before clinical symptoms cause irreversible damage. Understanding the methodology, the disorders screened, and the follow-up process is essential for clinical pathology practice.
The Philosophy of Newborn Screening
The principle is simple: some devastating diseases are treatable if detected early but cause permanent damage if diagnosis is delayed until symptoms appear. The classic example is phenylketonuria (PKU)-untreated, it causes severe intellectual disability; treated from birth with dietary phenylalanine restriction, children develop normally.
Wilson and Jungner criteria (1968) guide decisions about which conditions to screen: - The condition is an important health problem - There is an accepted treatment - Facilities for diagnosis and treatment are available - There is a recognizable latent or early symptomatic stage - A suitable test exists - The test is acceptable to the population - The natural history is adequately understood - There is agreement on whom to treat - The cost of finding cases is economically balanced with expenditure on treatment - Case-finding should be a continuous process
Specimen Collection
The dried blood spot (DBS): Blood is collected by heel stick (avoiding the central heel to prevent bone damage) onto special filter paper (Guthrie card). The blood must saturate the paper completely, creating a uniform spot. Proper collection technique is critical-inadequate saturation or layered spots cause invalid results.
Timing: Collection at 24-48 hours of age balances two concerns: - Too early: Some metabolites haven’t accumulated to detectable levels; early discharge may miss abnormalities - Too late: Delays treatment initiation and risks damage
Most programs recommend collection after 24 hours of life but before hospital discharge. Premature and sick infants may need repeat screening.
Tandem Mass Spectrometry: The Technology Revolution
Tandem mass spectrometry (MS/MS) transformed newborn screening. Previously, each disorder required a separate test. MS/MS can detect dozens of metabolites simultaneously from a single blood spot, enabling screening for 40+ disorders at once.
How it works: 1. Metabolites are extracted from the dried blood spot 2. Electrospray ionization creates charged molecules 3. First mass analyzer (Q1) selects parent ions by mass-to-charge ratio 4. Collision cell fragments the ions 5. Second mass analyzer (Q3) measures specific fragment ions 6. The combination of parent mass and fragment mass uniquely identifies each metabolite
Why MS/MS is ideal for newborn screening: - High specificity (identifies specific metabolites, not just classes) - High sensitivity - Multiplex capability (many analytes from one specimen) - Rapid throughput - Small sample volume
Disorders Screened
The Recommended Uniform Screening Panel (RUSP) standardizes newborn screening across the US. The core panel includes:
Amino Acid Disorders
| Disorder | Analyte | Consequence if Untreated | Treatment |
|---|---|---|---|
| Phenylketonuria (PKU) | ↑ Phenylalanine | Intellectual disability, seizures | Phe-restricted diet |
| Maple Syrup Urine Disease (MSUD) | ↑ Leucine, isoleucine, valine | Encephalopathy, death | BCAA-restricted diet |
| Homocystinuria | ↑ Methionine | Intellectual disability, lens dislocation, thrombosis | B6, methionine-restricted diet |
| Tyrosinemia Type I | ↑ Tyrosine, succinylacetone | Liver failure, HCC | Nitisinone + diet |
| Citrullinemia | ↑ Citrulline | Hyperammonemia, encephalopathy | Protein restriction, nitrogen scavengers |
| Argininosuccinic aciduria | ↑ Argininosuccinic acid | Hyperammonemia | Protein restriction, arginine supplementation |
PKU in detail: Phenylalanine hydroxylase deficiency prevents conversion of phenylalanine to tyrosine. Phenylalanine accumulates and is neurotoxic. Screening measures phenylalanine; elevated levels trigger confirmatory testing. Treatment is lifelong dietary phenylalanine restriction with special medical formulas. Maternal PKU is critical-women with PKU must maintain strict dietary control during pregnancy or their babies (regardless of genotype) suffer teratogenic effects from in utero phenylalanine exposure.
Fatty Acid Oxidation Disorders
| Disorder | Analyte | Consequence if Untreated | Treatment |
|---|---|---|---|
| MCAD deficiency | ↑ C8 acylcarnitine (octanoylcarnitine) | Hypoketotic hypoglycemia, sudden death | Avoid fasting, carnitine supplementation |
| VLCAD deficiency | ↑ C14:1 acylcarnitine | Cardiomyopathy, hypoglycemia | Avoid fasting, MCT supplementation |
| LCHAD deficiency | ↑ 3-OH C16, C18 acylcarnitines | Cardiomyopathy, retinopathy, neuropathy | Avoid fasting, MCT diet |
| Carnitine uptake defect | ↓ Free carnitine | Cardiomyopathy, hypoglycemia | Carnitine supplementation |
MCAD deficiency in detail: Medium-chain acyl-CoA dehydrogenase deficiency is the most common fatty acid oxidation disorder (~1:15,000). During fasting, the body cannot oxidize medium-chain fatty acids for energy. Patients present with hypoketotic hypoglycemia (low glucose, inappropriately low ketones) during illness or fasting, which can cause sudden death. A common mutation (c.985A>G, p.K304E) accounts for ~80% of mutant alleles. Treatment is remarkably simple: avoid prolonged fasting, ensure adequate carbohydrate intake during illness. With early diagnosis and simple precautions, outcomes are excellent.
Organic Acid Disorders
| Disorder | Analyte | Consequence if Untreated | Treatment |
|---|---|---|---|
| Propionic acidemia | ↑ C3 acylcarnitine | Metabolic acidosis, hyperammonemia, developmental delay | Protein restriction, carnitine |
| Methylmalonic acidemia | ↑ C3 acylcarnitine | Similar to propionic acidemia | Protein restriction, B12 (some forms), carnitine |
| Isovaleric acidemia | ↑ C5 acylcarnitine | “Sweaty feet” odor, metabolic crisis | Leucine restriction, glycine supplementation |
| Glutaric acidemia type I | ↑ C5DC (glutarylcarnitine) | Macrocephaly, dystonia after metabolic crisis | Lysine restriction, carnitine, emergency protocol |
| 3-MCC deficiency | ↑ C5OH acylcarnitine | Often benign; some have symptoms | Variable; often no treatment needed |
Endocrine Disorders
Congenital Hypothyroidism: - Screening: TSH (primary) or T4 (with TSH reflex) - Incidence: ~1:2,000-4,000 - Consequences: Intellectual disability, growth failure (cretinism) - Treatment: Levothyroxine-early treatment leads to normal development
Congenital Adrenal Hyperplasia (CAH): - Most commonly 21-hydroxylase deficiency - Screening: 17-hydroxyprogesterone (17-OHP) - Consequences: Salt-wasting crisis (life-threatening), virilization - Treatment: Glucocorticoid and mineralocorticoid replacement - Challenge: High false-positive rate in premature and stressed infants (17-OHP is normally elevated)
Hemoglobinopathies
Screening method: Isoelectric focusing (IEF), high-performance liquid chromatography (HPLC), or capillary electrophoresis
Sickle cell disease (HbSS, HbSC, HbS/β-thalassemia): - Pattern: FS (fetal hemoglobin + sickle hemoglobin, no HbA) - Consequences: Vasoocclusive crises, splenic sequestration, infection susceptibility - Treatment: Penicillin prophylaxis, vaccinations, hydroxyurea, transfusion support - The screened infant may be affected (SS) or carrier (AS)
Hemoglobin interpretation patterns:
| Pattern | Interpretation |
|---|---|
| FA | Normal (F = fetal, A = adult HbA) |
| FAS | Sickle cell trait (carrier) |
| FS | Sickle cell disease (or S/β0-thal)-no HbA |
| FSC | HbSC disease |
| FSA | Sickle/β+-thalassemia (some HbA present) |
| FAC | HbC trait |
| FC | HbC disease |
| F only | May indicate β-thalassemia major (follow up needed) |
Cystic Fibrosis
Screening approach: Immunoreactive trypsinogen (IRT) is elevated in CF due to pancreatic duct obstruction. High IRT triggers either: - DNA analysis for CFTR mutations, OR - Repeat IRT at 2 weeks
Confirmation: Sweat chloride testing (>60 mmol/L diagnostic)
Treatment impact: Early identification allows nutritional optimization, pulmonary therapy initiation, and family counseling before symptoms develop.
Other Conditions
Galactosemia: Deficiency of galactose-1-phosphate uridyltransferase (GALT). Galactose and galactose-1-phosphate accumulate. Presents with liver disease, cataracts, sepsis (especially E. coli). Treatment: Galactose-free diet (no breast milk or standard formula).
Biotinidase deficiency: Cannot recycle biotin. Presents with seizures, hypotonia, skin rash, alopecia. Treatment: Biotin supplementation-simple, cheap, effective.
Severe Combined Immunodeficiency (SCID): Screened by measuring T-cell receptor excision circles (TRECs)-low or absent TRECs indicate T-cell lymphopenia. Early diagnosis allows hematopoietic stem cell transplant before fatal infections occur.
Spinal Muscular Atrophy (SMA): Screened by detecting homozygous SMN1 deletion. New treatments (nusinersen, gene therapy) are most effective when given presymptomatically.
Second-Tier Testing
Some conditions have high false-positive rates on primary screening. Second-tier tests improve specificity:
| Condition | Primary Screen | Second-Tier Test |
|---|---|---|
| CAH | 17-OHP | Steroid profile by LC-MS/MS |
| Tyrosinemia type I | Tyrosine | Succinylacetone |
| MSUD | Leucine/Isoleucine | Allo-isoleucine |
| Homocystinuria | Methionine | Total homocysteine |
Follow-Up and Confirmation
An abnormal newborn screen is NOT a diagnosis-it indicates increased risk requiring follow-up testing.
Follow-up process: 1. Contact family urgently (some conditions cause rapid deterioration) 2. Repeat screen and/or confirmatory testing 3. Confirmatory tests may include: plasma amino acids, urine organic acids, acylcarnitine profile, enzyme assays, molecular genetic testing 4. Refer to metabolic specialist
False positives and negatives: - False positives cause parental anxiety and additional testing costs - False negatives occur with some metabolite disorders if specimen collected too early, with blood transfusion (dilutes abnormal hemoglobin), or with some variants - No screening test is perfect; clinical suspicion should prompt testing even with normal newborn screen
Chapter 23: Body Fluid Analysis
Body fluids provide a window into disease processes occurring in specific anatomic compartments. Unlike blood, which reflects systemic conditions, body fluids reveal local pathology-infection, inflammation, malignancy, or abnormal fluid dynamics. Proper collection, handling, and interpretation are essential because many body fluid tests are time-sensitive and specimen-dependent.
Quick Reference: Body Fluid Analysis
Pleural Fluid: Light’s Criteria (Exudate if ANY ONE met)
| Criterion | Exudate Threshold |
|---|---|
| Protein (fluid/serum ratio) | >0.5 |
| LDH (fluid/serum ratio) | >0.6 |
| LDH (fluid value) | >2/3 upper limit of normal serum LDH |
Interpretation: Transudates result from systemic factors (CHF, cirrhosis, nephrotic syndrome). Exudates result from pleural disease (infection, malignancy, PE, autoimmune).
Ascitic Fluid: SAAG (Serum-Ascites Albumin Gradient)
| SAAG | Interpretation |
|---|---|
| ≥1.1 g/dL | Portal hypertension (cirrhosis, CHF, Budd-Chiari) |
| <1.1 g/dL | Non-portal hypertension (malignancy, TB, nephrotic syndrome, pancreatic) |
Synovial Fluid Classification
| Type | WBC Count | %PMN | Appearance | Causes |
|---|---|---|---|---|
| Normal | <200 | <25% | Clear | - |
| Non-inflammatory | <2,000 | <25% | Clear/yellow | OA, trauma |
| Inflammatory | 2,000-50,000 | >50% | Cloudy | RA, crystals, reactive |
| Septic | >50,000 | >75% | Purulent | Bacterial infection |
Crystal identification: - Gout (MSU): Needle-shaped, negative birefringence (yellow parallel to axis) - Pseudogout (CPPD): Rhomboid, weak positive birefringence (blue parallel to axis)
23.1 Cerebrospinal Fluid (CSF)
Cerebrospinal fluid surrounds the brain and spinal cord, providing mechanical protection, nutrient delivery, and waste removal. CSF is produced by the choroid plexus (about 500 mL/day), circulates through the ventricles and subarachnoid space, and is absorbed by arachnoid granulations. Total CSF volume is only about 150 mL, so it turns over several times daily.
CSF Collection and Handling
CSF is obtained by lumbar puncture, typically at L3-L4 or L4-L5 (below the spinal cord termination). The fluid is collected into sequential tubes:
Tube 1: Chemistry, serology (least likely to have blood from traumatic tap) Tube 2: Microbiology (Gram stain, culture) Tube 3: Cell count (most representative if traumatic tap clears) Tube 4: Special studies (cytology, flow cytometry if indicated)
Critical handling: CSF must be analyzed promptly. WBCs begin to lyse within 1-2 hours at room temperature. Glucose decreases over time. Cell count tubes should be analyzed immediately or refrigerated.
Opening Pressure
Measured with the patient in the lateral decubitus position, legs relaxed. Normal is 6-20 cm H2O (varies by position and patient factors).
Elevated opening pressure indicates: - Increased CSF production (rare) - Decreased CSF absorption (meningitis, subarachnoid hemorrhage) - Obstruction to flow (mass lesion) - Increased venous pressure (venous sinus thrombosis, heart failure) - Idiopathic intracranial hypertension (pseudotumor cerebri)
Quick Reference: CSF Findings in Meningitis
| Parameter | Bacterial | Viral | Fungal/TB |
|---|---|---|---|
| Opening pressure | ↑↑ | Normal or ↑ | ↑ |
| WBC count | ↑↑↑ (>1000) | ↑ (10-500) | ↑ (10-500) |
| Cell type | Neutrophils (>80%) | Lymphocytes | Lymphocytes |
| Protein | ↑↑ (>100 mg/dL) | Normal or ↑ | ↑↑ |
| Glucose | ↓↓ (<40 mg/dL) | Normal | ↓ |
| CSF/serum glucose | <0.4 | >0.6 | <0.4 |
CSF Cell Count
Normal: 0-5 WBCs/μL (all mononuclear cells); 0 RBCs
The cell count distinguishes types of meningitis and other CNS processes:
Bacterial meningitis produces a robust neutrophilic response. Expect hundreds to thousands of WBCs, predominantly neutrophils (>80%). The meninges are acutely inflamed, and bacteria in the subarachnoid space trigger massive PMN recruitment.
Viral (aseptic) meningitis produces a lymphocytic response, typically 10-500 WBCs with lymphocyte predominance. Early in viral infection (first 24-48 hours), neutrophils may predominate before shifting to lymphocytes.
Tuberculous and fungal meningitis cause a lymphocytic pleocytosis, often with mixed cells including monocytes. The cell count is typically lower than bacterial meningitis (50-500/μL). The chronicity of these infections produces a more indolent inflammatory response.
Traumatic Tap vs. Subarachnoid Hemorrhage
When RBCs are present, distinguishing traumatic tap from true hemorrhage is critical.
Traumatic tap features: - RBC count decreases from tube 1 to tube 4 (blood clears as CSF flows) - No xanthochromia (fresh blood hasn’t broken down) - Clot may form in tube
Subarachnoid hemorrhage features: - RBC count similar in all tubes - Xanthochromia: Yellow discoloration from bilirubin (takes 2-4 hours to develop as RBCs lyse) - Elevated opening pressure
Xanthochromia is best detected by spectrophotometry (measures oxyhemoglobin and bilirubin) rather than visual inspection, which is insensitive.
CSF Protein
Normal: 15-45 mg/dL (lower than serum due to blood-brain barrier)
Elevated protein indicates disruption of the blood-brain barrier or intrathecal production: - Bacterial meningitis: Often >100 mg/dL, sometimes >500 mg/dL - Viral meningitis: Mild elevation (50-100 mg/dL) - TB/fungal meningitis: Moderate elevation - Guillain-Barré: Elevated protein with normal cell count (albuminocytologic dissociation) - Multiple sclerosis: Mildly elevated or normal
CSF Glucose
Normal: 50-80 mg/dL (approximately 60% of serum glucose)
Always interpret CSF glucose relative to serum glucose (draw serum glucose simultaneously).
Low CSF glucose (hypoglycorrhachia) occurs when glucose is consumed by cells or organisms: - Bacterial meningitis: Bacteria metabolize glucose; often <40 mg/dL or <40% of serum - TB/fungal meningitis: Also low due to organism metabolism and inflammation - Viral meningitis: Usually normal (viruses don’t metabolize glucose) - Carcinomatous meningitis: Malignant cells consume glucose
Special CSF Studies
Oligoclonal bands (OCB): Immunoglobulins produced intrathecally appear as discrete bands on CSF electrophoresis that aren’t present in matched serum. Finding ≥2 unique CSF bands (not in serum) supports MS diagnosis. Present in 85-95% of MS patients. Also seen in other inflammatory CNS conditions (neurosarcoidosis, CNS vasculitis, neurosyphilis).
IgG index: Compares CSF IgG to serum IgG, corrected for albumin (which reflects blood-brain barrier integrity): IgG index = (CSF IgG / Serum IgG) / (CSF albumin / Serum albumin) Normal <0.7. Elevated values indicate intrathecal IgG synthesis.
Cryptococcal antigen: Highly sensitive and specific for cryptococcal meningitis. Latex agglutination or lateral flow assay.
VDRL: Specific (not sensitive) for neurosyphilis. Positive CSF VDRL with appropriate clinical picture confirms neurosyphilis. Negative doesn’t rule it out.
23.2 Pleural Fluid
The pleural space normally contains only a few milliliters of fluid, which lubricates the lung surfaces during respiration. Pleural effusions accumulate when fluid production exceeds absorption-either from increased hydrostatic pressure, decreased oncotic pressure, increased capillary permeability, or impaired lymphatic drainage.
The Fundamental Question: Transudate or Exudate?
This distinction guides the entire diagnostic approach.
Transudates result from systemic factors affecting hydrostatic or oncotic pressure. The pleura itself is not diseased. Major causes: - Congestive heart failure (most common cause of pleural effusion overall) - Cirrhosis with ascites (hepatic hydrothorax) - Nephrotic syndrome - Hypoalbuminemia
Exudates result from local pleural disease-inflammation, infection, or malignancy. The pleura is actively involved. Major causes: - Parapneumonic effusion (adjacent pneumonia) - Empyema (pus in pleural space) - Malignancy (lung cancer, breast cancer, lymphoma, mesothelioma) - Pulmonary embolism - Autoimmune disease (lupus, rheumatoid arthritis) - Tuberculosis
Light’s Criteria
The pleural fluid is an exudate if it meets ANY of the following: 1. Pleural protein / serum protein ratio > 0.5 2. Pleural LDH / serum LDH ratio > 0.6 3. Pleural LDH > 2/3 the upper limit of normal serum LDH
These criteria are extremely sensitive for exudates (~98%) but less specific (~83%). Some transudates are misclassified as exudates, particularly in patients on diuretics (concentration of the fluid).
If Light’s criteria indicate exudate but clinical picture suggests transudate (e.g., CHF patient on diuretics), check the serum-pleural albumin gradient: - Gradient > 1.2 g/dL suggests transudate despite meeting Light’s criteria
Additional Pleural Fluid Tests
pH: Normal pleural fluid pH is 7.60 (higher than blood due to bicarbonate transport). Low pH (<7.30) indicates acid production by bacteria or metabolism of glucose by cells. - pH <7.20 in parapneumonic effusion suggests empyema; drainage usually needed - pH <7.30 in malignant effusion predicts poor prognosis
Glucose: Low glucose (<60 mg/dL or <50% of serum) suggests: - Complicated parapneumonic effusion/empyema - Rheumatoid effusion (can be very low) - Malignancy - TB
Adenosine deaminase (ADA): Elevated (>40 U/L) in tuberculous pleuritis (sensitivity ~90%). Useful in areas of high TB prevalence.
Cytology: Positive in about 60% of malignant effusions on first sample; increases with repeated sampling.
Triglycerides: >110 mg/dL indicates chylothorax (thoracic duct injury). Milky appearance.
23.3 Synovial Fluid
Synovial fluid is a viscous ultrafiltrate of plasma combined with hyaluronic acid secreted by synoviocytes. It lubricates joints and provides nutrition to cartilage (which is avascular). Normal joints contain only 1-4 mL of fluid.
Joint aspiration (arthrocentesis) is indicated for any acute monoarticular arthritis to rule out septic arthritis, which is a medical emergency.
Gross Examination
Normal: Clear, colorless to pale yellow, highly viscous
Inflammatory: Yellow, cloudy (from cells), decreased viscosity (hyaluronic acid degraded)
Septic: Turbid, may be frankly purulent
Hemorrhagic: Bloody-suggests trauma, coagulopathy, or (if recurrent) pigmented villonodular synovitis
Viscosity test: Normal synovial fluid forms a long string (4-6 cm) when dripped from a syringe due to hyaluronic acid. Inflammatory fluid has low viscosity and drips like water.
Cell Count Classification
The WBC count is the most useful parameter for classification:
Non-inflammatory (<2,000 WBC/μL, <25% PMNs): - Osteoarthritis - Trauma - Early rheumatoid arthritis (may be higher)
Inflammatory (2,000-50,000 WBC/μL, often >50% PMNs): - Rheumatoid arthritis - Crystal arthropathies (gout, pseudogout) - Reactive arthritis - Psoriatic arthritis
Septic (typically >50,000 WBC/μL, >75% PMNs): - Bacterial infection - Prosthetic joint infection (lower counts may still indicate infection)
Important caveat: These ranges overlap. Crystal arthropathies can produce counts >100,000/μL. Partially treated or indolent infections may have lower counts. When in doubt, treat as potentially infected.
Crystal Analysis
This is one of the most important and underutilized laboratory tests. Compensated polarized microscopy can definitively diagnose gout and pseudogout at the bedside or in the lab.
Monosodium urate crystals (GOUT): - Shape: Needle-shaped, pointed ends - Birefringence: Strongly negative (yellow when parallel to slow axis of compensator) - Size: 5-25 μm, often intracellular during acute attacks - Mnemonic: “Yellow when parallel” = urate

Calcium pyrophosphate dihydrate crystals (PSEUDOGOUT/CPPD): - Shape: Rhomboid or rod-shaped, blunt ends - Birefringence: Weakly positive (blue when parallel to slow axis) - Size: Smaller, 2-10 μm - Often associated with chondrocalcinosis on X-ray

Why this matters: Crystal arthritis and septic arthritis can coexist. Finding crystals doesn’t rule out infection-always send culture if there’s clinical suspicion.
23.4 Ascitic Fluid (Peritoneal Fluid)
Ascites is the pathological accumulation of fluid in the peritoneal cavity. The approach to ascites parallels pleural fluid-first determine if it’s due to portal hypertension or peritoneal disease.
Serum-Ascites Albumin Gradient (SAAG)
The SAAG has replaced the transudate/exudate classification for ascites because it better reflects the underlying pathophysiology.
SAAG = Serum albumin - Ascites albumin
High SAAG (≥1.1 g/dL) indicates portal hypertension: - Cirrhosis (most common) - Alcoholic hepatitis - Cardiac failure (cardiac cirrhosis) - Budd-Chiari syndrome (hepatic vein thrombosis) - Portal vein thrombosis
Low SAAG (<1.1 g/dL) indicates peritoneal disease (no portal hypertension): - Peritoneal carcinomatosis - Tuberculous peritonitis - Pancreatic ascites - Nephrotic syndrome - Serositis (lupus)
Why SAAG works: Portal hypertension creates a hydrostatic pressure gradient that forces fluid (low in albumin) into the peritoneal cavity. The serum albumin is higher than ascitic albumin by at least 1.1 g/dL due to this pressure gradient. In peritoneal disease, the capillaries leak protein, so the gradient is smaller.
Spontaneous Bacterial Peritonitis (SBP)
SBP is infection of ascitic fluid without an obvious intra-abdominal source (e.g., perforation). It occurs almost exclusively in cirrhotic patients due to bacterial translocation from the gut and impaired immune defenses.
Diagnosis: Ascitic fluid PMN count ≥250 cells/μL
Clinical presentation: Fever, abdominal pain, altered mental status, worsening liver function. But many patients have subtle or no symptoms-paracentesis should be performed liberally in cirrhotic patients with new ascites, clinical deterioration, or GI bleeding.
Culture: Often negative even in true SBP. Use blood culture bottles inoculated at the bedside to maximize yield. Monomicrobial in SBP; polymicrobial suggests secondary peritonitis (perforation).
Treatment: Third-generation cephalosporin (cefotaxime) empirically. Albumin infusion reduces mortality by preventing hepatorenal syndrome.
Chapter 24: Autoimmune Serology
Autoimmune diseases occur when the immune system attacks self-antigens. Laboratory testing detects autoantibodies, which serve as markers of disease (and sometimes participate in pathogenesis). Understanding these tests requires knowing which antibodies associate with which diseases-and equally important, understanding their limitations.
24.1 Antinuclear Antibodies (ANA)
The ANA test is the cornerstone of autoimmune serology, serving as a screening test for systemic autoimmune diseases, particularly systemic lupus erythematosus (SLE).
The ANA Test: Method and Interpretation
Indirect immunofluorescence (IIF) on HEp-2 cells remains the gold standard. Patient serum is incubated with HEp-2 cells (a human epithelial cell line), then fluorescent anti-human IgG is added. If the patient has antibodies against nuclear antigens, the nuclei fluoresce.
Titer: Serum is serially diluted. The titer is the highest dilution that still shows fluorescence (e.g., 1:160 means positive at 1:160 dilution). Higher titers are more clinically significant. - <1:40: Negative - 1:40-1:80: Borderline (often seen in healthy individuals) - ≥1:160: More likely to be clinically significant
Pattern: The pattern of nuclear staining suggests which antigens are targeted, guiding further testing.
ANA Patterns and Their Meaning
Homogeneous (diffuse): Uniform staining of the entire nucleus - Antigens: dsDNA, histones, chromatin - Associations: SLE, drug-induced lupus - Most common pattern, but least specific
Speckled: Discrete dots throughout the nucleus (nucleoplasm), sparing the nucleoli - Antigens: Extractable nuclear antigens (ENAs)-Sm, RNP, SSA (Ro), SSB (La) - Associations: SLE, mixed connective tissue disease (MCTD), Sjögren syndrome - Most common pattern overall; often seen in healthy individuals at low titers
Nucleolar: Staining limited to the nucleoli (3-5 bright spots per nucleus) - Antigens: RNA polymerase I/III, fibrillarin, PM-Scl - Associations: Systemic sclerosis (especially diffuse cutaneous)
Centromere (discrete speckled): 46 discrete dots per cell (corresponding to centromeres of chromosomes) - Antigen: Centromere proteins (CENP-A, B, C) - Association: Limited cutaneous systemic sclerosis (CREST syndrome) - Very specific pattern-strongly suggests this diagnosis
Nuclear membrane (rim): Staining at the nuclear periphery - Antigens: dsDNA, nuclear envelope proteins (lamins) - Associations: SLE (especially with nephritis); primary biliary cholangitis (anti-gp210, anti-lamin B receptor)
ANA Limitations
Low specificity: ANA is positive in many conditions besides autoimmune disease: - 5% of healthy young adults - 10-25% of elderly (increases with age) - Infections (EBV, hepatitis C) - Medications (hydralazine, procainamide, isoniazid, many others) - Malignancy
The appropriate response to a positive ANA is to pursue specific antibody testing based on the pattern and clinical context-not to diagnose lupus based on ANA alone.
24.2 SLE-Associated Antibodies
Anti-dsDNA (Anti-double-stranded DNA)
Clinical utility: Highly specific for SLE (~95% specificity). Present in 50-70% of SLE patients.
Why it matters: - Correlates with disease activity-levels rise during flares - Strongly associated with lupus nephritis (forms immune complexes that deposit in glomeruli) - Useful for monitoring: Rising titers may predict flares
Testing methods: - Farr assay (radioimmunoassay): Most specific, detects high-avidity antibodies - Crithidia luciliae IIF: Uses an organism with kinetoplast (pure dsDNA); very specific - ELISA: Most common; may detect low-avidity antibodies (less specific)
Anti-Smith (Anti-Sm)
Clinical utility: Most specific antibody for SLE (~99% specificity), but low sensitivity (~25-30%)
What it targets: Sm proteins are components of small nuclear ribonucleoproteins (snRNPs) involved in mRNA splicing.
Clinical meaning: If positive, it essentially confirms SLE. However, it doesn’t correlate with disease activity and levels remain stable over time.
Anti-Histone
Clinical utility: Present in >95% of drug-induced lupus; also in 50-70% of idiopathic SLE
Drug-induced lupus: Classically caused by hydralazine, procainamide, isoniazid. Presents with arthritis, serositis, constitutional symptoms. Notably spares the kidneys and CNS. Anti-histone positive, anti-dsDNA usually negative. Resolves when drug is stopped.
Anti-SSA (Ro) and Anti-SSB (La)
Clinical associations: - Sjögren syndrome (primary and secondary) - SLE (especially subacute cutaneous lupus, which causes photosensitive rashes) - Neonatal lupus
Neonatal lupus: Maternal anti-SSA (and sometimes anti-SSB) cross the placenta. In the fetus, they can cause: - Congenital heart block: Permanent; requires pacing in severe cases. Risk ~2% in anti-SSA positive mothers - Neonatal lupus rash: Transient; resolves as maternal antibodies clear - Cytopenias: Transient
All pregnant women with known anti-SSA should have fetal heart monitoring.
Laboratory note: Anti-SSA antibodies may cause a negative ANA with a positive anti-SSA because Ro antigens may be lost during HEp-2 cell fixation. Always test specifically for anti-SSA if Sjögren syndrome is suspected, regardless of ANA result.
24.3 Systemic Sclerosis (Scleroderma) Antibodies
Anti-Centromere
Association: Limited cutaneous systemic sclerosis (lcSSc), formerly called CREST syndrome - Calcinosis - Raynaud phenomenon - Esophageal dysmotility - Sclerodactyly - Telangiectasia
Pattern on ANA: Distinctive discrete speckled pattern (46 dots per nucleus)
Prognosis: Generally better prognosis than diffuse SSc. Pulmonary hypertension is the major concern (not interstitial lung disease).
Anti-Scl-70 (Anti-topoisomerase I)
Association: Diffuse cutaneous systemic sclerosis (dcSSc)
Clinical implications: Increased risk of interstitial lung disease (ILD), which is a major cause of mortality. Requires monitoring with pulmonary function tests and high-resolution CT.
Anti-RNA Polymerase III
Association: Diffuse SSc with increased risk of scleroderma renal crisis (acute hypertensive emergency with renal failure)
Also associated with increased risk of concurrent or developing malignancy (SSc as paraneoplastic phenomenon).
24.4 Inflammatory Myopathy Antibodies
Anti-Jo-1 and Other Antisynthetases
Antisynthetase syndrome: A subset of inflammatory myopathy (dermatomyositis/polymyositis) characterized by: - Inflammatory myopathy - Interstitial lung disease (major morbidity) - Arthritis - Mechanic’s hands (rough, cracked skin) - Raynaud phenomenon - Fever
Anti-Jo-1 (anti-histidyl-tRNA synthetase) is the most common antisynthetase antibody (~20% of myositis patients). Other antisynthetases (anti-PL-7, anti-PL-12, etc.) have similar clinical associations.
Anti-Mi-2
Associated with dermatomyositis with classic skin findings (heliotrope rash, Gottron papules). Generally better prognosis-good response to treatment, lower risk of ILD and malignancy.
Anti-MDA5 (Anti-CADM-140)
Associated with clinically amyopathic dermatomyositis (skin findings without muscle weakness) and rapidly progressive interstitial lung disease-a life-threatening complication requiring aggressive immunosuppression.
24.5 ANCA (Anti-Neutrophil Cytoplasmic Antibodies)
ANCA-associated vasculitides are systemic vasculitides affecting small vessels. ANCA testing is essential for diagnosis.
Patterns and Targets
c-ANCA (cytoplasmic pattern): Diffuse granular staining of the cytoplasm - Target: Proteinase 3 (PR3) - Association: Granulomatosis with polyangiitis (GPA, formerly Wegener’s)
p-ANCA (perinuclear pattern): Staining around the nucleus (artifact of fixation-the antigen redistributes) - Target: Myeloperoxidase (MPO) - Association: Microscopic polyangiitis (MPA), eosinophilic granulomatosis with polyangiitis (EGPA, Churg-Strauss)
Important: Always confirm IIF pattern with specific PR3 and MPO antibody testing by ELISA or other immunoassay. Atypical p-ANCA patterns can be seen in IBD and autoimmune hepatitis (directed against other antigens, not MPO).
Clinical Correlations
GPA (Wegener’s): Upper respiratory tract (sinusitis, saddle nose), lower respiratory tract (pulmonary nodules, hemorrhage), and kidney (rapidly progressive glomerulonephritis). PR3-ANCA positive in ~90%.
MPA: Similar to GPA but without granulomatous inflammation. Pulmonary-renal syndrome common. MPO-ANCA positive in ~70%.
EGPA (Churg-Strauss): Asthma, eosinophilia, systemic vasculitis. MPO-ANCA positive in ~40% (more often in those with glomerulonephritis).
24.6 Other Important Autoantibodies
Anti-GBM (Anti-Glomerular Basement Membrane)
Target: Type IV collagen in glomerular and alveolar basement membranes
Disease: Goodpasture syndrome-rapidly progressive glomerulonephritis with pulmonary hemorrhage
Mechanism: The antibody directly attacks the basement membrane (type II hypersensitivity). Linear IgG deposits on kidney biopsy immunofluorescence.
Clinical urgency: Medical emergency. Untreated, leads to irreversible renal failure. Treatment: Plasmapheresis (remove the antibody) + immunosuppression.
Anti-CCP (Anti-Cyclic Citrullinated Peptide)
Disease: Rheumatoid arthritis
Utility: More specific than rheumatoid factor (>95% specific vs. ~80%). Positive in 60-70% of RA patients. Can be positive years before clinical RA develops.
Anti-CCP positivity predicts more aggressive, erosive disease.
Rheumatoid Factor (RF)
What it is: IgM antibody directed against the Fc portion of IgG
Sensitivity: Present in 70-80% of RA patients
Specificity: Poor-RF is elevated in many conditions: - Sjögren syndrome (90%) - SLE (30%) - Chronic infections (endocarditis, hepatitis C) - Elderly without disease (up to 5-10%)
Clinical use: Combined with anti-CCP for RA diagnosis. RF-positive/anti-CCP-positive RA has the worst prognosis.
24.7 Complement Testing
The complement system is a cascade of proteins that enhances (“complements”) the immune response. In autoimmune diseases, complement activation leads to consumption, causing low levels.
C3 and C4 Levels
Both low (C3 and C4 decreased): Classical pathway activation with consumption - Active SLE (especially nephritis)-immune complexes activate classical pathway - Cryoglobulinemia - Severe bacterial infection (consumption)
Low C4, normal C3: Early classical pathway activation or hereditary deficiency - C4 is consumed first in the classical pathway - C4 deficiency (genetic)-associated with SLE susceptibility - Hereditary angioedema (C1 inhibitor deficiency causes C4 consumption)
Low C3, normal C4: Alternative pathway activation - C3 nephritic factor (autoantibody stabilizes C3 convertase, causing C3 consumption) - Membranoproliferative glomerulonephritis
CH50 (Total Hemolytic Complement)
The CH50 is a functional assay measuring the entire classical pathway (C1 through C9). Patient serum is mixed with sheep RBCs coated with antibody. If the classical pathway is intact, complement lyses the RBCs.
Utility: Screens for complete deficiency of any classical pathway component. A very low or absent CH50 suggests homozygous deficiency of one component.
Hereditary complement deficiencies: - Early classical components (C1, C2, C4): Associated with SLE - C3: Severe recurrent bacterial infections - Late components (C5-C9): Susceptibility to Neisseria infections (the membrane attack complex is essential for killing Neisseria)
Chapter 25: Infectious Disease Serology
Serological testing for infectious diseases relies on detecting antibodies (indicating exposure or immunity) or antigens (indicating active infection). Understanding the patterns of antibody response-which antibodies appear when, and what they mean-is essential for interpreting these tests.
Hepatitis B Serology: The Master Table
Hepatitis B serology is notoriously confusing because there are multiple markers, each with different meanings. The key is understanding what each marker represents and then using the pattern to determine the clinical state.
The Markers and What They Mean
HBsAg (Hepatitis B Surface Antigen): The viral coat protein. Its presence indicates the virus is actively replicating-the patient has active infection (acute or chronic). This is the first marker to appear (1-2 weeks before symptoms) and the first marker of infection.
Anti-HBs (Antibody to Surface Antigen): Neutralizing antibody that provides immunity. Its presence indicates either: - Recovery from past infection (with immunity), OR - Successful vaccination
Anti-HBc (Antibody to Core Antigen): Indicates exposure to the virus at some point. The core antigen is internal and not released into blood, so anti-HBc forms only from actual infection-never from vaccination. - Anti-HBc IgM: Indicates recent/acute infection (present for ~6 months) - Anti-HBc IgG (total anti-HBc): Indicates any past or current infection (persists for life)
HBeAg (Hepatitis B e Antigen): A secreted viral protein indicating high viral replication and high infectivity. Its presence means the patient is highly contagious.
Anti-HBe (Antibody to e Antigen): Indicates lower viral replication (seroconversion). The transition from HBeAg-positive to anti-HBe-positive is generally favorable.
HBV DNA: Direct measure of viral load. Most sensitive marker of active replication.
The Interpretation Table
| Clinical State | HBsAg | Anti-HBs | Anti-HBc (total) | Anti-HBc IgM | HBeAg | Interpretation |
|---|---|---|---|---|---|---|
| Susceptible (never infected, not immune) | - | - | - | - | - | No exposure, no vaccination |
| Immune (vaccination) | - | + | - | - | - | Anti-HBs from vaccine; no core antibody because never infected |
| Immune (past infection) | - | + | + | - | - | Cleared infection; anti-HBs provides immunity |
| Acute infection (early) | + | - | + | + | + | Active replication; IgM indicates recent infection |
| Acute infection (window) | - | - | + | + | - | HBsAg cleared but anti-HBs not yet formed; IgM confirms acute |
| Chronic infection (active) | + | - | + | - | +/- | HBsAg >6 months; IgM negative; high infectivity if HBeAg+ |
| Chronic infection (inactive carrier) | + | - | + | - | - | Low replication; anti-HBe positive; lower (but not zero) infectivity |
The Window Period
The “window period” is a critical concept. After acute infection, HBsAg may become undetectable before anti-HBs appears. During this window (which can last weeks), the only positive marker is anti-HBc IgM. This is why blood banks test for anti-HBc-it catches donors in the window period who would be missed by HBsAg testing alone.
Special Scenarios
Isolated anti-HBc positive (anti-HBc positive, everything else negative): - Window period (acute infection)-check IgM - Resolved infection with waned anti-HBs (most common) - Occult HBV infection (low-level chronic infection; check HBV DNA) - False positive
HBsAg positive >6 months = Chronic hepatitis B (by definition)
“e antigen seroconversion”: Transition from HBeAg-positive to HBeAg-negative with anti-HBe appearance. Generally indicates reduced viral replication and improved prognosis-but watch for “e-negative” mutants that replicate despite anti-HBe.
Hepatitis C Serology
Hepatitis C testing is simpler than hepatitis B because there are fewer markers.
The Markers
Anti-HCV: Antibody to hepatitis C virus. Indicates exposure at some point but does NOT distinguish active from resolved infection. Takes 4-10 weeks to appear after infection.
HCV RNA: Direct detection of viral genetic material. Indicates active, current infection.
Interpretation
| Anti-HCV | HCV RNA | Interpretation |
|---|---|---|
| - | - | No HCV infection (or very early acute, before antibody) |
| + | + | Active HCV infection (acute or chronic) |
| + | - | Past infection (cleared spontaneously or treated) OR false positive antibody |
| - | + | Very early acute infection (RNA positive before antibody develops) |
Key point: Unlike hepatitis B, there is no protective antibody for HCV. Anti-HCV does NOT provide immunity-reinfection is possible. About 20-25% of people clear HCV spontaneously; the rest develop chronic infection.
Testing algorithm: 1. Screen with anti-HCV 2. If positive, confirm active infection with HCV RNA 3. If RNA positive, genotype to guide treatment
Hepatitis A Serology
Anti-HAV IgM: Acute hepatitis A infection. Appears at symptom onset, persists ~3-6 months.
Anti-HAV IgG (or total anti-HAV): Past infection or vaccination; indicates immunity.
Key point: Hepatitis A does NOT cause chronic infection. IgM = acute; IgG = immune.
EBV (Epstein-Barr Virus) Serology
EBV serology is used to diagnose infectious mononucleosis and determine immune status. The pattern of antibodies tells you where the patient is in the infection timeline.
The Markers
VCA IgM (Viral Capsid Antigen IgM): Appears early in acute infection; disappears within 4-8 weeks. Indicates acute/recent infection.
VCA IgG (Viral Capsid Antigen IgG): Appears during acute infection; persists for life. Indicates current or past infection.
EA (Early Antigen): Appears during acute infection in ~70-80% of patients; disappears after recovery in most. Persistence may indicate chronic active infection or reactivation. Less commonly used.
EBNA (EBV Nuclear Antigen): Appears late (3-6 months after infection); persists for life. Its presence excludes acute primary infection.
The Interpretation Table
| VCA IgM | VCA IgG | EBNA | Interpretation |
|---|---|---|---|
| - | - | - | Susceptible (never infected) |
| + | + | - | Acute primary infection |
| - | + | - | Early convalescence (recent infection, EBNA not yet positive) |
| - | + | + | Past infection (immune) |
| + | + | + | Probable false positive IgM, OR reactivation (rare) |
Key pattern for boards: In acute infectious mononucleosis, expect VCA IgM positive, VCA IgG positive, EBNA negative. If EBNA is positive, the infection is not acute.

Heterophile antibody (Monospot): A rapid test that detects heterophile antibodies produced during acute EBV infection. Positive in ~85% of adults with infectious mono but may be negative in children and early in illness. A positive Monospot confirms acute EBV in the right clinical context; a negative test should prompt specific EBV serology.
CMV (Cytomegalovirus) Serology
CMV serology is used for determining immune status (important for transfusion and transplant) and diagnosing acute infection.
The Markers
CMV IgM: Indicates recent or active infection. May persist for months, so presence doesn’t definitively indicate acute infection.
CMV IgG: Indicates past infection. Persists for life.
CMV IgG Avidity: Measures how tightly antibodies bind to antigen. Low avidity = recent infection (antibodies mature over time). High avidity = past infection (>3-4 months ago). Useful when IgM is positive and you need to distinguish recent from past infection.
Interpretation
| CMV IgM | CMV IgG | Interpretation |
|---|---|---|
| - | - | Susceptible (seronegative) |
| + | - | Very early acute infection (IgG not yet formed) |
| + | + | Recent infection OR reactivation (check avidity) |
| - | + | Past infection (seropositive, immune) |
Clinical applications: - Pregnancy: Primary CMV during pregnancy carries highest risk to fetus. Low avidity IgG with positive IgM suggests recent infection. - Transplant: CMV-seronegative recipients receiving organs from seropositive donors are at highest risk for CMV disease. - Blood transfusion: CMV-seronegative or leukoreduced blood for at-risk recipients (premature infants, seronegative transplant recipients).
HIV Serology and Testing
The Testing Algorithm
Fourth-generation (Ag/Ab combination) assay: Detects both HIV-1/2 antibodies AND p24 antigen. This is the recommended initial screening test. The p24 antigen component shortens the window period by detecting acute infection before antibodies develop.
| 4th Gen Screen | HIV-1/2 Differentiation | HIV-1 NAT | Interpretation |
|---|---|---|---|
| Negative | - | - | HIV negative (or very early acute) |
| Positive | HIV-1 positive | - | HIV-1 infection confirmed |
| Positive | HIV-2 positive | - | HIV-2 infection confirmed |
| Positive | Negative or indeterminate | Positive | Acute HIV-1 (antibody not yet formed, but RNA present) |
| Positive | Negative or indeterminate | Negative | False positive screen (or rare late seroconversion) |
Window periods (approximate): - RNA (NAT): Detectable ~10-14 days after infection - p24 antigen: Detectable ~14-18 days after infection - Antibody: Detectable ~21-28 days after infection
Syphilis Serology
Covered in the microbiology section, but the key serological points:
Non-treponemal tests (RPR, VDRL): - Detect antibodies to cardiolipin (not specific to syphilis) - Quantitative titers correlate with disease activity - Decrease with treatment (useful for monitoring) - False positives: pregnancy, autoimmune disease, other infections
Treponemal tests (FTA-ABS, TP-PA, EIA/CIA): - Detect antibodies specific to T. pallidum - More specific than non-treponemal tests - Remain positive for life (can’t use to monitor treatment)
Reverse sequence algorithm (increasingly common): 1. Screen with treponemal EIA/CIA 2. If positive, reflex to non-treponemal (RPR) 3. If discordant (EIA+, RPR-), confirm with different treponemal test (TP-PA)
PART III: HEMATOPATHOLOGY
Hematopathology is the study of diseases affecting blood cells and their precursors. It encompasses benign conditions (anemias, coagulopathies) and malignancies (leukemias, lymphomas). Understanding hematopathology requires integrating morphology, laboratory findings, immunophenotype, and molecular genetics.
Taxonomic Overview of Hematologic Diseases
The following classification organizes hematologic diseases by cell lineage. All blood cells derive from a common hematopoietic stem cell (HSC) that differentiates into myeloid and lymphoid progenitors. Understanding where each disease fits in this hierarchy aids in predicting morphology, immunophenotype, clinical behavior, and treatment approach.


I. MYELOID LINEAGE DISORDERS
A. RED BLOOD CELL DISORDERS
- Anemias - Decreased Production (Hypoproliferative)
- Microcytic (MCV <80)
- Iron deficiency anemia - most common worldwide; low ferritin, high TIBC
- Anemia of chronic disease/inflammation - low iron, low TIBC, high ferritin, high hepcidin
- Thalassemias - alpha (gene deletions) and beta (point mutations); target cells, microcytosis out of proportion to anemia
- Sideroblastic anemia - ringed sideroblasts, defective heme synthesis (lead, B6 deficiency, MDS-RS)
- Normocytic (MCV 80-100)
- Anemia of chronic disease (early)
- Chronic kidney disease - decreased erythropoietin
- Aplastic anemia - pancytopenia, hypocellular marrow, fatty replacement
- Pure red cell aplasia - parvovirus B19, thymoma, autoimmune
- Myelophthisic anemia - marrow infiltration (tumor, fibrosis)
- Macrocytic (MCV >100)
- Megaloblastic: B12 deficiency (neurologic symptoms, methylmalonic acid elevated), Folate deficiency (no neuro, homocysteine elevated) - hypersegmented neutrophils, oval macrocytes
- Non-megaloblastic: liver disease, hypothyroidism, MDS, alcohol, reticulocytosis
- Microcytic (MCV <80)
- Anemias - Increased Destruction (Hemolytic)
- Intrinsic (RBC defect)
- Membrane: Hereditary spherocytosis (spectrin/ankyrin, osmotic fragility), Hereditary elliptocytosis, PNH (CD55/CD59 loss, complement-mediated)
- Enzyme: G6PD deficiency (oxidant stress, bite cells, Heinz bodies), Pyruvate kinase deficiency (rigid cells)
- Hemoglobin: Sickle cell disease (HbSS, vaso-occlusion), HbSC disease, HbC disease (target cells, crystals)
- Extrinsic (external to RBC)
- Immune: Warm AIHA (IgG, spherocytes, spleen), Cold AIHA (IgM, complement, agglutination), Drug-induced
- Mechanical: MAHA (TTP, HUS, DIC - schistocytes), Mechanical heart valves, March hemoglobinuria
- Infectious: Malaria, Babesia, Clostridial sepsis
- Intrinsic (RBC defect)
- Polycythemia (Increased RBCs)
- Primary: Polycythemia vera - JAK2 V617F (95%), panmyelosis, low EPO, risk of thrombosis and transformation to myelofibrosis/AML
- Secondary: Appropriate (hypoxia, high altitude, lung disease, cyanotic heart disease) vs Inappropriate (EPO-secreting tumors - RCC, HCC, hemangioblastoma)
- Relative: Dehydration, stress polycythemia (Gaisbock syndrome)
B. WHITE BLOOD CELL DISORDERS - MYELOID NEOPLASMS
- Acute Myeloid Leukemia (AML) - ≥20% blasts, aggressive
- AML with recurrent genetic abnormalities (generally better prognosis)
- APL: t(15;17) PML-RARA - Auer rods, DIC, ATRA therapy, HLA-DR negative
- t(8;21) RUNX1-RUNX1T1 - large blasts, Auer rods, good prognosis
- inv(16)/t(16;16) CBFB-MYH11 - abnormal eosinophils, good prognosis
- t(9;11) KMT2A (MLL) - monocytic features, intermediate prognosis
- NPM1 mutation - cup-like nuclear invaginations, favorable (if no FLT3-ITD)
- Biallelic CEBPA mutation - favorable prognosis
- FLT3-ITD - poor prognosis, targetable with midostaurin/gilteritinib
- AML with myelodysplasia-related changes - multilineage dysplasia, poor prognosis
- Therapy-related AML - prior alkylating agents (del 5/7) or topoisomerase II inhibitors (11q23)
- AML, NOS - classified by differentiation (minimally differentiated through monocytic, erythroid, megakaryocytic)
- AML with recurrent genetic abnormalities (generally better prognosis)
- Myelodysplastic Syndromes (MDS) - cytopenias with dysplasia, <20% blasts
- Refractory anemia, refractory cytopenia with multilineage dysplasia
- MDS with ring sideroblasts - SF3B1 mutation, favorable
- MDS with excess blasts (5-19%) - higher risk of AML transformation
- MDS with isolated del(5q) - thrombocytosis, hypolobated megakaryocytes, lenalidomide responsive
- Key mutations: SF3B1, TET2, ASXL1, TP53 (poor prognosis), RUNX1
- Myeloproliferative Neoplasms (MPN) - clonal proliferation, hypercellular marrow, increased mature cells
- Polycythemia vera (PV) - JAK2 V617F (95%), erythrocytosis, pruritus after bathing, thrombosis
- Essential thrombocythemia (ET) - JAK2, CALR, or MPL mutations; thrombocytosis, bleeding or thrombosis
- Primary myelofibrosis (PMF) - JAK2, CALR, or MPL; marrow fibrosis, teardrop cells, leukoerythroblastic smear, splenomegaly
- Chronic myeloid leukemia (CML) - t(9;22) BCR-ABL1 Philadelphia chromosome; basophilia, three phases (chronic → accelerated → blast crisis); imatinib
- MDS/MPN Overlap
- Chronic myelomonocytic leukemia (CMML) - persistent monocytosis >1000/μL, dysplasia, ±splenomegaly
- Atypical CML - neutrophilia with dysplasia, BCR-ABL1 negative
- Juvenile myelomonocytic leukemia (JMML) - children, RAS pathway mutations
- Mastocytosis
- Systemic mastocytosis - KIT D816V mutation, tryptase elevated, urticaria pigmentosa
- Mast cell leukemia - ≥20% mast cells in marrow, aggressive
C. PLATELET AND MEGAKARYOCYTE DISORDERS
- Thrombocytopenia - Decreased Production
- Marrow failure (aplastic anemia, MDS, infiltration)
- Congenital: Wiskott-Aldrich (small platelets, eczema, immunodeficiency), TAR syndrome, Bernard-Soulier (giant platelets, GPIb deficiency)
- Thrombocytopenia - Increased Destruction
- Immune: ITP (antiplatelet antibodies, diagnosis of exclusion), HIT (PF4 antibodies, thrombosis), Drug-induced, Post-transfusion purpura, Neonatal alloimmune
- Non-immune: TTP (ADAMTS13 deficiency, pentad), HUS (Shiga toxin, renal failure), DIC (consumption)
- Thrombocytopenia - Sequestration
- Hypersplenism, massive splenomegaly
- Thrombocytosis
- Reactive: Iron deficiency, infection, inflammation, malignancy, post-splenectomy
- Clonal: Essential thrombocythemia, other MPNs, MDS with del(5q)
- Qualitative Platelet Disorders
- Glanzmann thrombasthenia - GPIIb/IIIa deficiency, no aggregation to any agonist (except ristocetin)
- Bernard-Soulier - GPIb deficiency, no aggregation to ristocetin, giant platelets
- Storage pool disorders - dense granule or alpha granule deficiency
- Acquired: Uremia, aspirin/NSAIDs, myeloproliferative neoplasms
II. LYMPHOID LINEAGE DISORDERS
A. PRECURSOR LYMPHOID NEOPLASMS
- B-Lymphoblastic Leukemia/Lymphoma (B-ALL)
- TdT+, CD19+, CD10+ (most), surface Ig negative
- Children: most common childhood cancer, excellent prognosis
- Favorable: Hyperdiploidy (>50 chromosomes), ETV6-RUNX1 t(12;21)
- Unfavorable: Hypodiploidy, KMT2A rearrangements (infants), BCR-ABL1 (Philadelphia chromosome ALL)
- Ph-like ALL - poor prognosis, ABL-class or JAK-STAT alterations
- T-Lymphoblastic Leukemia/Lymphoma (T-ALL)
- TdT+, CD3 (cytoplasmic)+, CD7+, variable CD4/CD8
- Often presents as mediastinal mass (thymic), adolescent males
- NOTCH1 mutations common
B. MATURE B-CELL NEOPLASMS
- Small Lymphocytic Lymphoma / Chronic Lymphocytic Leukemia (CLL/SLL)
- Same disease: SLL (nodal), CLL (blood/marrow)
- CD5+, CD19+, CD23+, CD200+, dim CD20, dim surface Ig
- Smudge cells on smear, proliferation centers in lymph node
- Good prognosis: del(13q), mutated IGHV
- Poor prognosis: del(17p)/TP53, del(11q), unmutated IGHV
- Richter transformation to DLBCL (aggressive)
- Mantle Cell Lymphoma
- CD5+, CD19+, CD23 negative, Cyclin D1+, SOX11+
- t(11;14) CCND1-IGH
- Aggressive, often presents advanced stage
- Blastoid variant - very aggressive
- Follicular Lymphoma
- CD10+, CD19+, CD5 negative, BCL2+, BCL6+
- t(14;18) BCL2-IGH - antiapoptotic, constitutive BCL2 expression
- Indolent, nodular/follicular pattern, centrocytes and centroblasts
- Grading: 1-2 (low grade, indolent), 3A (intermediate), 3B (treat as DLBCL)
- Transformation to DLBCL
- Marginal Zone Lymphoma
- CD19+, CD20+, CD5 negative, CD10 negative, CD23 negative
- Extranodal (MALT): stomach (H. pylori - may regress with antibiotics), lung, thyroid (Hashimoto’s), salivary (Sjogren’s)
- Nodal: generalized lymphadenopathy
- Splenic: splenomegaly, villous lymphocytes
- Lymphoplasmacytic Lymphoma / Waldenstrom Macroglobulinemia
- IgM monoclonal protein (paraprotein)
- MYD88 L265P mutation (>90%)
- Hyperviscosity syndrome, neuropathy, cryoglobulinemia, cold agglutinins
- Hairy Cell Leukemia
- CD19+, CD11c+, CD25+, CD103+, CD123+, TRAP (tartrate-resistant acid phosphatase)+
- BRAF V600E mutation (almost 100%)
- Pancytopenia, splenomegaly, “dry tap” on marrow aspirate (fibrosis)
- “Hairy” cytoplasmic projections, “fried egg” appearance in marrow
- Diffuse Large B-Cell Lymphoma (DLBCL)
- Most common NHL in adults
- CD19+, CD20+, variable CD10, BCL6, BCL2
- Aggressive but curable with R-CHOP
- Cell of origin: GCB (germinal center B-cell, better prognosis) vs ABC (activated B-cell, worse)
- MYC rearrangement + BCL2 or BCL6 = “double-hit” (very aggressive)
- Burkitt Lymphoma
- CD10+, CD19+, BCL6+, BCL2 negative, Ki-67 ~100%
- t(8;14) MYC-IGH (or variants t(2;8), t(8;22))
- “Starry sky” pattern (tingible body macrophages)
- Endemic (Africa, EBV+, jaw), Sporadic (abdomen, children), Immunodeficiency-associated (HIV)
- Highly aggressive but curable, tumor lysis syndrome risk
- Plasma Cell Neoplasms
- MGUS - <3g/dL M-protein, <10% plasma cells, no end-organ damage; 1%/year progression to myeloma
- Smoldering myeloma - higher M-protein/plasma cells but no symptoms
- Multiple myeloma - CRAB criteria (Calcium, Renal, Anemia, Bone lesions), CD138+, CD38+, often CD56+ (aberrant)
- Rouleaux formation, lytic bone lesions, serum/urine protein electrophoresis
- High-risk: t(4;14), t(14;16), del(17p), 1q gain
- Primary amyloidosis (AL) - light chain deposition, Congo red birefringence
- Waldenstrom - see lymphoplasmacytic lymphoma above (IgM)
C. MATURE T-CELL AND NK-CELL NEOPLASMS
- T-Cell Prolymphocytic Leukemia
- Aggressive, splenomegaly, skin involvement
- inv(14) or t(14;14) involving TCL1
- T-Cell Large Granular Lymphocytic Leukemia (T-LGL)
- CD3+, CD8+, CD57+
- Indolent, neutropenia, rheumatoid arthritis association, STAT3 mutations
- Large lymphocytes with azurophilic granules
- Adult T-Cell Leukemia/Lymphoma (ATLL)
- HTLV-1 associated, endemic in Japan, Caribbean
- “Flower cells” (multilobated nuclei)
- Hypercalcemia, lytic bone lesions, aggressive
- Mycosis Fungoides / Sezary Syndrome
- Cutaneous T-cell lymphoma
- CD4+ T-cells with cerebriform nuclei
- MF: patches → plaques → tumors, Pautrier microabscesses (epidermotropism)
- Sezary: erythroderma + circulating Sezary cells (leukemic phase)
- Peripheral T-Cell Lymphoma, NOS
- Heterogeneous group, aggressive, poor prognosis
- Angioimmunoblastic T-Cell Lymphoma (AITL)
- CD4+ T-follicular helper phenotype (PD-1+, CXCL13+, CD10+)
- Systemic symptoms, polyclonal hypergammaglobulinemia, EBV+ B-cells in background
- TET2, DNMT3A, RHOA mutations
- Anaplastic Large Cell Lymphoma (ALCL)
- CD30+ (hallmark), ALK+ or ALK-
- ALK+ (younger, better prognosis) - t(2;5) NPM1-ALK
- “Hallmark cells” with horseshoe/kidney-shaped nuclei
- Breast implant-associated ALCL - ALK negative, localized, good prognosis if capsulectomy
- Extranodal NK/T-Cell Lymphoma, Nasal Type
- EBV-associated, Asian/Central American populations
- Midline destructive lesions (nose, palate), angiocentric/angiodestructive
- CD56+, cytoplasmic CD3+, surface CD3 negative
- Hepatosplenic T-Cell Lymphoma
- Young males, immunosuppression (IBD on thiopurines + anti-TNF)
- Gamma-delta T-cell origin, sinusoidal infiltration
- Very aggressive
D. HODGKIN LYMPHOMA
- Classical Hodgkin Lymphoma (95%)
- Reed-Sternberg cells: CD30+, CD15+, PAX5 weak+, CD45 negative, CD20 usually negative
- “Owl eye” binucleated RS cells in inflammatory background
- Nodular sclerosis - most common, mediastinal mass, lacunar cells, young adults
- Mixed cellularity - EBV-associated, older/HIV patients
- Lymphocyte-rich - best prognosis
- Lymphocyte-depleted - worst prognosis, HIV-associated, older patients
- Nodular Lymphocyte-Predominant Hodgkin Lymphoma (5%)
- LP cells (“popcorn cells”): CD20+, CD45+, CD15 negative, CD30 negative
- Indolent, excellent prognosis
- Can transform to DLBCL
III. HEMOSTASIS AND COAGULATION DISORDERS
A. BLEEDING DISORDERS
- Platelet/Primary Hemostasis Disorders - mucocutaneous bleeding
- Quantitative: Thrombocytopenia (see above)
- Qualitative: von Willebrand disease, Glanzmann, Bernard-Soulier, acquired
- Coagulation Factor/Secondary Hemostasis Disorders - deep tissue bleeding, hemarthrosis
- Inherited
- Hemophilia A (Factor VIII) - X-linked, most common severe deficiency
- Hemophilia B (Factor IX) - X-linked, Christmas disease
- Hemophilia C (Factor XI) - autosomal, Ashkenazi Jewish
- von Willebrand Disease - most common inherited bleeding disorder; Type 1 (quantitative), Type 2 (qualitative), Type 3 (severe)
- Acquired
- Vitamin K deficiency - Factors II, VII, IX, X, Protein C, S
- Liver disease - decreased synthesis of all factors except VIII
- DIC - consumption of factors and platelets, microthrombi
- Acquired inhibitors - Factor VIII inhibitor (autoantibody)
- Inherited
B. THROMBOTIC DISORDERS (Thrombophilias)
- Inherited
- Factor V Leiden - most common; activated protein C resistance
- Prothrombin G20210A mutation - elevated prothrombin levels
- Antithrombin deficiency - heparin resistance
- Protein C deficiency - warfarin-induced skin necrosis
- Protein S deficiency
- Acquired
- Antiphospholipid syndrome - lupus anticoagulant, anticardiolipin, anti-beta2-glycoprotein I; arterial and venous thrombosis, pregnancy loss
- Malignancy (Trousseau syndrome)
- HIT - heparin-induced thrombocytopenia with thrombosis
- PNH - complement-mediated hemolysis and thrombosis
Key Classification Principles:
| Lineage | Key Markers | Disease Examples |
|---|---|---|
| Myeloid | CD13, CD33, CD117, MPO | AML, MDS, MPN, CML |
| B-lymphoid (precursor) | TdT+, CD19+, CD10+ | B-ALL |
| B-lymphoid (mature) | CD19, CD20, surface Ig, CD5 (some) | CLL, FL, DLBCL, MCL |
| T-lymphoid (precursor) | TdT+, cytoplasmic CD3, CD7 | T-ALL |
| T-lymphoid (mature) | Surface CD3, CD4 or CD8, CD7 | PTCL, ALCL, MF/SS |
| NK-cell | CD56+, surface CD3 negative | NK/T-cell lymphoma |
| Plasma cell | CD138+, CD38+, CD19 negative | Myeloma |
| Hodgkin RS cell | CD30+, CD15+, CD45 negative | Classical HL |
Quick Reference: Key Immunophenotypes in Hematologic Malignancies
| Disease | Key Markers |
|---|---|
| B-ALL | TdT+, CD19+, CD10+ (usually), surface Ig- |
| T-ALL | TdT+, CD3+ (cytoplasmic), CD7+, variable CD4/CD8 |
| CLL/SLL | CD5+, CD19+, CD23+, dim CD20, dim surface Ig, CD200+ |
| Mantle cell lymphoma | CD5+, CD19+, CD23-, Cyclin D1+, SOX11+ |
| Follicular lymphoma | CD10+, CD19+, CD5-, BCL2+, BCL6+ |
| Hairy cell leukemia | CD19+, CD11c+, CD25+, CD103+, TRAP+ |
| Marginal zone lymphoma | CD19+, CD20+, CD5-, CD10-, CD23- |
| Burkitt lymphoma | CD10+, CD19+, BCL6+, BCL2-, Ki-67 ~100% |
| AML | CD13+, CD33+, CD117+, MPO+ |
| APL | CD13+, CD33+, CD117+, HLA-DR- |
| Plasma cell myeloma | CD138+, CD38+, often CD56+ (aberrant), CD19-, CD20- |
| Hodgkin lymphoma (RS cells) | CD30+, CD15+, CD45-, PAX5 weak+, CD20- |
Practical use: When you see a lymphocyte malignancy with CD5+, the main differential is CLL vs. mantle cell. The distinguishing feature is CD23-positive in CLL, negative in mantle cell. Cyclin D1 confirms mantle cell.
Chapter 26: Normal Hematopoiesis and the Complete Blood Count
26.1 Hematopoiesis: The Production of Blood Cells
All blood cells derive from a common hematopoietic stem cell (HSC) in the bone marrow. This stem cell has two defining properties: 1. Self-renewal: Ability to replicate without differentiation 2. Multipotency: Ability to differentiate into all blood cell lineages
The Hematopoietic Hierarchy
The HSC differentiates through increasingly lineage-restricted progenitors:
Hematopoietic Stem Cell ↓ Multipotent Progenitor ↓ (splits into) Common Myeloid Progenitor → Common Lymphoid Progenitor
The Common Myeloid Progenitor gives rise to: - Megakaryocyte-Erythroid Progenitor → Megakaryocytes (platelets) and Erythrocytes - Granulocyte-Monocyte Progenitor → Neutrophils, Eosinophils, Basophils, and Monocytes
The Common Lymphoid Progenitor gives rise to: - B lymphocytes - T lymphocytes - NK cells
Sites of Hematopoiesis Through Life
- Yolk sac (weeks 3-8 gestation): Primitive hematopoiesis
- Liver and spleen (weeks 6-birth): Fetal hematopoiesis
- Bone marrow (week 20-throughout life): Definitive adult hematopoiesis
In adults, active hematopoiesis occurs primarily in the axial skeleton (vertebrae, sternum, ribs, pelvis) and proximal long bones.
Extramedullary hematopoiesis (EMH) occurs when bone marrow cannot meet demand or is replaced by disease. Common sites are liver and spleen, which retain embryonic hematopoietic capability.
Key Growth Factors
| Growth Factor | Primary Action |
|---|---|
| Erythropoietin (EPO) | RBC production (produced by kidney) |
| Thrombopoietin (TPO) | Platelet production (produced by liver) |
| G-CSF | Neutrophil production |
| GM-CSF | Granulocyte and monocyte production |
| IL-3 | Multi-lineage stimulation |
| IL-7 | Lymphocyte development |
| SCF (Stem Cell Factor) | HSC maintenance and early differentiation |
26.2 The Complete Blood Count (CBC)
The CBC is the most commonly ordered laboratory test. Understanding it requires knowing what each parameter measures and what affects it.
Red Blood Cell Parameters
RBC count: Number of red blood cells per unit volume (millions/μL)
Hemoglobin (Hgb): Concentration of hemoglobin (g/dL)-the oxygen-carrying protein
Hematocrit (Hct): Percentage of blood volume occupied by RBCs - Calculated on most analyzers as: RBC count × MCV - Direct measurement by centrifugation (microhematocrit) may differ due to trapped plasma
Red Cell Indices:
Mean Corpuscular Volume (MCV): Average RBC volume in femtoliters (fL) - Directly measured by impedance or light scatter - Classification: Microcytic (<80 fL), Normocytic (80-100 fL), Macrocytic (>100 fL)
Mean Corpuscular Hemoglobin (MCH): Average hemoglobin per RBC in picograms - Calculated: Hgb / RBC count - Parallels MCV (low in microcytic anemias, high in macrocytic)
Mean Corpuscular Hemoglobin Concentration (MCHC): Average hemoglobin concentration within RBCs (g/dL) - Calculated: Hgb / Hct - Represents hemoglobin density - Elevated (>36 g/dL): Spherocytosis (cells are smaller but packed with Hgb) - Decreased: Hypochromic anemias (iron deficiency)
Red Cell Distribution Width (RDW): Coefficient of variation of RBC volume-a measure of anisocytosis - Elevated RDW indicates variation in cell size - High RDW + microcytic anemia: Iron deficiency (mixed population) - Normal RDW + microcytic anemia: Thalassemia trait (uniform microcytosis)
Reticulocyte Count
Reticulocytes are immature RBCs that still contain ribosomal RNA (stained with methylene blue or detected by fluorescent dyes).
Normal: 0.5-2% (or 25,000-75,000/μL absolute)
Interpretation: - Elevated: Appropriate bone marrow response to anemia (hemolysis, blood loss, treatment response) - Low or normal in setting of anemia: Inadequate marrow response (marrow failure, nutritional deficiency, anemia of chronic disease)
Reticulocyte Production Index (RPI): Corrects for degree of anemia and early release of reticulocytes:
RPI = Reticulocyte % × (Patient Hct / Normal Hct) × (1 / Maturation factor)
- Maturation factor increases as anemia worsens (reticulocytes released earlier spend more time in circulation)
- RPI >2-3 suggests appropriate marrow response
- RPI <2 suggests inadequate response
White Blood Cell Parameters
WBC count: Total white blood cells per unit volume (thousands/μL)
Differential: Percentage or absolute count of each WBC type
| Cell Type | Normal % | Normal Absolute |
|---|---|---|
| Neutrophils | 40-70% | 1.8-7.7 × 10³/μL |
| Lymphocytes | 20-40% | 1.0-4.8 × 10³/μL |
| Monocytes | 2-8% | 0.1-0.8 × 10³/μL |
| Eosinophils | 1-4% | 0.0-0.4 × 10³/μL |
| Basophils | 0-1% | 0.0-0.1 × 10³/μL |
Absolute neutrophil count (ANC): WBC × (% neutrophils + % bands) - ANC <1500/μL: Neutropenia - ANC <500/μL: Severe neutropenia (high infection risk) - ANC <100/μL: Profound neutropenia
Platelet Parameters
Platelet count: Number of platelets per unit volume (thousands/μL) - Normal: 150-400 × 10³/μL - <150: Thrombocytopenia - <50: Increased bleeding risk with surgery - <10-20: Risk of spontaneous bleeding
Mean Platelet Volume (MPV): Average platelet volume - Increased: Young platelets (bone marrow compensating), ITP - Decreased: Marrow failure, Wiskott-Aldrich syndrome
26.3 Automated Hematology Analyzers
Modern analyzers use several technologies:
Electrical impedance (Coulter principle): Cells pass through a small aperture between electrodes. Each cell causes a momentary increase in electrical resistance proportional to cell volume. This measures cell counts and sizes.
Light scatter: Laser light is scattered by cells. Forward scatter correlates with size; side scatter correlates with internal complexity (granularity, nuclear lobulation).
Fluorescent staining: Nucleic acid dyes identify cell types (reticulocytes, nucleated RBCs, immature granulocytes).
Flags: Analyzers flag abnormalities requiring manual review: - Blasts - Atypical lymphocytes - Nucleated RBCs - Left shift - Cell clumps
Chapter 27: Red Blood Cell Disorders
Quick Reference: Anemia Classification by MCV
| MCV | Category | Common Causes |
|---|---|---|
| <80 fL | Microcytic | Iron deficiency, thalassemia, anemia of chronic disease (some), sideroblastic anemia, lead poisoning |
| 80-100 fL | Normocytic | Acute blood loss, anemia of chronic disease, renal disease, hemolysis (if not compensated), bone marrow failure, early iron or B12/folate deficiency |
| >100 fL | Macrocytic | B12/folate deficiency (megaloblastic), liver disease, hypothyroidism, myelodysplasia, reticulocytosis, drugs (methotrexate, hydroxyurea, AZT) |
Iron Studies Interpretation
| Condition | Serum Iron | TIBC | Ferritin | Transferrin Saturation |
|---|---|---|---|---|
| Iron deficiency | ↓ | ↑ | ↓ | ↓ (<15%) |
| Anemia of chronic disease | ↓ | ↓ or N | ↑ or N | ↓ or N |
| Thalassemia trait | N | N | N | N |
| Sideroblastic anemia | ↑ | N or ↓ | ↑ | ↑ |
| Hemochromatosis | ↑ | ↓ | ↑↑ | ↑↑ (>45%) |
Key distinction: In iron deficiency, the body is hungry for iron (high TIBC = more transferrin being made to carry iron). In anemia of chronic disease, the body is sequestering iron (normal or low TIBC = body isn’t making more transferrin because the problem isn’t iron supply, it’s iron release from macrophages). Ferritin is the best single test to distinguish them-it’s truly low only in iron deficiency.
27.1 Approach to Anemia
Anemia is defined as decreased hemoglobin/hematocrit below normal for age and sex. The approach begins with classifying by RBC size (MCV).
Microcytic Anemia (MCV <80 fL)
The differential for microcytic anemia can be remembered by the mnemonic TAILS: - Thalassemia - Anemia of chronic disease (sometimes microcytic) - Iron deficiency - Lead poisoning - Sideroblastic anemia
Iron Deficiency Anemia - The most common cause of anemia worldwide
Pathophysiology: Iron is essential for heme synthesis. Deficiency leads to impaired hemoglobin production, causing small (microcytic), pale (hypochromic) red cells.
Causes: - Blood loss (GI bleeding, menstruation)-most common in adults - Inadequate intake (infants, restricted diets) - Malabsorption (celiac disease, gastrectomy) - Increased demand (pregnancy, growth)
Laboratory findings:
| Test | Finding |
|---|---|
| Serum iron | ↓ |
| TIBC (transferrin) | ↑ (liver makes more transferrin) |
| Transferrin saturation | ↓↓ (<15%) |
| Ferritin | ↓ (<12 ng/mL highly specific) |
| Reticulocytes | ↓ or normal |
Peripheral smear: Hypochromic, microcytic cells; target cells; elliptocytes (pencil cells); high RDW (variation in cell size)

Progression: Iron stores (ferritin) deplete first → serum iron falls → microcytosis develops → anemia develops
Important caveat: Ferritin is an acute phase reactant-it may be normal or elevated in iron deficiency with concurrent inflammation. In this setting, check: - Soluble transferrin receptor (elevated in iron deficiency, not affected by inflammation) - Ferritin index: sTfR/log ferritin
Thalassemia - Decreased globin chain synthesis
Pathophysiology: Hemoglobin consists of 4 globin chains-2 alpha (α) and 2 non-alpha. In adults, HbA (α2β2) predominates. Thalassemias result from decreased production of one globin chain type, leading to: 1. Decreased hemoglobin synthesis (microcytosis) 2. Imbalanced chains forming inclusions (hemolysis)

Alpha Thalassemia: Decreased α-chain production (genes on chromosome 16)
Normal individuals have 4 α-globin genes (2 on each chromosome 16). Severity depends on how many are deleted/mutated:
| # Genes Affected | Syndrome | Clinical Features |
|---|---|---|
| 1 (-α/αα) | Silent carrier | Normal; slight microcytosis |
| 2 (–/αα or -α/-α) | α-thal trait | Mild microcytic anemia |
| 3 (–/-α) | HbH disease | Moderate hemolytic anemia; HbH (β4) inclusions |
| 4 (–/–) | Hb Bart’s hydrops fetalis | Incompatible with life; Hb Bart’s (γ4) |
Note: The genotype (–/αα) is called cis deletion (both deletions on same chromosome, common in Asians) and is more likely to produce severely affected offspring than (-α/-α) trans deletion (one deletion per chromosome, common in Africans).
Beta Thalassemia: Decreased β-chain production (genes on chromosome 11)
There are 2 β-globin genes (one on each chromosome 11). Mutations are usually point mutations (not deletions).
| Genotype | Syndrome | Clinical Features |
|---|---|---|
| β/β+ or β/β0 | β-thal minor (trait) | Mild microcytic anemia; elevated HbA2 (>3.5%) |
| β+/β+ or β0/β+ | β-thal intermedia | Moderate anemia; may need transfusions |
| β0/β0 | β-thal major (Cooley’s) | Severe transfusion-dependent anemia; hepatosplenomegaly |
Why is HbA2 elevated in β-thal trait? With less β-chain available, more α-chains bind to δ-chains (forming HbA2 = α2δ2). This is the key diagnostic finding-elevated HbA2 (>3.5%) confirms β-thal trait.
Laboratory comparison:
| Finding | Iron Deficiency | β-Thal Trait |
|---|---|---|
| MCV | ↓ | ↓↓ (often very low for degree of anemia) |
| RDW | ↑ | Normal |
| RBC count | ↓ | Normal or ↑ |
| Ferritin | ↓ | Normal |
| HbA2 | Normal | ↑ (>3.5%) |
The Mentzer index (MCV/RBC) can help: <13 suggests thalassemia; >13 suggests iron deficiency.
Sideroblastic Anemia - Defective heme synthesis with iron accumulation
Pathophysiology: Defective protoporphyrin synthesis in mitochondria leads to iron accumulation in mitochondria, visible as ring sideroblasts (erythroblasts with iron-laden mitochondria forming a ring around the nucleus).
Causes: - Hereditary: X-linked (ALAS2 mutation)-responds to pyridoxine (vitamin B6) - Acquired: - Myelodysplastic syndrome (most common; especially MDS with ring sideroblasts, often SF3B1 mutation) - Drugs/toxins: Alcohol, lead, isoniazid, chloramphenicol - Copper deficiency
Laboratory findings: - Microcytic anemia (or dimorphic with normal + microcytic cells) - Elevated serum iron, ferritin, transferrin saturation (iron overload pattern) - Ring sideroblasts on Prussian blue stain of marrow (≥15% defines the category)
Lead Poisoning
Pathophysiology: Lead inhibits several enzymes in heme synthesis: - δ-aminolevulinic acid dehydratase (accumulation of δ-ALA) - Ferrochelatase (decreased iron incorporation)
Laboratory findings: - Microcytic anemia - Basophilic stippling (ribosomal aggregates due to inhibited pyrimidine 5’-nucleotidase) - Elevated blood lead level - Elevated free erythrocyte protoporphyrin (FEP) or zinc protoporphyrin (ZPP)
Clinical features: Abdominal pain, constipation, neurological symptoms (encephalopathy in severe cases), “lead lines” on gingiva and long bone metaphyses
Normocytic Anemia (MCV 80-100 fL)
Anemia of Chronic Disease (ACD)
Also called “anemia of inflammation”-the second most common cause of anemia.
Pathophysiology: The key player is hepcidin, a liver-produced hormone that regulates iron metabolism: - Inflammation (via IL-6) → Increased hepcidin - Hepcidin binds and degrades ferroportin (iron exporter on macrophages and enterocytes) - Iron is trapped in macrophages and cannot be absorbed from gut - Result: Low serum iron despite adequate iron stores
This is a protective response-sequestering iron limits its availability to pathogens.
Laboratory findings:
| Test | Finding |
|---|---|
| Serum iron | ↓ |
| TIBC | ↓ or normal (unlike iron deficiency) |
| Transferrin saturation | ↓ or normal |
| Ferritin | ↑ or normal (acute phase reactant) |
MCV: Usually normocytic, may be mildly microcytic
Distinguishing from iron deficiency: Ferritin is the key-elevated in ACD, low in iron deficiency. If both coexist, soluble transferrin receptor (sTfR) or sTfR/log ferritin index helps.
Anemia of Chronic Kidney Disease
Pathophysiology: The kidneys produce erythropoietin (EPO). In CKD, EPO production decreases, leading to inadequate stimulation of erythropoiesis.
Additional factors: - Uremic toxins suppress marrow - Shortened RBC survival - Blood loss from dialysis - Functional iron deficiency
Treatment: EPO-stimulating agents (ESAs) with adequate iron supplementation
Hemolytic Anemia (covered in detail in next section)
Hemolysis can be normocytic (if compensated) or macrocytic (reticulocytosis-reticulocytes are larger).
Acute Blood Loss
Immediately after acute hemorrhage, hemoglobin and hematocrit are normal because whole blood is lost. As the body compensates with fluid shifts and IV fluids, anemia becomes apparent. Reticulocytosis takes 3-5 days to appear.
Macrocytic Anemia (MCV >100 fL)
Megaloblastic vs. Non-megaloblastic: Critical distinction
Megaloblastic anemia results from impaired DNA synthesis (while RNA and protein synthesis continue normally). This causes nuclear-cytoplasmic asynchrony-cells grow large but nuclei remain immature.
Hallmark finding: Hypersegmented neutrophils (≥5% with 5 lobes, or any with 6+ lobes)
Causes: Vitamin B12 (cobalamin) or folate deficiency
Vitamin B12 (Cobalamin) Deficiency
Biochemistry: B12 is a cofactor for two enzymes: 1. Methionine synthase: Converts homocysteine → methionine (requires B12 and folate) 2. Methylmalonyl-CoA mutase: Converts methylmalonyl-CoA → succinyl-CoA (requires B12 only)
Deficiency causes: - Elevated homocysteine (shared with folate deficiency) - Elevated methylmalonic acid (MMA) (specific to B12 deficiency)
Causes of B12 deficiency: - Pernicious anemia: Autoimmune destruction of gastric parietal cells (anti-intrinsic factor, anti-parietal cell antibodies) → loss of intrinsic factor → impaired B12 absorption in terminal ileum - Gastrectomy, gastric bypass - Terminal ileum disease (Crohn’s, resection) - Strict vegan diet (takes years to deplete stores) - Metformin (impairs absorption)
Clinical features: - Anemia symptoms - Neurological symptoms: Subacute combined degeneration (posterior columns + lateral corticospinal tracts), peripheral neuropathy, dementia, mood changes - Glossitis, angular cheilitis
Important: Neurological symptoms can occur without anemia and may be irreversible if not treated promptly.
Laboratory findings: - Macrocytic anemia (MCV often >110 fL) - Low reticulocyte count - Hypersegmented neutrophils - Low serum B12 (<200 pg/mL) - Elevated MMA (>0.4 μmol/L) - Elevated homocysteine - Elevated LDH (ineffective erythropoiesis) - Elevated indirect bilirubin (same reason)
Folate Deficiency
Biochemistry: Folate is essential for DNA synthesis-specifically, for thymidylate synthesis (dTMP).
Causes: - Inadequate intake (alcoholism, poor diet) - Increased demand (pregnancy, hemolysis, malignancy) - Malabsorption (celiac disease, tropical sprue) - Drugs: Methotrexate (DHF reductase inhibitor), phenytoin, trimethoprim
Laboratory findings: - Macrocytic anemia, hypersegmented neutrophils (same as B12) - Low serum or RBC folate - Elevated homocysteine - Normal MMA (this distinguishes from B12 deficiency)
Non-megaloblastic Macrocytosis
Many conditions cause macrocytosis without the nuclear-cytoplasmic asynchrony:
- Alcoholism: Direct toxic effect on marrow; also often have folate deficiency
- Liver disease: Altered lipid metabolism affects RBC membrane
- Hypothyroidism: Mechanism unclear
- Myelodysplastic syndrome: Clonal marrow disorder
- Reticulocytosis: Reticulocytes are larger; high reticulocyte count raises MCV
- Drugs: Hydroxyurea, azathioprine, zidovudine (interfere with DNA synthesis)
Key clue: Absence of hypersegmented neutrophils helps distinguish non-megaloblastic from megaloblastic causes.
27.2 Hemolytic Anemias
Hemolytic anemia results from increased RBC destruction. The bone marrow compensates by increasing production (reticulocytosis).
Laboratory Evidence of Hemolysis
| Finding | Mechanism |
|---|---|
| ↑ Reticulocyte count | Compensatory marrow response |
| ↑ Indirect bilirubin | Heme catabolism |
| ↑ LDH | Released from RBCs |
| ↓ Haptoglobin | Binds free hemoglobin; complex cleared by liver |
| ↑ Urobilinogen in urine | Increased bilirubin metabolism |
Intravascular hemolysis (hemolysis in the bloodstream) additionally shows: - Hemoglobinemia (pink plasma) - Hemoglobinuria (pink/red urine positive for blood but no RBCs) - Hemosiderinuria (hemosiderin in urine sediment-late finding) - Very low/undetectable haptoglobin
Extravascular hemolysis (hemolysis in spleen/liver by macrophages): - Haptoglobin moderately decreased - No hemoglobinemia/hemoglobinuria - Splenomegaly often present
Classification
Hemolytic anemias are classified as: 1. Intrinsic (defect within the RBC): Membrane, enzyme, or hemoglobin disorders 2. Extrinsic (external cause): Immune, mechanical, infectious, toxins
Membrane Disorders
Hereditary Spherocytosis (HS)
Pathophysiology: Defects in proteins linking the RBC cytoskeleton to the lipid bilayer (most commonly spectrin, ankyrin, band 3, or protein 4.2). The membrane becomes unstable, and bits are lost as the cell passes through the spleen. The cell becomes progressively smaller and spherical.
Inheritance: Usually autosomal dominant (75%)
Clinical features: - Variable severity (mild to severe) - Jaundice, splenomegaly - Pigment gallstones (from chronic hemolysis) - Aplastic crisis (parvovirus B19 infection)
Laboratory findings: - Spherocytes on peripheral smear - Elevated MCHC (>36 g/dL)-concentrated hemoglobin in small cells - Elevated RDW - Increased osmotic fragility (spherocytes lyse at higher osmolarity) - Decreased eosin-5-maleimide (EMA) binding on flow cytometry-modern diagnostic test
Treatment: Splenectomy (removes site of destruction); vaccinate for encapsulated organisms first
Hereditary Elliptocytosis
Pathophysiology: Defects in horizontal (lateral) interactions of cytoskeleton proteins (spectrin self-association, protein 4.1). RBCs become elongated/elliptical.
Clinical features: Usually mild hemolysis; may be asymptomatic
Smear: >25% elliptocytes (normally <15%)
Paroxysmal Nocturnal Hemoglobinuria (PNH)
Pathophysiology: Acquired mutation in the PIGA gene in a hematopoietic stem cell. PIGA is required to synthesize the GPI anchor, which attaches many proteins to the cell surface, including: - CD55 (DAF) and CD59 (MIRL): Complement regulatory proteins
Without these regulators, RBCs are susceptible to complement-mediated lysis.
Clinical features: - Intravascular hemolysis (episodic or chronic) - Classic morning hemoglobinuria (nocturnal acidosis activates complement)-but most patients don’t have this classic presentation - Thrombosis (leading cause of death): Unusual sites-hepatic vein (Budd-Chiari), cerebral, mesenteric - Bone marrow failure (PNH often arises from/coexists with aplastic anemia) - Risk of AML/MDS
Laboratory findings: - Hemolysis labs (↑ LDH, ↓ haptoglobin, ↑ reticulocytes) - Flow cytometry: Decreased/absent CD55 and CD59 on RBCs and WBCs - FLAER (fluorescent aerolysin): Binds GPI anchors; decreased binding on WBCs is most sensitive test - Often have concurrent cytopenias
Treatment: - Eculizumab (monoclonal antibody against C5, blocks terminal complement) - Bone marrow transplant (only cure)
Enzyme Deficiencies
Glucose-6-Phosphate Dehydrogenase (G6PD) Deficiency
Biochemistry: G6PD is the rate-limiting enzyme of the pentose phosphate pathway, which generates NADPH. NADPH maintains glutathione in its reduced form, which protects against oxidative damage.
Without G6PD, RBCs are vulnerable to oxidative stress.
Genetics: X-linked recessive (males affected; heterozygous females are carriers)
Variants: - G6PD B: Normal (most common) - G6PD A-: 10-15% of African Americans; moderate deficiency - G6PD Mediterranean: Severe deficiency; more severe hemolysis
Triggers of hemolysis: - Infections (most common trigger) - Drugs: Primaquine, dapsone, sulfonamides, nitrofurantoin - Fava beans (favism)-mainly Mediterranean variant - Metabolic acidosis (DKA)
Pathophysiology of hemolysis: Oxidative stress → Hemoglobin denatures → Forms Heinz bodies (precipitated hemoglobin) → Splenic macrophages remove Heinz bodies (creating “bite cells”) → Eventually removes whole cell
Laboratory findings during episode: - Acute intravascular hemolysis - Bite cells (cells with “bites” taken out) and blister cells - Heinz bodies (visible with supravital stain like crystal violet, not Wright stain) - Elevated reticulocytes (after few days)
G6PD assay: May be falsely normal during acute hemolysis (reticulocytes and young cells have higher G6PD levels). Test 2-3 months after episode or test during episode with caveat.
Pyruvate Kinase (PK) Deficiency
Biochemistry: PK is the final step of glycolysis, generating ATP. Without adequate ATP, the Na-K-ATPase fails, and RBCs become rigid and are removed by the spleen.
Genetics: Autosomal recessive
Clinical features: Chronic hemolytic anemia (extravascular), splenomegaly, jaundice
Laboratory: - Elevated 2,3-DPG (increased substrate proximal to block) - Echinocytes on smear - Decreased PK activity assay
Hemoglobinopathies
Sickle Cell Disease (HbSS)
Genetics: Autosomal recessive; point mutation in β-globin gene (glutamic acid → valine at position 6)
Pathophysiology: Deoxygenated HbS polymerizes, distorting RBCs into sickle shapes. Sickled cells are rigid and sticky, causing: 1. Vaso-occlusion: Sickled cells obstruct small vessels → ischemia → pain crises 2. Hemolysis: Sickled cells have shortened lifespan (~17 days vs. 120 days)
Clinical features: - Painful vaso-occlusive crises (bones, chest, abdomen) - Acute chest syndrome: Vaso-occlusion in pulmonary vasculature; fever, chest pain, infiltrate, hypoxia-leading cause of death - Stroke: Especially in children - Splenic sequestration: Massive pooling in spleen → acute anemia, shock - Autosplenectomy: Repeated infarction → fibrosis → functional asplenia by adulthood - Aplastic crisis: Parvovirus B19 infection (infects erythroid precursors) - Chronic complications: Renal disease, retinopathy, avascular necrosis, priapism, leg ulcers
Laboratory findings: - Chronic hemolytic anemia (Hgb 6-9 g/dL) - Sickle cells on peripheral smear - Target cells (reduced surface-to-volume ratio after membrane loss) - Howell-Jolly bodies (nuclear remnants-indicates splenic dysfunction) - Elevated reticulocytes - Hemoglobin electrophoresis: HbS predominant (80-90%), HbF variable, HbA absent (no normal β chains)
Sickle Solubility Test: HbS polymerizes in reducing agent (sodium dithionite), causing turbidity. Positive in HbS trait and disease. Does not distinguish amount of HbS-use electrophoresis for diagnosis.
Sickle Cell Trait (HbAS)
Carriers of one HbS allele (heterozygotes).
Hemoglobin electrophoresis: HbA ~60%, HbS ~40%
Clinical significance: Generally asymptomatic. May have: - Hematuria (renal papillary necrosis from medullary sickling) - Inability to concentrate urine (same reason) - Rare splenic infarction at high altitude
Hemoglobin C Disease (HbCC)
Genetics: Glutamic acid → lysine at position 6 of β-globin
Clinical features: Mild hemolytic anemia, splenomegaly
Smear: Target cells, HbC crystals (rectangular intracellular crystals)
Hemoglobin SC Disease
Compound heterozygote for HbS and HbC.
Clinical features: Intermediate severity between HbSS and HbCC; notable for proliferative retinopathy and avascular necrosis
Immune Hemolytic Anemias
(Covered extensively in Blood Banking section)
Key points for Hematopathology: - Warm AIHA: IgG autoantibodies; spherocytes on smear; DAT positive for IgG - Cold agglutinin disease: IgM autoantibodies; RBC agglutination on smear; DAT positive for C3 only - Drug-induced: Various mechanisms; DAT may show IgG, C3, or both
Microangiopathic Hemolytic Anemia (MAHA)
Pathophysiology: Mechanical shearing of RBCs as they pass through abnormal microvasculature (fibrin strands, platelet aggregates, or damaged endothelium).
Hallmark finding: Schistocytes (helmet cells, fragmented RBCs) on peripheral smear
Causes: - TTP: ADAMTS13 deficiency → large vWF multimers → platelet microthrombi - HUS: Typical (STEC: Shiga toxin-producing E. coli O157:H7); Atypical (complement dysregulation) - DIC: Widespread coagulation activation - HELLP syndrome: Hemolysis, Elevated Liver enzymes, Low Platelets in pregnancy - Malignant hypertension - Prosthetic heart valves
Laboratory findings: - Schistocytes (>1% suggests MAHA) - Thrombocytopenia (platelets consumed in microthrombi) - Elevated LDH, indirect bilirubin - Decreased haptoglobin - Negative DAT (not immune-mediated) - Coag studies: Normal in TTP/HUS; abnormal in DIC
27.3 Aplastic Anemia and Bone Marrow Failure
Aplastic Anemia: Pancytopenia with hypocellular bone marrow (fat replacing hematopoietic tissue)
Causes: - Idiopathic (most common)-likely immune-mediated - Drugs: Chloramphenicol, NSAIDs, carbamazepine, benzene - Infections: Parvovirus B19 (if underlying hemolytic anemia), hepatitis (seronegative hepatitis) - Inherited: Fanconi anemia (DNA repair defect, congenital anomalies, cancer predisposition)
Diagnosis: - Pancytopenia - Reticulocytopenia (marrow not responding) - Bone marrow biopsy: <25-30% cellularity with fat spaces
Treatment: - Immunosuppression (ATG + cyclosporine) for older or no matched donor - Bone marrow transplant (curative, best for young patients with matched donor)
Chapter 28: White Blood Cell Disorders
28.1 Neutrophil Disorders
Neutropenia
Definition: ANC <1500/μL
Causes: - Drugs (most common): Chemotherapy, clozapine, carbamazepine, methimazole - Infections: Viral (HIV, EBV), bacterial (typhoid, TB) - Autoimmune: Lupus, Felty syndrome (RA + splenomegaly + neutropenia) - Nutritional: B12, folate, copper deficiency - Primary marrow disorders: MDS, leukemia, aplastic anemia - Cyclic neutropenia: Regular 21-day cycles of neutropenia - Severe congenital neutropenia (Kostmann syndrome)
Risk of infection: Increases as ANC falls below 500/μL
Neutrophilia
Definition: ANC >7700/μL
Causes: - Infection: Bacterial most common cause - Inflammation: Rheumatic diseases, IBD, vasculitis - Stress/steroids: Demargination of neutrophils - Drugs: G-CSF, lithium - Neoplastic: CML, other myeloproliferative neoplasms
Left shift: Increased band forms (>10%) and/or immature forms (metamyelocytes, myelocytes) indicating accelerated release from marrow
Leukemoid reaction: WBC >50,000/μL with reactive cause (infection, severe hemolysis, marrow recovery). Distinguished from CML by: - High LAP score (leukocyte alkaline phosphatase)-elevated in reactive conditions, low in CML - Absence of BCR-ABL1 fusion - Toxic granulation, Döhle bodies in reactive conditions
Inherited Neutrophil Disorders
Chronic Granulomatous Disease (CGD)
Pathophysiology: Defective NADPH oxidase cannot generate superoxide for respiratory burst. Neutrophils cannot kill catalase-positive organisms (which destroy their own H2O2).
Genetics: X-linked (most common) or autosomal recessive
Infections: Recurrent severe infections with catalase-positive organisms: - Staphylococcus aureus - Aspergillus (most common cause of death) - Serratia, Nocardia, Burkholderia cepacia
Diagnosis: - Dihydrorhodamine (DHR) flow cytometry: Most sensitive. DHR is oxidized to fluorescent rhodamine by reactive oxygen species. In CGD, no fluorescence. - Nitroblue tetrazolium (NBT) test: Historical; NBT turns blue when reduced by respiratory burst. No color change in CGD.
Leukocyte Adhesion Deficiency (LAD)
Pathophysiology: Deficiency of CD18 (β2 integrin), which is essential for neutrophil adhesion and emigration from blood to tissues.
Clinical features: - Delayed umbilical cord separation (>30 days) - Recurrent bacterial infections without pus (neutrophils can’t get to tissue) - Very high WBC count (neutrophils trapped in circulation) - Poor wound healing
Diagnosis: Flow cytometry shows absent CD18
Chédiak-Higashi Syndrome
Pathophysiology: Defective lysosomal trafficking protein (LYST mutation)
Findings: - Giant granules in WBCs and other cells - Partial oculocutaneous albinism - Recurrent pyogenic infections - Peripheral neuropathy - May develop accelerated phase (lymphohistiocytic infiltration)
28.2 Morphologic Abnormalities
| Abnormality | Appearance | Associations |
|---|---|---|
| Toxic granulation | Dark azurophilic granules | Infection, inflammation |
| Döhle bodies | Blue cytoplasmic inclusions (rough ER) | Infection, inflammation |
| Hypersegmented neutrophils | ≥5 lobes | Megaloblastic anemia |
| Pelger-Huët anomaly | Bilobed nuclei (pince-nez) | Benign inherited or pseudo-PH in MDS |
| Auer rods | Pink rod-shaped inclusions | AML (especially APL) |
Key RBC Morphology Images:

28.3 Eosinophilia
Definition: Absolute eosinophil count >500/μL
Causes (mnemonic NAACP): - Neoplastic: Hodgkin lymphoma, T-cell lymphomas, mastocytosis - Allergic: Asthma, hay fever, drug reactions - Addison disease (adrenal insufficiency) - Collagen vascular disease (rare) - Parasites: Tissue-invasive helminths (not protozoa)
Hypereosinophilic Syndrome (HES): - Eosinophils >1500/μL for >6 months - Organ damage (endomyocardial fibrosis, neuropathy) - Exclude secondary causes - Some cases have FIP1L1-PDGFRA fusion (respond to imatinib)
28.4 Basophilia
Definition: Absolute basophil count >200/μL (rare)
Causes: - CML: Basophilia is characteristic - Allergic reactions - Myeloproliferative neoplasms - Ulcerative colitis, hypothyroidism
28.5 Monocytosis
Definition: Absolute monocyte count >800/μL
Causes: - Chronic infections (TB, endocarditis) - Autoimmune/inflammatory diseases - Recovery from neutropenia - CMML (Chronic Myelomonocytic Leukemia)
28.6 Lymphocytosis
Definition: Absolute lymphocyte count >4000/μL in adults
Reactive lymphocytosis: - Viral infections (EBV, CMV, HIV, hepatitis) - Pertussis (Bordetella pertussis promotes lymphocyte trafficking) - Toxoplasmosis
Reactive (atypical) lymphocytes: Large lymphocytes with abundant blue cytoplasm, often indented by surrounding RBCs. Classic in infectious mononucleosis (EBV).
Clonal lymphocytosis: - CLL/SLL - Other lymphoproliferative disorders
Chapter 29: Platelet and Coagulation Disorders
29.1 Thrombocytopenia
Definition: Platelet count <150,000/μL
Causes by Mechanism
Decreased Production: - Bone marrow failure (aplastic anemia, MDS, leukemia) - Marrow infiltration (metastatic cancer, fibrosis) - Nutritional deficiency (B12, folate) - Drugs (chemotherapy, alcohol) - Viral infections (HIV, hepatitis C)
Increased Destruction:
Immune: - Immune Thrombocytopenic Purpura (ITP): Autoantibodies to platelet glycoproteins (usually GPIIb/IIIa or GPIb/IX). Isolated thrombocytopenia; diagnosis of exclusion. - Drug-induced: Heparin (HIT), quinine, sulfonamides, vancomycin - Post-transfusion purpura: Anti-HPA antibodies
Non-immune: - TTP, HUS (microangiopathic consumption) - DIC (widespread coagulation consuming platelets) - Sepsis
Sequestration: - Splenomegaly (hypersplenism): Spleen pools up to 90% of platelets (normal 30%)
Dilutional: - Massive transfusion
Heparin-Induced Thrombocytopenia (HIT)
Two types: - Type I: Non-immune, mild decrease in platelets (100,000-150,000), occurs within first 2 days, clinically insignificant - Type II: Immune-mediated, serious, what we mean by “HIT”
Pathophysiology of Type II HIT: 1. Heparin binds to platelet factor 4 (PF4) 2. Conformational change exposes neoepitope 3. IgG antibodies form against heparin-PF4 complex 4. Antibody-coated complexes bind platelet Fc receptors 5. Platelet activation → thrombosis + platelet consumption
The paradox: Despite thrombocytopenia, HIT is a hypercoagulable state with high risk of thrombosis (not bleeding).
Timing: Typically days 5-10 after heparin exposure (or sooner if prior exposure)
Clinical features: - Platelet drop >50% from baseline (may still be >150,000) - Thrombosis (DVT, PE, arterial thrombosis, skin necrosis) - At heparin injection sites: Necrosis
Diagnosis: - 4T Score: Thrombocytopenia, Timing, Thrombosis, oTher causes excluded - PF4/heparin ELISA: Sensitive but not specific; many false positives - Serotonin Release Assay (SRA): Gold standard, highly specific; tests ability of patient antibodies to activate donor platelets
Management: 1. Stop ALL heparin (including flushes, heparin-coated catheters) 2. Start alternative anticoagulation immediately (argatroban, fondaparinux, direct oral anticoagulants) 3. Do NOT give warfarin until platelets recover (risk of warfarin-induced skin necrosis) 4. Do NOT transfuse platelets (fuels thrombosis)
Thrombotic Thrombocytopenic Purpura (TTP)
TTP is a medical emergency with >90% mortality if untreated, reduced to <10-20% with prompt plasma exchange. Understanding the molecular pathophysiology explains why treatment works.
Pathophysiology-The ADAMTS13 Story:
ADAMTS13 (a disintegrin and metalloprotease with thrombospondin type 1 motif, member 13) is a plasma enzyme that cleaves von Willebrand factor (vWF) at a specific site within the A2 domain.
Why this matters: 1. Both platelets and endothelial cells produce ultra-large vWF (ULvWF) multimers-these are much larger and more adhesive than the vWF that normally circulates 2. ULvWF multimers are anchored to endothelial cells and extend into flowing blood like streamers 3. Under shear stress (in arterioles and capillaries), these multimers bind platelets via GPIb, causing spontaneous platelet adhesion and aggregation 4. Normally, ADAMTS13 rapidly cleaves these ULvWF multimers, releasing them from endothelium and reducing them to smaller, less adhesive forms 5. When ADAMTS13 is absent or inhibited, ULvWF accumulates, causing widespread platelet microthrombi in small vessels 6. These microthrombi shear red blood cells mechanically, producing schistocytes 7. End-organ ischemia (brain, kidney, heart, GI tract) results from microvascular occlusion
Causes of ADAMTS13 Deficiency: - Acquired (most common, ~95%): IgG autoantibodies against ADAMTS13 (autoimmune TTP). May be idiopathic or associated with autoimmune diseases, HIV, pregnancy - Congenital (Upshaw-Schulman syndrome): Mutations in the ADAMTS13 gene. Presents in childhood, often triggered by infections. Chronic relapsing course
The Classic Pentad (present in <10% of patients at diagnosis-don’t wait for all five!): 1. Microangiopathic hemolytic anemia (MAHA): Schistocytes, elevated LDH, low haptoglobin, elevated indirect bilirubin, negative DAT 2. Thrombocytopenia: Often severe (<20,000/μL), median ~15,000 at presentation 3. Neurologic abnormalities: Fluctuating and varied-headache, confusion, visual disturbances, transient focal deficits, seizures, stroke. Key feature is the fluctuating nature 4. Renal dysfunction: Usually mild (creatinine ~1.5-2.0); severe renal failure suggests HUS instead 5. Fever: Low-grade; high fever suggests sepsis
Clinical Clue: The combination of MAHA + thrombocytopenia + normal PT/aPTT should immediately suggest TTP (or other thrombotic microangiopathy).
Laboratory Findings: - Peripheral smear: Schistocytes (fragmented RBCs)-essential finding - Platelet count: Severely decreased - LDH: Markedly elevated (from hemolysis AND tissue ischemia) - Haptoglobin: Low or absent - PT/aPTT: Normal (distinguishes from DIC, where both are prolonged) - ADAMTS13 activity <10% with inhibitor detected-diagnostic for acquired TTP - Note: ADAMTS13 testing takes time; don’t wait for results to initiate treatment
Differential Diagnosis of Thrombotic Microangiopathies:
| Feature | TTP | HUS | DIC | HELLP |
|---|---|---|---|---|
| ADAMTS13 | <10% | Normal | Normal | Normal |
| Renal failure | Mild | Severe | Variable | Moderate |
| Diarrhea prodrome | No | Yes (typical HUS) | No | No |
| PT/aPTT | Normal | Normal | Prolonged | Normal |
| Pregnancy | Sometimes | Rare | Variable | Yes |
Treatment-Why Plasma Exchange Works: 1. Removes: Autoantibodies against ADAMTS13 and accumulated ULvWF multimers 2. Provides: Functional ADAMTS13 in replacement plasma
Treatment Protocol: - Plasma exchange (TPE): Begin immediately when TTP is suspected-don’t wait for ADAMTS13 results. Exchange 1-1.5 plasma volumes daily using FFP or cryopoor plasma (cryopoor lacks large vWF multimers). Continue until platelet count normalizes and LDH decreases. - Corticosteroids: Prednisone 1 mg/kg/day or methylprednisolone-helps suppress autoantibody production - Rituximab: Anti-CD20 monoclonal antibody; used for refractory cases or to prevent relapse - Caplacizumab: Anti-vWF nanobody that blocks platelet-vWF interaction; accelerates response - Do NOT transfuse platelets unless life-threatening bleeding (may fuel microthrombi)
Monitoring Response: Platelet count and LDH are followed daily. Platelet recovery indicates response; LDH normalization follows. ADAMTS13 activity should recover with successful treatment.
29.2 Thrombocytosis
Definition: Platelet count >450,000/μL
Reactive (secondary) thrombocytosis: - Infection, inflammation - Iron deficiency - Post-splenectomy - Malignancy
Reactive thrombocytosis rarely causes thrombosis.
Clonal (primary) thrombocytosis: - Essential thrombocythemia (ET) - Other myeloproliferative neoplasms (PV, PMF, CML)
Clonal thrombocytosis carries risk of both thrombosis and bleeding (acquired von Willebrand syndrome at very high counts).
29.3 Coagulation Disorders
Understanding coagulation requires grasping both the cascade itself and what the laboratory tests actually measure. The cascade may seem complex, but the logic becomes clear once you understand what each pathway does and why the tests work as they do.
The Coagulation Cascade: A Logical Framework

The traditional model divides coagulation into three pathways, and while the in vivo process is more integrated, this framework remains essential for interpreting coagulation tests.
The Extrinsic Pathway-Initiation (measured by PT): Coagulation begins when tissue factor (TF) is exposed by vascular injury. TF binds Factor VII (which circulates in small amounts in its active form), and this TF-VIIa complex activates Factor X. This pathway is called “extrinsic” because tissue factor comes from outside the blood.
The prothrombin time (PT) measures this pathway. The laboratory adds tissue factor (thromboplastin) to patient plasma and measures time to clot. Because Factor VII has the shortest half-life of any clotting factor (about 6 hours), the PT is the first test to become abnormal in vitamin K deficiency or warfarin therapy.
The Intrinsic Pathway-Amplification (measured by aPTT): This pathway begins with contact activation-Factor XII activates when blood contacts negatively charged surfaces (like glass or kaolin in the lab). The cascade then proceeds: XII→XIIa→XI→XIa→IX→IXa. Factor IXa, together with Factor VIIIa as a cofactor, forms the “tenase complex” that activates Factor X.
The activated partial thromboplastin time (aPTT) measures this pathway. The laboratory adds a contact activator (like kaolin or silica) plus phospholipid to patient plasma and measures time to clot. The “partial” distinguishes it from the PT, which uses complete thromboplastin (tissue factor + phospholipid).
Important nuance: Factor XII deficiency prolongs the aPTT but doesn’t cause bleeding. This is why hemophilia (Factor VIII or IX deficiency) causes severe bleeding, but Factor XII deficiency doesn’t-Factor XII is important in the lab tube but not in vivo.
The Common Pathway-Thrombin Generation (measured by both PT and aPTT): Both pathways converge on Factor X activation. Factor Xa, with Factor Va as a cofactor, forms the “prothrombinase complex” that converts prothrombin (Factor II) to thrombin (Factor IIa). Thrombin then converts fibrinogen (Factor I) to fibrin. Finally, Factor XIII crosslinks fibrin polymers to form a stable clot.
Because the common pathway is measured by both tests, abnormalities here prolong both PT and aPTT. This happens with liver disease (decreased synthesis of multiple factors), DIC (consumption of multiple factors), or supratherapeutic heparin.
Quick Reference: Coagulation Test Interpretation
| PT | aPTT | Likely Cause |
|---|---|---|
| ↑ | Normal | Factor VII deficiency, early warfarin, early vitamin K deficiency, mild liver disease |
| Normal | ↑ | Hemophilia A (VIII), Hemophilia B (IX), Factor XI deficiency, von Willebrand disease, heparin, lupus anticoagulant |
| ↑ | ↑ | Common pathway (X, V, II, I), severe liver disease, DIC, supratherapeutic anticoagulation, vitamin K deficiency |
| Normal | Normal | Factor XIII deficiency, mild platelet disorders, vascular disorders, normal |
Mixing Studies: Deficiency vs. Inhibitor
When PT or aPTT is prolonged, the critical question is: why? Mixing studies provide the answer.
The logic: Mix patient plasma 1:1 with normal pooled plasma, then repeat the test. Normal plasma contains 100% of all clotting factors, and you only need about 50% of most factors for normal clotting.
If the cause is factor deficiency, the normal plasma provides the missing factor, and the mixing study corrects. If the cause is an inhibitor (an antibody that blocks clotting factors), the inhibitor in the patient’s plasma will also block factors in the normal plasma, and the mixing study doesn’t correct.
Mixing Study Interpretation:
| Result | Interpretation |
|---|---|
| Corrects immediately and stays corrected | Factor deficiency (normal plasma provides missing factor) |
| Does not correct | Inhibitor present (blocks factors in both patient and normal plasma) |
| Corrects immediately, prolongs on incubation | Factor VIII inhibitor (time- and temperature-dependent) |
The incubation step matters: Some inhibitors (especially Factor VIII inhibitors) are time- and temperature-dependent-they need time to bind and inactivate factors. A mixing study may correct immediately after mixing but become prolonged after 1-2 hours incubation at 37°C. Always perform incubated mixing studies when evaluating for inhibitors.
Practical interpretation: Correction is typically defined as the mixed result falling within the normal range or within 5 seconds of the normal control. Failure to correct suggests an inhibitor.
The lupus anticoagulant caveat: Lupus anticoagulant (LA) is an antiphospholipid antibody that prolongs the aPTT by interfering with the phospholipid-dependent coagulation assay. Despite prolonging aPTT, LA actually causes thrombosis, not bleeding-this is the classic paradox. LA mixing studies may partially correct because it’s a relatively weak inhibitor; confirm with specific LA testing (dilute Russell viper venom time, hexagonal phase phospholipid neutralization).
The incubated mixing study: Factor VIII inhibitors are time- and temperature-dependent. An immediate mix may correct, but after incubation at 37°C for 1-2 hours, the inhibitor has time to inactivate Factor VIII, and the aPTT becomes prolonged again. Always incubate mixing studies when investigating a prolonged aPTT.
Factor Deficiencies
Hemophilia A: Factor VIII deficiency - X-linked recessive (males affected) - Prolonged aPTT, normal PT - Severity correlates with factor level: Severe (<1%), Moderate (1-5%), Mild (5-40%) - Clinical: Joint bleeding (hemarthrosis), muscle hematomas, prolonged bleeding after surgery - Treatment: Factor VIII concentrate; desmopressin (DDAVP) for mild cases - Emicizumab: Bispecific antibody mimicking factor VIII function
Hemophilia B (Christmas Disease): Factor IX deficiency - X-linked recessive - Clinically identical to hemophilia A - Treatment: Factor IX concentrate
Hemophilia C: Factor XI deficiency - Autosomal (common in Ashkenazi Jews) - Variable bleeding tendency (poor correlation with factor level)
Von Willebrand Disease (vWD)
The most common inherited bleeding disorder (~1% of population).
vWF functions: 1. Platelet adhesion: vWF binds exposed collagen and platelet GPIb/IX → initial platelet plug 2. Factor VIII carrier: vWF stabilizes factor VIII in circulation
Classification:
| Type | Defect | Lab Findings |
|---|---|---|
| Type 1 | Partial quantitative deficiency (most common) | ↓ vWF:Ag, ↓ vWF:RCo, ↓ FVIII |
| Type 2A | Defective vWF with loss of large multimers | ↓ vWF:RCo/vWF:Ag ratio; loss of large multimers |
| Type 2B | Increased affinity for platelets | ↓ platelets; loss of large multimers (consumed) |
| Type 2M | Defective platelet binding, normal multimers | ↓ vWF:RCo/vWF:Ag ratio; normal multimers |
| Type 2N | Defective FVIII binding | ↓↓ FVIII (can mimic hemophilia A) |
| Type 3 | Complete deficiency (rare, severe) | Absent vWF:Ag, vWF:RCo; very low FVIII |
Clinical features: Mucocutaneous bleeding (epistaxis, menorrhagia, bruising, GI bleeding); post-surgical bleeding
Laboratory testing: - vWF:Ag (antigen level) - vWF:RCo (ristocetin cofactor activity-measures function) - Factor VIII level - Ristocetin-induced platelet aggregation (RIPA): ↑ in Type 2B (enhanced binding) - Multimer analysis: Loss of large multimers in 2A, 2B
Treatment: - DDAVP (releases stored vWF): Type 1; contraindicated in 2B (causes thrombocytopenia) - vWF-containing concentrates: Type 3 and severe Type 1/2 - Aminocaproic acid (antifibrinolytic): Adjunct
Acquired Coagulation Disorders
Vitamin K Deficiency
Vitamin K is required for γ-carboxylation of factors II, VII, IX, X (and proteins C, S).
Causes: - Dietary deficiency (rare; vitamin K in green vegetables) - Malabsorption (biliary obstruction, celiac disease, CF) - Antibiotic-mediated (gut bacteria produce vitamin K) - Warfarin therapy
Laboratory: - Prolonged PT first (factor VII has shortest half-life) - Then prolonged aPTT - Corrects with vitamin K administration
Liver Disease Coagulopathy
The liver synthesizes all clotting factors except VIII and vWF. In liver disease: - Decreased synthesis of procoagulant factors (II, V, VII, IX, X) - Also decreased synthesis of anticoagulants (protein C, S, antithrombin) - Net effect: Complex coagulopathy with both bleeding and thrombosis risk
PT/INR elevated but does not accurately reflect thrombotic risk-patients may be hypercoagulable despite elevated INR.
Disseminated Intravascular Coagulation (DIC)
Pathophysiology: Systemic activation of coagulation, leading to: 1. Widespread microthrombi formation → organ ischemia 2. Consumption of clotting factors and platelets → bleeding
DIC is always secondary to an underlying condition.
Causes: - Sepsis (especially gram-negative) - Trauma, burns - Obstetric complications (amniotic fluid embolism, placental abruption, HELLP) - Malignancy (especially acute promyelocytic leukemia) - Transfusion reactions
Laboratory findings: - Prolonged PT and aPTT (factor consumption) - Thrombocytopenia (platelet consumption) - Low fibrinogen (consumed) - Elevated D-dimer (fibrin degradation) - Schistocytes (microangiopathic hemolysis)
Acute DIC: Bleeding predominates (factors consumed faster than produced)
Chronic (compensated) DIC: Thrombosis may predominate (liver can keep up with production); seen with malignancy
Treatment: Treat underlying cause; supportive care with blood products as needed (FFP, cryoprecipitate, platelets) if actively bleeding.
29.4 Hypercoagulable States (Thrombophilia)
Inherited Thrombophilias
Factor V Leiden
Most common inherited thrombophilia in Caucasians (~5% prevalence).
Mechanism: Point mutation in Factor V makes it resistant to inactivation by activated Protein C (APC resistance).
Risk: 5-fold increased VTE risk (heterozygous); 50-fold (homozygous)
Testing: - APC resistance assay (screening): Ratio of aPTT with/without APC - Genetic testing for Factor V Leiden mutation (confirmation)
Prothrombin G20210A Mutation
Second most common inherited thrombophilia (~2% prevalence in Caucasians).
Mechanism: Mutation in 3’ untranslated region → increased prothrombin levels → increased thrombin generation.
Risk: 3-fold increased VTE risk
Testing: Genetic testing (prothrombin level is nonspecific)
Antithrombin Deficiency
Mechanism: Antithrombin (AT) inactivates thrombin, Xa, and other serine proteases. Deficiency → unregulated coagulation.
Risk: High risk of VTE (10-50 fold)
Clinical: Heparin resistance (heparin works by enhancing AT activity; without AT, less effective)
Testing: Antithrombin activity assay (functional)
Protein C Deficiency
Mechanism: Protein C is activated by thrombin-thrombomodulin complex; activated Protein C (APC) inactivates Factors Va and VIIIa. Deficiency → unregulated coagulation.
Clinical: - VTE risk - Warfarin-induced skin necrosis: Protein C has short half-life (~8 hours). When warfarin is started, Protein C drops faster than procoagulant factors, causing transient hypercoagulable state → microvascular thrombosis → skin necrosis.
Protein S Deficiency
Protein S is a cofactor for activated Protein C. Deficiency has similar clinical features.
Testing considerations: Protein S levels decrease with pregnancy, estrogen, inflammation, liver disease. Free Protein S is the active form.
Acquired Thrombophilias
Antiphospholipid Syndrome (APS)
Pathophysiology: Autoantibodies (antiphospholipid antibodies) directed against phospholipid-binding proteins (especially β2-glycoprotein I and prothrombin). Paradoxically, these cause thrombosis (not bleeding) through complex mechanisms including endothelial activation and platelet activation.
Clinical features: - Venous or arterial thrombosis - Pregnancy complications (recurrent miscarriage, stillbirth, preeclampsia)
Laboratory findings: - Prolonged aPTT (lupus anticoagulant interferes with phospholipid-dependent coag tests) - But patient is hypercoagulable (not bleeding)
Diagnostic criteria (requires clinical criterion + laboratory criterion):
Clinical criteria: - Thrombosis (venous or arterial) - Pregnancy morbidity
Laboratory criteria (must be persistent-positive on 2 occasions ≥12 weeks apart): - Lupus anticoagulant (LA) - Anticardiolipin antibodies (aCL) IgG or IgM - Anti-β2-glycoprotein I antibodies (aβ2GPI) IgG or IgM
Lupus anticoagulant testing: 1. Screening: Prolonged phospholipid-dependent test (dilute Russell viper venom time [dRVVT] or sensitive aPTT) 2. Mixing study: Does not correct (inhibitor present) 3. Confirmation: Corrects with excess phospholipid (antibody is phospholipid-dependent)
29.5 Qualitative Platelet Disorders
Qualitative (functional) platelet disorders present with mucocutaneous bleeding despite normal platelet counts. Understanding the molecular basis of each disorder explains the characteristic platelet aggregation patterns and guides diagnosis.
Glanzmann Thrombasthenia
Pathophysiology: Autosomal recessive deficiency or dysfunction of GPIIb/IIIa (integrin αIIbβ3), the fibrinogen receptor essential for platelet aggregation.
GPIIb/IIIa is the final common pathway of platelet aggregation. When platelets are activated by any agonist (ADP, collagen, thrombin, epinephrine), GPIIb/IIIa undergoes conformational change to its active form, binds fibrinogen (and vWF), and crosslinks adjacent platelets. Without functional GPIIb/IIIa, platelets can adhere to the vessel wall but cannot aggregate with each other.
Clinical features: - Severe mucocutaneous bleeding from birth (epistaxis, gingival bleeding, menorrhagia, GI bleeding) - Prolonged bleeding time / abnormal PFA-100 - Normal platelet count and morphology
Platelet aggregation studies - the diagnostic hallmark: - No aggregation to ADP, collagen, epinephrine, thrombin, arachidonic acid (all require GPIIb/IIIa for aggregation) - Normal aggregation to ristocetin (ristocetin causes vWF to bind GPIb, which is intact; doesn’t require GPIIb/IIIa)
This pattern is pathognomonic: absent response to all agonists except ristocetin.
Treatment: Platelet transfusions for bleeding; recombinant Factor VIIa for refractory bleeding; avoid antiplatelet agents; HLA-matched platelets if alloimmunized.
Bernard-Soulier Syndrome
Pathophysiology: Autosomal recessive deficiency of the GPIb/IX/V complex, the receptor for von Willebrand factor essential for platelet adhesion.
GPIb/IX/V mediates the initial adhesion of platelets to exposed subendothelium via vWF. Under high shear conditions (in arterioles), vWF binds to exposed collagen, undergoes conformational change, and captures flowing platelets via GPIb. Without this receptor, platelets cannot adhere to the vessel wall at sites of injury.
Clinical features: - Moderate to severe mucocutaneous bleeding - Giant platelets on blood smear (platelets as large as RBCs) - GPIb/IX/V is also important for normal platelet production - Mild thrombocytopenia (often 20,000-100,000/μL) - May be misdiagnosed as ITP (thrombocytopenia + bleeding)
Platelet aggregation studies: - No aggregation to ristocetin (ristocetin requires GPIb to mediate vWF binding) - Normal aggregation to ADP, collagen, epinephrine, thrombin (these don’t require GPIb)
This is the opposite pattern from Glanzmann - isolated failure to respond to ristocetin.
Distinguishing from von Willebrand disease: Both show absent ristocetin aggregation. The key difference: - vWD: Adding normal plasma (which contains vWF) restores ristocetin response - Bernard-Soulier: Adding normal plasma does NOT restore response (the defect is in the platelet receptor, not the plasma)
Treatment: Platelet transfusions; desmopressin is NOT effective (vWF is normal); avoid alloimmunization.
Storage Pool Disorders
Platelets contain two types of granules that release their contents upon activation:
Dense (δ) granules contain small molecules that amplify platelet activation: - ADP and ATP (recruit more platelets) - Serotonin - Calcium
Alpha (α) granules contain adhesive proteins and growth factors: - Fibrinogen, vWF, fibronectin - Platelet factor 4, β-thromboglobulin - PDGF, TGF-β
Dense granule deficiency (δ-storage pool disease): - Reduced ADP release → impaired secondary wave of aggregation - Aggregation studies show absent or reduced “secondary wave” response to ADP and epinephrine - Associated syndromes: Hermansky-Pudlak syndrome (oculocutaneous albinism), Chediak-Higashi syndrome
Alpha granule deficiency (Gray Platelet Syndrome): - Platelets appear gray/agranular on Wright stain (lack alpha granules) - Thrombocytopenia, large platelets - Associated with myelofibrosis (PDGF and TGF-β normally sequestered in alpha granules are released, stimulating marrow fibrosis)
Acquired Platelet Dysfunction
Uremia: Uremic toxins impair platelet function through multiple mechanisms. Treat with dialysis, desmopressin (DDAVP), or cryoprecipitate.
Medications: - Aspirin: Irreversibly acetylates COX-1, blocking thromboxane A2 synthesis. Effect lasts the platelet’s lifespan (~10 days). - NSAIDs: Reversibly inhibit COX-1; effect wears off as drug clears. - Clopidogrel, prasugrel, ticagrelor: Block P2Y12 ADP receptor. - GPIIb/IIIa inhibitors (abciximab, eptifibatide, tirofiban): Directly block the fibrinogen receptor.
Myeloproliferative neoplasms: Acquired storage pool deficiency, acquired vWD at very high platelet counts.
Cardiopulmonary bypass: Mechanical damage, activation, and consumption of platelets.
29.6 Factor XIII Deficiency
Factor XIII is the final enzyme in the coagulation cascade. After thrombin converts fibrinogen to fibrin, Factor XIII (activated by thrombin) crosslinks fibrin polymers through covalent bonds, creating a stable, insoluble clot resistant to fibrinolysis.
Pathophysiology: Without Factor XIII, fibrin clots form but are unstable and susceptible to premature breakdown by plasmin.
Inheritance: Autosomal recessive; heterozygotes are usually asymptomatic.
Clinical features: - Delayed bleeding - clot forms initially but breaks down hours to days later - Umbilical stump bleeding in neonates (classic presentation) - Intracranial hemorrhage (higher risk than other bleeding disorders) - Poor wound healing - Recurrent miscarriage (Factor XIII is important for placental implantation)
Laboratory diagnosis: - PT and aPTT are NORMAL (Factor XIII acts after fibrin is formed, so it’s not measured by these tests) - Clot solubility test: Patient’s clot is placed in 5M urea or 1% monochloroacetic acid. Normal crosslinked clots are insoluble. Factor XIII-deficient clots dissolve within 24 hours. - Factor XIII activity assay: Quantitative measurement.
Treatment: Factor XIII concentrate (plasma-derived or recombinant); prophylaxis every 4-6 weeks maintains hemostasis (Factor XIII has long half-life ~10 days).
29.7 Acquired Factor Inhibitors
Acquired coagulation factor inhibitors are autoantibodies that neutralize specific clotting factors. The most clinically significant is the acquired Factor VIII inhibitor.
Acquired Factor VIII Inhibitor (Acquired Hemophilia A)
Epidemiology: Rare (1-4 per million/year) but serious. Bimodal distribution: - Young women: Postpartum (appears weeks to months after delivery) - Elderly: Associated with autoimmune diseases, malignancy, or idiopathic
Pathophysiology: IgG autoantibodies bind Factor VIII and neutralize its activity. Unlike alloantibodies in congenital hemophilia patients, these arise spontaneously.
Clinical presentation: - Severe, sudden-onset bleeding in a patient with no prior bleeding history - Extensive soft tissue hematomas, muscle bleeding, retroperitoneal hemorrhage - Unlike congenital hemophilia, joint bleeding (hemarthrosis) is uncommon - High mortality if unrecognized (~20%)
Laboratory findings: - Isolated prolonged aPTT (PT normal) - Mixing study does not correct (or corrects immediately but prolongs on incubation - time-dependent inhibitor) - Factor VIII level very low (<10%, often <1%) - Bethesda assay positive: Quantifies inhibitor titer in Bethesda Units (BU). One BU is the amount of inhibitor that neutralizes 50% of Factor VIII in normal plasma after 2-hour incubation at 37°C.
Treatment: 1. Control acute bleeding: - Low titer inhibitor (<5 BU): High-dose Factor VIII may overcome inhibitor - High titer inhibitor (≥5 BU): Bypassing agents - recombinant Factor VIIa (rFVIIa) or activated prothrombin complex concentrate (aPCC/FEIBA) 2. Eradicate the inhibitor: Immunosuppression with corticosteroids ± cyclophosphamide or rituximab. Most inhibitors can be eradicated, but it takes weeks to months.
29.8 Additional Coagulation Laboratory Tests
Thrombin Time (TT)
What it measures: Time for plasma to clot after adding exogenous thrombin. Measures the final step of coagulation: thrombin → fibrinogen → fibrin.
Prolonged by: - Hypofibrinogenemia (low fibrinogen) - Dysfibrinogenemia (abnormal fibrinogen) - Heparin (thrombin inhibitor) - Direct thrombin inhibitors (dabigatran, argatroban, bivalirudin) - Elevated fibrin degradation products (interfere with fibrin polymerization) - Paraproteins (interfere with fibrin polymerization)
Clinical utility: - Detecting heparin contamination (very sensitive to heparin) - Evaluating fibrinogen disorders - Screening for DTI effect
Reptilase Time
What it measures: Similar to thrombin time, but uses reptilase (a thrombin-like enzyme from Bothrops snake venom) instead of thrombin. Reptilase converts fibrinogen to fibrin but is NOT inhibited by heparin or direct thrombin inhibitors.
Clinical utility: Distinguishing causes of prolonged thrombin time: - Prolonged TT, normal reptilase time → Heparin or DTI (reptilase is not inhibited) - Prolonged TT, prolonged reptilase time → Fibrinogen problem (hypo/dysfibrinogenemia) or FDPs
Fibrinogen Assays
Clauss method (functional): Measures time to clot with excess thrombin; inversely proportional to fibrinogen concentration. Most commonly used.
Immunologic assay: Measures fibrinogen antigen regardless of function. Higher than Clauss method in dysfibrinogenemia (abnormal protein is immunologically detected but doesn’t function).
Interpretation: - Low Clauss, low immunologic → Hypofibrinogenemia (quantitative deficiency) - Low Clauss, normal immunologic → Dysfibrinogenemia (qualitative defect)
D-Dimer
What it measures: D-dimer is a specific fibrin degradation product released when crosslinked fibrin is broken down by plasmin. Indicates that both coagulation (to form crosslinked fibrin) and fibrinolysis (to break it down) have occurred.
Clinical utility: - High negative predictive value for VTE: A negative D-dimer in low-probability patients effectively rules out DVT/PE. - Elevated in: DVT/PE, DIC, recent surgery, trauma, pregnancy, malignancy, infection, inflammation - many conditions cause elevated D-dimer, so it’s not specific.
Platelet Function Testing
Platelet Function Analyzer (PFA-100/PFA-200): Whole blood is aspirated through a small aperture coated with collagen/epinephrine or collagen/ADP. Platelets adhere and aggregate, eventually occluding the aperture. The “closure time” reflects platelet function.
- Sensitive to vWD, severe platelet disorders, aspirin effect
- Not sensitive to mild platelet dysfunction or clopidogrel
- Affected by platelet count <100,000 and hematocrit <30%
Platelet aggregometry (Light Transmission Aggregometry): Gold standard for platelet function testing. Platelet-rich plasma is stirred with various agonists (ADP, collagen, epinephrine, arachidonic acid, ristocetin), and light transmission is measured as platelets aggregate.
Characteristic patterns:
| Disorder | ADP | Collagen | Epinephrine | Arachidonic Acid | Ristocetin |
|---|---|---|---|---|---|
| Glanzmann thrombasthenia | Absent | Absent | Absent | Absent | Normal |
| Bernard-Soulier | Normal | Normal | Normal | Normal | Absent |
| vWD (types 1, 2A, 3) | Normal | Normal | Normal | Normal | Decreased |
| vWD type 2B | Normal | Normal | Normal | Normal | Enhanced (at low-dose ristocetin) |
| Aspirin/NSAID effect | Normal | Decreased | Decreased 2nd wave | Absent | Normal |
| Storage pool disease | Decreased 2nd wave | Decreased | Decreased 2nd wave | Variable | Normal |
29.9 The Fibrinolytic System
The fibrinolytic system dissolves clots after they have served their purpose. Imbalance leads to either bleeding (excess fibrinolysis) or thrombosis (deficient fibrinolysis).
Key components:
Plasminogen: Inactive precursor circulating in plasma; binds to fibrin.
Tissue Plasminogen Activator (tPA): Released from endothelium; converts plasminogen to plasmin. Most active when bound to fibrin (localizes fibrinolysis to clots).
Plasmin: Active enzyme that degrades fibrin (and fibrinogen, Factor V, Factor VIII). Produces fibrin degradation products (FDPs) including D-dimer.
Plasminogen Activator Inhibitor-1 (PAI-1): Inhibits tPA; elevated in obesity, metabolic syndrome.
α2-Antiplasmin: Rapidly inactivates free plasmin in circulation; plasmin bound to fibrin is partially protected.
Hyperfibrinolysis: - Primary: α2-antiplasmin deficiency, PAI-1 deficiency (rare) - Secondary: DIC, liver disease (decreased α2-antiplasmin synthesis), acute promyelocytic leukemia (APL cells release tPA and uPA) - Presents with delayed bleeding, oozing from wounds, mucosal bleeding - Labs: Low fibrinogen, elevated FDPs/D-dimer, shortened euglobulin clot lysis time
Antifibrinolytic therapy: - Tranexamic acid and aminocaproic acid are lysine analogs that block plasminogen binding to fibrin - Used for: Dental procedures in hemophilia, menorrhagia, trauma (CRASH-2 trial), cardiac surgery
Chapter 30: Myeloid Neoplasms
Myeloid neoplasms arise from hematopoietic stem cells with abnormal differentiation, proliferation, or both. The WHO classification organizes them by molecular, morphologic, and clinical features.
30.1 Acute Myeloid Leukemia (AML)
Definition: Clonal expansion of myeloid blasts (≥20% blasts in blood or marrow) OR presence of certain genetic abnormalities regardless of blast count.
Classification (WHO 2022)
- AML with recurrent genetic abnormalities (defined by specific translocations/mutations)
- AML with myelodysplasia-related changes
- Therapy-related myeloid neoplasms
- AML, not otherwise specified (NOS)
AML with Recurrent Genetic Abnormalities
| Subtype | Genetics | Features | Prognosis |
|---|---|---|---|
| APL | t(15;17) PML-RARA | Auer rods, DIC, promyelocytes | Good (with ATRA) |
| AML with t(8;21) | RUNX1-RUNX1T1 | Auer rods, maturation | Favorable |
| AML with inv(16)/t(16;16) | CBFB-MYH11 | Abnormal eosinophils | Favorable |
| AML with t(9;11) | KMT2A-MLLT3 | Monocytic features | Intermediate |
| AML with NPM1 mutation | NPM1 | Cup-like nuclear indentation | Favorable (if no FLT3-ITD) |
| AML with CEBPA mutation | Biallelic CEBPA | Often normal karyotype | Favorable |
| AML with FLT3-ITD | FLT3 internal tandem duplication | High WBC | Adverse |
| AML with TP53 mutation | TP53 | Complex karyotype | Very adverse |
Acute Promyelocytic Leukemia (APL)
The most important AML to recognize because of its unique presentation and treatment.
Genetics: t(15;17)(q24;q21) creating PML-RARA fusion
Pathophysiology: The fusion protein blocks myeloid differentiation at the promyelocyte stage. These cells accumulate and release procoagulant granule contents, causing DIC.
Clinical presentation: - Often presents with DIC (bleeding and/or thrombosis) - May have hyperleukocytosis or leukopenia - Medical emergency-high early mortality from hemorrhage
Morphology: - Hypergranular promyelocytes with numerous Auer rods - Some cells have multiple Auer rods (“faggot cells”) - Microgranular variant: Bilobed nuclei, less apparent granules (can mimic monocytes)

Treatment: - ATRA (all-trans retinoic acid): Differentiates promyelocytes; targeted therapy - Arsenic trioxide: Also promotes differentiation and apoptosis - Often no traditional chemotherapy needed - With modern treatment, cure rates >90%
Differentiation syndrome: Complication of ATRA/ATO therapy. As blasts differentiate, inflammatory response causes fever, pulmonary infiltrates, hypoxia, effusions. Treat with steroids.
Cytochemistry and Immunophenotype
Cytochemical stains (historical, still useful): - Myeloperoxidase (MPO): Positive in myeloid cells - Sudan Black B: Positive in myeloid cells (similar to MPO) - Non-specific esterase: Positive in monocytic cells; inhibited by sodium fluoride
Flow cytometry immunophenotype (standard of care):
| Lineage | Markers |
|---|---|
| Myeloid | CD13, CD33, CD117 (c-kit), MPO |
| Monocytic | CD14, CD64, CD11b, CD11c |
| Erythroid | CD71, Glycophorin A |
| Megakaryocytic | CD41 (GPIIb), CD61 (GPIIIa) |
| Blasts | CD34 (most), CD38 |
30.2 Myelodysplastic Syndromes (MDS)
Definition: Clonal hematopoietic disorders characterized by: - Ineffective hematopoiesis (cytopenias) - Morphologic dysplasia in ≥1 lineage - <20% blasts (otherwise = AML) - Risk of transformation to AML
Morphologic Dysplasia
Dyserythropoiesis: - Nuclear budding, multinucleation, megaloblastic changes - Ring sideroblasts (iron-laden mitochondria around nucleus) - Nuclear-cytoplasmic asynchrony
Dysgranulopoiesis: - Hypogranulation (pale cytoplasm) - Hypolobation (pseudo-Pelger-Huët) - Hypersegmentation is NOT dysplasia
Dysmegakaryopoiesis: - Hypolobated nuclei (especially micromegakaryocytes) - Widely separated nuclear lobes
Peripheral blood dysplasia: Macrocytes, hypogranular neutrophils, giant platelets, circulating blasts
Key Genetic Abnormalities
| Mutation/Cytogenetic | Clinical Association |
|---|---|
| del(5q) | 5q- syndrome (macrocytic anemia, hypolobated megakaryocytes); responds to lenalidomide |
| SF3B1 mutation | Ring sideroblasts; favorable prognosis |
| TP53 mutation | Complex karyotype; poor prognosis |
| del(7) or del(7q) | Poor prognosis |
| Complex karyotype (≥3 abnormalities) | Poor prognosis |
IPSS-R Risk Stratification
The International Prognostic Scoring System (IPSS-R) incorporates: - Cytogenetics - Blast percentage - Hemoglobin - Platelet count - ANC
Categories range from Very Low to Very High risk, guiding treatment decisions.
30.3 Myeloproliferative Neoplasms (MPN)
MPNs are clonal stem cell disorders characterized by effective (not ineffective) proliferation of one or more myeloid lineages. Unlike MDS, the cells are morphologically normal and function properly-the problem is overproduction.
Chronic Myeloid Leukemia (CML)
Defining feature: BCR-ABL1 fusion gene from t(9;22)(q34;q11)-the Philadelphia chromosome
Pathophysiology: BCR-ABL1 encodes a constitutively active tyrosine kinase that drives uncontrolled proliferation of myeloid cells (especially granulocytes).
Phases: 1. Chronic phase: Leukocytosis with full maturation spectrum (myelocytes, metamyelocytes, bands, neutrophils); basophilia; <10% blasts 2. Accelerated phase: 10-19% blasts, increasing basophilia, cytogenetic evolution 3. Blast crisis: ≥20% blasts; transforms to either myeloid (2/3) or lymphoid (1/3) acute leukemia
Laboratory findings: - Markedly elevated WBC (often >100,000/μL) - All stages of granulocyte maturation (“myelocyte bulge”) - Basophilia (characteristic) - Thrombocytosis (common) - Low LAP score (distinguishes from leukemoid reaction)
- BCR-ABL1 detected by cytogenetics, FISH, or PCR
Treatment: Tyrosine kinase inhibitors (imatinib, dasatinib, nilotinib, etc.)-transformed CML treatment; most patients achieve deep molecular remission
The BCR-ABL1-Negative MPNs
Three related disorders, all driven by mutations activating the JAK-STAT pathway:
| Driver Mutation | PV | ET | PMF |
|---|---|---|---|
| JAK2 V617F | ~95% | ~60% | ~60% |
| CALR mutation | Rare | ~25% | ~25% |
| MPL mutation | Rare | ~5% | ~5% |
| Triple-negative | Rare | ~10% | ~10% |
Polycythemia Vera (PV)
Defining feature: Increased red cell mass (polycythemia) independent of erythropoietin
Pathophysiology: JAK2 V617F mutation causes constitutive activation of erythropoietin receptor signaling → EPO-independent erythropoiesis
Clinical features: - Ruddy complexion (plethora) - Pruritus (especially after bathing-aquagenic pruritus) - Splenomegaly - Thrombosis (stroke, MI, Budd-Chiari, portal vein thrombosis) - Erythromelalgia (burning pain in hands/feet)
Laboratory findings: - Elevated hemoglobin/hematocrit (Hgb >16.5 men, >16 women; Hct >49/48%) - Often elevated WBC and platelets - Low serum EPO (suppressed by high Hgb) - JAK2 V617F positive (97%); if negative, check JAK2 exon 12
Diagnosis (WHO criteria): - Elevated Hgb/Hct plus JAK2 mutation, or - Elevated Hgb/Hct plus low EPO and characteristic bone marrow
Complications: - Thrombosis (leading cause of death) - Progression to myelofibrosis (“post-PV MF”) - Transformation to AML (<5%)
Treatment: Phlebotomy (target Hct <45%); low-dose aspirin; cytoreduction (hydroxyurea) if high-risk
Essential Thrombocythemia (ET)
Defining feature: Sustained thrombocytosis (≥450,000/μL) with characteristic megakaryocyte morphology
Clinical features: - Thrombosis (arterial > venous) - Paradoxical bleeding at very high platelet counts (acquired von Willebrand syndrome-large vWF multimers adsorbed by excess platelets) - Erythromelalgia
Bone marrow: Large, hyperlobated (staghorn) megakaryocytes; no significant fibrosis
Diagnosis (WHO criteria): - Platelet count ≥450,000/μL - Bone marrow showing megakaryocyte proliferation with mature morphology - Not meeting criteria for CML, PV, PMF, MDS, or other myeloid neoplasm - JAK2, CALR, or MPL mutation (or other clonal marker)
Primary Myelofibrosis (PMF)
Defining feature: Bone marrow fibrosis with extramedullary hematopoiesis
Pathophysiology: Clonal megakaryocytes release profibrotic cytokines (TGF-β, PDGF), stimulating fibroblast proliferation and collagen deposition. Fibrosis replaces hematopoietic marrow, so hematopoiesis moves to spleen and liver.
Clinical features: - Massive splenomegaly (extramedullary hematopoiesis) - Constitutional symptoms (fatigue, weight loss, night sweats) - Cytopenias (despite being an MPN) - Portal hypertension
Peripheral blood findings: - Leukoerythroblastic picture: Nucleated RBCs + immature granulocytes (WBCs and RBCs released from extramedullary sites) - Teardrop cells (dacrocytes): Distorted by trying to exit fibrotic marrow - Large platelets, thrombocytosis or thrombocytopenia
Bone marrow: “Dry tap” (fibrosis prevents aspiration); biopsy shows reticulin/collagen fibrosis and atypical megakaryocytes
Prognosis: Worse than PV or ET; median survival 5-7 years
Treatment: JAK inhibitors (ruxolitinib) for symptoms/splenomegaly; allogeneic stem cell transplant for eligible patients
Chapter 31: Lymphoid Neoplasms
31.1 Acute Lymphoblastic Leukemia/Lymphoma (ALL)
ALL is a malignancy of lymphoid precursor cells (lymphoblasts). It’s the most common malignancy in children but can occur at any age.
Classification
B-lymphoblastic leukemia/lymphoma (B-ALL): - Most common (85%) - Derived from B-cell precursors
T-lymphoblastic leukemia/lymphoma (T-ALL): - 15% of cases - Often presents with mediastinal mass (thymic involvement) - Derived from T-cell precursors
Immunophenotype
B-ALL markers: - TdT positive (blast marker) - CD19, CD79a positive - CD10 (CALLA) usually positive - Surface Ig negative (immature) - Cytoplasmic μ may be present (pre-B)
T-ALL markers: - TdT positive - CD3 positive (cytoplasmic early, surface later) - CD7 positive (most sensitive T marker) - CD4/CD8: Variable (may be double positive, double negative, or single positive) - CD1a positive in cortical T-ALL
Cytogenetic/Molecular Subtypes (B-ALL)
| Abnormality | Features | Prognosis |
|---|---|---|
| Hyperdiploidy (>50 chromosomes) | Common in children | Favorable |
| t(12;21) ETV6-RUNX1 | Children | Favorable |
| t(9;22) BCR-ABL1 (Ph+) | Increases with age | Unfavorable (improved with TKI) |
| KMT2A rearrangements | Infants | Unfavorable |
| Hypodiploidy (<44 chromosomes) | Any age | Unfavorable |
| Ph-like ALL | Kinase-activating alterations | Unfavorable |
31.2 Chronic Lymphocytic Leukemia (CLL) / Small Lymphocytic Lymphoma (SLL)
CLL and SLL are the same disease: - CLL: Primarily involves blood and marrow (lymphocytosis >5000/μL) - SLL: Primarily involves lymph nodes without significant lymphocytosis
Epidemiology: Most common leukemia in Western adults; median age ~70
Immunophenotype (key for diagnosis): - CD5 positive (unusual for B-cells-helps distinguish CLL) - CD19, CD20 positive (CD20 dim) - CD23 positive - Surface Ig weak/dim (λ or κ light chain restriction) - CD200 positive - FMC7 negative, CD79b weak (helps distinguish from mantle cell)
Blood smear: Small, mature-appearing lymphocytes; smudge cells (fragile cells disrupted during smear preparation)

Prognostic markers: - IGHV mutation status: Mutated = favorable; unmutated = unfavorable - Cytogenetics by FISH: - del(13q) isolated: Favorable - Normal, +12: Intermediate - del(11q), del(17p): Unfavorable (del(17p) = TP53 loss) - ZAP-70, CD38 expression: Positive = unfavorable (correlates with unmutated IGHV)
Complications: - Autoimmune hemolytic anemia (warm type) - Autoimmune thrombocytopenia - Hypogammaglobulinemia → infections - Richter transformation (to diffuse large B-cell lymphoma)-poor prognosis
31.3 Hairy Cell Leukemia
Clinical features: Middle-aged men; splenomegaly; pancytopenia
Pathophysiology: Clonal B-cell with characteristic “hairy” cytoplasmic projections (best seen on phase contrast microscopy).
Blood smear: Lymphocytes with circumferential, irregular cytoplasmic projections
Immunophenotype: - CD19, CD20, CD22 positive - CD11c positive (strongly) - CD25 positive - CD103 positive - CD123 positive - Annexin A1 positive (specific) - CD5 and CD23 negative (helps distinguish from CLL)
Molecular: BRAF V600E mutation in nearly all cases (can be targeted therapeutically)
Special stain: TRAP (tartrate-resistant acid phosphatase) positive-historical marker
Bone marrow: “Fried egg” appearance (cells with abundant cytoplasm separated by reticulin); often “dry tap” (fibrosis)
Treatment: Purine analogs (cladribine, pentostatin)-highly effective; most patients achieve durable remission
31.4 Plasma Cell Neoplasms
Multiple Myeloma
Definition: Clonal plasma cell neoplasm with ≥10% bone marrow plasma cells AND evidence of end-organ damage or biomarkers of malignancy.
Diagnostic criteria:
Myeloma-defining events (CRAB + SLiM): - Calcium elevation (>11 mg/dL) - Renal insufficiency (creatinine >2 mg/dL) - Anemia (Hgb <10 g/dL) - Bone lesions (lytic lesions on X-ray, CT, or PET-CT) - Sixty percent clonal plasma cells in marrow - Light chain ratio involved/uninvolved ≥100 - MRI with >1 focal lesion
Laboratory findings: - M-protein on SPEP (usually IgG > IgA; IgM rare in myeloma) - Abnormal serum free light chain ratio - Bence Jones proteinuria (free light chains in urine) - Rouleaux on blood smear
Bone disease: Osteolytic lesions (myeloma cells produce RANKL, inhibit OPG → osteoclast activation). Bone scan often negative (no osteoblastic activity).
Immunophenotype of myeloma cells: - CD138 (syndecan-1) positive - CD38 positive - Often CD56 positive (aberrant) - CD19 usually negative (unlike normal plasma cells) - CD20 usually negative
Prognosis (R-ISS staging): Based on β2-microglobulin, albumin, LDH, and high-risk cytogenetics (del(17p), t(4;14), t(14;16))
MGUS (Monoclonal Gammopathy of Undetermined Significance)
Criteria: - M-protein <3 g/dL - Clonal plasma cells <10% of marrow - No myeloma-defining events
Clinical significance: ~1% per year risk of progression to myeloma or related disorder
Smoldering Myeloma
Criteria: - M-protein ≥3 g/dL OR clonal plasma cells 10-60% - No myeloma-defining events
Higher risk of progression than MGUS; may be monitored or treated based on risk stratification.
31.5 Non-Hodgkin Lymphomas
Follicular Lymphoma
Second most common NHL (most common indolent NHL)
Pathophysiology: Arises from germinal center B-cells. Characterized by: - t(14;18)(q32;q21): BCL2-IGH fusion (BCL2 is anti-apoptotic) - Follicles that don’t have normal architecture
Immunophenotype: - CD19, CD20, CD10 positive - BCL2 positive (overexpressed due to translocation) - BCL6 positive - CD5 negative (helps distinguish from CLL, mantle cell)
Grading: Based on number of centroblasts (large cells) per high-power field - Grade 1-2: Few centroblasts; indolent - Grade 3A: Many centroblasts - Grade 3B: Sheets of centroblasts; treated as aggressive

Clinical course: Indolent; may wax and wane; not curable with standard therapy but patients live many years. Risk of transformation to DLBCL.
Diffuse Large B-Cell Lymphoma (DLBCL)
Most common NHL (most common aggressive NHL)
Classification (cell of origin): - GCB type (germinal center B-cell origin): Better prognosis - ABC/non-GCB type (activated B-cell): Worse prognosis
Immunophenotype: CD19, CD20 positive; variable CD10, BCL6, MUM1 (used for cell of origin determination-Hans algorithm)
“Double-hit” and “Triple-hit” lymphoma: - MYC rearrangement plus BCL2 and/or BCL6 rearrangement - Highly aggressive; now classified as “High-grade B-cell lymphoma with MYC and BCL2 and/or BCL6 rearrangements” - Poor prognosis; requires intensive therapy
Mantle Cell Lymphoma
Pathophysiology: Arises from naïve B-cells in the mantle zone - t(11;14)(q13;q32): CCND1-IGH → Cyclin D1 overexpression

Immunophenotype: - CD19, CD20 positive - CD5 positive (like CLL-important DDx) - CD23 negative (usually; helps distinguish from CLL) - Cyclin D1 positive (characteristic) - SOX11 positive (most cases)
Clinical: Aggressive course despite indolent appearance; GI involvement common (lymphomatous polyposis)
Marginal Zone Lymphomas
Three subtypes: 1. Extranodal marginal zone lymphoma (MALT lymphoma): Associated with chronic antigen stimulation - Gastric MALT: H. pylori (may regress with antibiotic treatment) - Other sites: Salivary (Sjögren), thyroid (Hashimoto), ocular 2. Nodal marginal zone lymphoma 3. Splenic marginal zone lymphoma: Splenomegaly, villous lymphocytes in blood
Immunophenotype: CD19, CD20 positive; CD5 and CD10 negative
Burkitt Lymphoma
Highly aggressive but potentially curable
Pathophysiology: All cases have MYC translocation - t(8;14) (most common): MYC-IGH - t(2;8) or t(8;22): MYC with light chain genes
Variants: - Endemic (African): EBV associated; jaw involvement - Sporadic: Abdominal involvement; less EBV - Immunodeficiency-associated: HIV/AIDS
Morphology: - Medium-sized cells with deeply basophilic cytoplasm and lipid vacuoles - “Starry sky” pattern (macrophages clearing apoptotic debris among sheets of tumor cells) - Very high mitotic rate, Ki-67 approaches 100%

Immunophenotype: - CD19, CD20, CD10, BCL6 positive - BCL2 negative (unlike follicular lymphoma-MYC drives proliferation without BCL2 protection) - Ki-67 ~100%
31.6 Mature T-Cell and NK-Cell Neoplasms
T-cell lymphomas are less common than B-cell lymphomas but often more aggressive. Unlike B-cell neoplasms, where light chain restriction proves clonality, T-cell clonality is demonstrated by T-cell receptor gene rearrangement studies or by loss of pan-T-cell markers.
Mycosis Fungoides and Sézary Syndrome
These are related cutaneous T-cell lymphomas that arise from skin-homing CD4+ T-cells.
Mycosis fungoides is the most common cutaneous T-cell lymphoma. Despite its name (which predates the understanding that it’s a lymphoma), it has nothing to do with fungi. It progresses through three clinical stages:
The patch stage presents as flat, erythematous, scaly patches, often in sun-protected areas (“bathing suit distribution”). Histology may be subtle-atypical lymphocytes in the epidermis (epidermotropism) with minimal dermal infiltrate.
The plaque stage shows raised, indurated plaques. Histology reveals more prominent epidermotropism, often with Pautrier microabscesses (collections of atypical lymphocytes in the epidermis).
The tumor stage presents with large nodules that may ulcerate. The dermis is heavily infiltrated with atypical lymphocytes that have characteristic cerebriform (convoluted) nuclei.
Sézary syndrome is the leukemic variant-erythroderma (generalized red skin), lymphadenopathy, and circulating Sézary cells (malignant T-cells with cerebriform nuclei) in the blood. It’s more aggressive than mycosis fungoides.
Immunophenotype: CD4+, CD7- (loss of CD7 is characteristic), CD26-. The cells are mature T-helper cells.
Treatment: Skin-directed therapy for early stages (phototherapy, topical steroids, topical chemotherapy). Systemic therapy for advanced disease, including photopheresis (extracorporeal photochemotherapy).
Peripheral T-Cell Lymphoma, Not Otherwise Specified (PTCL-NOS)
This is a wastebasket category for T-cell lymphomas that don’t fit other specific entities. It’s heterogeneous and generally aggressive with poor prognosis.
Anaplastic Large Cell Lymphoma (ALCL)
ALCL is characterized by large cells with abundant cytoplasm and horseshoe-shaped nuclei (“hallmark cells”). All cases are CD30 positive (strongly).
ALK-positive ALCL: Contains the ALK (anaplastic lymphoma kinase) translocation, most commonly t(2;5) creating NPM-ALK fusion. Occurs in children and young adults. Despite appearing aggressive, it has a favorable prognosis with chemotherapy.
ALK-negative ALCL: Lacks the ALK translocation. Occurs in older adults. Worse prognosis than ALK-positive.
Breast implant-associated ALCL: A recently recognized entity arising in the fibrous capsule around breast implants (especially textured implants). Usually indolent if confined to the capsule; complete capsulectomy may be curative.
Adult T-Cell Leukemia/Lymphoma (ATLL)
Caused by HTLV-1 (human T-lymphotropic virus type 1). Endemic in Japan, Caribbean, and parts of Africa and South America.
Clinical features: Lymphadenopathy, hepatosplenomegaly, skin lesions, hypercalcemia (from PTHrP production), and characteristic “flower cells” (multilobated nuclei) in blood.
Prognosis: Extremely poor for acute and lymphomatous forms. The virus integrates into the host genome and drives T-cell proliferation through the Tax protein.
31.7 Hodgkin Lymphoma
Hodgkin lymphoma is fundamentally different from non-Hodgkin lymphomas-the malignant cells (Reed-Sternberg cells) comprise only a tiny fraction of the tumor mass, which is predominantly reactive inflammatory cells. This explains the B symptoms (fever, weight loss, night sweats) that are common in Hodgkin lymphoma-the inflammatory milieu produces cytokines.
The Reed-Sternberg Cell: A Bizarre B-Cell
The Reed-Sternberg (RS) cell is the diagnostic hallmark. It’s a large cell (20-50 μm) with bilobed or multilobed nucleus, each lobe containing a prominent eosinophilic nucleolus, creating the classic “owl eye” appearance.

The origin of RS cells was long mysterious because they lack typical B-cell markers. Molecular studies revealed they derive from germinal center B-cells that have undergone “crippling” immunoglobulin gene mutations-mutations that would normally trigger apoptosis, but the cells escape death through mechanisms including EBV infection (in ~40% of cases) and constitutive NF-κB activation.
Immunophenotype of classic RS cells: - CD30 positive: Always; essential for diagnosis - CD15 positive: Usually; helpful for diagnosis - CD45 negative: Unlike most hematologic malignancies - CD20 negative or variable: Despite B-cell origin - PAX5 weakly positive: Confirms B-cell lineage
The RS cell immunophenotype helps distinguish Hodgkin from large cell NHL and other mimics.
Classical Hodgkin Lymphoma (95% of cases)
Four subtypes, all sharing the classic RS cell immunophenotype:
Nodular sclerosis (70% of classical HL): The most common subtype. Presents in young adults with mediastinal involvement. Histologically characterized by collagen bands dividing the node into nodules, and “lacunar cells” (RS variants with cytoplasm that retracts during fixation, creating a clear space). EBV association is low.
Mixed cellularity (20-25%): Mixed inflammatory background with eosinophils, plasma cells, histiocytes, and scattered RS cells. More common in older adults and HIV-positive patients. Often EBV-associated.
Lymphocyte-rich (5%): Nodular growth pattern with abundant small lymphocytes and scattered RS cells. Best prognosis of classical subtypes.
Lymphocyte-depleted (<5%): Few lymphocytes, numerous RS cells or pleomorphic variants, often with fibrosis. Most aggressive classical subtype. Associated with HIV and EBV.
Nodular Lymphocyte-Predominant Hodgkin Lymphoma (NLPHL) (5%)
This is a distinct entity, different from classical Hodgkin lymphoma:
The malignant cells are “LP cells” (lymphocyte-predominant) or “popcorn cells”-large cells with multilobated, folded nuclei resembling popcorn. Unlike classic RS cells, LP cells are CD20 positive, CD15 negative, CD30 negative, and CD45 positive-essentially retaining B-cell markers.
The clinical course is indolent with excellent prognosis but with risk of late relapses and transformation to DLBCL.
Chapter 32: Flow Cytometry
Flow cytometry is essential for diagnosing and classifying hematologic malignancies. Understanding the principles helps interpret results.
32.1 Principles
How it works: 1. Cells in suspension pass single-file through a laser beam 2. Light scatter and fluorescence are detected 3. Forward scatter (FSC): Correlates with cell size 4. Side scatter (SSC): Correlates with internal complexity (granularity, nuclear lobulation) 5. Fluorescence: Antibodies conjugated to fluorophores detect specific antigens
Gating: Sequential selection of cell populations for analysis - Initial gate based on FSC vs. SSC identifies cell populations - Subsequent gates refine analysis to population of interest
32.2 Interpreting Flow Cytometry
Key patterns to recognize:
| Pattern | Diagnosis |
|---|---|
| CD5+, CD19+, CD23+, dim CD20 | CLL |
| CD5+, CD19+, CD23-, Cyclin D1+ | Mantle cell lymphoma |
| CD10+, CD19+, CD5- | Follicular lymphoma, Burkitt, B-ALL |
| CD19+, TdT+, dim CD45 | B-ALL |
| CD3+, TdT+, CD4/CD8 variable | T-ALL |
| CD38++, CD138+, CD19-, abnormal PC markers | Plasma cell myeloma |
Light chain restriction: Normal B-cells show polyclonal κ and λ light chains (κ:λ ratio ~2:1). Monoclonal B-cell population shows either κ or λ only-evidence of clonality.
Chapter 33: Bone Marrow Examination
The bone marrow examination is fundamental to hematopathology. Understanding how to interpret the aspirate and biopsy is essential.
Indications for Bone Marrow Examination
- Unexplained cytopenias or cytoses
- Suspected hematologic malignancy (staging, diagnosis)
- Fever of unknown origin
- Staging of lymphoma or solid tumors
- Evaluation of iron stores
- Monitoring treatment response
- Evaluation of abnormal peripheral blood findings
Specimen Types
Aspirate: Liquid marrow obtained by suction. Best for: - Cell morphology (individual cell detail) - Differential count (myeloid:erythroid ratio) - Iron stain - Flow cytometry - Cytogenetics - Molecular studies
Core biopsy: Solid cylinder of bone and marrow. Best for: - Overall cellularity assessment - Architecture (fibrosis, granulomas, metastatic tumor) - Focal lesions that may be missed by aspiration - Reticulin/collagen staining
Touch preparations (imprints): Biopsy touched to slide before fixation. Useful when aspirate is a “dry tap.”
Cellularity Assessment
Cellularity is the percentage of marrow space occupied by hematopoietic cells (vs. fat).
Normal cellularity by age: Approximately 100 minus age (±10%) - Infant/child: 80-100% - Young adult: 60-70% - Elderly: 30-40%
Hypercellular marrow (>expected for age): - Reactive: Infection, hemolysis, recovery from chemotherapy - Neoplastic: Leukemia, MPN, MDS
Hypocellular marrow (<expected for age): - Aplastic anemia - Hypoplastic MDS - Post-chemotherapy - Some infections (parvovirus B19)
The Myeloid:Erythroid (M:E) Ratio
Normal M:E ratio is approximately 2:1 to 4:1 (myeloid cells outnumber erythroid precursors).
| M:E Ratio | Interpretation |
|---|---|
| Increased (>4:1) | Myeloid hyperplasia (infection, CML, G-CSF), erythroid hypoplasia (pure red cell aplasia) |
| Decreased (<2:1) | Erythroid hyperplasia (hemolysis, blood loss, B12/folate recovery), myeloid hypoplasia |
Maturation Assessment
Normal myeloid maturation: Progressive stages visible-blast → promyelocyte → myelocyte → metamyelocyte → band → neutrophil. A “left shift” means increased immature forms.
Normal erythroid maturation: Pronormoblast → basophilic normoblast → polychromatic normoblast → orthochromatic normoblast → reticulocyte. Look for synchronous nuclear and cytoplasmic maturation.
Dysplasia: Abnormal maturation features (see MDS section). Must involve ≥10% of a lineage to be significant.
Iron Stores Assessment
Iron stain (Prussian blue) on the aspirate assesses:
Storage iron: Iron in macrophages. Graded 0-4+ (absent to markedly increased). - Absent: Iron deficiency - Increased: Anemia of chronic disease, sideroblastic anemia, hemochromatosis, transfusion iron overload
Sideroblasts: Erythroid precursors with iron granules (normal: scattered fine granules in 20-50% of normoblasts)
Ring sideroblasts: ≥5 iron granules encircling ≥1/3 of the nucleus. These represent iron-laden mitochondria and are pathologic-seen in: - MDS with ring sideroblasts (SF3B1 mutation) - Congenital sideroblastic anemia - Acquired sideroblastic anemia (alcohol, lead, drugs)
Common Patterns
| Finding | Consider |
|---|---|
| Hypercellular, left-shifted myelopoiesis | CML, infection, G-CSF effect |
| Hypercellular with dysplasia | MDS |
| Hypercellular with blasts ≥20% | Acute leukemia |
| Hypocellular with fatty replacement | Aplastic anemia |
| Dry tap with teardrop cells on smear | Myelofibrosis |
| Paratrabecular lymphoid aggregates | Follicular lymphoma, other B-NHLs |
| Interstitial lymphoid infiltrate | CLL, other low-grade lymphomas |
| Non-caseating granulomas | Sarcoidosis, infections (TB, fungal), drugs |
| Metastatic carcinoma (clusters) | Breast, prostate, lung most common |
Chapter 34: Post-Transplant Lymphoproliferative Disorder (PTLD)
PTLD represents a spectrum of lymphoid proliferations occurring in immunosuppressed transplant recipients. Understanding PTLD requires appreciating the role of EBV and the balance between immune surveillance and malignant transformation.
Pathophysiology
In immunocompetent individuals, EBV infects B-cells and drives their proliferation, but T-cells control this proliferation. In transplant recipients on immunosuppression, T-cell surveillance is impaired, allowing EBV-infected B-cells to proliferate unchecked. Most PTLD is EBV-driven, though EBV-negative cases occur (usually later post-transplant, more aggressive).
Risk Factors
- EBV seronegativity at transplant (highest risk-primary EBV infection post-transplant)
- Type of transplant: Higher risk with more intense immunosuppression
- Highest: Intestinal, multivisceral, lung
- Intermediate: Heart, liver
- Lowest: Kidney
- Intensity of immunosuppression: T-cell depleting agents (ATG, OKT3) increase risk
- Time post-transplant: Most cases occur in first year (EBV+ cases); EBV- cases occur later
- Pediatric recipients (more likely EBV-naïve)
WHO Classification of PTLD
1. Non-destructive PTLD (early lesions) - Plasmacytic hyperplasia - Infectious mononucleosis-like - Florid follicular hyperplasia - Preserve nodal architecture; polyclonal or oligoclonal
2. Polymorphic PTLD - Mixed population of lymphocytes, plasma cells, immunoblasts - Destructive (efface architecture) - Usually EBV+, often clonal - May regress with reduced immunosuppression
3. Monomorphic PTLD (most common) - Fulfills criteria for a lymphoma diagnosis - Usually B-cell (DLBCL-like most common) - Less commonly T-cell or NK-cell - Clonal, often EBV+
4. Classical Hodgkin lymphoma-type PTLD - Rare; resembles classical HL - EBV+ in most cases
Clinical Presentation
- May involve any site (nodal or extranodal)
- Allograft involvement is common and concerning
- GI tract, CNS, and lungs commonly involved
- Often presents with fever, lymphadenopathy, or graft dysfunction
- May mimic rejection in the allograft
Diagnosis
- Tissue biopsy is essential
- EBV testing: EBER in situ hybridization (most sensitive for EBV in tissue)
- EBV viral load monitoring: Rising EBV DNA in blood may precede clinical PTLD
- Clonality studies: Immunoglobulin gene rearrangement
Treatment
Reduction of immunosuppression (RI): First-line for many cases; allows immune reconstitution. Balances PTLD control vs. rejection risk.
Rituximab: Anti-CD20 antibody for CD20+ B-cell PTLD. Often combined with RI.
Chemotherapy: R-CHOP or similar regimens for aggressive or rituximab-refractory disease.
EBV-specific cytotoxic T lymphocytes: Adoptive immunotherapy; restores EBV-specific immunity.
Surgery/radiation: For localized disease.
Chapter 35: Mastocytosis
Mastocytosis is a clonal proliferation of mast cells. The clinical spectrum ranges from indolent cutaneous disease to aggressive systemic mastocytosis with organ damage.
Pathophysiology
KIT D816V mutation is found in >90% of adult systemic mastocytosis. This mutation causes constitutive activation of the KIT receptor tyrosine kinase, driving mast cell proliferation and survival. The mutation is important therapeutically-it confers resistance to imatinib but sensitivity to midostaurin and avapritinib.
Classification
Cutaneous mastocytosis (CM): Mast cell infiltration limited to skin - Urticaria pigmentosa: Most common; reddish-brown macules/papules that urticate when stroked (Darier sign) - Diffuse cutaneous mastocytosis: Rare; diffuse skin thickening - Mastocytoma of skin: Solitary lesion; usually in children
Systemic mastocytosis (SM): Mast cells infiltrate extracutaneous organs (bone marrow, liver, spleen, GI tract) - Indolent SM: No organ dysfunction; good prognosis - Smoldering SM: Higher mast cell burden but no organ damage - SM with associated hematologic neoplasm: SM + MPN, MDS, or other myeloid neoplasm - Aggressive SM: Organ dysfunction (cytopenias, hepatomegaly, malabsorption) - Mast cell leukemia: ≥20% mast cells in bone marrow aspirate or ≥10% in blood
Diagnostic Criteria for Systemic Mastocytosis
Major criterion: Multifocal dense aggregates of ≥15 mast cells in bone marrow or other extracutaneous organ
Minor criteria: 1. >25% of mast cells are spindle-shaped or atypical 2. KIT D816V mutation 3. Mast cells express CD25 and/or CD2 (aberrant; normal mast cells don’t express these) 4. Serum tryptase persistently >20 ng/mL
Diagnosis requires: Major + 1 minor, OR 3 minor criteria
Clinical Features
Mediator-related symptoms (from mast cell degranulation): - Flushing, pruritus, urticaria - Hypotension, syncope (anaphylactoid reactions) - GI symptoms (cramping, diarrhea) - Triggered by heat, exercise, alcohol, certain medications (NSAIDs, opioids)
Organ infiltration symptoms: - Hepatosplenomegaly - Cytopenias - Bone pain, pathologic fractures (mast cell bone lesions) - Malabsorption
Laboratory Findings
- Serum tryptase: Elevated (>20 ng/mL in SM); useful for monitoring
- Bone marrow: Aggregates of atypical mast cells
- Immunophenotype: CD117+ (KIT), CD25+ and/or CD2+ (aberrant)
- KIT D816V mutation: By PCR or sequencing
Treatment
Mediator symptoms: H1 and H2 antihistamines, cromolyn sodium, leukotriene inhibitors, epinephrine for anaphylaxis
Cytoreductive therapy (for advanced SM): Midostaurin (KIT inhibitor approved for advanced SM), avapritinib, cladribine, interferon-α
Chapter 36: Histiocytic and Dendritic Cell Neoplasms
Langerhans Cell Histiocytosis (LCH)
LCH is a clonal proliferation of Langerhans cells, which are dendritic cells normally found in skin and mucosal epithelium. Despite being derived from myeloid precursors, LCH cells express CD1a and langerin (CD207).
Molecular pathogenesis: The MAPK pathway is activated in virtually all cases: - BRAF V600E mutation: ~50-60% of cases - MAP2K1 mutations: Many BRAF-negative cases - This has transformed treatment-BRAF inhibitors are effective
Clinical presentations (historically had separate names, now unified as LCH):
Single-system LCH: - Bone (most common): Lytic “punched-out” lesions, especially skull, ribs, vertebrae. Eosinophilic granuloma was the old name. - Skin: Seborrheic dermatitis-like rash, especially scalp - Lymph node: Usually cervical
Multisystem LCH: - Involvement of 2+ organ systems - “Risk organs” (liver, spleen, bone marrow) involvement predicts worse prognosis - Diabetes insipidus from pituitary involvement (classic presentation) - Pulmonary LCH: Almost exclusively in adult smokers; cystic lung disease
Histopathology: - Langerhans cells with characteristic grooved, folded, or “coffee-bean” nuclei - Mixed inflammatory background with eosinophils (hence “eosinophilic granuloma”) - Birbeck granules on electron microscopy: Tennis racket-shaped cytoplasmic inclusions (pathognomonic but rarely needed for diagnosis now)
Immunophenotype: CD1a+, langerin (CD207)+, S100+
Treatment: - Single bone lesion: Curettage, intralesional steroids, or observation - Multisystem/risk organ: Chemotherapy (vinblastine + prednisone standard) - BRAF-mutated refractory disease: BRAF inhibitors (vemurafenib)
Hemophagocytic Lymphohistiocytosis (HLH)
HLH is not a neoplasm but a life-threatening syndrome of immune dysregulation with excessive activation of macrophages and T-cells, causing a cytokine storm. It’s included here because it’s in the differential of histiocytic disorders and critical to recognize.
Pathophysiology: Normally, NK cells and cytotoxic T-cells kill infected or abnormal cells and then undergo apoptosis-this terminates the immune response. In HLH, this “off switch” fails: - Defective cytotoxic function → ineffective killing → persistent antigen stimulation - Uncontrolled T-cell and macrophage activation - Massive cytokine release (IFN-γ, TNF-α, IL-6, IL-18) - Macrophages phagocytose blood cells (hemophagocytosis)
Classification:
Primary (familial) HLH: Genetic defects in cytotoxic pathway (perforin, MUNC13-4, syntaxin-11, etc.). Usually presents in infancy.
Secondary (acquired) HLH: Triggered by: - Infections (most common trigger): EBV especially, also CMV, HSV, HIV, bacterial, fungal - Malignancy (especially T-cell/NK-cell lymphomas, HL) - Autoimmune/autoinflammatory diseases: “Macrophage activation syndrome” (MAS) in Still disease, SLE
Diagnostic Criteria (HLH-2004): Need 5 of 8 criteria: 1. Fever 2. Splenomegaly 3. Cytopenias (≥2 lineages): Hgb <9, platelets <100K, ANC <1000 4. Hypertriglyceridemia (≥265 mg/dL) and/or hypofibrinogenemia (≤150 mg/dL) 5. Hemophagocytosis in bone marrow, spleen, or lymph nodes 6. Low or absent NK-cell activity 7. Ferritin ≥500 ng/mL (often massively elevated, >10,000) 8. Elevated soluble CD25 (sIL-2R) ≥2400 U/mL
Key laboratory findings: - Ferritin: Massively elevated (often >10,000 ng/mL); ferritin >10,000 is highly specific for HLH in the right clinical context - Fibrinogen: Low (consumed) - Triglycerides: High - LDH: Elevated - Transaminases: Elevated - Soluble CD25 (sIL-2R): Very elevated; reflects T-cell activation
Hemophagocytosis: Macrophages engulfing RBCs, WBCs, or platelets in bone marrow. Present in ~80% but not required for diagnosis. Also not specific-can be seen in other conditions.
Treatment: - Identify and treat trigger (infection, malignancy) - Immunosuppression: Dexamethasone (CNS-penetrating), etoposide - Supportive care: Transfusions, antimicrobials - Emapalumab: Anti-IFN-γ antibody for refractory disease - Stem cell transplant: For familial HLH or refractory disease
Prognosis: High mortality without treatment. Even with treatment, mortality significant (especially malignancy-associated HLH).
PART IV: MEDICAL MICROBIOLOGY
Microbiology is unique among the clinical laboratory sciences in requiring identification of living organisms and understanding their pathogenic mechanisms. This section provides comprehensive coverage of bacteria, viruses, fungi, and parasites with emphasis on organism identification and clinical correlations.
Taxonomic Overview of Human Pathogens
The following hierarchy provides a roadmap for the organisms covered in this section. Understanding where each pathogen fits in this classification aids in predicting its characteristics, staining properties, culture requirements, and antimicrobial susceptibilities.
I. BACTERIA
A. GRAM-POSITIVE
- Cocci
- Catalase-Positive –> STAPHYLOCOCCUS
- Coagulase-positive –> S. aureus (MSSA, MRSA)
- Coagulase-negative –> S. epidermidis, S. saprophyticus, S. lugdunensis
- Catalase-Negative –> STREPTOCOCCUS / ENTEROCOCCUS
- Beta-hemolytic: Group A (S. pyogenes), Group B (S. agalactiae)
- Alpha-hemolytic: Optochin-sensitive (S. pneumoniae), Optochin-resistant (Viridans streptococci)
- Gamma-hemolytic: Bile esculin +, 6.5% NaCl + (Enterococcus); Bile esculin +, 6.5% NaCl - (S. gallolyticus)
- Catalase-Positive –> STAPHYLOCOCCUS
- Bacilli (Rods)
- Spore-forming: Aerobic (Bacillus) vs Anaerobic (Clostridium)
- Non-spore-forming: Listeria monocytogenes, Corynebacterium
- Branching/Filamentous: Actinomyces (anaerobic), Nocardia (aerobic, partially acid-fast)
- Acid-Fast Bacilli
- Mycobacterium tuberculosis complex
- Nontuberculous mycobacteria (MAC, M. kansasii, M. abscessus)
- Mycobacterium leprae
B. GRAM-NEGATIVE
- Cocci
- Neisseria gonorrhoeae (ferments glucose only)
- Neisseria meningitidis (ferments glucose + maltose)
- Moraxella catarrhalis
- Enterobacteriaceae (Oxidase-NEGATIVE)
- Lactose Fermenters (pink on MacConkey): E. coli, Klebsiella, Enterobacter
- Non-Lactose Fermenters (colorless): Salmonella, Shigella, Proteus, Yersinia, Serratia
- Non-Fermenters (Oxidase-POSITIVE)
- Pseudomonas aeruginosa, Acinetobacter baumannii, Stenotrophomonas maltophilia, Burkholderia cepacia
- Fastidious Gram-Negative Bacilli
- Haemophilus influenzae, Legionella pneumophila, Bordetella pertussis
- HACEK organisms, Brucella, Francisella tularensis, Pasteurella, Bartonella
- Curved/Spiral Bacteria
- Vibrio, Campylobacter jejuni, Helicobacter pylori
C. ATYPICAL / GRAM-INDETERMINATE
- Spirochetes: Treponema pallidum, Borrelia burgdorferi, Leptospira interrogans
- Obligate Intracellular: Rickettsia, Coxiella, Anaplasma, Ehrlichia, Chlamydia
- Cell Wall-Deficient: Mycoplasma pneumoniae
II. FUNGI
A. YEASTS (unicellular, reproduce by budding)
- Candida species (germ tube test, CHROMagar for speciation)
- C. albicans - most common; oral thrush, vulvovaginitis, esophagitis (AIDS), candidemia; germ tube POSITIVE
- C. glabrata - second most common; intrinsically fluconazole-resistant, elderly/diabetics
- C. parapsilosis - TPN lines, neonates, hand carriage by healthcare workers
- C. tropicalis - neutropenic patients, hematologic malignancy
- C. krusei - intrinsically fluconazole-resistant, bone marrow transplant patients
- C. auris - emerging MDR threat, healthcare outbreaks, difficult to identify, often pan-resistant
- Cryptococcus (encapsulated, urease positive, India ink visualization)
- C. neoformans - meningitis in AIDS (CD4 <100), “soap bubble” lesions in brain, pigeon droppings
- C. gattii - immunocompetent hosts, Pacific Northwest, pulmonary and CNS disease
- Pneumocystis jirovecii (atypical fungus, cannot be cultured)
- PCP pneumonia in AIDS (CD4 <200), ground-glass opacities on CT
- Diagnosed by methenamine silver or DFA on induced sputum/BAL
- Prophylaxis and treatment: TMP-SMX
- Malassezia furfur (lipophilic, requires oil overlay for culture)
- Tinea versicolor (hypo/hyperpigmented patches, “spaghetti and meatballs” on KOH)
- Folliculitis, catheter-related fungemia (TPN with lipids)
B. MOLDS (multicellular, grow as hyphae)
- Aspergillus (septate hyphae, 45-degree acute angle branching)
- A. fumigatus - most common pathogen; invasive aspergillosis (neutropenia), aspergilloma (“fungus ball”), ABPA (allergic bronchopulmonary aspergillosis in asthmatics/CF)
- A. flavus - sinusitis, produces aflatoxin (hepatocellular carcinoma)
- A. niger - otomycosis (ear infection), black conidia
- A. terreus - intrinsically amphotericin-resistant
- Mucormycetes (pauciseptate/ribbon-like hyphae, 90-degree wide angle branching)
- Rhizopus, Mucor, Lichtheimia (Absidia), Cunninghamella
- Rhinocerebral mucormycosis - diabetic ketoacidosis, iron overload, deferoxamine use
- Angioinvasive → vessel thrombosis, tissue necrosis, black eschar
- Treatment: amphotericin B + surgical debridement; resistant to voriconazole
- Dermatophytes (keratinophilic - infect skin, hair, nails only)
- Trichophyton - all three sites (skin, hair, nails); T. rubrum most common cause of tinea pedis/onychomycosis
- Microsporum - skin and hair only; M. canis from cats/dogs (fluoresces under Wood’s lamp)
- Epidermophyton - skin and nails only (NOT hair); E. floccosum
- Clinical: Tinea capitis (scalp), corporis (body/ringworm), cruris (groin/jock itch), pedis (foot/athlete’s foot), unguium (nails/onychomycosis)
- Fusarium (septate, banana-shaped macroconidia)
- Keratitis (contact lens), disseminated disease in neutropenia, onychomycosis
- Often resistant to amphotericin; voriconazole preferred
- Scedosporium/Lomentospora
- S. apiospermum - near-drowning pneumonia, mycetoma
- L. prolificans - disseminated disease, highly drug-resistant
C. DIMORPHIC FUNGI (mold at 25°C/environment, yeast at 37°C/body - “mold in the cold, yeast in the heat”)
- Histoplasma capsulatum
- Geography: Ohio and Mississippi River valleys, bat/bird droppings (caves, chicken coops)
- Small intracellular yeast within macrophages
- Acute pulmonary histoplasmosis (often asymptomatic), chronic cavitary disease, disseminated (AIDS, immunocompromised) - hepatosplenomegaly, pancytopenia, oral ulcers
- Diagnosis: urine/serum antigen, culture, histopath showing macrophages with yeast
- Blastomyces dermatitidis
- Geography: Great Lakes, Ohio/Mississippi valleys, southeastern US
- Broad-based budding yeast (“figure 8”), thick double-refractile cell wall
- Pulmonary disease, skin lesions (verrucous/ulcerative), osteomyelitis, prostatitis
- Diagnosis: culture, histopath; antigen cross-reacts with Histoplasma
- Coccidioides immitis/posadasii
- Geography: Southwestern US (Arizona, California), Mexico - “Valley fever”
- Spherules containing endospores (unique - does NOT convert to yeast)
- Primary pulmonary infection (60% asymptomatic), erythema nodosum (“desert rheumatism”), disseminated disease (meningitis, skin, bone) - risk factors: pregnancy, Filipino/African ancestry, immunosuppression
- Diagnosis: serology (IgM then IgG), culture (highly infectious - BSL-3)
- Paracoccidioides brasiliensis
- Geography: South America (Brazil, Colombia, Venezuela)
- “Captain’s wheel” / “pilot wheel” - large yeast with multiple peripheral buds
- Chronic pulmonary disease, mucocutaneous lesions (mulberry-like oral lesions), lymphadenopathy
- Sporothrix schenckii
- “Rose gardener’s disease” - inoculation from thorns, sphagnum moss, cats
- Lymphocutaneous sporotrichosis: painless nodule at inoculation site → ascending nodular lymphangitis
- “Cigar-shaped” yeast at 37°C
- Treatment: itraconazole; amphotericin for disseminated
- Talaromyces (Penicillium) marneffei
- Geography: Southeast Asia, Southern China - endemic mycosis of AIDS
- Intracellular yeast with central septum (divides by fission, not budding)
- Disseminated disease: skin papules with central umbilication (molluscum-like), fever, hepatosplenomegaly
III. PARASITES
A. PROTOZOA (single-celled eukaryotes)
Blood and Tissue Protozoa:
- Plasmodium (malaria - Anopheles mosquito vector)
- P. falciparum - most severe, cerebral malaria, no hypnozoites, banana-shaped gametocytes, high parasitemia, knobs on RBCs
- P. vivax - benign tertian, hypnozoites (relapse), Duffy antigen required, enlarged RBCs, Schuffner dots
- P. ovale - benign tertian, hypnozoites (relapse), oval RBCs with fimbriated edges
- P. malariae - quartan malaria, “band forms,” nephrotic syndrome, no hypnozoites
- P. knowlesi - Southeast Asia, zoonotic (macaques), can cause severe disease, 24-hour cycle
- Diagnosis: thick and thin smears, rapid antigen tests, PCR
- Babesia microti (Ixodes tick - same as Lyme)
- Northeast US, “Maltese cross” tetrad form in RBCs
- Hemolytic anemia, asplenic patients at highest risk
- Co-infection with Lyme, Anaplasma common
- Toxoplasma gondii
- Cat definitive host (oocysts in feces), undercooked meat (tissue cysts)
- Immunocompetent: usually asymptomatic or mononucleosis-like
- AIDS (CD4 <100): ring-enhancing brain lesions, encephalitis
- Congenital: chorioretinitis, hydrocephalus, intracranial calcifications (diffuse)
- Diagnosis: serology (IgG/IgM), PCR of CSF/amniotic fluid
- Trypanosoma
- T. brucei gambiense - West African sleeping sickness, chronic, Winterbottom sign (posterior cervical lymphadenopathy)
- T. brucei rhodesiense - East African sleeping sickness, acute/severe
- Both: tsetse fly vector, trypomastigotes in blood, antigenic variation, CNS involvement (sleeping, behavioral changes)
- T. cruzi - Chagas disease, reduviid bug (“kissing bug”), Central/South America
- Acute: Romana sign (unilateral periorbital edema), chagoma
- Chronic: dilated cardiomyopathy, megacolon, megaesophagus
- Amastigotes in tissue (heart, GI)
- Leishmania (sandfly vector)
- Visceral leishmaniasis (kala-azar) - L. donovani, hepatosplenomegaly, pancytopenia, hypergammaglobulinemia, fever
- Cutaneous leishmaniasis - L. tropica, L. major, L. mexicana; painless ulcer with raised borders
- Mucocutaneous leishmaniasis - L. braziliensis; destructive nasal/oral lesions
- Amastigotes within macrophages (Leishman-Donovan bodies)
- Naegleria fowleri
- Primary amebic meningoencephalitis (PAM), warm freshwater (lakes, hot springs)
- Enters through cribriform plate, rapidly fatal
- Motile trophozoites in CSF
- Acanthamoeba
- Granulomatous amebic encephalitis (GAE) - immunocompromised, subacute
- Keratitis - contact lens wearers (homemade saline)
- Cysts and trophozoites in tissue
Intestinal and Urogenital Protozoa:
- Giardia lamblia (intestinalis)
- “Camper’s diarrhea,” fecal-oral, contaminated water (beavers)
- Bloating, foul-smelling fatty stools (malabsorption), no blood/WBCs
- Trophozoites: “owl face” / falling leaf motility; cysts: 4 nuclei
- Diagnosis: stool antigen, O&P (cysts), string test (trophozoites)
- Entamoeba histolytica
- Amebiasis: bloody diarrhea (flask-shaped ulcers), liver abscess (“anchovy paste”)
- Trophozoites with ingested RBCs, cysts with 4 nuclei and chromatoid bars
- Must distinguish from non-pathogenic E. dispar (antigen testing)
- Cryptosporidium
- Severe watery diarrhea in AIDS (CD4 <100), self-limited in immunocompetent
- Acid-fast oocysts in stool, organisms on brush border
- Waterborne outbreaks (resistant to chlorine)
- Cyclospora cayetanensis
- Prolonged watery diarrhea, imported berries/produce
- Acid-fast oocysts (larger than Cryptosporidium), autofluoresce
- Treatment: TMP-SMX
- Cystoisospora (Isospora) belli
- Chronic diarrhea in AIDS
- Large acid-fast oocysts, Charcot-Leyden crystals (eosinophils)
- Treatment: TMP-SMX
- Microsporidia (Enterocytozoon, Encephalitozoon)
- Chronic diarrhea in AIDS, keratitis
- Tiny spores (1-2 μm), modified trichrome or Gram stain
- Trichomonas vaginalis
- STI, “strawberry cervix,” frothy green-yellow discharge
- Motile trophozoites on wet mount (jerky motility), no cyst stage
- Treat patient AND partner with metronidazole
B. HELMINTHS (multicellular worms - eosinophilia is common)
Nematodes (Roundworms) - cylindrical, complete GI tract
Intestinal Nematodes:
- Ascaris lumbricoides - largest intestinal roundworm
- Fecal-oral (eggs), larval migration through lungs (Loeffler syndrome - eosinophilia, pulmonary infiltrates)
- Intestinal obstruction, biliary/pancreatic obstruction
- Eggs: fertilized (round, mammillated) vs unfertilized (elongated)
- Enterobius vermicularis (pinworm)
- Most common US helminth, fecal-oral, perianal itching (nocturnal)
- Scotch tape test for eggs, no eosinophilia (no tissue invasion)
- Trichuris trichiura (whipworm)
- Fecal-oral, “whip-shaped” worm, rectal prolapse in heavy infection
- Barrel-shaped eggs with bipolar plugs
- Hookworm - skin penetration (walking barefoot)
- Necator americanus (Americas), Ancylostoma duodenale (Old World)
- Larval lung migration, iron deficiency anemia (blood loss from intestinal attachment)
- Eggs: thin-shelled, oval, with developing embryo
- Strongyloides stercoralis
- Skin penetration, autoinfection cycle (can persist for decades)
- Hyperinfection syndrome in immunocompromised (steroids!) - disseminated, gram-negative sepsis
- Larvae (not eggs) in stool - rhabditiform (feeding) vs filariform (infectious)
- Trichinella spiralis
- Undercooked pork/game meat, encysted larvae in muscle
- Periorbital edema, myalgias, eosinophilia, splinter hemorrhages
- Diagnosis: serology, muscle biopsy showing coiled larvae
Tissue Nematodes (Filarial worms): - all transmitted by arthropod vectors
- Wuchereria bancrofti / Brugia malayi
- Lymphatic filariasis, mosquito vector
- Elephantiasis (lymphedema), hydrocele
- Microfilariae with nocturnal periodicity (blood smear at night)
- Onchocerca volvulus
- “River blindness,” blackfly vector, West Africa/Central America
- Subcutaneous nodules (adult worms), skin changes (“leopard skin”), blindness (microfilariae in eye)
- Skin snip for microfilariae
- Loa loa
- “African eye worm,” deerfly (Chrysops) vector
- Migration across conjunctiva, Calabar swellings (transient subcutaneous edema)
- Microfilariae with diurnal periodicity
- Dracunculus medinensis (Guinea worm)
- Contaminated water (copepods), near eradication
- Female worm emerges through skin (usually leg), wound wrapped around stick for slow extraction
- Toxocara canis/cati
- Dog/cat roundworm, children (pica), humans are dead-end host
- Visceral larva migrans (hepatomegaly, eosinophilia) or ocular larva migrans (unilateral vision loss)
Cestodes (Tapeworms) - flat, segmented (proglottids), no GI tract, scolex attachment
- Taenia solium (pork tapeworm)
- Intestinal infection: eating undercooked pork (cysticerci) → adult worm
- CYSTICERCOSIS: eating eggs (fecal-oral, autoinfection) → larvae encyst in tissues
- Neurocysticercosis: seizures, “Swiss cheese” brain, ring-enhancing or calcified cysts
- Proglottids: <13 uterine branches (vs >13 in T. saginata)
- Taenia saginata (beef tapeworm)
- Intestinal infection only (NO cysticercosis)
- Undercooked beef, largest tapeworm (up to 25 meters)
- Proglottids: >13 uterine branches
- Diphyllobothrium latum (fish tapeworm)
- Raw freshwater fish (sushi, gefilte fish)
- Vitamin B12 deficiency (worm competes for B12) → megaloblastic anemia
- Operculated eggs
- Echinococcus granulosus
- Dog definitive host, sheep intermediate host, humans accidental
- Hydatid cyst disease - liver (most common), lung; anaphylaxis if cyst ruptures
- “Water lily sign” / daughter cysts / hydatid sand (scolices)
- Do NOT aspirate without anti-helminthic coverage
- Echinococcus multilocularis
- Fox definitive host, rodents intermediate
- Alveolar echinococcosis - invasive, “parasitic cancer” of liver
- Hymenolepis nana (dwarf tapeworm)
- Most common tapeworm in US, direct fecal-oral (no intermediate host needed)
- Autoinfection possible, institutionalized children
Trematodes (Flukes) - flat, leaf-shaped, unsegmented; complex life cycles with snail intermediate hosts
- Schistosoma (blood flukes) - cercariae penetrate skin in freshwater
- S. mansoni - Africa, South America, Middle East; lateral spine on egg; hepatosplenic disease, “pipestem fibrosis”
- S. japonicum - Asia; small round egg, no spine; most eggs in tissue → severe hepatosplenic disease
- S. haematobium - Africa, Middle East; terminal spine; urinary schistosomiasis, bladder cancer (squamous cell)
- Swimmer’s itch (cercarial dermatitis), Katayama fever (acute schistosomiasis)
- Clonorchis sinensis / Opisthorchis viverrini (liver flukes)
- Raw freshwater fish, Asia
- Biliary obstruction, cholangiocarcinoma
- Operculated eggs with “sitting Buddha” appearance
- Fasciola hepatica (sheep liver fluke)
- Watercress, sheep/cattle, worldwide
- Biliary disease, eosinophilia, “liver rot”
- Large operculated eggs
- Fasciolopsis buski (intestinal fluke)
- Water chestnuts, water bamboo, Asia
- Intestinal obstruction, malabsorption
- Paragonimus westermani (lung fluke)
- Raw freshwater crabs/crayfish, Asia/Americas
- Hemoptysis, lung cysts (mimics TB), eosinophilia
- Operculated eggs in sputum/stool
C. ECTOPARASITES
- Sarcoptes scabiei (scabies mite)
- Intense pruritus (worse at night), burrows in web spaces/wrists/genitals
- Norwegian (crusted) scabies in immunocompromised - highly contagious
- Diagnosis: skin scraping showing mites, eggs, or scybala (feces)
- Lice (Pediculosis)
- Pediculus humanus capitis - head lice, nits on hair shafts
- Pediculus humanus corporis - body lice, live in clothing, vector for typhus/trench fever/relapsing fever
- Phthirus pubis - pubic lice (“crabs”), also eyelashes
- Demodex
- D. folliculorum - hair follicle mite, blepharitis, rosacea
IV. VIRUSES
A. DNA Viruses (all dsDNA except Parvovirus which is ssDNA)
- Herpesviruses (dsDNA, enveloped, establish lifelong latency)
- HSV-1 - oral herpes, herpes encephalitis (temporal lobe), herpetic whitlow, keratitis
- HSV-2 - genital herpes, neonatal herpes (vertical transmission)
- VZV (HHV-3) - varicella (chickenpox), zoster (shingles), Ramsay Hunt syndrome
- EBV (HHV-4) - infectious mononucleosis, Burkitt lymphoma, nasopharyngeal carcinoma, PTLD, oral hairy leukoplakia
- CMV (HHV-5) - mononucleosis-like syndrome, congenital CMV (hearing loss, intracranial calcifications), retinitis/colitis in AIDS, transplant rejection
- HHV-6 - roseola infantum (exanthem subitum), febrile seizures
- HHV-7 - roseola (less common cause)
- HHV-8 - Kaposi sarcoma, primary effusion lymphoma, multicentric Castleman disease
- Hepadnavirus
- Hepatitis B virus (HBV) - acute/chronic hepatitis, cirrhosis, hepatocellular carcinoma; uses reverse transcriptase
- Papillomaviruses (dsDNA, non-enveloped, circular genome)
- HPV 1, 2, 4 - common warts (verruca vulgaris)
- HPV 6, 11 - anogenital warts (condyloma acuminata), laryngeal papillomatosis; LOW-risk
- HPV 16, 18, 31, 33, 45 - cervical/anal/oropharyngeal carcinoma; HIGH-risk (E6 inhibits p53, E7 inhibits Rb)
- Polyomaviruses (dsDNA, non-enveloped)
- JC virus - progressive multifocal leukoencephalopathy (PML) in immunocompromised; demyelination
- BK virus - hemorrhagic cystitis (BMT patients), polyomavirus nephropathy (renal transplant)
- Adenovirus (dsDNA, non-enveloped, icosahedral)
- Pharyngoconjunctival fever, epidemic keratoconjunctivitis (“pink eye”)
- Acute respiratory disease (military recruits)
- Gastroenteritis (serotypes 40, 41)
- Hemorrhagic cystitis (immunocompromised)
- Parvovirus (ssDNA - the ONLY ssDNA human virus, non-enveloped, smallest DNA virus)
- Parvovirus B19 - erythema infectiosum (fifth disease, “slapped cheek”), aplastic crisis (sickle cell), hydrops fetalis, pure red cell aplasia
- Poxviruses (dsDNA, enveloped, largest DNA virus, replicates in CYTOPLASM)
- Variola (Smallpox) - eradicated; synchronous rash, Guarnieri bodies
- Molluscum contagiosum - umbilicated papules, Henderson-Patterson bodies
- Monkeypox - zoonotic, lymphadenopathy distinguishes from smallpox
- Vaccinia - used for smallpox vaccine
B. RNA Viruses
POSITIVE-SENSE ssRNA (genome can directly serve as mRNA)
- Picornaviruses (small, non-enveloped, icosahedral; “PicoRNAvirus”)
- Poliovirus - poliomyelitis (anterior horn cell destruction, flaccid paralysis)
- Coxsackievirus A - hand-foot-mouth disease, herpangina
- Coxsackievirus B - myocarditis, pericarditis, pleurodynia (Bornholm disease)
- Echovirus - aseptic meningitis, nonspecific febrile illness
- Rhinovirus - common cold (>100 serotypes, acid-labile)
- Hepatitis A virus (HAV) - acute hepatitis (fecal-oral, no chronicity), “infectious hepatitis”
- Flaviviruses (enveloped, icosahedral)
- Hepatitis C virus (HCV) - chronic hepatitis (80% chronicity), cirrhosis, HCC; RNA hypervariable region
- Dengue virus - dengue fever, dengue hemorrhagic fever/shock syndrome; Aedes mosquito
- Yellow fever virus - hemorrhagic fever, jaundice, Councilman bodies; Aedes mosquito
- West Nile virus - meningoencephalitis, flaccid paralysis; Culex mosquito, bird reservoir
- Zika virus - congenital microcephaly, Guillain-Barre; Aedes mosquito
- St. Louis encephalitis - encephalitis; Culex mosquito
- Japanese encephalitis - encephalitis in Asia; Culex mosquito, pig reservoir
- Togaviruses (enveloped)
- Rubella virus - German measles (3-day measles), congenital rubella syndrome (cataracts, deafness, PDA, “blueberry muffin” rash)
- Eastern equine encephalitis (EEE) - severe encephalitis, high mortality
- Western equine encephalitis (WEE) - milder encephalitis
- Venezuelan equine encephalitis - flu-like illness, encephalitis
- Chikungunya - severe polyarthralgia (“bending up disease”); Aedes mosquito
- Coronaviruses (enveloped, largest RNA genome, “crown” appearance)
- Common cold coronaviruses (229E, OC43, NL63, HKU1)
- SARS-CoV - severe acute respiratory syndrome (2003)
- MERS-CoV - Middle East respiratory syndrome; camel reservoir
- SARS-CoV-2 - COVID-19; ACE2 receptor entry
- Caliciviruses (non-enveloped)
- Norovirus - viral gastroenteritis (“cruise ship virus,” “winter vomiting disease”), highly contagious, 24-48 hour incubation
- Sapovirus - pediatric gastroenteritis
- Hepeviruses
- Hepatitis E virus (HEV) - acute hepatitis (fecal-oral), high mortality in pregnant women, pig reservoir
NEGATIVE-SENSE ssRNA (must carry RNA-dependent RNA polymerase; genome must be transcribed to + sense first)
- Orthomyxoviruses (enveloped, SEGMENTED genome - 8 segments)
- Influenza A - pandemics and epidemics; avian/swine reservoirs, antigenic shift AND drift
- Influenza B - epidemics only (no animal reservoir), antigenic drift only
- Influenza C - mild respiratory illness
- Paramyxoviruses (enveloped, NON-segmented, contain fusion protein)
- Measles (Rubeola) - cough/coryza/conjunctivitis, Koplik spots, maculopapular rash (starts at head), SSPE, giant cell pneumonia, Warthin-Finkeldey cells
- Mumps - parotitis, orchitis (sterility risk), aseptic meningitis, pancreatitis
- Parainfluenza - croup (barking cough, steeple sign), bronchiolitis; types 1-4
- RSV (Respiratory syncytial virus) - bronchiolitis/pneumonia in infants, palivizumab prophylaxis; syncytia formation
- Human metapneumovirus - RSV-like illness
- Nipah/Hendra viruses - encephalitis, bat reservoir (emerging threat)
- Rhabdoviruses (bullet-shaped, enveloped)
- Rabies virus - fatal encephalitis, Negri bodies (cytoplasmic inclusions in Purkinje cells/hippocampus), hydrophobia, travels retrograde via peripheral nerves
- Filoviruses (filamentous, enveloped)
- Ebola virus - viral hemorrhagic fever, high mortality, fruit bat reservoir
- Marburg virus - viral hemorrhagic fever, African fruit bat reservoir
- Bunyaviruses (enveloped, segmented - 3 segments)
- Hantavirus - hantavirus pulmonary syndrome (Sin Nombre virus, deer mouse), hemorrhagic fever with renal syndrome (Old World hantaviruses)
- California encephalitis virus / La Crosse virus - pediatric encephalitis
- Rift Valley fever virus - hemorrhagic fever, livestock reservoir
- Crimean-Congo hemorrhagic fever - tick-borne hemorrhagic fever
- Arenaviruses (enveloped, segmented - 2 segments, “sandy” appearance from ribosomes)
- Lymphocytic choriomeningitis virus (LCMV) - aseptic meningitis; mouse/hamster reservoir
- Lassa fever virus - hemorrhagic fever in West Africa; rat reservoir
- Junin, Machupo viruses - South American hemorrhagic fevers
DOUBLE-STRANDED RNA
- Reoviruses (non-enveloped, segmented - 10-12 segments, “REO” = Respiratory Enteric Orphan)
- Rotavirus - #1 cause of severe pediatric gastroenteritis worldwide, winter peaks, vaccine available
- Coltivirus - Colorado tick fever
RETROVIRUSES (diploid +ssRNA genome, uses reverse transcriptase to make DNA that integrates into host genome)
- Lentiviruses (slow viruses)
- HIV-1 - AIDS worldwide; CD4+ T cell tropism, CCR5/CXCR4 coreceptors
- HIV-2 - AIDS in West Africa, more indolent course
- Deltaretrovirus
- HTLV-1 - adult T-cell leukemia/lymphoma, HTLV-associated myelopathy (HAM)/tropical spastic paraparesis; transmitted via breast milk, sex, blood
Key Classification Principles:
| Domain | Key Distinguishing Features | Empiric Treatment Considerations |
|---|---|---|
| Gram-positive bacteria | Thick peptidoglycan, purple on Gram stain | β-lactams, vancomycin |
| Gram-negative bacteria | Thin peptidoglycan + outer membrane (LPS), pink on Gram stain | Broader β-lactams, fluoroquinolones |
| Mycobacteria | Mycolic acid cell wall, acid-fast | Rifamycins, isoniazid, ethambutol, pyrazinamide |
| Atypical bacteria | Lack cell wall or obligate intracellular | Macrolides, tetracyclines, fluoroquinolones |
| Fungi | Eukaryotic, ergosterol membrane, chitin/glucan wall | Azoles, echinocandins, amphotericin B |
| Parasites | Eukaryotic, complex life cycles | Varies widely by organism |
| Viruses | Obligate intracellular, DNA or RNA genome | Antivirals specific to viral targets |
Chapter 37: General Microbiology Principles
37.1 Specimen Collection and Transport
The success of microbiological diagnosis depends entirely on proper specimen collection.
General principles: - Collect before antibiotics when possible - Collect from the actual site of infection (not surrounding colonized areas) - Use appropriate containers and transport media - Minimize transport time - Label specimens properly
Common specimen types and considerations:
| Specimen | Collection Considerations |
|---|---|
| Blood cultures | 2-3 sets from separate venipunctures; 20-30 mL total; before antibiotics; aseptic technique |
| Urine | Clean-catch midstream or catheterized; transport quickly or refrigerate |
| CSF | Aseptic lumbar puncture; never refrigerate (N. meningitidis dies in cold) |
| Respiratory | Lower respiratory preferred (sputum quality matters); induced sputum or BAL for some pathogens |
| Stool | Fresh specimen; transport medium for culture; special containers for ova/parasites |
| Wound/abscess | Avoid swabs if possible; aspirate pus; anaerobic transport for deep wounds |
37.2 Microscopy and Staining
The microscope was the first tool to reveal the microbial world, and staining remains foundational to microbiology. Understanding why stains work allows you to interpret results and troubleshoot problems.
The Gram Stain: The Most Important Test in Clinical Microbiology
The Gram stain, developed by Hans Christian Gram in 1884, divides bacteria into two major groups based on fundamental differences in cell wall architecture. This simple test, performed in minutes, immediately narrows the differential and guides empiric antibiotic therapy.
Why the Gram stain works: The difference lies in cell wall structure.
Gram-positive bacteria have a thick peptidoglycan layer (20-80 nm) external to the cell membrane. This thick meshwork of cross-linked sugars and amino acids acts like a sponge, absorbing crystal violet dye and holding it tightly. When decolorizer (alcohol or acetone) is applied, the thick peptidoglycan dehydrates and contracts, trapping the crystal violet-iodine complexes inside. The cells remain purple.
Gram-negative bacteria have a thin peptidoglycan layer (2-7 nm) sandwiched between two membranes-the inner (cytoplasmic) membrane and an outer membrane containing lipopolysaccharide (LPS). When decolorizer is applied, it dissolves the outer membrane lipids, and the thin peptidoglycan cannot retain the crystal violet. The dye washes out, leaving the cells colorless until the pink safranin counterstain is applied.
The clinical power of morphology: Within seconds of examining a Gram stain, the morphology tells you which organisms to consider.
Gram-positive cocci in clusters are virtually always Staphylococcus-the cells divide in multiple planes and stick together. Gram-positive cocci in chains or pairs are Streptococcus or Enterococcus-they divide in one plane and remain attached.
Gram-negative diplococci in a CSF specimen immediately suggest Neisseria meningitidis. The same morphology in a urethral discharge is Neisseria gonorrhoeae. These organisms characteristically appear as kidney-bean-shaped pairs with adjacent sides flattened.
Gram-negative rods are a large group, but the clinical context narrows the differential-Enterobacteriaceae dominate in urinary and intra-abdominal infections, while Pseudomonas is the concern in nosocomial pneumonia.
Acid-Fast Staining: Detecting Mycobacteria
Mycobacteria possess cell walls unlike any other bacteria-up to 60% of their wall mass consists of mycolic acids, long-chain fatty acids that create a waxy, hydrophobic barrier. This barrier makes mycobacteria impermeable to many antibiotics, resistant to desiccation, and able to survive inside macrophages. It also makes them resistant to routine Gram staining and requires a specialized approach.
The Ziehl-Neelsen stain exploits the same property that makes mycobacteria pathogenic. Carbol fuchsin (a red dye mixed with phenol) is applied with heat, which opens the waxy cell wall and allows dye penetration. Once inside, the dye becomes trapped. When the slide is washed with acid-alcohol-a mixture strong enough to decolorize virtually any other organism-mycobacteria retain the red dye because their waxy coat prevents the decolorizer from penetrating. Hence the term “acid-fast.”
Organisms that appear as red rods against a blue (methylene blue counterstain) background are acid-fast bacilli (AFB). In the right clinical context-a patient with chronic cough, night sweats, and upper lobe cavitary disease-this finding is diagnostic of tuberculosis until proven otherwise.
Fluorescent acid-fast staining (auramine-rhodamine) uses a fluorescent dye that binds to mycolic acids. It is more sensitive than conventional staining because fluorescent organisms are easier to spot against a dark background. However, positive results should be confirmed with a conventional stain because some artifacts can fluoresce.
Modified acid-fast staining uses a weaker decolorizer and detects organisms that are “partially” acid-fast-they have some mycolic acids but less than true mycobacteria. This includes Nocardia (important in immunocompromised patients), and the coccidian parasites Cryptosporidium, Cyclospora, and Cystoisospora.
Special Stains and Their Rationale
India ink is a negative stain that doesn’t stain the organism-it stains the background. Cryptococcus neoformans produces a thick polysaccharide capsule that excludes the ink particles, creating a clear halo around the yeast cell. In CSF from an AIDS patient with meningitis, this finding strongly suggests cryptococcal infection, though the cryptococcal antigen test is now preferred for diagnosis.
Calcofluor white binds to chitin in fungal cell walls and fluoresces under UV light. It detects all fungi-yeasts and molds alike-and is more sensitive than potassium hydroxide (KOH) preparations alone.
Silver stains (Gomori methenamine silver, GMS) deposit silver on fungal cell walls, turning them black. GMS is particularly important for detecting Pneumocystis jirovecii in lung tissue and bronchoalveolar lavage. It also highlights other fungi and some bacteria like Legionella.
37.3 Culture Media
Culture media are carefully formulated mixtures that provide the nutrients and conditions bacteria need to grow. Understanding why certain media are used for certain purposes helps you order appropriate cultures and interpret results.
Non-selective Media: Supporting Growth of Most Organisms
Blood agar (usually sheep blood) is the workhorse of the microbiology laboratory. It provides the proteins, carbohydrates, and growth factors that most bacteria require. But beyond mere support of growth, blood agar reveals hemolytic patterns that help identify organisms.
Hemolysis reflects bacterial production of enzymes (hemolysins) that damage red blood cell membranes. Beta-hemolysis produces a clear zone around colonies-the RBCs have been completely lysed. This pattern is seen with Streptococcus pyogenes, Staphylococcus aureus, and Listeria monocytogenes, among others. Alpha-hemolysis produces a greenish zone-the hemoglobin has been oxidized to methemoglobin, but the cells aren’t fully lysed. Streptococcus pneumoniae and the viridans streptococci show this pattern. Gamma-hemolysis means no hemolysis at all.
Chocolate agar is blood agar that has been heated until the red cells lyse, releasing their contents. The brown color (like chocolate) comes from denatured hemoglobin. The critical difference from regular blood agar is that heating releases two growth factors from RBCs: hemin (factor X) and NAD (factor V). Haemophilus influenzae cannot synthesize these factors and will not grow on regular blood agar-it absolutely requires chocolate agar. Neisseria species also grow better on chocolate agar.
Selective Media: Isolating Specific Organisms
When you culture a specimen that contains many different bacteria (like stool or a wound swab), the organisms you’re looking for may be overgrown by normal flora. Selective media contain inhibitors that suppress unwanted organisms while allowing pathogens to grow.
MacConkey agar revolutionized enteric microbiology. It contains bile salts and crystal violet, which inhibit gram-positive bacteria while allowing gram-negative enterics to grow. It also contains lactose and a pH indicator-lactose fermenters produce acid, turning colonies pink, while non-fermenters remain colorless. This immediately distinguishes lactose-fermenting coliforms (E. coli, Klebsiella) from non-fermenters like Salmonella and Shigella, the usual pathogens sought in stool cultures.
Thayer-Martin agar is designed to isolate pathogenic Neisseria (gonorrhoeae and meningitidis) from sites with normal flora, like the genital tract or nasopharynx. It contains antibiotics-vancomycin (kills gram-positives), colistin (kills gram-negatives except Neisseria), and nystatin (kills fungi). Only Neisseria can grow.
Mannitol salt agar exploits the halotolerance of Staphylococcus. The 7.5% salt concentration inhibits most bacteria, but staphylococci thrive. The medium also contains mannitol and a pH indicator-S. aureus ferments mannitol and turns the agar yellow, while coagulase-negative staphylococci typically don’t.
Buffered charcoal yeast extract (BCYE) is the medium for Legionella. These organisms have unusual nutritional requirements-they need L-cysteine and iron supplementation that BCYE provides. The charcoal absorbs toxic substances from the agar. Legionella will not grow on routine media, so BCYE must be specifically requested when Legionnaires’ disease is suspected.
37.4 Identification Methods
Once an organism grows in culture, identification is the next step. The methods available range from simple phenotypic tests that have been used for over a century to sophisticated molecular techniques that can identify organisms in minutes.
Biochemical Testing
For most of microbiology’s history, organisms were identified by what they could metabolize. Can this organism ferment lactose? Does it produce urease? Can it grow without oxygen? These metabolic fingerprints, combined with Gram stain morphology, allow identification of most common pathogens.
The power of biochemical testing lies in its simplicity and low cost. Sugar fermentation tubes show acid production (color change) and gas production (bubbles in a Durham tube). The oxidase test-a drop of reagent that turns purple if cytochrome c oxidase is present-takes seconds and immediately narrows the differential among gram-negative rods. The catalase test distinguishes staphylococci (positive) from streptococci (negative). These tests require only basic supplies and no expensive equipment.
The limitation is time. Traditional biochemical testing requires overnight incubation, sometimes longer for slow-growing organisms. Automated systems (Vitek, MicroScan, Phoenix) miniaturize and accelerate the process but still require pure cultures and several hours of incubation.
MALDI-TOF Mass Spectrometry
MALDI-TOF MS has revolutionized clinical microbiology. What once took 24-48 hours now takes minutes. This technology identifies organisms by their protein fingerprint, particularly ribosomal proteins that vary among species.
The principle is elegant: a colony is smeared onto a target plate, covered with a matrix chemical, and hit with a laser. The laser causes proteins to be ejected and ionized. These ions accelerate through a vacuum tube; smaller proteins travel faster than larger ones. The pattern of arrival times-the mass spectrum-is unique to each species. Software compares the unknown spectrum to a database and provides an identification.
The impact on clinical microbiology has been profound. Blood culture bottles that turn positive at 3 AM can be Gram-stained and identified by the time the microbiologist arrives in the morning. Same-day identification of most organisms has become routine. The technology is cost-effective-once the instrument is purchased, per-test costs are minimal.
Limitations exist: MALDI-TOF requires a pure culture (though direct testing from positive blood cultures is increasingly used), the database must contain the organism (unusual species may not be identified), and closely related species may have indistinguishable spectra (different Shigella species, for example, cannot be reliably distinguished from E. coli).
Molecular Methods
When biochemical testing and MALDI-TOF fail-or when identification is urgent-molecular methods provide the answer.
16S ribosomal RNA gene sequencing is the universal bacterial identifier. All bacteria possess ribosomes, and the genes encoding ribosomal RNA contain both conserved regions (allowing universal PCR primers) and variable regions (allowing species differentiation). When an organism cannot be identified by conventional methods, 16S sequencing provides the answer. It’s the reference standard for describing new species.
Syndrome-based multiplex PCR panels have transformed rapid diagnosis of infectious syndromes. A respiratory panel can simultaneously test for 15-20 pathogens (bacteria and viruses) from a single nasopharyngeal swab in about an hour. Meningitis/encephalitis panels test CSF for bacterial, viral, and fungal causes of CNS infection. GI panels test stool for common causes of infectious diarrhea. These panels are expensive but provide rapid results that guide therapy and infection control.
The limitation of molecular methods is that they detect nucleic acid, not viable organisms. A positive PCR doesn’t necessarily mean viable pathogen-residual DNA from prior infection or colonization may be detected. Clinical correlation is essential.
Chapter 38: Gram-Positive Cocci
The gram-positive cocci include some of the most important human pathogens. Two genera dominate clinical practice: Staphylococcus (catalase-positive) and Streptococcus/Enterococcus (catalase-negative). This simple catalase test-dropping hydrogen peroxide on colonies and watching for bubbles-is the first branch point in identifying any gram-positive coccus.
38.1 Staphylococcus
Staphylococci are gram-positive cocci that divide in multiple planes, producing irregular clusters that resemble bunches of grapes (the name comes from the Greek “staphyle,” meaning grape). All staphylococci produce catalase, the enzyme that breaks down hydrogen peroxide into water and oxygen. This distinguishes them from streptococci, which are catalase-negative.
The next critical distinction is coagulase, an enzyme that clots plasma. Staphylococcus aureus is coagulase-positive; all other staphylococci are coagulase-negative. This matters because S. aureus is far more virulent and requires different treatment considerations.
Staphylococcus aureus: The Superbug
S. aureus is the single most important bacterial pathogen in clinical medicine. It causes disease ranging from minor skin infections to life-threatening bacteremia and endocarditis. Its name comes from the golden (aureus) pigment its colonies produce.
Why S. aureus is so pathogenic: This organism possesses an extraordinary array of virulence factors that allow it to evade immune defenses, adhere to tissues, invade, and cause damage.
The coagulase enzyme that defines S. aureus contributes to its pathogenicity by coating bacteria with fibrin, hiding them from phagocytes. Protein A binds the Fc portion of antibodies in the wrong orientation, preventing opsonization. The golden pigment (staphyloxanthin) is actually an antioxidant that protects against neutrophil-generated reactive oxygen species.
For tissue destruction, S. aureus produces numerous toxins. Alpha-toxin (alpha-hemolysin) punches holes in cell membranes. Proteases, lipases, and hyaluronidase break down tissue barriers. Panton-Valentine leukocidin (PVL) destroys neutrophils and is associated with the severe necrotizing pneumonia and skin infections seen with community-acquired MRSA strains.
Some S. aureus strains produce superantigen toxins that cause specific toxin-mediated diseases. Toxic shock syndrome toxin-1 (TSST-1) causes toxic shock syndrome-fever, hypotension, diffuse rash, and multiorgan failure-classically associated with retained tampons but also occurring with any S. aureus infection. Exfoliative toxins A and B cause staphylococcal scalded skin syndrome, where the toxin cleaves desmoglein-1 in the epidermis, causing widespread skin sloughing in neonates and young children. Enterotoxins cause staphylococcal food poisoning-preformed toxin in food causes vomiting within hours of ingestion.
Identification in the laboratory: S. aureus grows readily on blood agar, producing beta-hemolytic colonies, often with a golden pigment (though not all strains are pigmented, and you can’t rely on color alone). The key tests are catalase (positive, like all staphylococci) and coagulase (positive, distinguishing it from coagulase-negative staphylococci). The tube coagulase test is definitive-mixing colonies with rabbit plasma causes visible clotting within 4 hours. The slide coagulase test detects clumping factor, a surface-bound protein-it’s faster but less specific.
Mannitol salt agar (MSA) exploits two S. aureus features: tolerance of high salt (7.5% NaCl, which inhibits most bacteria) and fermentation of mannitol (which turns the pH indicator yellow). Yellow colonies on MSA are presumptively S. aureus.
The clinical spectrum-from trivial to fatal: S. aureus causes infections ranging from pimples to endocarditis. Skin and soft tissue infections are most common: folliculitis (hair follicle infection), furuncles (boils-deeper infections), carbuncles (interconnected furuncles), impetigo (superficial, crusted lesions), and cellulitis. These can be trivial or can progress to invasive disease.
When S. aureus enters the bloodstream, it causes bacteremia that metastasizes to distant sites with frightening efficiency. S. aureus endocarditis can destroy heart valves within days. Osteomyelitis typically involves the vertebrae or long bones. Septic arthritis destroys joints. Pneumonia, particularly following influenza, is necrotizing and often fatal. The triad of bacteremia, spine pain, and elevated inflammatory markers should prompt urgent imaging for vertebral osteomyelitis.
MRSA-the beta-lactam resistant epidemic: Methicillin-resistant S. aureus carries the mecA gene (or less commonly mecC), which encodes an altered penicillin-binding protein called PBP2a. Normal PBPs are essential for cell wall synthesis and are the targets of beta-lactam antibiotics. PBP2a has such low affinity for beta-lactams that it continues functioning even at high antibiotic concentrations. The result is resistance to all beta-lactams-penicillins, cephalosporins, and carbapenems (with two exceptions: the recently developed ceftaroline and ceftobiprole retain activity).
Two distinct epidemics occurred. Healthcare-associated MRSA (HA-MRSA) emerged in hospitals in the 1960s and spread globally. These strains are often resistant to multiple non-beta-lactam antibiotics as well. Community-associated MRSA (CA-MRSA) emerged in the 1990s in people without healthcare exposure. CA-MRSA strains often carry Panton-Valentine leukocidin (PVL), a pore-forming toxin that destroys neutrophils and is associated with severe skin infections and necrotizing pneumonia in otherwise healthy young people.
Laboratory detection of MRSA: The cefoxitin disk test is the preferred phenotypic method-cefoxitin is a better inducer of mecA expression than oxacillin. Molecular testing (PCR for mecA or mecC) provides definitive results. Chromogenic agars that selectively grow and color MRSA colonies are useful for screening.
Coagulase-Negative Staphylococci (CoNS)
The coagulase-negative staphylococci present a clinical conundrum: they’re the most common organisms isolated from blood cultures, yet most of the time they’re contaminants. Distinguishing true infection from contamination-and knowing when contamination itself has become infection-requires understanding both the organisms and the clinical context.
Staphylococcus epidermidis is the prototypical CoNS and the most common species isolated from clinical specimens. It’s a normal skin inhabitant and almost always reaches culture bottles through skin contamination during phlebotomy. But S. epidermidis is also a legitimate pathogen in specific settings: it’s the leading cause of prosthetic device infections, including prosthetic valve endocarditis, vascular graft infections, and infected orthopedic hardware.
The key to S. epidermidis pathogenicity is biofilm formation. The organism produces polysaccharide intercellular adhesin (PIA) that allows it to stick to plastic and metal surfaces and form multilayered communities. Within biofilms, bacteria are protected from antibiotics and immune defenses. This is why device infections are so difficult to cure without device removal-antibiotics can suppress planktonic bacteria but can’t eradicate biofilm.
Interpreting positive cultures: When CoNS grows from a blood culture, consider: Was there a single positive bottle or multiple? Were the same species and antibiogram present in separate cultures? Does the patient have a central line, prosthetic heart valve, or other hardware? A single positive blood culture from a patient without devices is almost certainly contamination. Multiple positive cultures with the same organism from a patient with a central line probably represents true catheter-related bloodstream infection.
Staphylococcus saprophyticus is unique among CoNS because it has a well-defined clinical niche: urinary tract infections in young, sexually active women. It’s the second most common cause of UTI in this demographic after E. coli. The organism has specific adherence factors for uroepithelium. Unlike S. epidermidis, S. saprophyticus is novobiocin-resistant-a simple disk test distinguishes them.
Staphylococcus lugdunensis deserves special attention because it’s a CoNS that behaves like S. aureus. It causes aggressive native valve endocarditis, deep-seated abscesses, and skin infections with virulence matching S. aureus. It produces a bound coagulase (clumping factor) that can cause positive slide coagulase tests, potentially leading to misidentification as S. aureus-but the tube coagulase test is negative. When S. lugdunensis is identified, it should be treated as aggressively as S. aureus infection.
38.2 Streptococcus
Streptococci are gram-positive cocci that divide in one plane, producing chains or pairs (the name comes from “streptos,” meaning twisted chain). The key feature distinguishing them from staphylococci is catalase-streptococci are catalase-negative. Hydrogen peroxide dropped on colonies produces no bubbles.
Classification: Hemolysis and Lancefield Groups
Streptococci are classified by two complementary systems:
Hemolysis on blood agar provides immediate visual classification. Beta-hemolysis (complete clearing around colonies) indicates complete RBC lysis-the most pathogenic streptococci (Groups A, B) are beta-hemolytic. Alpha-hemolysis (greenish discoloration) indicates partial hemolysis with hemoglobin oxidation-S. pneumoniae and the viridans group produce this pattern. Gamma-hemolysis (no change) means no hemolysis.
Lancefield grouping classifies beta-hemolytic streptococci by cell wall carbohydrate antigens. Rebecca Lancefield developed this serological scheme in the 1930s, and it remains clinically useful: Group A (S. pyogenes), Group B (S. agalactiae), Groups C and G (various species), and so on.
Streptococcus pyogenes (Group A Streptococcus, GAS)
GAS is one of the most important human pathogens, causing diseases ranging from trivial pharyngitis to rapidly fatal necrotizing fasciitis. It’s exclusively a human pathogen-transmission is person-to-person.
Laboratory identification: GAS produces beta-hemolysis on blood agar. Two simple tests provide presumptive identification: sensitivity to bacitracin (a small disk inhibits growth) and PYR positivity (the enzyme pyrrolidonyl arylamidase, which is also positive in enterococci). Lancefield grouping or rapid antigen tests confirm Group A.
Virulence factors-why GAS is so dangerous: The M protein is the most important virulence factor. This surface protein extends from the cell wall like hair, and its structure (coiled-coil with a hypervariable N-terminus) allows for over 200 M types. M protein is antiphagocytic-it inhibits complement deposition. Antibodies to M protein are protective, but because of the antigenic diversity, infection with one M type doesn’t protect against others.
The hyaluronic acid capsule provides additional antiphagocytic protection and has a clever twist-it’s chemically identical to human hyaluronic acid, so the immune system doesn’t recognize it as foreign.
GAS produces two hemolysins. Streptolysin O is oxygen-labile (destroyed by oxygen) and immunogenic-the ASO (antistreptolysin O) titer measures antibodies against it, documenting recent GAS infection. Streptolysin S is oxygen-stable and causes the beta-hemolysis visible on blood agar.
The streptococcal pyrogenic exotoxins (SpeA, SpeB, SpeC) are superantigens-they cross-link MHC Class II molecules to T-cell receptors non-specifically, causing massive T-cell activation and cytokine storm. These toxins cause the rash of scarlet fever and drive streptococcal toxic shock syndrome.
The spectrum of GAS disease:
Suppurative infections range from minor to catastrophic. Pharyngitis (“strep throat”) is the most common-fever, exudative pharyngitis, tender cervical lymphadenopathy. Scarlet fever is pharyngitis plus a diffuse erythematous rash (from pyrogenic exotoxins), with sandpaper texture and pastia lines (accentuation in skin folds). Impetigo is superficial skin infection with honey-crusted lesions. Cellulitis and erysipelas (sharply demarcated, raised cellulitis) are deeper infections. Necrotizing fasciitis is the dreaded “flesh-eating” disease-rapid spread along fascial planes with tissue destruction, often requiring extensive surgical debridement. Streptococcal toxic shock syndrome combines soft tissue infection with shock and multiorgan failure.
Post-infectious sequelae-the immune aftermath: GAS infection can trigger immune-mediated diseases weeks later. Acute rheumatic fever occurs 2-3 weeks after pharyngitis (not skin infection). The mechanism is molecular mimicry-antibodies and T-cells directed against M protein cross-react with cardiac tissue. The Jones criteria diagnose rheumatic fever: major manifestations include carditis, migratory polyarthritis, Sydenham chorea, erythema marginatum, and subcutaneous nodules. Rheumatic heart disease (valvular damage, especially mitral stenosis) results from recurrent episodes-secondary prophylaxis with penicillin prevents recurrences.
Post-streptococcal glomerulonephritis follows either pharyngeal or skin GAS infection. Immune complexes deposit in glomeruli, causing the classic nephritic syndrome-hematuria, proteinuria, hypertension, and edema. It’s usually self-limited but can occasionally cause chronic kidney disease.
Diagnosis and treatment: Rapid antigen detection tests on throat swabs provide quick results but have lower sensitivity than culture-a negative rapid test should be confirmed with culture in children. Treatment with penicillin or amoxicillin shortens symptoms and, importantly, prevents rheumatic fever if started within 9 days of symptom onset. GAS has never developed penicillin resistance.
Streptococcus agalactiae (Group B Streptococcus, GBS)
Group B strep is a commensal organism that colonizes the vaginal and gastrointestinal tracts of about 25% of healthy women. In adults, it rarely causes disease. The reason GBS matters so much in medicine is what it does to newborns.
The neonatal catastrophe: When a colonized mother gives birth vaginally, the baby passes through a birth canal teeming with GBS. Most babies clear the organism without incident, but some develop invasive infection-and when they do, it’s often devastating. GBS is the leading cause of neonatal sepsis and meningitis in developed countries.
Early-onset disease (within the first week of life, usually first 24-48 hours) presents as sepsis, pneumonia, or meningitis. The baby was exposed during delivery, and bacteria that entered the respiratory tract or bloodstream multiply rapidly. Late-onset disease (1 week to 3 months) presents primarily as meningitis and may be acquired from the mother, healthcare workers, or the community.
Prevention through screening: Because colonization is common but disease is uncommon, we can’t treat every colonized mother. Instead, universal screening at 35-37 weeks gestation identifies colonized women, who receive intrapartum antibiotic prophylaxis (penicillin or ampicillin during labor). This dramatically reduces early-onset disease-one of the great successes of evidence-based obstetric practice. Late-onset disease is not prevented by intrapartum antibiotics.
Laboratory identification: GBS produces beta-hemolysis on blood agar. The CAMP test is the classic identification method-when GBS is streaked perpendicular to a streak of S. aureus, an arrowhead-shaped zone of enhanced hemolysis appears where the two organisms’ toxins interact. GBS also hydrolyzes hippurate. Unlike Enterococcus (which shares some characteristics), GBS is PYR-negative.
GBS in adults: While neonatal disease gets the attention, GBS increasingly causes invasive infections in adults, particularly diabetics and the elderly. Skin and soft tissue infections, bacteremia, and bone/joint infections occur. These strains may represent an aging population with more comorbidities or possible changes in GBS epidemiology.
Streptococcus pneumoniae (Pneumococcus)
The pneumococcus is a formidable pathogen that has shaped the history of infectious disease. Before antibiotics, pneumococcal pneumonia killed one-third of those infected. Even today, with vaccines and antibiotics, it remains a leading cause of pneumonia, meningitis, and otitis media worldwide.
What makes the pneumococcus dangerous-the capsule: S. pneumoniae possesses a thick polysaccharide capsule that is absolutely essential for virulence. Strains without capsules are avirulent. The capsule works by preventing phagocytosis-its slippery surface and negative charge repel neutrophils and macrophages, allowing the bacteria to multiply unchecked.
There are over 90 different capsular serotypes, and immunity to one serotype doesn’t protect against others. This antigenic diversity explains why people can get pneumococcal infections repeatedly and why vaccine development has been challenging.
The characteristic morphology: S. pneumoniae appears as lancet-shaped (pointed) gram-positive diplococci. The cells often have a “halo” visible on Gram stain-this is the capsule, which doesn’t take up the stain. The diplococci arrangement with pointed ends is distinctive and helps distinguish pneumococcus from other gram-positive cocci.
Laboratory identification: On blood agar, pneumococci produce alpha-hemolysis-a greenish zone of partial RBC lysis. Two simple tests distinguish pneumococcus from the viridans streptococci (which also produce alpha-hemolysis): optochin sensitivity (pneumococcus is inhibited by optochin, viridans strep is not) and bile solubility (pneumococcus lyses when exposed to bile salts, viridans strep does not). The quellung reaction-capsular swelling when specific antisera are applied-provides serotyping but is rarely performed in routine labs.
Clinical syndromes: Community-acquired pneumonia is the signature disease. The classic presentation-sudden onset of shaking chills, high fever, pleuritic chest pain, and productive cough with “rusty” sputum (blood-tinged from alveolar hemorrhage)-is actually uncommon in the antibiotic era. Most cases present less dramatically. Chest X-ray shows lobar consolidation.
Pneumococcal meningitis is the most common cause of bacterial meningitis in adults and carries a high mortality rate even with appropriate treatment. It may follow pneumonia, otitis media, or sinusitis, or occur without an obvious primary focus.
Otitis media and sinusitis, especially in children, are extremely common pneumococcal infections. While not usually life-threatening, they cause enormous morbidity and antibiotic use.
Vaccines represent a triumph of immunology: The polysaccharide capsule is a target for protective antibodies. PPSV23 contains purified capsular polysaccharides from 23 serotypes. It works in adults but fails in children under 2-their immature immune systems cannot mount a response to pure polysaccharides without T-cell help.
Conjugate vaccines (PCV13, PCV15, PCV20) solve this problem by chemically linking the polysaccharides to a protein carrier (like diphtheria toxoid). This converts the T-cell-independent polysaccharide into a T-cell-dependent antigen, generating robust immunity even in infants. The introduction of conjugate vaccines has dramatically reduced invasive pneumococcal disease in children.
Antibiotic resistance: Pneumococcal resistance to penicillin emerges not through beta-lactamase production but through alterations in penicillin-binding proteins (PBPs). These modified PBPs have reduced affinity for penicillin. Resistance is graded (susceptible, intermediate, resistant) based on MIC, and the clinical breakpoints differ by infection site-what’s susceptible for pneumonia may be resistant for meningitis, where drug penetration is limited.
Viridans Group Streptococci
The viridans streptococci are a heterogeneous collection of species that share key characteristics: they’re alpha-hemolytic (or non-hemolytic), optochin-resistant, and bile-insoluble-all features that distinguish them from S. pneumoniae. They’re called “viridans” from the Latin for green, referring to their alpha-hemolysis.
These organisms are commensals of the mouth and upper respiratory tract. They play a beneficial role by occupying niches that might otherwise be taken by pathogens. But they can cause serious disease when they reach sites they shouldn’t.
Infective endocarditis-the classic viridans disease: Dental procedures and even routine tooth brushing cause transient bacteremia with oral flora, including viridans streptococci. In people with normal heart valves, these bacteria are rapidly cleared. But damaged or abnormal valves-from rheumatic heart disease, congenital defects, or degenerative changes-provide surfaces where bacteria can adhere and proliferate.
Viridans streptococcal endocarditis is the prototype of “subacute bacterial endocarditis.” The infection develops insidiously over weeks to months, with low-grade fever, malaise, weight loss, and the classic peripheral manifestations (splinter hemorrhages, Osler nodes, Janeway lesions) that reflect immune complex deposition and septic emboli. Without treatment, it’s fatal; with treatment, cure rates are high because these organisms remain susceptible to penicillin.
The anginosus group deserves special mention: S. anginosus, S. intermedius, and S. constellatus (collectively the “S. anginosus group” or “S. milleri group”) have a distinctive tendency to form abscesses. When you culture pus from a brain abscess, liver abscess, or other deep-seated collection, and viridans streptococci grow, it’s probably the anginosus group. Some strains produce a characteristic butterscotch odor.
S. mutans and dental caries: This viridans species is the principal agent of tooth decay. It metabolizes sucrose to produce lactic acid, which demineralizes tooth enamel. The importance of dental hygiene has as much to do with preventing S. mutans biofilm formation as anything else.
Streptococcus gallolyticus (formerly S. bovis)
This organism deserves special attention because of its strong clinical association with colorectal pathology-a classic boards topic.
Classification: S. gallolyticus is part of the Streptococcus bovis/equinus complex (SBSEC), which was reclassified in recent years. The clinically important point is that S. gallolyticus (previously S. bovis biotype I) is strongly associated with colorectal neoplasia.
Identification: - Group D streptococcus (Lancefield grouping) - γ-hemolytic (non-hemolytic) or α-hemolytic - Bile esculin positive (like Enterococcus) - 6.5% NaCl negative (distinguishes from Enterococcus) - PYR negative
The colon cancer connection: When S. gallolyticus is isolated from blood cultures (bacteremia) or endocarditis, colonoscopy should be performed to evaluate for colorectal carcinoma or adenomatous polyps. Studies show 25-80% of patients with S. gallolyticus bacteremia have underlying colorectal pathology. The mechanism is thought to involve bacterial translocation through compromised gut mucosa or specific bacterial affinity for neoplastic tissue.
Clinical pearl: Any patient with S. gallolyticus bacteremia or endocarditis needs a GI workup, even if asymptomatic. Missing a colon cancer in this setting is a preventable error.
38.3 Enterococcus
Enterococci are hardy organisms that inhabit the human gastrointestinal tract. They’re gram-positive cocci that form chains or pairs and are catalase-negative-features they share with streptococci, from which they were historically classified (as “Group D streptococci”). But enterococci are distinct organisms with a unique clinical profile, characterized most notably by their intrinsic resistance to many antibiotics and their remarkable ability to acquire resistance to almost everything else.
The enterococcal paradox: These organisms are not particularly virulent. They cause disease primarily in debilitated, hospitalized patients who have been treated with broad-spectrum antibiotics. The very antibiotics meant to help these patients eliminate normal flora competition and select for enterococci-which then cause infection.
Two species dominate human disease: E. faecalis causes 80-90% of enterococcal infections and, while resistant to many antibiotics, generally remains susceptible to ampicillin. E. faecium causes most of the remainder and is far more concerning-it’s often resistant to ampicillin and more likely to be vancomycin-resistant. When a lab reports “Enterococcus species,” knowing whether it’s faecalis or faecium matters for treatment.
Laboratory identification: Enterococci share the PYR positivity of Group A strep but are easily distinguished by bile esculin positivity (they hydrolyze esculin in the presence of bile, producing a black precipitate) and growth in 6.5% NaCl-a high-salt environment that most streptococci cannot tolerate. These simple tests quickly identify the genus.
Intrinsic resistance creates therapeutic challenges: Enterococci are naturally resistant to cephalosporins (all of them), clindamycin, and low levels of aminoglycosides. The aminoglycoside resistance is overcome when aminoglycosides are combined with a cell wall-active agent (ampicillin or vancomycin)-the cell wall agent allows aminoglycoside entry, producing synergistic killing. This is why enterococcal endocarditis is traditionally treated with ampicillin plus gentamicin.
Acquired resistance-the VRE problem: Vancomycin-resistant enterococci (VRE) have become a major hospital pathogen. The vanA gene cluster confers high-level resistance to both vancomycin and teicoplanin and can transfer to other bacteria. The nightmare scenario-vanA transferring to S. aureus to create VRSA-has occurred, though rarely. The vanB gene cluster confers resistance to vancomycin only. The vanC genes are intrinsic to the species E. gallinarum and E. casseliflavus, conferring low-level resistance-these organisms are usually identified and distinguished because they’re motile (other enterococci are not).
Clinical infections: Enterococci primarily cause healthcare-associated infections. Urinary tract infections, especially catheter-associated, are the most common. Bacteremia often follows UTI or intra-abdominal infection. Endocarditis, while less common than in the pre-antibiotic era, still occurs and requires prolonged combination therapy. Enterococci frequently participate in polymicrobial infections-they’re often part of the mix in complicated intra-abdominal infections and wound infections-but their pathogenic contribution in these settings is debated.
Chapter 39: Gram-Positive Bacilli
39.1 Bacillus
The genus Bacillus comprises large, gram-positive, spore-forming rods. Most are harmless environmental organisms, but two species cause significant human disease through completely different mechanisms: B. anthracis through invasive infection with potent toxins, and B. cereus through food poisoning.
Bacillus anthracis
Anthrax occupies a unique place in the history of microbiology. It was the first disease for which a bacterial etiology was proven (by Robert Koch in 1876), the first disease against which animals were vaccinated (by Louis Pasteur in 1881), and it remains the prototypical bioterrorism agent. The 2001 anthrax letter attacks in the United States killed five people and created widespread panic, demonstrating the terror potential of this organism.
What makes B. anthracis special: Unlike most Bacillus species, B. anthracis is non-motile and non-hemolytic. It produces two plasmid-encoded virulence factors that are both required for full pathogenicity: a poly-D-glutamate capsule (unusual because it’s a polypeptide rather than a polysaccharide) that is antiphagocytic, and the tripartite anthrax toxin.
The anthrax toxin is a remarkable three-component system: Protective antigen (PA) is the binding component that delivers the two enzymatic components into host cells. Edema factor (EF) is an adenylate cyclase that causes massive increases in intracellular cAMP, leading to edema. Lethal factor (LF) is a metalloprotease that cleaves MAP kinase kinases, disrupting cell signaling and causing cell death. Neither EF nor LF can enter cells alone-they require PA. This understanding is critical because the anthrax vaccine targets PA, blocking both toxic activities.
Cutaneous anthrax accounts for 95% of naturally occurring cases. Spores enter through a break in the skin, germinate, and multiply locally. The initial lesion is a painless papule that progresses to a vesicle and then ulcerates. What’s distinctive is the black eschar (from Greek for coal-hence “anthrax”)-a painless, depressed black scab surrounded by edema. Without treatment, cutaneous anthrax has about 20% mortality; with antibiotics, death is rare.
Inhalation anthrax is far more deadly and is the form most feared in bioterrorism scenarios. Spores are inhaled and reach the alveoli, where they’re engulfed by macrophages and transported to mediastinal lymph nodes. There they germinate, multiply, and produce toxin. The clinical presentation is initially flu-like, then rapidly progresses to hemorrhagic mediastinitis, sepsis, and shock. Chest imaging shows a widened mediastinum from hemorrhagic lymphadenopathy. Even with aggressive treatment, mortality exceeds 50%.
Laboratory considerations: B. anthracis is a CDC select agent, and laboratory protocols reflect biosafety concerns. Large, non-hemolytic, non-motile gram-positive rods that form “Medusa head” colonies (ground-glass appearance with irregular comma-shaped projections) should be handled with extreme caution and referred to public health laboratories for confirmation.
Bacillus cereus
B. cereus is an environmental organism that causes food poisoning through two distinct mechanisms-one resembling staphylococcal food poisoning, the other resembling C. perfringens.
The emetic syndrome results from ingestion of preformed cereulide toxin. The classic scenario is reheated fried rice: B. cereus spores survive cooking, germinate when rice is left at room temperature, and produce the heat-stable cereulide toxin. Reheating doesn’t destroy the toxin. Within 1-6 hours of eating, patients develop nausea and vomiting. The illness is brief and self-limited.
The diarrheal syndrome results from enterotoxins produced in the intestine after ingestion of vegetative organisms or spores. Onset is 8-16 hours after eating, with watery diarrhea and cramps. This presentation is essentially identical to C. perfringens food poisoning and is also self-limited.
Beyond food poisoning: In immunocompromised patients, particularly those with indwelling catheters or injection drug users, B. cereus can cause serious invasive infections. Endophthalmitis following penetrating eye trauma is a particularly devastating manifestation-the organism produces toxins that rapidly destroy ocular tissues, often resulting in loss of the eye even with prompt treatment.
Distinguishing B. cereus from B. anthracis matters: B. cereus is beta-hemolytic and motile; B. anthracis is non-hemolytic and non-motile. This distinction is critical when a Bacillus species grows from a clinical specimen, particularly in the context of possible bioterrorism.
39.2 Listeria monocytogenes
Listeria is one of the most important foodborne pathogens, not because it causes common disease-it doesn’t-but because it causes devastating disease in vulnerable populations: pregnant women, newborns, the elderly, and the immunocompromised.
Why Listeria is unique among foodborne pathogens: Most bacteria that contaminate food are killed by refrigeration. Listeria is psychrophilic-it thrives at refrigerator temperatures (4°C). This means refrigerated foods that might seem safe can actually allow Listeria to multiply to dangerous levels. The classic high-risk foods are soft cheeses (particularly those made with unpasteurized milk), deli meats, hot dogs, and smoked seafood-all foods that are kept refrigerated and eaten without further cooking.
The intracellular lifestyle: Listeria is a facultative intracellular pathogen that has evolved remarkable mechanisms to survive and spread inside host cells. After being ingested by a macrophage, Listeria escapes from the phagosome into the cytoplasm using listeriolysin O, a pore-forming toxin that punches holes in the phagosomal membrane. Once in the cytoplasm, Listeria hijacks the host cell’s actin machinery using a surface protein called ActA. ActA recruits host actin to polymerize at one pole of the bacterium, creating an “actin rocket tail” that propels the bacterium through the cytoplasm. When the bacterium reaches the cell membrane, it pushes outward, creating a protrusion that is engulfed by neighboring cells-allowing Listeria to spread from cell to cell without ever entering the extracellular space where antibodies could neutralize it.
Clinical presentations: In healthy adults, Listeria typically causes a self-limited febrile gastroenteritis. The real danger is in vulnerable populations. In pregnancy, Listeria can cross the placenta and infect the fetus, causing miscarriage, stillbirth, or neonatal sepsis and meningitis. In the elderly and immunocompromised, Listeria causes meningitis with a mortality rate of 20-30%. The meningitis often has a subacute presentation-developing over days rather than hours-and should be suspected when CSF shows gram-positive rods.
Laboratory identification: Listeria appears as small gram-positive rods that can look almost coccoid. Key features include catalase positivity (distinguishing it from streptococci), beta-hemolysis (narrow zone), and the distinctive “tumbling motility” when grown at room temperature. At 37°C, the motility disappears. The CAMP test is positive, but unlike group B strep (which produces an arrowhead shape), Listeria produces a rectangular zone of enhanced hemolysis.
Treatment considerations: Ampicillin is the drug of choice, often combined with gentamicin for synergy in serious infections. A critical point: Listeria is intrinsically resistant to cephalosporins. This matters because empiric meningitis coverage typically includes ceftriaxone-which won’t cover Listeria. In any patient at risk for Listeria meningitis (elderly, immunocompromised, pregnant), ampicillin must be added to the empiric regimen.
39.3 Corynebacterium
The corynebacteria are gram-positive rods with a distinctive appearance-club-shaped cells that fail to separate completely after division, leaving them arranged in “V” and “L” formations or parallel rows called palisades. This “Chinese letters” arrangement is characteristic and helps identify the genus on Gram stain.
Corynebacterium diphtheriae
Diphtheria was once a leading cause of childhood death. The disease is now rare in vaccinated populations, but understanding its pathogenesis illuminates fundamental principles of bacterial toxin biology and the power of vaccination.
The toxin is the disease: C. diphtheriae causes local infection in the throat, but the systemic disease-the myocarditis, the neuropathy, the death-is caused entirely by a single toxin. This toxin is not even encoded in the bacterial chromosome; it’s carried by a lysogenic bacteriophage. Only strains infected with this phage (lysogenized strains) produce toxin and cause clinical diphtheria.
Diphtheria toxin is the prototype A-B toxin. The B subunit binds to a receptor on host cells, allowing the A subunit to enter. Once inside, the A subunit performs a devastatingly specific biochemical reaction: it ADP-ribosylates elongation factor 2 (EF-2), a protein absolutely essential for ribosome function. With EF-2 inactivated, the cell cannot synthesize proteins and dies. Because a single toxin molecule can inactivate many EF-2 molecules (it acts catalytically), even tiny amounts of toxin are lethal to cells.
Clinical presentation: Respiratory diphtheria begins as pharyngitis, but the hallmark is the pseudomembrane-a thick, gray, adherent membrane composed of dead epithelial cells, inflammatory cells, fibrin, and bacteria. The membrane is tenacious; attempting to remove it causes bleeding. As local disease progresses, the pseudomembrane can extend and obstruct the airway. Massive cervical lymphadenopathy produces the classic “bull neck” appearance.
The systemic effects of absorbed toxin appear after the acute illness. Myocarditis typically develops during weeks two to three and is the leading cause of death. Peripheral neuropathy-often affecting cranial nerves first (palatal paralysis, diplopia) then peripheral nerves-may develop weeks to months later.
Prevention through vaccination: The diphtheria toxoid vaccine contains inactivated toxin. By stimulating antibody production against the toxin, vaccination prevents systemic disease even if colonization occurs. This is why diphtheria has virtually disappeared from vaccinated populations-and why it resurges wherever vaccination rates drop.
Corynebacterium jeikeium
This species deserves mention because it represents the “diphtheroids”-corynebacteria other than C. diphtheriae that are usually dismissed as skin contaminants but can cause real disease in immunocompromised patients. C. jeikeium causes catheter-related bloodstream infections and is notoriously antibiotic-resistant-often susceptible only to vancomycin. When corynebacteria grow from blood cultures in a patient with an indwelling catheter, don’t automatically dismiss them as contamination.
39.5 Anaerobic Gram-Positive Bacilli
Clostridioides (Clostridium) difficile
C. difficile is the most important cause of healthcare-associated diarrhea and one of the most urgent antibiotic resistance threats. Understanding its pathogenesis explains why it’s so difficult to eradicate and why it keeps coming back.
The ecology of C. difficile infection: C. difficile lives in the gut-it’s present in about 3% of healthy adults and up to 30% of hospitalized patients. In a healthy gut, the normal microbiota outcompetes C. difficile and keeps its numbers low through “colonization resistance.” Antibiotics destroy this competition. When broad-spectrum antibiotics decimate the normal flora, C. difficile proliferates unchecked and produces toxins that cause disease. This is why C. difficile infection (CDI) is fundamentally a disease of disrupted microbiota.
The spore problem: C. difficile forms spores, and this single feature explains most of the infection control challenges. Spores are metabolically dormant, encased in a protective coat, and resistant to almost everything-heat, drying, alcohol-based hand sanitizers, and most disinfectants. When a patient with CDI has diarrhea, they shed millions of spores that contaminate the environment and can persist on surfaces for months. Healthcare workers pick up spores on their hands, carry them to the next patient, and the cycle continues. The only way to remove spores from hands is physical washing with soap and water-alcohol doesn’t kill them.
The toxin-mediated disease: C. difficile doesn’t invade tissue. All disease manifestations result from two large toxins: toxin A (TcdA) and toxin B (TcdB). Both toxins enter colonic epithelial cells and inactivate Rho GTPases by glucosylation. Rho GTPases regulate the cytoskeleton; when they’re inactivated, the cytoskeleton collapses, tight junctions break down, and cells die. The result is fluid secretion, inflammation, and mucosal damage.
In severe cases, the damaged mucosa becomes covered with pseudomembranes-plaques of fibrin, mucus, inflammatory cells, and debris that look like yellow-white patches on colonoscopy. Fulminant colitis can progress to toxic megacolon and perforation.
Hypervirulent strains: The NAP1/BI/027 strain emerged in the early 2000s and caused devastating outbreaks. This strain produces more toxin, has additional virulence factors including a binary toxin (CDT), and is associated with fluoroquinolone resistance-which gave it a selective advantage as fluoroquinolone use increased.
Diagnostic approach: The challenge in diagnosis is that detecting C. difficile isn’t the same as diagnosing CDI. Many hospitalized patients carry C. difficile without symptoms (colonization). Only test patients with significant diarrhea (≥3 unformed stools in 24 hours). NAAT is highly sensitive-it detects the toxin genes-but it can’t distinguish colonization from infection. The two-step algorithm uses GDH (an enzyme made by all C. difficile) as a sensitive screen, then confirms with toxin EIA. This approach balances sensitivity and specificity.
Treatment principles: The first step is stopping the inciting antibiotic if possible. Oral vancomycin or fidaxomicin (not IV vancomycin, which doesn’t reach the gut lumen) are preferred. For recurrent infection, which occurs in 20-30% of patients because spores survive in the gut and germinate when treatment stops, fecal microbiota transplantation (FMT) restores colonization resistance by repopulating the gut with healthy bacteria-it’s remarkably effective, with cure rates exceeding 90%.
Clostridium perfringens
C. perfringens is one of the fastest-growing bacteria known-its doubling time of 10 minutes means that what starts as a few contaminating organisms can become an overwhelming infection in hours. This speed, combined with a potent array of tissue-destroying toxins, makes C. perfringens the agent of gas gangrene, one of the most feared infections in surgery and trauma.
The organism: C. perfringens is a large gram-positive rod and an obligate anaerobe. Unlike most clostridia, it rarely forms spores in clinical specimens-but spores are abundant in soil, dust, and the GI tract, explaining how wounds become contaminated. On blood agar, colonies show a distinctive “double zone” of hemolysis: complete hemolysis close to the colony (from α-toxin) and partial hemolysis further out (from θ-toxin).
The toxins do the damage: C. perfringens produces over a dozen toxins, but α-toxin is the key player in gas gangrene. α-toxin is a lecithinase (phospholipase C) that destroys cell membranes by cleaving lecithin, a major membrane phospholipid. When α-toxin attacks muscle cells, they die and lyse, providing more nutrients for bacterial growth. The fermentation of muscle sugars produces gas, which dissects along tissue planes.
Gas gangrene (clostridial myonecrosis) is a surgical emergency. It typically follows traumatic injury or surgery where muscle is contaminated with spores. The wound becomes exquisitely painful-pain out of proportion to examination is an early warning sign. The skin develops a bronze discoloration, then blisters. Crepitus (a crackling sensation from gas in the tissues) may be felt. A thin, foul-smelling “dishwater” discharge seeps from the wound. Systemically, the patient deteriorates rapidly with shock and multiorgan failure. Without emergent surgical debridement-often requiring amputation-death follows within hours. Even with surgery and antibiotics (penicillin plus clindamycin), mortality is substantial.
Food poisoning is a much more benign manifestation. C. perfringens type A produces an enterotoxin in the intestine. When spores in contaminated food (typically meat dishes held at warm temperatures) survive cooking, they germinate and multiply. After ingestion, sporulation in the gut releases enterotoxin, causing watery diarrhea and cramps 8-16 hours later. The illness is self-limited and rarely requires treatment.
Clostridium tetani
Tetanus has been known since antiquity-Hippocrates described the characteristic muscle spasms. The disease is entirely preventable by vaccination, yet it still kills tens of thousands annually in regions with inadequate immunization, particularly neonates in developing countries.
The organism and its niche: C. tetani is an obligate anaerobe that forms terminal spores, giving the cell a distinctive “drumstick” or “tennis racket” appearance. Spores are ubiquitous in soil and remarkably durable-they can survive for decades. The organism itself is not invasive; it remains localized at the wound site. All clinical manifestations result from its toxin.
Tetanospasmin-a toxin of exquisite specificity: Tetanospasmin is the second most potent toxin known (after botulinum toxin). It’s an A-B toxin that enters peripheral nerve terminals and travels retrograde along axons to the spinal cord and brainstem. There, the A subunit cleaves synaptobrevin (VAMP), a protein essential for neurotransmitter release. But tetanospasmin specifically targets inhibitory neurons-those releasing GABA and glycine. Without inhibitory input, motor neurons fire unopposed, and muscles contract uncontrollably.
The clinical picture is unforgettable: Generalized tetanus begins with trismus (lockjaw)-spasm of the masseter muscles makes it impossible to open the mouth. The facial muscles contract, producing risus sardonicus-a grimacing “sardonic smile.” As the disease progresses, spasms spread to the neck, back, and extremities. Opisthotonus is the extreme hyperextension of the spine from paraspinal muscle spasm. Spasms are excruciatingly painful and can be triggered by minor stimuli-a noise, a touch, a light. Respiratory failure from laryngeal spasm or diaphragmatic involvement is the usual cause of death.
Localized tetanus, with rigidity confined to muscles near the wound, may occur and can progress to generalized disease. Neonatal tetanus, from infection of the umbilical stump in babies born to unimmunized mothers, remains a significant cause of infant mortality in developing countries.
Prevention is everything: The tetanus toxoid vaccine is one of medicine’s great successes. The toxoid (inactivated toxin) induces protective antibodies, and boosters maintain immunity. DTaP for children and Tdap for adults include tetanus toxoid. For contaminated wounds in inadequately immunized individuals, tetanus immune globulin provides passive protection.
Clostridium botulinum
Botulinum toxin is the most potent biological toxin known-the estimated lethal dose in humans is approximately 1 nanogram per kilogram body weight. This extraordinary potency reflects the toxin’s mechanism: it blocks neuromuscular transmission, causing flaccid paralysis that can paralyze the diaphragm and kill by respiratory arrest.
The toxin mechanism is the mirror image of tetanus: Both tetanospasmin and botulinum toxin are zinc metalloproteases that cleave SNARE proteins required for synaptic vesicle fusion. But while tetanospasmin blocks inhibitory neurons in the CNS, botulinum toxin blocks the release of acetylcholine at the neuromuscular junction. The result is the opposite of tetanus: flaccid paralysis rather than spastic paralysis.
Seven serotypes (A-G) are recognized, with types A, B, and E causing most human disease. The toxin is an A-B structure-the B component binds to receptors on presynaptic nerve terminals, allowing the A component to enter and cleave synaptobrevin (or SNAP-25, depending on serotype).
Foodborne botulism results from ingesting preformed toxin in food. Classic sources are home-canned vegetables with low acid content, where spores survive inadequate canning and germinate under anaerobic conditions. Commercial canning failures and fermented foods are other sources. Symptoms begin 12-36 hours after ingestion with cranial nerve dysfunction: diplopia, dysphagia, dysarthria, and dilated pupils. Descending symmetric paralysis follows-the hallmark that distinguishes botulism from Guillain-Barré syndrome (which ascends). Respiratory failure may develop. Importantly, patients remain alert-the toxin doesn’t cross the blood-brain barrier.
Infant botulism is the most common form in the United States. Infants under one year ingest spores (the classic source is honey, which is why honey should never be given to infants), which germinate in the immature intestine where normal flora has not yet established colonization resistance. Toxin is produced in vivo. The baby becomes hypotonic (“floppy baby syndrome”), feeds poorly, has a weak cry, and may develop respiratory failure. Unlike foodborne botulism, infant botulism is treated with botulism immune globulin (BIG), not antitoxin.
Wound botulism has emerged as a disease of injection drug users, particularly those injecting black tar heroin. Spores contaminate the drug, germinate in the wound, and produce toxin locally.
Treatment: For foodborne botulism, equine antitoxin neutralizes circulating toxin but cannot reverse toxin already bound to nerve terminals-hence the importance of early administration. Supportive care, often including prolonged mechanical ventilation, is essential. Recovery occurs as new nerve terminals sprout, a process that can take months.
39.4 Gram-Positive Branching Filamentous Rods
Actinomyces and Nocardia are gram-positive bacteria that form branching filaments, giving them a fungus-like appearance on microscopy. They’re often confused with each other and with true fungi, but they’re distinct organisms with very different pathogenesis and treatment. The key to distinguishing them lies in their oxygen requirements and acid-fast staining properties.
Actinomyces israelii
Actinomyces species are normal inhabitants of the human mouth, living in the crevices between teeth and in tonsillar crypts. They’re strict anaerobes and cause no harm in their usual niches. Disease occurs when these organisms breach their normal boundaries-following dental procedures, facial trauma, aspiration, or, classically, in association with intrauterine devices.
Understanding actinomycosis: Unlike most bacterial infections, which present acutely, actinomycosis is a chronic disease that evolves over weeks to months. The organisms grow slowly, forming dense masses of branching filaments surrounded by inflammatory tissue. As the infection progresses, it forms multiple draining sinus tracts that discharge pus containing characteristic “sulfur granules”-yellow, grainy particles that are actually dense colonies of organisms (not sulfur at all; the name refers to their appearance).
Cervicofacial actinomycosis (“lumpy jaw”) is the most common form. It typically follows dental work or tooth extraction, or occurs in patients with poor dental hygiene. A painless indurated mass develops in the jaw or neck, eventually forming sinus tracts that drain through the skin. The infection ignores tissue planes, crossing fascial boundaries and even eroding bone-behavior that often leads clinicians to suspect malignancy rather than infection.
Thoracic actinomycosis results from aspiration of oral contents. The pulmonary infection mimics lung cancer or tuberculosis, with mass lesions, cavitation, and chest wall involvement. Abdominal and pelvic actinomycosis are associated with surgery, trauma, and IUDs-the copper or plastic provides a surface for biofilm formation and anaerobic conditions.
Diagnosis requires suspicion: Because the organisms are slow-growing anaerobes, they’re often missed on routine culture. The sulfur granules in pus are highly suggestive but not pathognomonic (Nocardia and some fungi can produce similar structures). Histopathology showing branching gram-positive filaments in a background of chronic inflammation supports the diagnosis.
Treatment: Actinomyces is exquisitely sensitive to penicillin, which remains the drug of choice. The challenge is duration-because the organisms grow slowly and form dense colonies protected from antibiotics, treatment must continue for 6-12 months. Surgical debridement of large abscesses accelerates recovery.
Nocardia Species
Where Actinomyces is an anaerobic commensal that causes disease by breaching normal barriers, Nocardia is an aerobic environmental organism that causes disease in patients with impaired immunity. This fundamental difference explains their different epidemiology and clinical presentations.
Ecology and host factors: Nocardia species live in soil and decaying organic matter. Infection occurs by inhalation of dust containing the organisms. In immunocompetent people, the infection is contained; clinical nocardiosis is predominantly a disease of the immunocompromised, particularly those on chronic corticosteroids (which impair macrophage function), transplant recipients, and patients with advanced HIV.
The critical distinction-partial acid-fastness: Nocardia has a waxy cell wall that makes it weakly or partially acid-fast. Using a modified acid-fast stain (with a weaker decolorizer than the standard Ziehl-Neelsen), Nocardia stains red while Actinomyces does not. This simple test differentiates the two organisms when you see branching gram-positive filaments.
Pulmonary nocardiosis is the most common presentation. Patients develop nodular or cavitary pneumonia that often mimics tuberculosis or malignancy. The infection has a propensity to disseminate, and brain imaging should be performed in all cases of pulmonary nocardiosis-CNS involvement occurs in 30-50% of cases, often without neurological symptoms. Brain abscesses are frequently multiple.
Treatment differs fundamentally from actinomycosis: Nocardia is not susceptible to penicillin. TMP-SMX is the traditional drug of choice, though species-level identification with susceptibility testing is important because resistance patterns vary. Treatment duration is prolonged (months to years in immunocompromised patients), and the mortality rate remains significant despite appropriate therapy.
| Feature | Actinomyces | Nocardia |
|---|---|---|
| Oxygen requirement | Obligate anaerobe | Obligate aerobe |
| Acid-fast | Negative | Weakly positive |
| Source | Normal oral flora | Environmental (soil) |
| Host | Normal hosts (trauma/surgery) | Immunocompromised |
| Characteristic | Sulfur granules, sinus tracts | Pulmonary + CNS dissemination |
| Treatment | Penicillin | TMP-SMX |
Chapter 40: Gram-Negative Cocci
40.1 Neisseria
Gram-negative diplococci (kidney bean-shaped); oxidase-positive
Neisseria gonorrhoeae (Gonococcus)
Neisseria gonorrhoeae is a gram-negative diplococcus that causes gonorrhea, one of the most common sexually transmitted infections worldwide. The organism is exclusively a human pathogen-it infects only humans and has no animal reservoir. Understanding how gonococcal virulence factors function mechanistically explains both the clinical manifestations and the challenges of prevention and treatment.
Laboratory Identification: On Gram stain, gonococci appear as gram-negative diplococci that are often intracellular-seen within neutrophils. This intracellular location reflects both the organism’s ability to be phagocytosed and its remarkable ability to survive inside phagocytes. The organism is oxidase positive (like all Neisseria) and ferments glucose only-not maltose, lactose, or sucrose. This carbohydrate utilization pattern distinguishes it from N. meningitidis, which ferments both glucose and maltose. Gonococci are fastidious and require enriched media (chocolate agar) or selective media (Thayer-Martin, Martin-Lewis) containing antibiotics that suppress competing flora while allowing Neisseria growth.
Virulence Factors and Their Pathophysiological Mechanisms
The gonococcus has evolved a sophisticated arsenal of virulence factors that enable it to establish mucosal infection, evade immunity, and persist despite the inflammatory response it provokes.
Pili (Type IV pili)-The First Point of Contact: Gonococcal pili are hair-like protein appendages that extend from the bacterial surface and are essential for initial attachment to mucosal epithelium. Without pili, gonococci cannot establish infection. The pili bind to CD46 and other receptors on epithelial cells, anchoring the bacterium close enough to deploy additional adhesins.
But pili do something more remarkable: they undergo antigenic variation. The gonococcal genome contains one expressed pilin gene (pilE) and multiple silent pilin gene copies (pilS). Through recombination, portions of pilS genes can be copied into pilE, generating a new antigenic variant. A single strain can generate millions of different pilin variants. This variation allows the organism to escape antibody responses-by the time the host mounts effective anti-pilin antibodies, the bacterium has changed its coat.
Opa (Opacity) Proteins-Mediating Intimate Attachment and Invasion: Opa proteins are outer membrane proteins that mediate closer attachment to host cells and can promote cellular invasion. They’re named for their effect on colony morphology-Opa-expressing colonies appear opaque. Gonococci possess multiple opa genes, and each gene can independently switch on or off through phase variation-slipped-strand mispairing during replication changes the reading frame, turning protein expression on or off. This creates a population of bacteria with different combinations of Opa proteins expressed.
Different Opa proteins bind different host receptors. Some bind CEACAM (carcinoembryonic antigen-related cell adhesion molecule) receptors on epithelial cells, facilitating invasion. Some bind heparan sulfate proteoglycans. This repertoire allows the organism to adapt to different tissue niches and evade Opa-specific antibodies.
LOS (Lipooligosaccharide)-Endotoxin Without the O-Antigen: Gonococci produce lipooligosaccharide rather than the lipopolysaccharide of enteric bacteria-it lacks the repeating O-antigen polysaccharide. Like LPS, LOS has a lipid A component that activates innate immunity via TLR4, triggering the inflammatory response responsible for the purulent discharge characteristic of symptomatic gonorrhea. But LOS also undergoes phase variation and can be sialylated using host-derived CMP-NANA (cytidine monophosphate-N-acetylneuraminic acid). Sialylated LOS mimics host glycoconjugates and helps the organism resist complement-mediated killing.
IgA Protease-Disabling Mucosal Defense: The mucosal surfaces of the genital tract, pharynx, and rectum are protected by secretory IgA antibodies. Gonococci produce an IgA1 protease that cleaves human IgA1 antibodies at the hinge region, separating the antigen-binding Fab portions from the Fc portion needed for effector functions. This neutralizes mucosal antibody defenses at the site of infection.
Mechanisms of Iron Acquisition: Iron is essential for bacterial growth but is sequestered by host proteins (transferrin, lactoferrin, hemoglobin). Gonococci express surface receptors (TbpA/TbpB for transferrin, LbpA/LbpB for lactoferrin, HpuA/HpuB for hemoglobin-haptoglobin) that directly strip iron from these host proteins-a sophisticated system that reflects the organism’s adaptation to the iron-limited human environment.
Clinical Syndromes Reflect the Organism’s Mucosal Tropism
Urethritis in men is typically symptomatic-the inflammatory response to gonococcal infection produces purulent discharge and dysuria. Symptoms develop 2-5 days after exposure. The symptomatic nature of male urethritis means most men seek treatment, limiting transmission.
Cervicitis in women is often asymptomatic or causes only mild symptoms (discharge, bleeding), which is the crux of the public health problem. Unrecognized infection leads to ongoing transmission. More critically, untreated cervicitis can ascend to cause pelvic inflammatory disease (PID)-infection of the endometrium, fallopian tubes, and peritoneum. The inflammatory damage causes tubal scarring, leading to chronic pelvic pain, ectopic pregnancy, and infertility.
Pharyngeal and rectal gonorrhea are common among men who have sex with men and are usually asymptomatic, serving as hidden reservoirs for transmission.
Disseminated gonococcal infection (DGI) occurs in 0.5-3% of infections when gonococci enter the bloodstream. The classic triad is dermatitis (pustular skin lesions, often on the extremities), tenosynovitis (inflammation of tendon sheaths, producing “sausage fingers”), and migratory polyarthralgia. DGI can progress to septic arthritis, typically affecting a single large joint like the knee. Risk factors include complement deficiencies (especially terminal complement components C5-C9, which are needed for bactericidal activity against Neisseria), menstruation, and pregnancy.
Diagnosis and Treatment: NAAT (nucleic acid amplification testing) is the preferred diagnostic method-it’s highly sensitive and can be performed on urine or swabs, facilitating screening. Culture is essential when antimicrobial susceptibility testing is needed, which is increasingly important given resistance trends.
Treatment has become challenging due to antimicrobial resistance. Gonococci have progressively developed resistance to sulfonamides, penicillins, tetracyclines, and fluoroquinolones. Current CDC recommendations call for ceftriaxone 500 mg IM as single-dose therapy. Because coinfection with Chlamydia is common and Chlamydia is not detected by gonococcal cultures, empiric treatment for both infections (adding doxycycline or azithromycin) is standard practice.
Neisseria meningitidis (Meningococcus)
Neisseria meningitidis is one of the most feared bacterial pathogens because of its ability to cause fulminant disease in previously healthy people. A person can go from perfect health to death within 24 hours. Understanding the pathophysiology of meningococcal disease explains why it can be so devastating and why certain populations are at particular risk.
Laboratory Identification: Meningococci appear as gram-negative diplococci, morphologically indistinguishable from gonococci. The key laboratory distinction is carbohydrate fermentation: meningococci ferment both glucose AND maltose, while gonococci ferment glucose only. Like all Neisseria, meningococci are oxidase positive. Unlike gonococci, meningococci are encapsulated-the polysaccharide capsule is visible as a halo around diplococci on Gram stain and is essential for virulence.
Serogroups and Epidemiology: The capsular polysaccharide defines 13 serogroups, but five cause nearly all disease: A, B, C, W, and Y. The geographic distribution varies-serogroup A causes epidemics in the African “meningitis belt,” while B, C, and Y predominate in developed countries.
About 10% of the population carries N. meningitidis asymptomatically in the nasopharynx at any given time. Transmission is by respiratory droplets, requiring close contact. Carriage induces immunity to the colonizing strain but can lead to invasive disease during the initial colonization period before immunity develops. This explains why close contacts of cases (household members, military recruits sharing barracks, college students in dormitories) are at highest risk.
Virulence Factors and How They Cause Disease
The Polysaccharide Capsule-Essential for Bloodstream Survival: The capsule is absolutely essential for invasive disease. Unencapsulated strains can colonize the nasopharynx but cannot cause systemic infection. The capsule works by inhibiting complement-mediated killing and phagocytosis. The polysaccharide’s negative charge repels phagocytes, and the capsule prevents complement component C3b from depositing directly on the bacterial surface where it could promote opsonization or membrane attack complex formation.
This explains why patients with complement deficiencies-particularly deficiencies of the terminal complement components C5-C9 (which form the membrane attack complex)-are at dramatically increased risk of meningococcal disease. In these patients, even if complement is activated, they cannot form the pore-forming complex that directly kills gram-negative bacteria. Patients with properdin deficiency (an alternative pathway regulator) are also at high risk. Asplenic patients are vulnerable because the spleen is critical for clearing encapsulated bacteria that have resisted complement killing.
Lipooligosaccharide (LOS)-The Endotoxin That Drives Shock: Meningococcal LOS is among the most potent endotoxins known. When meningococci reach the bloodstream and are killed by immune defenses, they release massive amounts of LOS (also called endotoxin or lipid A). This LOS binds to TLR4 on macrophages and endothelial cells, triggering an explosive cytokine response-TNF-α, IL-1, IL-6, and others.
The consequences of this cytokine storm explain the clinical syndrome of meningococcemia. Vascular endothelium becomes “activated” and procoagulant. Capillary leak causes fluid extravasation and hypotension. Diffuse intravascular coagulation (DIC) develops, consuming clotting factors and platelets while depositing microthrombi throughout the circulation. The petechial rash that is the hallmark of meningococcal disease represents microvascular thrombosis and hemorrhage-platelets consumed by DIC can’t plug the small vessel leaks.
Purpura Fulminans-When DIC Becomes Visible: The most terrifying manifestation of meningococcemia is purpura fulminans-large, rapidly expanding areas of hemorrhagic necrosis of the skin and underlying tissue. These represent complete thrombotic occlusion of dermal blood vessels with subsequent tissue death. Purpura fulminans carries high mortality and, in survivors, often requires amputation of gangrenous extremities.
Waterhouse-Friderichsen Syndrome: Bilateral adrenal hemorrhage occurs in fulminant meningococcemia because the adrenal glands are particularly susceptible to hemorrhagic necrosis during DIC. The resulting acute adrenal insufficiency compounds the shock state. This is why glucocorticoid replacement is part of the treatment of suspected meningococcemia.
Pili and Adhesins-Initiating Colonization: Like gonococci, meningococci use Type IV pili for initial attachment to nasopharyngeal epithelium. The pili bind to CD46 on epithelial cells. Opa proteins provide additional attachment. Interestingly, meningococcal pili also undergo antigenic variation, though in a different pattern than gonococcal pili.
Clinical Syndromes
Meningococcal Meningitis presents with the classic triad of fever, headache, and neck stiffness, but may progress rapidly from initial symptoms to obtundation. The petechial/purpuric rash is a critical diagnostic clue-bacterial meningitis with a petechial rash is meningococcal until proven otherwise. CSF shows purulent findings (neutrophilic pleocytosis, high protein, low glucose), and Gram stain may show gram-negative diplococci.
Meningococcemia Without Meningitis can be even more fulminant-septic shock with DIC develops so rapidly that the patient may die before meningeal inflammation develops. The rash starts as petechiae (small, non-blanching spots) and can progress to purpura (larger hemorrhagic areas) and purpura fulminans within hours.
Diagnosis and Treatment: The rapidity of disease mandates empiric treatment on clinical suspicion. Blood cultures and CSF (if lumbar puncture is safe) should be obtained, but antibiotic therapy must not be delayed. Gram stain of CSF showing diplococci is rapid and specific. PCR can detect meningococcal DNA in CSF and blood.
Treatment is with high-dose penicillin or a third-generation cephalosporin (ceftriaxone). Dexamethasone as adjunctive therapy reduces neurological sequelae in bacterial meningitis.
Prevention
Vaccines: Meningococcal conjugate vaccines (MenACWY) contain capsular polysaccharides conjugated to protein carriers, making them immunogenic even in young children and inducing immunological memory. These are routinely recommended for adolescents at age 11-12 with a booster at 16. Serogroup B vaccines (MenB) use different technology-because the serogroup B polysaccharide resembles human neural antigens and is poorly immunogenic, MenB vaccines use outer membrane proteins as antigens.
Chemoprophylaxis for close contacts (household members, kissing contacts, daycare contacts, healthcare workers with direct respiratory exposure) eliminates nasopharyngeal carriage and prevents secondary cases. Options include rifampin (600 mg BID × 2 days), ciprofloxacin (single dose), or ceftriaxone (single dose).
Laboratory handling note: N. meningitidis is fragile outside the human host. CSF specimens should never be refrigerated-the organism dies rapidly in the cold. Specimens should be transported promptly to the laboratory at room temperature.
40.2 Moraxella catarrhalis
Moraxella catarrhalis was long considered a harmless commensal of the upper respiratory tract, but it’s now recognized as the third most common bacterial cause of otitis media and sinusitis in children (after S. pneumoniae and H. influenzae) and a significant cause of lower respiratory tract infections in adults with chronic lung disease. Understanding its niche in respiratory infections and its nearly universal β-lactamase production is important for appropriate empiric therapy.
Laboratory Identification: M. catarrhalis is a gram-negative diplococcus that morphologically resembles Neisseria-in fact, it was formerly classified in the Neisseria genus. Key identifying features include oxidase positivity, DNase positivity, and the distinctive “hockey puck” colonies that can be pushed intact across the agar surface (reflecting the cells’ tendency to adhere to each other rather than the agar). It grows well on blood and chocolate agar and does not require the special factors that Haemophilus needs.
Pathogenesis and Host-Pathogen Interaction
M. catarrhalis colonizes the nasopharynx, particularly in young children-colonization rates can exceed 50% in children under 2 years. The organism possesses several adherence factors that mediate attachment to respiratory epithelium, including outer membrane proteins (OMPs) like UspA1 and UspA2 that bind to epithelial cell receptors. These proteins also help the organism resist complement-mediated killing and may be targets for vaccine development.
Unlike the major respiratory pathogens S. pneumoniae and H. influenzae type b, M. catarrhalis is rarely invasive. It doesn’t have a polysaccharide capsule (though it has lipooligosaccharide in its outer membrane), and it lacks the virulence factors needed to survive in the bloodstream. Its pathogenicity is limited to the respiratory mucosa, where it acts as an opportunist-causing disease when local defenses are impaired by viral infection, allergy, or underlying lung disease.
Clinical Syndromes
Otitis media and sinusitis in children account for most M. catarrhalis disease. The organism is the third most common cause of acute otitis media, responsible for about 15-20% of cases. It tends to cause disease during winter months, often following viral upper respiratory infections that disrupt mucociliary function and promote bacterial overgrowth.
COPD exacerbations are triggered by M. catarrhalis in a significant proportion of cases. Patients with chronic bronchitis have altered airway defenses and chronic bacterial colonization; shifts in the colonizing population or acquisition of new strains can trigger acute exacerbations with increased sputum production, purulence, and dyspnea.
Pneumonia occurs primarily in elderly patients and those with underlying lung disease. It’s a community-acquired pathogen in these populations.
The β-Lactamase Problem-Why Ampicillin Doesn’t Work
The most clinically important feature of M. catarrhalis is that over 90% of strains (approaching 100% in many surveys) produce β-lactamase. This wasn’t always the case-β-lactamase production was rare until the 1970s but spread rapidly through the population, a classic example of antibiotic selection pressure driving resistance evolution.
The β-lactamases produced by M. catarrhalis are typically BRO-1 or BRO-2 enzymes. These efficiently hydrolyze penicillin and ampicillin, making these antibiotics useless. This is critically important for empiric therapy of otitis media and sinusitis, where M. catarrhalis is one of the common pathogens-amoxicillin alone will not cover M. catarrhalis.
Empiric treatment of suspected M. catarrhalis infections (or mixed infections where M. catarrhalis is a possible pathogen) should use antibiotics stable to these β-lactamases: amoxicillin-clavulanate, second- or third-generation cephalosporins (which are stable to this enzyme), or macrolides. The β-lactamase inhibitor clavulanate effectively neutralizes M. catarrhalis β-lactamase, making amoxicillin-clavulanate an excellent empiric choice for respiratory tract infections.
Chapter 41: Enterobacteriaceae (Enterobacterales)
The Enterobacteriaceae family includes many of the most important human pathogens-E. coli, Klebsiella, Salmonella, Shigella, and others. They share defining features that unify the family: gram-negative bacilli, facultative anaerobes, glucose fermenters, nitrate reducers, and oxidase negative. This last feature-oxidase negativity-is the single most useful test distinguishing Enterobacteriaceae from other gram-negative rods like Pseudomonas (oxidase positive).
On MacConkey agar, Enterobacteriaceae are divided by whether they ferment lactose. Lactose fermenters produce acid, turning the pH indicator pink/red. Non-fermenters remain colorless. This simple distinction immediately narrows the differential: lactose fermenters include E. coli, Klebsiella, and Enterobacter; non-fermenters include Salmonella, Shigella, and Proteus.
41.1 Lactose Fermenters
Escherichia coli
E. coli is simultaneously the most common commensal gram-negative bacterium in the human gut and one of the most important pathogens. This paradox reflects the fact that different strains have very different capabilities. The E. coli living harmlessly in your intestine lacks the virulence factors that make pathogenic strains dangerous.
E. coli causing disease outside the gut: Commensal E. coli becomes pathogenic when it escapes its normal niche. Urinary tract infections-the most common bacterial infection in humans-occur when fecal E. coli ascend the urethra to the bladder. E. coli accounts for 80-85% of uncomplicated community-acquired UTIs. The bacteria don’t need special virulence factors; they just need to reach a normally sterile site. In neonates, E. coli (particularly strains bearing the K1 polysaccharide capsule, which helps evade complement and cross the blood-brain barrier) is a leading cause of meningitis, transmitted during passage through the birth canal.
E. coli causing intestinal disease: Diarrheal disease requires acquisition of specific virulence factors-toxins, adhesins, or invasion machinery-that distinguish pathogenic strains. Understanding the different pathotypes explains the different clinical presentations.
Enterotoxigenic E. coli (ETEC) is the leading cause of traveler’s diarrhea. These strains produce heat-labile (LT) and heat-stable (ST) enterotoxins that act on intestinal epithelial cells without damaging them. LT is structurally and functionally similar to cholera toxin-it activates adenylate cyclase, raising intracellular cAMP, which opens chloride channels and causes massive fluid secretion. The result is profuse watery diarrhea without blood or inflammation. The patient is uncomfortable but not in danger; the infection resolves in a few days.
Enterohemorrhagic E. coli (EHEC) causes a completely different-and far more dangerous-disease. The prototype is E. coli O157:H7. These strains produce Shiga toxin (identical to the toxin made by Shigella dysenteriae), which inhibits protein synthesis by cleaving ribosomal RNA. The toxin particularly damages vascular endothelial cells. The initial presentation is bloody diarrhea-often so bloody it looks like pure blood. In about 5-10% of children (less often in adults), Shiga toxin damages glomerular capillary endothelium, triggering hemolytic uremic syndrome (HUS): microangiopathic hemolytic anemia, thrombocytopenia, and acute kidney injury.
The critical clinical point: when EHEC is suspected, do not give antibiotics. Antibiotics lyse bacteria, potentially releasing more toxin, and epidemiological studies associate antibiotic treatment with increased HUS risk. Management is supportive-hydration and monitoring for HUS.
Laboratory identification of EHEC exploits a metabolic quirk: O157:H7 doesn’t ferment sorbitol, so it produces colorless colonies on sorbitol-MacConkey agar while other E. coli produce pink colonies.
Klebsiella pneumoniae
Klebsiella pneumoniae is characterized by its thick polysaccharide capsule, which gives colonies a distinctive mucoid, glistening appearance and contributes to virulence by inhibiting phagocytosis. Understanding Klebsiella requires recognizing that it now exists in three clinical contexts: classic community-acquired infection, hypervirulent strains causing invasive disease, and highly resistant strains threatening healthcare.
Classic Klebsiella pneumonia: Historically, K. pneumoniae was known for causing a severe, necrotizing pneumonia in alcoholics and diabetics-patients with impaired neutrophil function. The classic description includes “currant jelly” sputum (bloody, mucoid) and upper lobe cavitation. While this presentation still occurs, it’s less common than Klebsiella’s role as a nosocomial pathogen causing pneumonia, UTI, and bloodstream infections in hospitalized patients.
Hypervirulent K. pneumoniae: In the 1980s, a distinct syndrome emerged in Asia: community-acquired pyogenic liver abscess in otherwise healthy patients, caused by Klebsiella strains with enhanced capsule production and other virulence factors. These hypervirulent strains are associated with metastatic infection-the bacteria seed from the liver abscess to the eyes (endophthalmitis, often causing blindness), CNS, or other sites. This syndrome is most common in patients of Asian descent and in diabetics.
Carbapenem-resistant K. pneumoniae (CRKP): Perhaps the most concerning development is the emergence of strains resistant to carbapenems-our “last-line” antibiotics for serious gram-negative infections. These strains produce carbapenemases, enzymes that hydrolyze virtually all beta-lactams. The most common in the United States is KPC (Klebsiella pneumoniae carbapenemase). Treatment options are severely limited-polymyxins (which have significant toxicity), tigecycline, and newer agents like ceftazidime-avibactam and meropenem-vaborbactam.
Enterobacter
Enterobacter species are opportunistic gram-negative pathogens that have become increasingly important causes of healthcare-associated infections. What makes Enterobacter particularly challenging is not its virulence-it’s relatively low-virulence compared to organisms like Pseudomonas-but its intrinsic resistance mechanism that can turn initial susceptibility into treatment failure. Understanding the molecular basis of this inducible resistance is essential for clinical practice.
Laboratory Identification: Enterobacter species are lactose fermenters, producing pink/red colonies on MacConkey agar. They are motile (unlike Klebsiella) and Voges-Proskauer positive (they produce acetoin from glucose metabolism-a feature useful for distinguishing them from similar Enterobacteriaceae). Multiple species exist, with E. cloacae and E. aerogenes (now reclassified as Klebsiella aerogenes) being the most clinically important.
Clinical Significance: Enterobacter causes healthcare-associated infections in hospitalized patients, particularly those who have received prior antibiotics, have indwelling devices, or are in the ICU. Common infections include ventilator-associated pneumonia, catheter-associated urinary tract infections, bloodstream infections (often from catheter or intra-abdominal sources), and wound infections. Enterobacter is not a particularly aggressive pathogen-it primarily infects patients whose defenses are already compromised.
The Inducible AmpC β-Lactamase-Why Cephalosporins Fail
The key to understanding Enterobacter is its chromosomal AmpC β-lactamase. All Enterobacter carry the ampC gene, which encodes a β-lactamase capable of hydrolyzing most cephalosporins and penicillins. The critical point is that this gene is inducible-under normal conditions, it’s expressed at low levels, and the organism may test susceptible to third-generation cephalosporins like ceftriaxone. But when exposed to certain β-lactams, ampC expression is induced to high levels, and resistance emerges.
The molecular mechanism: AmpC expression is regulated by a complex system involving the ampR regulator, AmpD (a cytoplasmic amidase), and AmpG (a permease). Normally, cell wall recycling products (muropeptides) are processed by AmpD, keeping AmpC expression low. When β-lactam antibiotics disrupt cell wall synthesis, the recycling pathway is overwhelmed, muropeptides accumulate, and they trigger AmpR to activate ampC transcription. The result is rapid β-lactamase production.
The clinical trap: A patient with Enterobacter bacteremia may have cultures showing susceptibility to ceftriaxone. The physician starts ceftriaxone, and the patient initially improves. But the antibiotic selects for constitutive AmpC overproducers (mutants that express AmpC at high levels even without induction-often through mutations in ampD). Within days, the patient relapses with now-resistant Enterobacter. This “emergence of resistance on therapy” occurs in up to 20% of patients treated with third-generation cephalosporins for Enterobacter infections.
The SPACE organisms: Enterobacter is one of the “SPACE” organisms-Serratia, Pseudomonas, Acinetobacter, Citrobacter (specifically C. freundii), and Enterobacter-all of which carry inducible AmpC β-lactamases and are at risk for the same phenomenon. The mnemonic helps remember which organisms should NOT be treated with third-generation cephalosporins even if they test susceptible.
Treatment Implications: Because of the risk of resistance emergence, Enterobacter infections should be treated with agents stable to AmpC:
- Carbapenems (meropenem, imipenem) are stable to AmpC and are first-line for serious Enterobacter infections
- Cefepime (fourth-generation cephalosporin) is relatively stable to AmpC and can be used, though resistance can still emerge
- Fluoroquinolones are not affected by β-lactamases but resistance is increasing
- Aminoglycosides can be used in combination
- Third-generation cephalosporins (ceftriaxone, ceftazidime) should be avoided even when tested susceptible
The Emerging Carbapenem Resistance Threat: Beyond AmpC, some Enterobacter strains have acquired carbapenemases-enzymes that hydrolyze even carbapenems. These carbapenem-resistant Enterobacter (CRE) strains are designated urgent threats by the CDC. When carbapenems fail, options become very limited: ceftazidime-avibactam, meropenem-vaborbactam, polymyxins, or tigecycline, depending on the specific resistance mechanism.
41.2 Non-Lactose Fermenters
MacConkey agar: Colorless colonies
Salmonella
Salmonella is divided into two distinct clinical categories that behave very differently: non-typhoidal Salmonella (NTS), which causes gastroenteritis that stays in the gut, and typhoidal Salmonella (S. Typhi and S. Paratyphi), which causes a systemic illness. Understanding the pathogenesis explains this clinical divergence.
Non-typhoidal Salmonella gastroenteritis: More than 2,500 NTS serotypes exist, and they cause one of the most common foodborne infections. The bacteria are acquired from contaminated poultry, eggs, or produce, or from reptile pets (turtles, lizards, snakes harbor Salmonella). After ingestion, Salmonella invades the intestinal epithelium, triggering an inflammatory response with neutrophil recruitment. The result is an inflammatory diarrhea-watery to bloody, with fever, cramps, and nausea-typically 12-72 hours after exposure.
In immunocompetent patients, NTS gastroenteritis is self-limited. Antibiotics don’t shorten illness and may prolong bacterial shedding, so they’re generally not indicated. However, in immunocompromised patients, those at extremes of age, or those with structural abnormalities like sickle cell disease, NTS can escape the gut and cause bacteremia and metastatic infection. Patients with sickle cell disease are particularly prone to Salmonella osteomyelitis-the sickled RBCs infarct bone, creating a niche for bacterial seeding.
Typhoid fever: S. Typhi is a fundamentally different pathogen. Instead of causing localized intestinal inflammation, it invades the gut silently, penetrates to lymph nodes, enters the bloodstream, and disseminates to the liver, spleen, and bone marrow. The clinical presentation reflects this systemic infection: step-wise rising fever over days, relative bradycardia (pulse lower than expected for the fever), hepatosplenomegaly, and rose spots-faint salmon-colored macules on the abdomen. Counterintuitively, constipation is more common than diarrhea in the first week.
The danger of typhoid comes from the location of bacteria: they replicate in Peyer’s patches in the intestinal wall. As these patches swell and necrose, they can perforate or hemorrhage-life-threatening complications that occur in the third week if untreated.
Chronic carriage occurs in about 1-5% of patients. Bacteria persist in the gallbladder, shed intermittently in stool. The most famous carrier was “Typhoid Mary,” a cook who infected dozens before public health authorities forcibly isolated her.
Laboratory identification: Salmonella doesn’t ferment lactose (colorless on MacConkey) and produces H2S (black centers on Hektoen and XLD agars). Blood culture is key for typhoid diagnosis; bone marrow culture is even more sensitive and remains positive even after antibiotics are started.
Shigella
Shigella causes bacillary dysentery-bloody diarrhea with mucus, fever, and painful straining (tenesmus). Understanding Shigella’s pathogenesis explains why so few organisms cause disease and why the disease is so locally destructive.
The most infectious bacterial pathogen: The infectious dose for Shigella is remarkably low-as few as 10-100 organisms can cause disease, compared to millions required for Salmonella or Vibrio. This explains why Shigella spreads so efficiently person-to-person, particularly in settings with poor sanitation, daycare centers, and institutions.
Invasion without dissemination: Shigella’s strategy is invasion of the colonic epithelium. The bacteria are taken up by M cells, escape into the lamina propria, are engulfed by macrophages, and then induce apoptosis to escape. They enter colonic epithelial cells from the basolateral side and use actin-based motility (like Listeria) to spread from cell to cell. This invasion destroys the epithelium, causing ulceration, bleeding, and the characteristic bloody mucoid stool. Unlike Salmonella typhi, Shigella almost never disseminates to the bloodstream-the disease remains localized to the colon.
Shiga toxin: S. dysenteriae type 1 produces Shiga toxin, which inhibits protein synthesis by cleaving ribosomal RNA. This toxin can cause hemolytic uremic syndrome through the same mechanism as EHEC. The other Shigella species don’t produce this toxin, which is why S. dysenteriae causes the most severe disease.
The four species: S. dysenteriae (group A) is most virulent but uncommon. S. flexneri (group B) predominates in developing countries. S. boydii (group C) is rare. S. sonnei (group D) is most common in developed countries and causes milder disease.
Laboratory identification: Shigella doesn’t ferment lactose and doesn’t produce H2S (distinguishing it from Salmonella). It’s also non-motile (Salmonella is motile).
Complications: - HUS (S. dysenteriae type 1) - Post-infectious reactive arthritis (HLA-B27 associated)
Proteus
Proteus species are non-lactose fermenters notable for two distinctive laboratory features: swarming motility and powerful urease production. Both have clinical relevance.
Swarming motility is impossible to miss-on blood agar, Proteus colonies spread in successive waves, eventually covering the entire plate. This occurs because Proteus alternates between short swimmer cells (in liquid) and elongated, hyperflagellated swarmer cells (on solid surfaces). The swarming creates concentric rings of growth that can obscure other organisms on mixed culture plates.
Urease and stone formation: Proteus produces the most potent urease of any bacterium. This enzyme splits urea into ammonia and CO2, alkalinizing the urine. When the pH rises above 7, magnesium ammonium phosphate (struvite) precipitates, forming stones. Proteus is the classic cause of “struvite” or “infection stones”-large, branching calculi called “staghorn calculi” because they fill the renal pelvis and calyces like antlers. These stones harbor bacteria within their matrix, making eradication impossible without surgical removal.
Clinical infections: Proteus primarily causes urinary tract infections, particularly in catheterized patients. It also causes wound infections and can cause bacteremia. P. mirabilis is the most common species and is indole-negative; P. vulgaris is indole-positive and generally more resistant.
Yersinia
The genus Yersinia includes two pathogens of vastly different importance: Y. enterocolitica, a cause of self-limited gastroenteritis, and Y. pestis, the cause of plague, one of history’s great killers.
Yersinia enterocolitica causes a febrile diarrheal illness that can mimic appendicitis because of prominent mesenteric lymphadenopathy and right lower quadrant pain. This has led to unnecessary appendectomies. The organism has an unusual ability to grow at refrigerator temperatures (4°C), which is useful for cold enrichment culture but concerning for blood transfusion-Y. enterocolitica can multiply in refrigerated blood products and cause fatal transfusion-associated sepsis.
Yersinia pestis caused the Black Death of the 14th century, which killed one-third of Europe’s population, and has caused at least two other pandemics. Plague persists today in wild rodent populations worldwide, including the American Southwest.
Bubonic plague, the classic form, results from a flea bite. The flea feeds on an infected rodent, and Y. pestis multiplies in the flea’s gut, eventually blocking it. The starving flea bites repeatedly, regurgitating bacteria into each bite wound. At the bite site, bacteria travel to regional lymph nodes, which swell massively and become necrotic-these are the buboes (from Greek for groin, their most common location). Without treatment, bacteria spread to the blood (septicemic plague) and can seed the lungs (pneumonic plague). Pneumonic plague is directly transmissible person-to-person and was responsible for the most devastating outbreaks.
Y. pestis is a CDC select agent and tier 1 biothreat pathogen. Laboratory protocols reflect these biosafety concerns.
Serratia marcescens
Serratia is a nosocomial pathogen that first came to attention because of a striking feature: some strains produce a bright red pigment called prodigiosin. This pigment made Serratia useful as a marker organism in the pre-antibiotic era-the red color made it easy to trace. The organism was once considered nonpathogenic and was even used in biowarfare dispersal experiments. We now know it causes serious hospital-acquired infections.
Clinical significance: Serratia causes pneumonia (especially ventilator-associated), urinary tract infections, wound infections, and bacteremia, primarily in hospitalized patients. It’s been implicated in outbreaks traced to contaminated solutions, medications, and equipment-including multi-dose saline vials and intravenous fluids.
Laboratory identification: Serratia is a non-lactose fermenter, though some strains ferment lactose slowly. The red pigment is helpful when present, but many clinical strains are non-pigmented. DNase positivity helps distinguish it from other Enterobacteriaceae.
Chapter 42: Non-Fermentative Gram-Negative Bacilli
The non-fermenters are a metabolically distinct group of gram-negative bacilli that cannot ferment glucose-they either oxidize it or are metabolically inert. This metabolic limitation reflects their environmental origins: they’re water and soil organisms, not adapted to the nutrient-rich mammalian gut. But in hospitals-with their artificial airways, catheters, and immunocompromised patients-these organisms have found a niche. They’re now among the most important causes of healthcare-associated infections, and their intrinsic and acquired resistance makes them therapeutic nightmares.
42.1 Pseudomonas aeruginosa
Pseudomonas aeruginosa is the quintessential opportunistic pathogen. In healthy people, it causes only trivial infections-swimmer’s ear, hot tub folliculitis. But in hospitalized patients, particularly those who are immunocompromised, mechanically ventilated, or catheterized, it causes serious, often fatal infections. The organism’s intrinsic resistance to many antibiotics, combined with its ability to rapidly acquire additional resistance mechanisms, makes every Pseudomonas infection a therapeutic challenge.
The laboratory gives immediate clues: P. aeruginosa is oxidase-positive-a drop of oxidase reagent on a colony turns purple within seconds. This single test distinguishes it from the Enterobacteriaceae, which are oxidase-negative. The organism produces a distinctive grape-like or corn tortilla-like odor, often noticed before the plate is even opened. Colonies frequently show blue-green pigmentation from pyocyanin (a blue phenazine) and pyoverdin (a green-yellow fluorescent siderophore). Not all strains are pigmented, but when present, the color is diagnostic.
Why Pseudomonas is so dangerous: This organism is armed with an array of virulence factors that explain its pathogenicity. Exotoxin A, like diphtheria toxin, ADP-ribosylates elongation factor 2, blocking protein synthesis and killing host cells. A type III secretion system acts like a molecular syringe, injecting toxins directly into host cells. Biofilm formation allows Pseudomonas to coat catheters, ventilator tubing, and damaged airways with a protected bacterial community that resists both antibiotics and immune defenses.
In cystic fibrosis patients, Pseudomonas undergoes a phenotypic switch, producing abundant alginate that forms a mucoid capsule. This mucoid phenotype signals a transition to chronic colonization-the organism becomes nearly impossible to eradicate and drives the progressive lung destruction that kills most CF patients.
Clinical syndromes reflect the settings where Pseudomonas thrives: Ventilator-associated pneumonia is a major concern in ICUs-Pseudomonas colonizes ventilator circuits and causes aggressive pneumonia. Catheter-associated UTIs and catheter-related bloodstream infections occur when urinary and vascular catheters are colonized. Burn wound infections can be devastating-Pseudomonas produces proteases and phospholipases that liquefy burned tissue. In neutropenic patients, Pseudomonas bacteremia may produce ecthyma gangrenosum-necrotic skin lesions with a black eschar that result from vascular invasion.
Malignant otitis externa deserves special mention. What begins as swimmer’s ear in a diabetic patient can become an invasive infection that spreads through cartilage and bone to involve the skull base, cranial nerves, and brain. The term “malignant” doesn’t mean cancer-it means aggressive and life-threatening.
Antibiotic selection is limited by intrinsic and acquired resistance: Pseudomonas is intrinsically resistant to many antibiotics including ampicillin, first- and second-generation cephalosporins, and most tetracyclines. Treatment requires “anti-pseudomonal” agents: piperacillin-tazobactam, ceftazidime, cefepime, carbapenems (except ertapenem), aminoglycosides, and fluoroquinolones. For serious infections, combination therapy is often used both for synergy and to prevent emergence of resistance-Pseudomonas can become resistant to any single agent during the course of therapy.
42.2 Acinetobacter baumannii
Acinetobacter has emerged as a global threat, particularly in intensive care units and military hospitals. The organism first gained notoriety during the Iraq and Afghanistan wars, when wounded soldiers developed infections with pan-resistant strains dubbed “Iraqibacter.” But Acinetobacter is now a worldwide problem, one of the most difficult hospital-acquired pathogens to treat.
What makes Acinetobacter dangerous isn’t virulence-it’s resistance and persistence: Compared to Pseudomonas, Acinetobacter is not particularly virulent. It primarily infects patients who are already critically ill. But it possesses two features that make it a hospital nightmare. First, it can acquire resistance genes with remarkable efficiency, and many strains are now resistant to virtually all conventional antibiotics. Second, it survives on dry surfaces for weeks to months, contaminating equipment and hands and spreading inexorably through ICUs.
Laboratory identification: Acinetobacter is a gram-negative coccobacillus-the cells are plump and round, sometimes mistaken for gram-positive cocci. Unlike Pseudomonas, Acinetobacter is oxidase-negative. It’s also a non-fermenter.
Treatment of MDR Acinetobacter has become an exercise in desperation. When carbapenems fail, options dwindle to toxic agents like polymyxins (colistin) and tigecycline, or newer agents like cefiderocol. Infection control-hand hygiene, environmental cleaning, contact precautions-is essential to prevent spread, because once Acinetobacter establishes itself in an ICU, eradication is extremely difficult.
42.3 Stenotrophomonas maltophilia
Stenotrophomonas occupies a peculiar niche: it’s inherently resistant to carbapenems, the antibiotics of last resort for many gram-negative infections. This resistance, conferred by chromosomal metallo-β-lactamases, means that the broad-spectrum carbapenem therapy used for severe hospital-acquired infections actually selects for Stenotrophomonas.
Clinical significance: Stenotrophomonas causes nosocomial pneumonia and bacteremia, primarily in immunocompromised patients and those with prolonged ICU stays. It’s increasingly recognized as a pathogen in cystic fibrosis patients. The irony is that the patients most likely to receive carbapenem therapy-those with resistant gram-negative infections-are the same patients likely to develop Stenotrophomonas superinfection.
Treatment paradox: Because of carbapenem resistance, the treatment of choice is trimethoprim-sulfamethoxazole-an old, inexpensive drug that remains reliably active. Fluoroquinolones are alternatives. This is one of the few gram-negative infections where knowing the organism immediately changes therapy away from carbapenems rather than toward them.
Treatment: TMP-SMX is first-line; fluoroquinolones, minocycline, ceftazidime-avibactam
42.4 Burkholderia cepacia Complex
Burkholderia cepacia complex (Bcc) occupies a unique and feared position in the world of cystic fibrosis-it’s an organism that can transform a stable CF patient into a critically ill one within weeks, and its ability to spread from patient to patient has led to strict infection control measures that have fundamentally changed CF care. Understanding why Bcc is so dangerous in CF patients, while being a relatively minor pathogen elsewhere, requires understanding both the organism’s characteristics and the unique CF airway environment.
Laboratory Identification: Bcc organisms are gram-negative bacilli that are oxidase positive (distinguishing them from Enterobacteriaceae) but require selective media for isolation from respiratory specimens because they grow slowly and are easily overgrown by other bacteria. BCSA (Burkholderia cepacia selective agar) contains antibiotics that suppress Pseudomonas and other organisms while allowing Bcc to grow. Importantly, “Burkholderia cepacia complex” is not a single species but a group of at least 20 closely related species (genomovars), with B. cenocepacia and B. multivorans being the most clinically important in CF.
Why Bcc Is a Cystic Fibrosis Pathogen
The CF lung provides an environment ideally suited for Bcc colonization. The thick, dehydrated mucus, chronic inflammation, and damaged epithelium create a niche where Bcc can establish itself. The organism possesses multiple features that enable it to thrive:
Metabolic versatility: Bcc can utilize an extraordinarily wide range of carbon sources, including compounds that are toxic to other bacteria. This metabolic flexibility allows it to survive in nutrient-poor environments and to persist in contaminated solutions (this property has caused outbreaks from contaminated antiseptics and nebulizer solutions).
Biofilm formation: Like Pseudomonas, Bcc forms robust biofilms in the CF airway. Within these biofilms, bacteria are protected from antibiotics and immune defenses.
Intrinsic antibiotic resistance: Bcc is naturally resistant to many antibiotics, including aminoglycosides and-critically-the polymyxins (colistin). This last point is significant because colistin is the inhaled antibiotic commonly used to suppress Pseudomonas in CF; it has no activity against Bcc. The mechanisms of intrinsic resistance include altered LPS structure (making colistin unable to bind), efflux pumps, and β-lactamases.
Cepacia Syndrome-The Nightmare Scenario
While many CF patients with Bcc have a chronic colonization pattern similar to Pseudomonas, a subset develop “cepacia syndrome”-a fulminant, often fatal illness. The patient rapidly develops necrotizing pneumonia, bacteremia, and septic shock. The clinical deterioration can occur over days to weeks. Even with aggressive treatment, mortality approaches 100% in severe cases. The mechanism is not fully understood, but it appears to involve a switch from chronic colonization to invasive disease, possibly triggered by host immunologic factors or bacterial quorum sensing signals.
Cepacia syndrome occurs predominantly with certain genomovars, particularly B. cenocepacia, which has epidemiologic markers associated with transmissibility and virulence.
Person-to-Person Transmission-Why Infection Control Matters
Bcc can spread directly from CF patient to CF patient through respiratory droplets or fomites. This was demonstrated dramatically in the 1990s when certain epidemic strains spread through CF clinics, causing outbreaks of colonization and death. This epidemiological pattern is different from Pseudomonas, which is primarily acquired from the environment rather than from other patients.
The transmission risk has led to strict infection control policies in CF care: - CF patients with Bcc are segregated from other CF patients - Separate clinic times or rooms are used for Bcc-positive patients - Many CF centers maintain lists of patients’ Bcc status - Social contact between CF patients (including attendance at CF camp or support groups) is now discouraged
These measures have reduced transmission but have also created social isolation for Bcc-positive CF patients-a reminder that infection control policies have human costs as well as benefits.
Treatment Challenges: Because of intrinsic resistance, treatment options are limited and must be guided by susceptibility testing. Combinations of antibiotics are typically required. Agents that may have activity include TMP-SMX, minocycline, meropenem (some strains), and ceftazidime (some strains), but resistance is common and unpredictable. Lung transplantation for CF patients with Bcc has historically been controversial because of concerns about post-transplant outcomes, though approaches vary by center and species.
Beyond CF: Bcc can occasionally cause infection in non-CF patients, particularly hospitalized patients with indwelling catheters or immune compromise. Outbreaks have occurred from contaminated solutions, including antiseptics (chlorhexidine) and nebulizer solutions, reflecting the organism’s ability to survive in these environments.
Chapter 43: Fastidious Gram-Negative Bacilli
43.1 Haemophilus influenzae
Haemophilus influenzae is a small gram-negative coccobacillus that causes two distinct patterns of disease depending on whether the strain is encapsulated. Understanding this distinction is critical: encapsulated strains (particularly serotype b) cause invasive disease, while non-encapsulated (nontypeable) strains cause mucosal infections. The Hib vaccine represents one of the great triumphs of vaccinology, virtually eliminating what was once the leading cause of bacterial meningitis in children.
Laboratory Identification and Growth Requirements
The name Haemophilus means “blood-loving,” reflecting the organism’s unusual nutritional requirements. H. influenzae requires two growth factors present in blood: X factor (hemin, an iron-containing porphyrin) and V factor (NAD/NADP). Regular blood agar contains both factors, but the V factor is sequestered inside intact red blood cells and is also destroyed by NADases released when the cells lyse. Therefore, H. influenzae will NOT grow on standard blood agar.
Chocolate agar supports growth because the heating process (which turns the agar brown) lyses the red cells, releases the V factor, and inactivates the NADases. This is why chocolate agar is essential for Haemophilus isolation.
Satelliting is a classic phenomenon demonstrating the V factor requirement. When H. influenzae is grown on blood agar alongside a streak of Staphylococcus aureus, colonies appear only immediately adjacent to the S. aureus streak. This occurs because S. aureus lyses red cells and releases V factor into its immediate environment. This “satellite” growth pattern is pathognomonic.
The Critical Distinction: Encapsulated vs. Nontypeable
H. influenzae strains fall into two categories with completely different clinical behavior.
Encapsulated strains possess a polysaccharide capsule that is the major virulence factor for invasive disease. Six capsular serotypes exist (a through f), but serotype b (Hib) is by far the most important human pathogen-it caused over 95% of invasive Haemophilus disease in the pre-vaccine era.
The type b capsule consists of polyribosyl ribitol phosphate (PRP), a polymer of ribose, ribitol, and phosphate. This capsule works like the capsules of pneumococcus and meningococcus-it inhibits complement deposition and phagocytosis, allowing the bacteria to survive in the bloodstream and cause invasive disease. The reason type b is so much more virulent than other serotypes is not fully understood but likely relates to the specific structure of PRP and its interactions with host immunity.
Nontypeable H. influenzae (NTHi) strains lack capsules and cannot cause invasive disease in immunocompetent hosts-they cannot survive in the bloodstream. However, they are highly adapted for mucosal colonization and infection. They possess surface adhesins (proteins that bind to respiratory epithelial cells), form biofilms, and produce IgA protease to evade mucosal immunity. NTHi causes otitis media, sinusitis, bronchitis, and pneumonia-all mucosal infections.
Pathogenesis of Invasive Hib Disease
Before the Hib vaccine, invasive H. influenzae type b disease was devastating. The organism colonized the nasopharynx, and in some children-particularly those under 5 whose immune systems couldn’t mount an effective antibody response to polysaccharide antigens-the bacteria invaded the bloodstream.
Meningitis was the most feared complication. Hib was the leading cause of bacterial meningitis in children aged 6 months to 3 years. The bacteria crossed from the bloodstream into the CSF, where the inflammatory response caused neurological damage. Mortality was 5%, and 25-35% of survivors had permanent sequelae including deafness, developmental delay, and seizure disorders.
Epiglottitis is a life-threatening emergency where the epiglottis becomes infected, swollen, and inflamed. The swelling can completely obstruct the airway within hours. Classic presentation is a toxic-appearing child sitting forward, drooling (unable to swallow secretions), with stridor and a muffled “hot potato” voice. Direct visualization shows a “cherry red” swollen epiglottis. The critical point: do NOT attempt to examine the throat or lay the child down-this can trigger complete airway obstruction. Secure the airway first.
Other invasive Hib diseases included pneumonia, septic arthritis (especially of large joints), facial cellulitis (often associated with sinusitis), and bacteremia.
The Hib Vaccine-A Triumph of Conjugate Technology
The Hib conjugate vaccine transformed pediatric infectious disease. Before the vaccine (introduced in the late 1980s), H. influenzae type b caused approximately 20,000 cases of invasive disease annually in the United States, primarily meningitis. Today, invasive Hib disease is rare.
The vaccine works by conjugating the PRP capsular polysaccharide to a protein carrier (diphtheria toxoid, tetanus toxoid, or meningococcal outer membrane protein, depending on the vaccine). This conjugation is essential because pure polysaccharide antigens are T-cell-independent antigens-they can stimulate B cells to produce antibodies, but they don’t induce immunological memory and don’t work in children under 2 (whose immune systems can’t respond well to polysaccharides alone). By attaching the polysaccharide to a protein, the vaccine converts it to a T-cell-dependent antigen, enabling robust, durable immunity even in infants.
NTHi Disease-Common but Not Invasive
While Hib disease has essentially disappeared, nontypeable H. influenzae remains a major cause of mucosal respiratory infections.
Otitis media (middle ear infection) is the most common reason for antibiotic prescriptions in children, and NTHi is one of the top three causes (along with S. pneumoniae and M. catarrhalis). The organism ascends the Eustachian tube from the nasopharynx to the middle ear.
Sinusitis occurs by the same mechanism-NTHi colonizing the nasopharynx can ascend to the sinuses, particularly when viral upper respiratory infections impair mucociliary clearance.
COPD exacerbations are commonly triggered by NTHi. Patients with chronic bronchitis and emphysema have damaged airways with impaired defenses, allowing NTHi (which colonizes the lower airways in COPD) to proliferate and cause acute infectious exacerbations.
Antibiotic Resistance: Approximately 30-40% of H. influenzae strains produce β-lactamase, rendering them resistant to ampicillin and amoxicillin. The β-lactamase is typically a TEM-type enzyme. For this reason, empiric treatment of suspected H. influenzae infections often includes a β-lactamase inhibitor (amoxicillin-clavulanate) or a cephalosporin (which is stable to this β-lactamase).
43.2 Legionella pneumophila
Legionella causes Legionnaires’ disease, a severe pneumonia that emerged dramatically in 1976 when 221 attendees of an American Legion convention in Philadelphia developed pneumonia and 34 died. The investigation led to discovery of a new bacterium-Legionella pneumophila-living in the hotel’s air conditioning system.
An environmental organism with unusual nutritional needs: Legionella lives naturally in freshwater environments, where it parasitizes amoebae. This intracellular lifestyle in amoebae pre-adapted it to survive inside human macrophages. In built environments, Legionella colonizes water systems-cooling towers, hot tubs, hospital water supplies, decorative fountains-and is transmitted when people inhale contaminated aerosols.
Legionella won’t grow on routine media because it has unusual nutritional requirements-it needs L-cysteine and iron supplementation. BCYE (buffered charcoal yeast extract) agar meets these requirements. The charcoal also absorbs toxic substances. If you suspect Legionella, you must specifically request BCYE culture-otherwise the laboratory won’t set it up and you’ll miss the diagnosis.
Clinical presentation: Legionnaires’ disease is an “atypical” pneumonia-meaning it presents differently from typical bacterial pneumonia. Patients have high fever, nonproductive cough, and often prominent extrapulmonary symptoms: diarrhea, confusion, and hyponatremia (SIADH). The chest X-ray shows consolidation that may be multilobar and progress rapidly. The Gram stain of sputum shows abundant neutrophils but no organisms-the bacteria stain faintly and are intracellular.
Pontiac fever is a milder, self-limited syndrome-flu-like illness without pneumonia-caused by the same organism but through a different (unclear) mechanism.
Diagnosis: The urine antigen test revolutionized Legionella diagnosis-it’s rapid and specific. The limitation is that it detects only serogroup 1, which accounts for about 70-80% of cases. Culture on BCYE remains the gold standard because it detects all serogroups, but it’s slower. PCR is increasingly available.
Treatment: Because Legionella lives inside macrophages, beta-lactam antibiotics are ineffective-they can’t reach intracellular bacteria. Treatment requires antibiotics that penetrate cells: fluoroquinolones (levofloxacin) or macrolides (azithromycin).
43.3 Bordetella pertussis
Pertussis-whooping cough-remains a significant cause of morbidity despite vaccination. The disease is particularly dangerous in infants too young to be vaccinated, which is why immunizing pregnant women in the third trimester has become standard practice.
Pathogenesis explains the clinical syndrome: Bordetella pertussis attaches to ciliated respiratory epithelium using adhesins like filamentous hemagglutinin. It doesn’t invade tissue-the bacteria remain on the surface. Instead, it produces a suite of toxins that cause local damage and systemic effects.
Tracheal cytotoxin destroys ciliated epithelial cells, eliminating the mucociliary escalator that normally clears debris and bacteria from the airways. With cilia gone, mucus accumulates and triggers the paroxysmal cough that defines the disease.
Pertussis toxin has systemic effects. It ADP-ribosylates inhibitory G proteins (Gi), locking them in an inactive state. This has multiple consequences: lymphocytes can’t respond to signals that normally keep them in lymph nodes, so they accumulate in the blood (lymphocytosis-often striking, with counts exceeding 20,000-50,000/μL). Islet cells lose inhibitory regulation, contributing to hypoglycemia in severe cases.
The classic three stages: The illness begins with the catarrhal stage-1-2 weeks of what seems like an ordinary upper respiratory infection with runny nose, mild cough, and low-grade fever. This is when patients are most contagious but least likely to be diagnosed.
The paroxysmal stage follows-2-4 weeks of characteristic coughing fits. Paroxysms consist of rapid, consecutive coughs followed by a forceful inspiration that produces the “whoop” (caused by air rushing through a narrowed glottis). Patients may turn red or blue, and paroxysms often end with vomiting or exhaustion. Between paroxysms, patients may appear well.
The convalescent stage brings gradual improvement over weeks to months-hence the Chinese name “hundred-day cough.”
The danger to infants: Infants may not whoop-their airways are too small to generate the sound. Instead, they may simply stop breathing (apnea) during coughing paroxysms. Most pertussis deaths occur in infants under 3 months, before they can complete their primary vaccine series.
Diagnosis: PCR of a nasopharyngeal swab or aspirate is the most sensitive test and has replaced culture in most settings. Culture on specialized media (Regan-Lowe or Bordet-Gengou) is specific but insensitive-the organism is fastidious and slow-growing, and culture sensitivity drops dramatically after the first two weeks of illness or after antibiotic treatment.
Prevention: The whole-cell pertussis vaccine was highly effective but caused frequent adverse reactions. The acellular vaccines now in use (DTaP, Tdap) are better tolerated but provide less durable immunity, which is why pertussis has resurged even in vaccinated populations. Vaccinating pregnant women in the third trimester allows antibodies to cross the placenta and protect newborns until they can be vaccinated themselves.
43.4 HACEK Organisms
The HACEK group is a collection of fastidious gram-negative bacteria that share an important clinical association: they cause infective endocarditis, often presenting as “culture-negative” endocarditis because they grow slowly or not at all on routine culture media.
The acronym HACEK stands for: Haemophilus species (particularly H. parainfluenzae and H. aphrophilus), Aggregatibacter (formerly classified as Actinobacillus and some Haemophilus), Cardiobacterium hominis, Eikenella corrodens, and Kingella kingae. These organisms are part of the normal oropharyngeal flora, and endocarditis occurs when they gain access to the bloodstream-often after dental procedures or in patients with pre-existing valve disease.
Why “culture-negative”? HACEK organisms grow slowly and require CO2-enriched atmosphere and/or extended incubation. If the laboratory processes blood cultures using standard 5-day protocols without appropriate conditions, these organisms may be missed. When endocarditis is suspected and initial cultures are negative, the laboratory should be alerted to hold and extend cultures to 2-3 weeks.
Kingella kingae deserves special mention as an increasingly recognized cause of pediatric bone and joint infections. It colonizes the respiratory tract of young children and can cause septic arthritis and osteomyelitis, particularly in children under 4 years. Improved culture techniques and molecular methods have revealed it to be much more common than previously recognized.
Treatment: HACEK organisms are generally susceptible to third-generation cephalosporins (ceftriaxone) and fluoroquinolones. Ampicillin-sulbactam is an alternative.
43.5 Other Fastidious Gram-Negative Bacteria
Brucella Species
Brucellosis is one of the most common zoonotic infections worldwide, though it’s rare in countries with pasteurized dairy and effective livestock control programs. The organism is a small gram-negative coccobacillus that’s notoriously difficult to grow and highly infectious to laboratory workers.
Transmission and pathogenesis: Humans acquire Brucella from infected animals-cattle (B. abortus), pigs (B. suis), goats/sheep (B. melitensis), and dogs (B. canis). Infection occurs through consumption of unpasteurized dairy products, direct contact with animal tissues or secretions (farmers, veterinarians, slaughterhouse workers), or inhalation of aerosols. The organism is a facultative intracellular pathogen that survives within macrophages, explaining why chronic infection is common and treatment requires prolonged combination therapy.
Clinical features: The classic presentation is “undulant fever”-a febrile illness with sweats, fatigue, weight loss, and generalized aching that can wax and wane for months if untreated. Hepatosplenomegaly is common. Complications include sacroiliitis (a classic association), vertebral osteomyelitis, and endocarditis.
Laboratory considerations: Brucella is a BSL-3 pathogen-laboratory-acquired infections are common, and laboratories must be notified when brucellosis is suspected. The organism grows slowly (7-21 days), so cultures must be held. Serologic diagnosis is an alternative.
Francisella tularensis
Francisella causes tularemia, a zoonotic infection acquired from rabbits, rodents, and arthropod bites. It’s one of the most infectious bacteria known-as few as 10 organisms can cause disease-and is classified as a potential bioterrorism agent.
Routes of infection determine clinical presentation: Ulceroglandular tularemia, the most common form, follows a tick or deer fly bite or handling of infected animals. A papule at the inoculation site ulcerates, and regional lymph nodes become massively enlarged and tender. Pneumonic tularemia follows inhalation-either from laboratory exposure, mowing over infected animal carcasses, or intentional release. This form is highly lethal.
Laboratory safety: Like Brucella, Francisella is a BSL-3 pathogen. Laboratory workers have become infected simply by sniffing culture plates. The laboratory must be warned when tularemia is suspected.
Pasteurella multocida
Pasteurella is the organism to think of when someone presents with a rapidly progressive wound infection after a cat or dog bite. Cats are the classic source-their long, sharp teeth inoculate bacteria deep into tissue, and their mouths harbor high concentrations of Pasteurella.
The clinical picture is distinctive: Within 24 hours of a bite-often much faster-the wound becomes red, swollen, and extremely painful. Purulent discharge may develop. Because the infection progresses so rapidly, patients often seek care within a day of the bite.
Treatment: Pasteurella remains susceptible to penicillin, and amoxicillin-clavulanate is the standard choice for animal bite wounds (covering Pasteurella plus oral anaerobes and streptococci). Fluoroquinolones are alternatives for penicillin-allergic patients.
Bartonella henselae (Cat Scratch Disease)
Bartonella henselae causes cat scratch disease, one of the most common causes of chronic lymphadenopathy in children and young adults. The organism is transmitted by cat scratches or bites, with kittens being the most common source (they have higher levels of bacteremia than adult cats). Cat fleas maintain the organism in cat populations.
The typical course: A papule or pustule develops at the scratch site within days. Weeks later-often after the initial lesion has healed-regional lymph nodes draining the scratch site become enlarged and tender. Axillary and epitrochlear nodes are common (scratches on arms), as are cervical nodes (scratches on face). The lymphadenopathy can persist for months before gradually resolving.
In immunocompromised patients, Bartonella causes something different entirely: Bacillary angiomatosis is a proliferative vascular disease resembling Kaposi sarcoma, with red-purple papular skin lesions and visceral involvement. It occurs primarily in AIDS patients and responds to antibiotic therapy.
Anaplasma phagocytophilum and Ehrlichia chaffeensis
These obligate intracellular bacteria cause clinically similar tick-borne diseases that were only recognized in the 1990s. Both infect white blood cells and produce characteristic intracytoplasmic inclusion bodies called morulae (from Latin for mulberry, describing the stippled appearance).
Anaplasma phagocytophilum causes human granulocytic anaplasmosis (HGA). It’s transmitted by Ixodes ticks-the same ticks that transmit Lyme disease and Babesia-making coinfection possible. Anaplasma infects neutrophils; morulae within neutrophils on peripheral blood smear are diagnostic when present.
Ehrlichia chaffeensis causes human monocytic ehrlichiosis (HME). It’s transmitted by Amblyomma americanum (Lone Star tick), which dominates the southeastern United States. Ehrlichia infects monocytes; morulae appear within monocytes.
Both diseases present similarly: Fever, headache, myalgia, and malaise develop about a week after a tick bite. Laboratory findings are often striking-leukopenia, thrombocytopenia, and elevated liver enzymes. This triad in a patient with tick exposure should prompt empiric doxycycline treatment immediately, before confirmatory testing returns.
Why doxycycline matters urgently: Both diseases can progress to severe illness with respiratory failure, meningitis, and death. Doxycycline is highly effective if started early, but delayed treatment increases mortality. When the clinical picture suggests ehrlichiosis or anaplasmosis, treat first and confirm later.
Chapter 44: Curved and Spiral Bacteria
This chapter covers bacteria with curved or spiral morphology-Vibrio, Campylobacter, and Helicobacter. Despite sharing similar shapes, they cause very different diseases.
44.1 Vibrio
The vibrios are curved gram-negative rods that live in aquatic environments. They’re halophilic (salt-loving), which explains their association with seafood and seawater. The genus includes three clinically important species, each causing distinct disease.
Vibrio cholerae and epidemic cholera: Cholera remains one of the great epidemic diseases of human history, still causing outbreaks where sanitation fails. Understanding the mechanism explains everything about the clinical presentation.
Cholera toxin is the prototype A-B toxin-five B subunits bind to GM1 ganglioside on intestinal epithelial cells and deliver the A subunit inside. The A subunit ADP-ribosylates the Gs protein, locking it in an active state. With Gs perpetually active, adenylate cyclase produces cAMP continuously. Elevated cAMP opens chloride channels, and chloride floods into the intestinal lumen, dragging sodium and water with it. The result is massive secretory diarrhea-patients can lose 10-20 liters per day, with stool that looks like rice water (the flecks are bits of mucus).
The critical clinical point: cholera is not an inflammatory disease. There’s no fever, no blood in the stool, no fecal leukocytes. The bacteria don’t invade-they simply produce toxin. Death comes from dehydration and electrolyte imbalance, which means treatment is fundamentally about fluid replacement. Oral rehydration solution (ORS) exploits the fact that glucose-sodium cotransport is preserved-glucose in the gut lumen enhances sodium (and water) absorption, partially compensating for secretory losses. This simple intervention has saved millions of lives.
Vibrio parahaemolyticus causes a milder gastroenteritis associated with raw or undercooked seafood, particularly oysters. The illness is self-limited.
Vibrio vulnificus is far more dangerous. It causes two syndromes. Wound infections occur when seawater contaminates cuts or abrasions-the result is rapidly progressive cellulitis that can advance to necrotizing fasciitis within hours. Primary septicemia occurs when people with liver disease or iron overload eat raw oysters-the bacteria cross from the gut into the bloodstream, causing septic shock with characteristic bullous skin lesions. Mortality exceeds 50%. Patients with liver disease should never eat raw oysters.
44.2 Campylobacter jejuni
Campylobacter is the most common bacterial cause of diarrhea in developed countries, surpassing Salmonella and Shigella. It’s a curved or S-shaped gram-negative rod that appears as “gull wings” on Gram stain.
The poultry connection: Campylobacter colonizes the intestinal tract of birds, which have a body temperature of 42°C. The organism grows optimally at this temperature-a feature that helps identify it in the laboratory. Contaminated poultry is the major source of human infection. Cross-contamination in the kitchen (cutting vegetables on a board used for raw chicken) is a common route.
Microaerophilic metabolism: Campylobacter requires a special atmosphere-low oxygen (5-10%) and high carbon dioxide (10%)-to grow. This microaerophilic requirement means routine aerobic cultures won’t recover it. The laboratory must set up specific Campylobacter culture, usually on selective media at 42°C in a microaerophilic environment.
Clinical presentation: Campylobacter causes an inflammatory enteritis-bloody diarrhea with fever and abdominal pain. The illness is usually self-limited over a week. Antibiotics (azithromycin) can shorten the duration if given early.
Post-infectious complications: The most important sequela is Guillain-Barré syndrome (GBS). About 1 in 1,000 Campylobacter infections triggers GBS, an autoimmune attack on peripheral nerves that causes ascending paralysis. The mechanism is molecular mimicry-antibodies against Campylobacter lipooligosaccharide cross-react with gangliosides on nerve membranes. Campylobacter is the most commonly identified preceding infection in GBS.
Laboratory identification: The gull-wing morphology on Gram stain is characteristic. The organism is oxidase positive. Culture requires microaerophilic conditions at 42°C-request it specifically when Campylobacter is suspected. The illness is typically self-limited over 3-7 days.
Post-infectious complications: Beyond Guillain-Barré syndrome, Campylobacter can trigger reactive arthritis-sterile joint inflammation that occurs weeks after the initial infection, particularly in HLA-B27 positive individuals.
44.3 Helicobacter pylori
Helicobacter pylori has transformed our understanding of gastric disease. For centuries, peptic ulcers were blamed on stress, diet, and excess acid. The discovery that most ulcers are caused by a bacterial infection-and can be cured with antibiotics-earned Barry Marshall and Robin Warren the 2005 Nobel Prize.
How it survives in acid: The stomach should be an impossible environment for bacteria. H. pylori has evolved a remarkable solution: it produces abundant urease, which converts urea to ammonia. The ammonia neutralizes gastric acid locally, creating a micro-environment where the bacterium can survive. This urease production is so characteristic that it’s the basis for several diagnostic tests.
H. pylori doesn’t invade tissue-it lives in the mucus layer overlying the gastric epithelium. But chronic infection induces persistent inflammation (chronic active gastritis), which over decades can lead to serious complications.
The spectrum of H. pylori disease: Nearly everyone infected with H. pylori develops chronic gastritis, but only a minority develop complications. Why some people get ulcers or cancer while others remain asymptomatic involves complex interactions between bacterial virulence factors (like the CagA cytotoxin), host genetics, and environmental factors.
Peptic ulcer disease develops in about 15-20% of infected individuals. The majority of duodenal ulcers and a significant proportion of gastric ulcers are caused by H. pylori-not NSAIDs or stress. Eradicating the infection cures the ulcer disease and prevents recurrence.
Gastric adenocarcinoma develops in about 1% of infected individuals over decades. The progression involves chronic gastritis → atrophic gastritis → intestinal metaplasia → dysplasia → carcinoma. H. pylori is classified as a Class I carcinogen. Geographic variation in gastric cancer rates correlates with H. pylori strain virulence.
MALT lymphoma (mucosa-associated lymphoid tissue lymphoma) is a remarkable example of infection-driven malignancy. The chronic antigenic stimulation of H. pylori drives lymphoid proliferation that can progress to frank lymphoma. Remarkably, early-stage MALT lymphomas often regress completely with H. pylori eradication alone-curing cancer with antibiotics.
Diagnostic approaches: Non-invasive tests include the urea breath test and stool antigen test, both of which detect active infection. In the breath test, the patient ingests labeled urea; if H. pylori is present, its urease breaks down the urea and labeled CO2 is detected in breath. Serology indicates exposure but cannot distinguish active from past infection. Invasive testing during endoscopy includes the rapid urease test (CLO test), histology, and culture. Proton pump inhibitors and antibiotics must be stopped before testing as they can cause false negatives.
Treatment requires combination therapy: H. pylori has developed resistance to individual antibiotics, so treatment requires multiple drugs simultaneously. Standard regimens include a proton pump inhibitor plus two or three antibiotics (clarithromycin, amoxicillin, metronidazole, or bismuth-containing quadruple therapy). Increasing clarithromycin resistance has complicated empiric treatment; where resistance is common, bismuth quadruple therapy or fluoroquinolone-based regimens are preferred.
44.4 Spirochetes
The spirochetes are a distinctive group of bacteria with a unique morphology-long, thin, helical cells that move by rotating around their long axis in a corkscrew motion. This motility is powered by axial filaments (endoflagella) that run between the cell membrane and outer membrane. Three genera cause human disease: Treponema (syphilis), Borrelia (Lyme disease and relapsing fever), and Leptospira (leptospirosis). Despite their similar morphology, they cause vastly different diseases.
Treponema pallidum (Syphilis)
Syphilis is the great imitator-a sexually transmitted infection that can mimic almost any disease. It progresses through defined stages over years to decades, and if untreated, can ultimately destroy the cardiovascular and nervous systems. The organism cannot be cultured in vitro, which has hampered research but also means diagnosis relies on serology and clinical recognition.
Primary syphilis appears 10-90 days after exposure (average 21 days) as a chancre at the site of inoculation-usually the genitals, but also mouth, anus, or fingers. The chancre is painless, indurated, and clean-based. It teems with spirochetes and is highly infectious. Even without treatment, the chancre heals spontaneously within 3-6 weeks, but the infection persists.
Secondary syphilis develops 4-10 weeks later when spirochetes disseminate hematogenously. The hallmark is a diffuse rash that classically involves the palms and soles-one of the few infections that does this (remember: syphilis, Rocky Mountain spotted fever, hand-foot-mouth disease). Condyloma lata are moist, warty lesions in intertriginous areas. Mucous patches are painless gray lesions on oral mucosa. Constitutional symptoms-fever, malaise, generalized lymphadenopathy-are common. Like primary disease, secondary syphilis resolves spontaneously, but the infection continues.
Latent syphilis is the asymptomatic period between secondary disease and potential tertiary complications. Early latent (infection within the past year) may still be infectious; late latent (infection of unknown duration or more than a year) is generally not. Patients are identified only through serologic screening.
Tertiary syphilis develops in about one-third of untreated patients, years to decades after initial infection. Gummas are granulomatous lesions that can affect skin, bone, or viscera-destructive but treatable. Cardiovascular syphilis attacks the aorta, causing aortitis, aortic root dilation, aortic regurgitation, and aneurysm of the ascending aorta. Neurosyphilis can occur at any stage but classically presents late as tabes dorsalis (posterior column degeneration with sensory ataxia and lancinating pains) or general paresis (dementia, personality change, psychosis).
Congenital syphilis occurs when T. pallidum crosses the placenta, particularly in early maternal infection. Early manifestations in infants include rhinitis (“snuffles”), hepatosplenomegaly, and rash. Late manifestations-appearing after age 2-include the classic Hutchinson triad (notched central incisors, interstitial keratitis, and eighth nerve deafness), saddle nose deformity, and saber shins.
Serodiagnosis requires understanding two test categories: Non-treponemal tests (RPR, VDRL) detect antibodies to cardiolipin, a lipid released from damaged host cells and present in treponemal membranes. They’re sensitive but not specific-false positives occur in pregnancy, autoimmune disease, and other infections. Titers correlate with disease activity and decline with successful treatment, making them useful for monitoring. Treponemal tests (FTA-ABS, TP-PA, EIA) detect antibodies to T. pallidum antigens. They’re specific and confirm the diagnosis, but they remain positive for life even after successful treatment-a “serologic scar.”
The traditional algorithm screens with a non-treponemal test and confirms positives with a treponemal test. The reverse sequence algorithm, now widely used, screens with a treponemal EIA (automated, cheap) and confirms with RPR. Discordant results (positive EIA, negative RPR) require a second treponemal test (TP-PA) for resolution.
Neurosyphilis diagnosis requires CSF examination. CSF-VDRL is specific but insensitive (may miss 30-50% of cases). CSF pleocytosis and elevated protein support the diagnosis.
Borrelia burgdorferi (Lyme Disease)
Lyme disease is the most common vector-borne disease in the United States and Europe. It’s caused by Borrelia burgdorferi (in North America) and related species (in Europe), transmitted by Ixodes ticks-the same ticks that carry Anaplasma and Babesia, making coinfection possible.
The tick must feed for 36-48 hours to transmit infection, which is why daily tick checks after outdoor activities in endemic areas are effective prevention. The endemic areas in the US are the Northeast, Mid-Atlantic, and upper Midwest (where white-footed mice and white-tailed deer maintain the transmission cycle) and northern California.
Early localized disease appears 3-30 days after the tick bite. Erythema migrans (EM) is the characteristic rash-an expanding erythematous patch that often (but not always) has central clearing, creating the “bull’s eye” appearance. EM is pathognomonic for Lyme disease; when present, it makes the diagnosis-serology is unnecessary and often negative this early. The rash is usually at least 5 cm in diameter and expands over days.
Early disseminated disease develops weeks to months later when spirochetes spread hematogenously. Multiple EM lesions may appear. Neurologic involvement includes facial nerve palsy (Bell’s palsy-Lyme disease is a common cause, especially bilateral cases), lymphocytic meningitis, and radiculopathy. Cardiac involvement causes AV block, which can be high-grade and require temporary pacing.
Late disease appears months to years after infection, most commonly as Lyme arthritis-typically a monoarticular or oligoarticular inflammatory arthritis affecting large joints, especially the knee. Episodes may be recurrent. Chronic neurologic disease (encephalopathy, peripheral neuropathy) is less common.
Diagnosis depends on the stage: Early localized disease with classic EM is a clinical diagnosis-treat without waiting for serology. For later stages, two-tier serologic testing is standard: screen with ELISA or immunofluorescence assay, then confirm positive or equivocal results with Western blot. Both IgM and IgG Western blots are performed early; after 4-6 weeks of symptoms, only IgG is relevant (IgM can remain positive and cause false-positive results). Newer testing approaches using multiple Borrelia antigens in a single assay are replacing traditional Western blot.
Borrelia Species (Relapsing Fever)
Relapsing fever is caused by different Borrelia species that have evolved a remarkable immune evasion strategy: antigenic variation. Just as the host mounts an antibody response, the bacteria switch their surface proteins, escaping immune clearance. The result is a pattern of recurring febrile episodes separated by afebrile intervals.
Two epidemiologic forms exist: Epidemic (louse-borne) relapsing fever is caused by B. recurrentis, transmitted by body lice. It occurs in conditions of overcrowding and poor hygiene-war, famine, refugee camps-where lice thrive. It’s rare today but can cause explosive outbreaks. Endemic (tick-borne) relapsing fever is caused by several Borrelia species (B. hermsii in North America) transmitted by soft-bodied Ornithodoros ticks. These ticks live in rodent burrows and infest rustic mountain cabins; tourists who sleep in such cabins are at risk.
The clinical pattern is distinctive: Sudden onset of high fever, headache, myalgia, and sometimes hepatosplenomegaly, lasting 3-7 days, then resolving abruptly-often with drenching sweats. Days later, fever recurs. Without treatment, multiple relapses occur, each typically milder than the last as the immune system gradually controls infection.
Diagnosis can be made by blood smear: Unlike Treponema and Borrelia burgdorferi, relapsing fever spirochetes reach high enough concentrations in blood to be visible on Wright- or Giemsa-stained peripheral smears during febrile episodes. This is unusual for spirochetes and aids rapid diagnosis.
The Jarisch-Herxheimer reaction is common when treatment begins-within hours of the first antibiotic dose, patients develop sudden fever, rigors, hypotension, and tachycardia. This results from release of bacterial components (possibly lipoproteins) and cytokine release as spirochetes die. It’s also seen in syphilis treatment and can be dangerous in late pregnancy or severe disease. Patients should be warned; supportive care is the management.
Leptospira interrogans (Leptospirosis)
Leptospirosis is the most widespread zoonotic disease in the world, caused by spirochetes with a distinctive morphology-thin, tightly coiled, with hooked ends that give them a question-mark shape. The disease ranges from mild flu-like illness to severe multiorgan failure.
Transmission occurs through environmental contamination: Infected animals-especially rats, but also dogs, livestock, and wildlife-shed leptospires in their urine for months to years. The organisms survive in warm, moist environments: fresh water, mud, and moist soil. Humans become infected when contaminated water or soil contacts abraded skin or mucous membranes. Risk factors include occupational exposure (farmers, veterinarians, sewer workers, military personnel), recreational water activities (swimming, kayaking in contaminated water), and flooding events in endemic areas.
The clinical spectrum spans mild to catastrophic: Most infections cause anicteric leptospirosis-a biphasic illness with sudden fever, severe headache, and myalgia (classically severe calf muscle pain), followed by an immune phase with recurrent fever. Conjunctival suffusion-redness of the conjunctivae without purulent discharge-is a classic finding that helps distinguish leptospirosis from other acute febrile illnesses.
Weil disease is severe leptospirosis with jaundice, acute kidney injury, and hemorrhage. The jaundice results from hepatocyte dysfunction but is typically not accompanied by hepatocellular necrosis-transaminases are only modestly elevated. Renal failure is usually non-oliguric and reversible. Pulmonary hemorrhage is increasingly recognized as a severe manifestation with high mortality.
Diagnosis: The clinical picture in an appropriate epidemiologic setting should prompt empiric treatment. Laboratory confirmation relies on serology (the microscopic agglutination test, MAT, is the reference standard) or PCR of blood or urine. Culture is possible but too slow for clinical utility.
Treatment: Doxycycline for mild disease; penicillin G for severe cases, though the evidence base is limited. Doxycycline prophylaxis can prevent infection in high-risk exposures.
Chapter 45: Mycobacteria
The mycobacteria are a distinctive group of bacteria defined by their unusual cell wall-rich in mycolic acids that make them impermeable to many stains and antibiotics. This waxy coat is responsible for their acid-fast staining, their slow growth (nutrients can’t get in quickly), and their ability to survive inside macrophages. The genus includes the two great human pathogens-M. tuberculosis and M. leprae-as well as numerous environmental species that cause opportunistic infections.
45.1 Mycobacterium tuberculosis
Tuberculosis has killed more people than any other infectious disease in human history. Even today, it infects one-quarter of the world’s population and kills over a million people annually. Understanding TB requires grasping the delicate balance between pathogen and host immunity that determines whether infection leads to disease.
The unique cell wall determines everything about TB: The mycobacterial cell wall is 60% lipid by weight, dominated by mycolic acids-long-chain fatty acids linked to arabinogalactan. This waxy barrier makes TB impermeable to many antibiotics, resistant to desiccation (allowing airborne transmission), and invisible to routine Gram staining. Cord factor (trehalose dimycolate) contributes to virulence and causes the characteristic serpentine cording pattern seen on culture.
Transmission and the initial encounter: TB is transmitted by airborne droplet nuclei-particles small enough (1-5 μm) to remain suspended in air and reach the alveoli. A single cough from a patient with cavitary pulmonary TB can generate thousands of infectious particles. After inhalation, bacilli are engulfed by alveolar macrophages. Unlike most bacteria, M. tuberculosis survives inside macrophages by preventing phagosome-lysosome fusion-it essentially converts the phagosome into a comfortable niche for replication.
The granuloma-containment but not elimination: Over 2-8 weeks, cell-mediated immunity develops. CD4+ T cells recognize mycobacterial antigens, secrete interferon-gamma, and activate macrophages to form granulomas-organized structures that wall off the bacteria. The center becomes necrotic (caseous necrosis), and multinucleated giant cells (Langhans giant cells) form at the periphery. In most people, this containment is successful-the bacteria persist in a dormant state, causing latent TB infection (LTBI). These individuals have positive skin tests or IGRAs but no symptoms, no abnormal chest radiographs, and are not infectious.
From latent to active-when containment fails: About 5-10% of people with LTBI eventually develop active TB disease, usually within the first two years but sometimes decades later. Reactivation occurs when immunity wanes-HIV infection is the most powerful risk factor, followed by immunosuppressive therapy, diabetes, malnutrition, and aging. Primary progressive disease can also occur, particularly in young children and the immunocompromised, when the initial infection overwhelms host defenses.
Clinical manifestations of active TB: Pulmonary TB is the most common form. Classic symptoms include chronic cough (often productive), hemoptysis, night sweats, fever, and weight loss. The upper lobes are preferred because higher oxygen tension favors this aerobe, and impaired lymphatic drainage allows bacterial persistence. Chest imaging shows infiltrates, cavities, or nodules, often in the upper lobes or superior segments of the lower lobes. Cavitary disease is highly infectious.
Miliary TB results from hematogenous dissemination, producing countless tiny granulomas throughout the body. Chest X-ray shows diffuse miliary (millet seed-sized) nodules. It occurs in immunocompromised patients and young children.
Extrapulmonary TB can affect any organ. Lymph node involvement (scrofula) is the most common extrapulmonary form. Pleural TB causes exudative effusions. Skeletal TB classically affects the spine (Pott disease). TB meningitis has insidious onset and carries high mortality.
Diagnostic testing depends on the clinical question: For LTBI, we test immune response to TB antigens. The tuberculin skin test (TST/PPD) measures delayed-type hypersensitivity-a positive test indicates exposure and immune priming. However, TST is confounded by prior BCG vaccination (common worldwide) and cross-reacts with nontuberculous mycobacteria. Interferon-gamma release assays (IGRAs) like QuantiFERON-TB Gold measure T-cell interferon-gamma production in response to TB-specific antigens (ESAT-6, CFP-10) not present in BCG or most NTM. IGRAs are more specific than TST and require only a single blood draw. Neither test distinguishes latent from active disease-they tell you only that immune response exists.
For active TB, we need to find the organism. AFB smear (acid-fast staining of sputum or other specimens) is rapid but requires high bacterial burden and cannot distinguish TB from NTM. Culture on solid media (Löwenstein-Jensen) or liquid media (MGIT) is the gold standard and provides organisms for drug susceptibility testing, but results take 2-6 weeks. Nucleic acid amplification tests (NAAT), particularly GeneXpert MTB/RIF, have transformed TB diagnosis-they can detect M. tuberculosis DNA directly from sputum within 2 hours and simultaneously identify rifampin resistance, flagging potential MDR-TB.
Treatment requires multiple drugs for prolonged duration: Standard treatment for drug-susceptible pulmonary TB uses four drugs initially (RIPE: Rifampin, Isoniazid, Pyrazinamide, Ethambutol) for 2 months, then two drugs (Rifampin and Isoniazid) for 4 more months. This prolonged, multi-drug regimen is essential to prevent resistance emergence-TB’s slow growth means that mutations conferring resistance, though rare, will occur unless multiple drugs attack the bacteria simultaneously.
Drug-resistant TB is a global crisis: MDR-TB is resistant to at least isoniazid and rifampin, the two most effective drugs. Treatment requires 18-24 months of toxic second-line agents. XDR-TB (extensively drug-resistant) is MDR-TB plus resistance to fluoroquinolones and at least one injectable agent-options become extremely limited. Newer drugs (bedaquiline, delamanid) offer hope for these difficult cases.
45.2 Nontuberculous Mycobacteria (NTM)
The nontuberculous mycobacteria are environmental organisms found in soil and water worldwide. Unlike M. tuberculosis, they’re not transmitted person-to-person-humans acquire them from the environment. They cause disease primarily in two settings: structural lung disease (bronchiectasis, COPD, cystic fibrosis) where damaged airways can’t clear inhaled organisms, and immunocompromised states where the host can’t contain infection.
Distinguishing clinical relevance from colonization is critical: Because NTM are environmental, isolating them from respiratory specimens doesn’t necessarily mean disease. A patient might simply be colonized, or the specimen might be contaminated. The American Thoracic Society criteria for NTM lung disease require clinical symptoms, radiographic abnormalities, AND microbiologic evidence (multiple positive cultures or positive culture from sterile site).
Classification by growth rate guides identification: Slow growers (>7 days for colonies) include M. avium complex, M. kansasii, and M. marinum. Rapid growers (<7 days) include M. abscessus, M. fortuitum, and M. chelonae.
Mycobacterium avium complex (MAC) is the most common NTM pathogen. In patients with structural lung disease (particularly older women with bronchiectasis-“Lady Windermere syndrome”), MAC causes chronic pulmonary infection with nodules and tree-in-bud pattern on CT. In AIDS patients with CD4 counts below 50, MAC causes disseminated disease with fever, weight loss, anemia, and elevated alkaline phosphatase. Treatment requires prolonged combination therapy (clarithromycin plus ethambutol plus rifamycin for at least 12 months) and is often difficult, with frequent relapse.
Mycobacterium kansasii causes TB-like pulmonary disease-upper lobe cavities, symptoms mimicking tuberculosis-but is generally easier to treat than MAC.
Mycobacterium marinum causes the classic “fish tank granuloma”-a nodular skin infection acquired from handling fish or cleaning aquariums. It grows optimally at 30°C (cooler than body temperature), which explains its predilection for cooler extremities.
Mycobacterium abscessus is the most problematic rapid-grower-highly drug-resistant and increasingly recognized in cystic fibrosis patients. Treatment is prolonged and often unsuccessful.
Mycobacterium leprae (Hansen Disease): Leprosy is covered here for completeness, though it’s clinically distinct. M. leprae has never been cultured in vitro-it grows only in armadillos and mouse footpads-and causes disease after years of incubation. The clinical spectrum depends on host immunity: tuberculoid leprosy (few lesions, few organisms, strong cellular immunity) versus lepromatous leprosy (numerous lesions, enormous bacterial load, weak cellular immunity). Nerve involvement-thickened peripheral nerves with sensory loss-is characteristic. Treatment uses dapsone, rifampin, and clofazimine in multidrug regimens.
Chapter 46: Atypical Bacteria (Gram-Indeterminate)
This chapter covers bacteria that don’t fit neatly into the gram-positive/gram-negative classification-either because they lack a cell wall entirely (Mycoplasma), live exclusively inside host cells (Rickettsia, Chlamydia, Coxiella), or stain variably. Despite their diversity, these organisms share important clinical features: they don’t grow on routine culture media, they don’t respond to cell wall-active antibiotics, and diagnosing them requires a high index of suspicion.
Rickettsia Species
The rickettsiae are obligate intracellular bacteria transmitted by arthropod vectors-ticks, lice, and fleas. They’ve evolved to live inside vascular endothelial cells, and this tropism explains the clinical manifestations: these are diseases of small blood vessels.
When rickettsiae infect endothelium, they cause endothelial cell injury, increased vascular permeability, and vasculitis. The clinical result is a constellation of fever, rash, and-in severe cases-vascular leak leading to edema, hypotension, and end-organ damage. The rash in rickettsial diseases often involves the palms and soles, which should always trigger consideration of these infections.
Rickettsia rickettsii (Rocky Mountain Spotted Fever)
Rocky Mountain spotted fever is a misnomer-the disease is most common in the southeastern United States, not the Rocky Mountains. But the name persists, and so does the disease’s lethality if not recognized and treated promptly.
The tick connection: R. rickettsii is transmitted by Dermacentor ticks-the American dog tick in the East and the Rocky Mountain wood tick in the West. The tick must be attached for several hours before transmission occurs, which is why careful tick checks after outdoor activities can prevent infection.
Pathogenesis explains the clinical picture: The bacteria invade vascular endothelium throughout the body. As endothelial cells are damaged, vessels become leaky. Fluid escapes into tissues, causing edema and hypovolemia. Damaged vessels thrombose, causing tissue ischemia. The brain, lungs, and kidneys are particularly vulnerable.
The classic triad is fever, headache, and rash-but this triad develops sequentially, not all at once. Fever and headache come first, often with myalgias so severe they’re described as “bone-breaking.” The rash typically appears on days 3-5 of illness, starting at the wrists and ankles and spreading centripetally toward the trunk. Initially macular, the rash becomes petechial as vasculitis progresses. Involvement of the palms and soles is characteristic-and should make you think of RMSF (along with secondary syphilis and endocarditis).
The treatment imperative: RMSF has a mortality rate of 20-30% if untreated, but less than 5% with appropriate treatment. The critical point is that doxycycline must be started based on clinical suspicion-before laboratory confirmation. Serology (the diagnostic test) doesn’t become positive until the second week of illness, and waiting for results is often fatal. Doxycycline is the treatment of choice even in children, where the risk of dental staining is far outweighed by the risk of death from untreated RMSF.
Rickettsia prowazekii (Epidemic Typhus)
Epidemic typhus is a disease of human suffering-it flourishes wherever people are crowded together in conditions that promote louse infestation: wars, famines, refugee camps, and prisons. The body louse (Pediculus humanus corporis) is the vector; humans are the reservoir.
The historical devastation: Typhus has killed millions throughout history, often determining the outcomes of wars. Napoleon’s army was decimated by typhus during the retreat from Moscow. The disease swept through concentration camps in World War II. Whenever social order collapses and people crowd together without access to clean clothing and bathing, typhus appears.
Clinical features: After an incubation period of 1-2 weeks, patients develop abrupt high fever, severe headache, and myalgias. The rash appears around day 5, starting on the trunk and spreading centrifugally to the extremities-the opposite pattern from RMSF. The rash typically spares the face, palms, and soles. Severe cases progress to stupor (the word “typhus” comes from the Greek for “smoky” or “hazy,” describing the mental clouding), shock, and death.
Brill-Zinsser disease: R. prowazekii can persist for years in a dormant state, reactivating decades later when host immunity wanes. This recrudescent disease, called Brill-Zinsser disease, is milder than primary infection but can serve as a source for new epidemics if lice are present.
Rickettsia typhi (Endemic/Murine Typhus)
Endemic typhus is maintained in a rat-flea-rat cycle; humans are incidental hosts infected by flea feces. Unlike epidemic typhus, it doesn’t require human crowding-just proximity to rats. The disease is milder than epidemic typhus, with a mortality rate under 5%, but it’s increasingly recognized as a cause of undifferentiated febrile illness in tropical and subtropical regions.
Coxiella burnetii (Q Fever)
Coxiella burnetii is the black sheep of the rickettsial family-it shares their obligate intracellular lifestyle but breaks all the other rules. It’s not transmitted by arthropod bite. It doesn’t primarily target endothelium. And it’s phenomenally resistant to environmental conditions.
An extraordinary organism: C. burnetii forms a spore-like structure that can survive for months to years in the environment. It’s one of the most infectious organisms known-a single bacterium can cause disease. These properties make it a potential bioterrorism agent and explain its epidemiology: infection occurs through inhalation of contaminated aerosols, not through bites.
The animal connection: The primary reservoirs are cattle, sheep, and goats. The organisms are found in extremely high concentrations in placental tissue, amniotic fluid, and milk. People at risk include farmers, veterinarians, and slaughterhouse workers, but outbreaks have occurred downwind from infected farms. The “Q” in Q fever stands for “query”-the disease was named before its cause was identified.
Two faces of Q fever: Acute Q fever typically presents as an undifferentiated febrile illness, atypical pneumonia, or hepatitis. It’s self-limited in most cases, though severe disease can occur.
Chronic Q fever is a different beast entirely. The organism persists intracellularly and causes endocarditis, typically affecting patients with pre-existing valve abnormalities (especially prosthetic valves or bicuspid aortic valves). Q fever endocarditis is one of the classic “culture-negative” endocarditis syndromes-because Coxiella won’t grow on standard media. It requires prolonged treatment (at least 18 months) with doxycycline plus hydroxychloroquine, and even then, relapse is common.
Diagnosis: Serology is the primary diagnostic method. C. burnetii undergoes phase variation-the organism expresses different surface antigens (phase I vs phase II) depending on conditions. In acute infection, phase II antibodies predominate. In chronic infection, phase I antibodies rise to high titers. This serologic pattern helps distinguish acute from chronic disease.
Chlamydia and Chlamydophila
The chlamydiae are obligate intracellular bacteria with a unique developmental cycle that makes them fundamentally different from other bacteria. They exist in two forms that alternate during infection, and understanding this cycle explains their biology and pathogenesis.
The biphasic life cycle: The elementary body (EB) is the infectious form. It’s small, metabolically inactive, and tough enough to survive outside cells. Think of it as a spore-like transmission stage. When an EB attaches to a host cell, it triggers its own uptake into an endosomal compartment that doesn’t fuse with lysosomes-the chlamydiae have evolved to prevent their own destruction.
Inside this protected vacuole (called an inclusion), the EB transforms into a reticulate body (RB). The RB is larger, metabolically active, and capable of replication-but it cannot survive outside cells. After multiple rounds of replication, RBs transform back into EBs, which are released when the cell ruptures to begin the cycle anew.
This cycle takes 48-72 hours, which has clinical implications: chlamydial infections are chronic, often indolent, and associated with repeated cycles of inflammation and scarring.
Why they can’t be Gram stained: Chlamydiae have a cell wall, but it lacks peptidoglycan-the component that retains the crystal violet-iodine complex in gram-positive bacteria. This is why β-lactams, which target peptidoglycan synthesis, are ineffective.
Chlamydia trachomatis
C. trachomatis is the most common bacterial STI in developed countries and the leading infectious cause of blindness worldwide. Different serovars cause remarkably different diseases-a testament to the specificity of bacterial-host cell interactions.
Serovars A, B, and C cause trachoma, an ocular infection endemic in developing countries with limited access to clean water. Repeated infections lead to chronic inflammation, scarring of the inner eyelid, and eventually trichiasis-inward turning of the eyelashes that abrades the cornea with each blink. The end result is corneal opacity and blindness. Trachoma affects millions globally and is theoretically preventable with improved sanitation and mass antibiotic treatment programs.
Serovars D-K cause urogenital infections. In women, the primary site is the cervix; in men, the urethra. Most infections are asymptomatic, which is the crux of the problem-people spread infection without knowing they’re infected. When symptoms occur, they’re often mild: mucopurulent discharge, dysuria, pelvic discomfort.
The danger lies in ascending infection. In women, C. trachomatis can ascend to the upper genital tract, causing pelvic inflammatory disease (PID). Repeated episodes of PID cause tubal scarring, leading to ectopic pregnancy and infertility. This is why screening programs for chlamydia in young women are so important-treating asymptomatic infection prevents these devastating complications.
Reactive arthritis (formerly Reiter syndrome): Some patients develop an autoimmune response triggered by chlamydial infection. The classic triad is urethritis, conjunctivitis, and arthritis-“can’t pee, can’t see, can’t climb a tree.” This occurs primarily in HLA-B27 positive individuals.
Serovars L1, L2, and L3 cause lymphogranuloma venereum (LGV), a more invasive STI that presents with painful inguinal lymphadenopathy (buboes) and can cause rectal strictures and fistulas. LGV was rare in developed countries but has reemerged among men who have sex with men.
Neonatal infections: Babies born to mothers with cervical chlamydia can acquire infection during passage through the birth canal. Neonatal conjunctivitis develops 5-14 days after birth (later than gonococcal ophthalmia). Chlamydial pneumonia presents at 1-3 months of age with a distinctive staccato cough and absence of fever.
Chlamydophila pneumoniae
C. pneumoniae (formerly Chlamydia pneumoniae) is a respiratory pathogen transmitted person-to-person via respiratory droplets-no intermediate host required. It’s a common cause of community-acquired pneumonia, accounting for about 10% of cases.
The clinical picture: C. pneumoniae pneumonia tends to be subacute, beginning with upper respiratory symptoms-sore throat, hoarseness, and a persistent cough that may linger for weeks. Fever is usually low-grade. The pneumonia itself is typically mild (“walking pneumonia”), though severe disease can occur, especially in elderly patients.
Diagnostic challenges: Like other chlamydiae, C. pneumoniae won’t grow on routine culture. Serology is available but complicated by the organism’s ubiquity-most adults have been exposed. PCR is increasingly used but not universally available.
Chlamydophila psittaci (Psittacosis)
C. psittaci causes psittacosis, also called parrot fever-a zoonotic infection acquired from birds. The organism is found in the respiratory secretions and feces of infected birds, and humans become infected by inhaling contaminated aerosols.
Bird exposure is the key to diagnosis: Pet store workers, poultry workers, and bird owners are at risk. The presentation is atypical pneumonia with prominent headache-headache is often described as the most severe symptom, which can help distinguish psittacosis from other causes of atypical pneumonia.
Mycoplasma pneumoniae
Mycoplasma pneumoniae holds a unique position in microbiology: it’s the smallest free-living organism capable of self-replication, and it lacks a cell wall entirely. These features have profound clinical implications.
Why the missing wall matters: Without a cell wall, Mycoplasma is invisible on Gram stain-there’s nothing for the stain to bind to. More importantly, cell wall-active antibiotics (β-lactams, vancomycin) are completely ineffective. You cannot treat Mycoplasma with penicillin or cephalosporins.
The missing wall also makes Mycoplasma pleomorphic and difficult to culture. It grows slowly, requiring specialized media rich in sterols (which it needs for membrane stability since it can’t make a wall). Colonies have a characteristic “fried egg” appearance-a dense center with a thinner spreading periphery-but this requires 1-3 weeks of incubation.
The classic presentation is “walking pneumonia”: Mycoplasma pneumonia is the archetypal atypical pneumonia. It predominantly affects young adults (ages 5-35) and presents gradually with malaise, low-grade fever, and a dry, hacking cough that can persist for weeks. Patients often feel relatively well despite chest X-ray findings-hence “walking” pneumonia. The X-ray typically shows patchy interstitial infiltrates that look worse than the patient seems.
Extrapulmonary manifestations hint at immunologic phenomena: Mycoplasma can trigger autoimmune responses. Erythema multiforme (targetoid skin lesions) occurs in some patients. The most interesting phenomenon is cold agglutinins-IgM antibodies that bind to the I antigen on red blood cells at cold temperatures, causing agglutination. This can be demonstrated at the bedside by placing a tube of the patient’s blood on ice and observing clumping that reverses with warming. Cold agglutinins occur in about half of Mycoplasma pneumonia cases and, in high titers, can cause clinically significant hemolytic anemia.
Diagnosis: PCR of respiratory specimens is becoming the diagnostic method of choice. Serology (looking for specific IgM or a fourfold rise in IgG) is also used. The cold agglutinin test is nonspecific but supportive when positive.
Gardnerella vaginalis and Bacterial Vaginosis
Bacterial vaginosis (BV) is not a true infection in the classical sense-there’s no single pathogen invading host tissue. Instead, it represents a disruption of the normal vaginal ecosystem: the protective lactobacilli that normally dominate the vaginal flora are replaced by an overgrowth of mixed anaerobes, including Gardnerella vaginalis, Mobiluncus, Prevotella, and others.
The ecology of the vagina: A healthy vagina is dominated by Lactobacillus species, which produce lactic acid and maintain a low pH (3.8-4.5). This acidic environment suppresses the growth of many potential pathogens. In BV, lactobacilli disappear, pH rises above 4.5, and anaerobes flourish. What triggers this shift is not fully understood, but risk factors include douching, new sexual partners, and IUD use.
Clinical presentation: The hallmark of BV is a thin, grayish-white vaginal discharge with a fishy odor. The odor intensifies after intercourse (semen is alkaline) and can be released by adding potassium hydroxide (KOH) to a sample-the “whiff test.” Unlike vaginitis caused by Trichomonas or Candida, BV typically doesn’t cause significant inflammation; pruritus and dysuria are absent.
Diagnosis relies on the Amsel criteria-three of four findings make the diagnosis: (1) thin, homogeneous discharge; (2) vaginal pH >4.5; (3) positive whiff test; (4) clue cells on wet mount. Clue cells are vaginal epithelial cells studded with adherent bacteria, giving them a stippled or granular appearance with obscured cell borders. They’re pathognomonic for BV.
Why BV matters beyond symptoms: BV is associated with significant complications: preterm delivery, increased susceptibility to STIs including HIV, and post-procedural infections following gynecologic surgery. Treatment with metronidazole or clindamycin clears symptoms, but recurrence is common-the fundamental dysbiosis tends to return.
Chapter 47: Fungi
47.1 Fungal Classification and Principles
Fungi are eukaryotes that occupy a kingdom distinct from bacteria, plants, and animals. This matters clinically because their eukaryotic cell biology makes them harder to treat than bacteria-their cellular machinery is similar to ours, limiting selective toxicity. Antifungal therapy must exploit the differences that do exist: the fungal cell membrane contains ergosterol (not cholesterol), and the cell wall contains unique components like β-glucan and chitin.
The fundamental morphologic division separates yeasts and molds. Yeasts are unicellular and reproduce by budding-a daughter cell pinches off from the mother cell. Molds are multicellular, composed of tubular filaments called hyphae that branch and interweave to form a mycelium. Some fungi exist as either form depending on conditions-these dimorphic fungi grow as molds in the environment (at 25°C) and convert to yeasts in tissue (at 37°C). This “mold in the cold, yeast in the heat” pattern is key to understanding the endemic mycoses.
Hyphal morphology provides diagnostic clues: Septate hyphae have cross-walls (septa) dividing them into compartments; Aspergillus is the classic example. Non-septate (or pauciseptate) hyphae lack frequent cross-walls and appear as broad, ribbon-like tubes; the Mucormycetes show this pattern. The angle of hyphal branching also helps-Aspergillus branches at 45° acute angles, while Mucormycetes branch at 90° right angles.
Conidia are asexual spores that allow environmental dispersal. When you inhale fungal spores (conidia) from Aspergillus, Histoplasma, or Coccidioides, you’re inhaling the infectious propagules that initiate disease.
47.2 Yeasts
Candida Species
Candida is the most important fungal pathogen in clinical medicine. Species of Candida are the fourth leading cause of healthcare-associated bloodstream infections and the most common cause of invasive fungal disease worldwide. The genus includes a handful of clinically important species, and knowing their differences matters for treatment.
The ecology of Candida shapes its pathogenesis: Candida species colonize human mucosal surfaces-mouth, gut, and vagina-as commensals. Disease occurs when local or systemic immunity is compromised, or when mucosal barriers are breached. Antibiotics that eliminate competing bacterial flora allow Candida overgrowth. Central venous catheters breach the skin barrier. Neutropenia removes a critical defense.
Species matter because susceptibility varies: C. albicans remains the most common species, accounting for about half of candidiasis. It’s reliably susceptible to fluconazole. But non-albicans species are increasingly recognized, and their resistance profiles differ.
C. glabrata is now the second most common species in many centers. It frequently demonstrates fluconazole resistance and reduced susceptibility to other azoles, making echinocandins the preferred treatment.
C. parapsilosis has a predilection for catheter-related infections and parenteral nutrition-biofilm formation on plastic surfaces is key to its pathogenicity. Interestingly, echinocandins have somewhat reduced activity against C. parapsilosis, so fluconazole is often preferred when susceptibility permits.
C. krusei is intrinsically resistant to fluconazole-this species is selected for when patients receive fluconazole prophylaxis. Echinocandins or amphotericin are required.
C. auris has emerged as a major public health threat. This species is often multidrug-resistant (including to echinocandins), difficult to identify by conventional methods (frequently misidentified as other species), and remarkably persistent in healthcare environments, causing nosocomial outbreaks. CDC considers it an urgent resistance threat.
Laboratory identification: The germ tube test has historically been used to rapidly identify C. albicans-when incubated in serum at 37°C, C. albicans produces short hyphal projections (germ tubes) within 2-3 hours. CHROMagar produces different colored colonies for different species based on chromogenic substrates. MALDI-TOF MS is now the standard for definitive identification.
The clinical spectrum ranges from mucosal to invasive: Mucosal candidiasis includes oral thrush (white plaques on erythematous mucosa), esophageal candidiasis (odynophagia, usually in AIDS or other immunocompromised states), and vulvovaginal candidiasis (the common “yeast infection”). These represent overgrowth on colonized surfaces.
Invasive candidiasis includes candidemia (bloodstream infection) and deep tissue involvement (endophthalmitis, endocarditis, hepatosplenic candidiasis). Risk factors include central venous catheters, abdominal surgery, total parenteral nutrition, broad-spectrum antibiotics, and neutropenia. Invasive disease carries significant mortality.
Treatment depends on disease and species: Mucosal disease typically responds to topical or oral azoles. Invasive candidiasis requires systemic therapy-echinocandins (caspofungin, micafungin, anidulafungin) are first-line because of their fungicidal activity and broad coverage of Candida species. Source control (catheter removal) is essential. Fluconazole can be used for step-down therapy once speciation confirms susceptibility.
Cryptococcus neoformans
Cryptococcus neoformans is the most important cause of fungal meningitis, particularly in patients with AIDS. Its thick polysaccharide capsule is both its defining feature and its major virulence factor.
Ecology and transmission: Cryptococcus lives in the environment, particularly in soil contaminated with pigeon droppings. Infection occurs through inhalation of yeast cells or spores. In immunocompetent people, the infection is usually controlled in the lungs and may be asymptomatic. In patients with severe T-cell immunodeficiency-especially AIDS with CD4 counts below 100-the organism disseminates to the central nervous system, where it has a particular tropism for the meninges.
The capsule as virulence factor: The polysaccharide capsule is critical to pathogenesis. It’s antiphagocytic-too large and slippery for macrophages to engulf. It also interferes with antigen presentation and complement activation. The capsule can be visualized directly using India ink, which is excluded by the capsule, creating a clear halo around the yeast cell.
Clinical presentation of cryptococcal meningitis: Unlike bacterial meningitis, which presents acutely over hours, cryptococcal meningitis is subacute-developing over days to weeks. Patients have headache, fever, and altered mental status. Neck stiffness may be subtle or absent. The diagnosis is often delayed because the presentation is indolent.
A characteristic and dangerous feature is elevated intracranial pressure. The polysaccharide capsule material clogs the arachnoid granulations, impairing CSF absorption. Patients may present with papilledema, cranial nerve palsies, or obtundation from high pressure. Serial lumbar punctures or CSF shunting may be needed to manage pressure.
Diagnosis: The cryptococcal antigen (CrAg) test has transformed diagnosis-it’s highly sensitive and specific, available as a rapid lateral flow assay, and can be performed on serum or CSF. India ink examination of CSF is less sensitive (positive in 50-75% of AIDS patients) but provides rapid confirmation when positive. CSF typically shows lymphocytic pleocytosis, elevated protein, and low glucose, but findings may be minimal in severely immunocompromised patients. Culture grows on routine media-the mucoid colonies and urease positivity help identify the organism.
Treatment: Cryptococcal meningitis requires prolonged, staged therapy. Induction with amphotericin B plus flucytosine rapidly kills organisms. Consolidation with fluconazole follows. In AIDS patients, maintenance therapy continues until immune reconstitution occurs with antiretroviral therapy.
Pneumocystis jirovecii
Pneumocystis jirovecii (formerly P. carinii-the species name changed when it was recognized that the organism infecting humans is distinct from the one in rats) causes Pneumocystis pneumonia (PCP), historically the most common AIDS-defining illness. Despite being classified as a fungus based on molecular analysis, it behaves very differently from other fungi and cannot be cultured.
A unique organism: Pneumocystis was long classified as a protozoan based on its morphology and response to antiprotozoal drugs. Molecular studies revealed it’s actually a fungus, but an unusual one. Its cell wall contains β-D-glucan (a fungal marker) but lacks ergosterol, which is why azole antifungals don’t work. It exists in two forms: trophic forms (small, thin-walled) and cysts (thick-walled, containing up to 8 intracystic bodies). It has never been cultured in vitro, which hampers research and diagnosis.
Who gets PCP: The organism is ubiquitous-most people are exposed by age 2-4, evidenced by seroconversion. In immunocompetent people, the infection is controlled. PCP occurs in severe T-cell immunodeficiency: AIDS patients with CD4 counts below 200, transplant recipients on immunosuppression, patients on high-dose corticosteroids, and those with hematologic malignancies.
Clinical presentation: PCP presents subacutely over days to weeks with progressive dyspnea, dry cough, and fever. The hypoxemia is often out of proportion to examination and chest X-ray findings-the patient looks and sounds okay but has an oxygen saturation of 80%. The classic chest X-ray shows bilateral interstitial infiltrates with a “ground glass” appearance, though early disease may show minimal changes and advanced disease may show consolidation. LDH is elevated, though nonspecifically.
Diagnosis: Because Pneumocystis can’t be cultured, diagnosis requires visualizing the organism in respiratory specimens. Induced sputum is the first-line approach; if negative, bronchoalveolar lavage (BAL) is more sensitive. Stains include GMS (methenamine silver, which stains cyst walls) and DFA (immunofluorescence). PCR is highly sensitive but may detect colonization rather than disease.
β-D-glucan is a useful adjunct-it’s elevated in PCP because the cyst walls contain this component. It’s sensitive but not specific (other fungi also produce β-D-glucan).
Treatment and prophylaxis: TMP-SMX is the drug of choice for both treatment and prophylaxis. For moderate-to-severe disease (PaO2 <70 or A-a gradient >35), adjunctive corticosteroids reduce mortality by dampening the inflammatory response as organisms die. Prophylaxis is indicated when CD4 drops below 200 in AIDS patients, and in other immunocompromised patients at high risk. Alternatives for sulfa-allergic patients include dapsone, atovaquone, and pentamidine.
47.3 Molds
Molds are filamentous fungi composed of branching hyphae. The two most important molds in clinical practice are Aspergillus and the Mucormycetes. Distinguishing them is critical because they require different treatments.
Aspergillus
Aspergillus species are ubiquitous environmental molds-we all inhale Aspergillus spores daily. In immunocompetent people, innate immunity clears them. Disease occurs when host defenses are impaired or when structural lung abnormalities provide a niche for growth.
The spectrum of aspergillus disease: The clinical syndrome depends entirely on the host’s immune status.
In allergic individuals (asthmatics, cystic fibrosis patients), Aspergillus triggers allergic bronchopulmonary aspergillosis (ABPA)-an IgE-mediated hypersensitivity response. The organism isn’t invading; the immune response to colonization causes damage. Patients have worsening asthma, bronchiectasis, eosinophilia, and markedly elevated IgE.
In patients with pre-existing lung cavities (from TB, sarcoidosis, or other causes), Aspergillus can colonize the cavity and grow into an aspergilloma-a “fungus ball” of matted hyphae. The aspergilloma itself may cause no symptoms, but erosion into blood vessels can cause massive hemoptysis.
In profoundly immunocompromised patients-particularly those with prolonged neutropenia from chemotherapy or stem cell transplant-Aspergillus causes invasive aspergillosis. This is an aggressive, angioinvasive infection. The hyphae penetrate blood vessels, causing thrombosis, infarction, and tissue necrosis. Pulmonary involvement is most common (nodules with characteristic “halo sign” on CT-hemorrhage surrounding the nodule). From the lungs, it can disseminate to brain, skin, and other organs. Mortality is high despite treatment.
Histologic identification: Aspergillus hyphae are septate (cross-walls divide the hyphae into compartments) and branch at acute angles-typically 45°, producing a Y-shaped branching pattern sometimes called “dichotomous branching.” This distinguishes Aspergillus from Mucormycetes on histopathology.

Diagnosis: Culture and histopathology remain important. The galactomannan antigen test detects a cell wall component released by growing Aspergillus and is useful for diagnosis and monitoring in neutropenic patients. β-D-glucan is elevated but nonspecific.
Treatment: Voriconazole is first-line for invasive aspergillosis-it was shown to be superior to amphotericin B in clinical trials. Isavuconazole is an alternative. Reducing immunosuppression and recovery of neutrophil counts are essential.
Mucormycetes (Mucormycosis/Zygomycosis)
The Mucormycetes (Rhizopus, Mucor, Lichtheimia) cause mucormycosis-a devastating infection that occurs in specific clinical contexts and requires urgent recognition because treatment must include surgical debridement.
The host determines the risk: Mucormycosis occurs almost exclusively in patients with specific predisposing conditions. The classic association is diabetic ketoacidosis-the acidotic, hyperglycemic environment enhances fungal growth and impairs neutrophil function. Iron overload is another major risk factor because these fungi thrive on free iron; deferoxamine therapy (which chelates iron but makes it available to Mucormycetes) paradoxically increases risk. Neutropenia and stem cell transplantation are additional risk factors.
Rhinocerebral disease-the classic presentation: The most common form starts in the sinuses and spreads relentlessly. Patients present with facial pain, nasal congestion, and fever. The fungus invades blood vessels (angioinvasion), causing thrombosis, infarction, and tissue necrosis. The characteristic finding is a black eschar on the palate or nasal septum-necrotic tissue from vascular invasion. From the sinuses, infection extends into the orbit (causing proptosis, vision loss, ophthalmoplegia) and brain. The progression is rapid-days, not weeks.
Distinguishing from Aspergillus: Both cause angioinvasive disease in neutropenic patients. Histopathology distinguishes them: Mucormycetes have broad, ribbon-like hyphae with few or no septa (pauciseptate) and branch at wide angles (90°), while Aspergillus has narrow septate hyphae with 45° branching. The distinction matters for treatment-Mucormycetes are NOT susceptible to voriconazole. Galactomannan and β-D-glucan are both negative in mucormycosis (the cell wall composition differs), which can be a helpful diagnostic clue.
Treatment requires surgery: Antifungal therapy alone is often inadequate. Aggressive surgical debridement of necrotic tissue is essential-the devascularized tissue won’t deliver drug, and residual fungus will progress. Lipid formulations of amphotericin B are the antifungal of choice; posaconazole or isavuconazole are alternatives. Correction of underlying conditions (treating DKA, stopping deferoxamine, reducing immunosuppression) is critical.
Dermatophytes
The dermatophytes are a specialized group of fungi that have evolved to live on keratin-the structural protein of skin, hair, and nails. Three genera cause human disease: Trichophyton (infects skin, hair, and nails), Microsporum (skin and hair), and Epidermophyton (skin and nails only). These organisms are transmitted by direct contact with infected humans, animals, or fomites (like shower floors and combs).
The diseases are named by body site: All are called “tinea” (Latin for worm, reflecting the ring-like appearance) followed by the location. Tinea capitis (scalp) primarily affects children and can cause scarring alopecia if untreated. Tinea corporis (body) produces the classic “ringworm”-an expanding annular plaque with a raised, scaly, erythematous border and central clearing. Tinea cruris (groin, “jock itch”) affects the inner thighs. Tinea pedis (feet, “athlete’s foot”) causes interdigital maceration and scaling. Tinea unguium (nails, onychomycosis) produces thickened, discolored, dystrophic nails.
Diagnosis: The KOH preparation is the rapid diagnostic tool-scraping scales or nail debris onto a slide and adding potassium hydroxide dissolves keratin and allows visualization of fungal hyphae and arthroconidia under the microscope. Culture on Sabouraud dextrose agar identifies the species but takes weeks. Dermatophyte Test Medium (DTM) changes color when dermatophytes grow, providing a simpler identification method.
Treatment depends on location and extent: Tinea corporis, cruris, and pedis usually respond to topical antifungals (terbinafine, azoles). Tinea capitis and onychomycosis require oral therapy because topicals can’t penetrate hair follicles or nail matrix-oral terbinafine is first-line, with itraconazole as an alternative. Treatment of onychomycosis requires 3 months for fingernails, 4-6 months for toenails.
Malassezia furfur
Malassezia is a lipophilic yeast that’s part of normal human skin flora-it lives on sebaceous areas like the scalp, face, and trunk, obtaining nutrients from skin lipids. Although it’s a commensal, Malassezia can cause superficial skin disease and, in specific circumstances, systemic infection.
Tinea versicolor (pityriasis versicolor) is the characteristic Malassezia infection. It presents as scaly patches on the trunk that may be hypopigmented (in darker skin) or hyperpigmented (in lighter skin). The pigmentation changes result from the organism’s interference with melanocyte function. Lesions are most apparent after sun exposure, when surrounding skin tans and the lesions don’t. The diagnostic feature on KOH prep is the “spaghetti and meatballs” appearance-short, curved hyphae (spaghetti) mixed with round yeast cells (meatballs).
Seborrheic dermatitis, ranging from mild dandruff to severe facial scaling, is associated with Malassezia, though the relationship is complex-the yeast triggers an inflammatory response in susceptible individuals. Malassezia folliculitis presents as uniform, pruritic papules and pustules on the trunk, often mistaken for acne. It’s exacerbated by humidity and sweating.
Systemic Malassezia infection is rare but occurs in neonates and adults receiving lipid-containing total parenteral nutrition through central catheters. Because Malassezia requires exogenous lipids for growth, the lipid infusion provides exactly what the organism needs. Catheter removal and discontinuing lipid infusion are essential; azoles are ineffective because Malassezia is inherently resistant.
Treatment of superficial disease: Selenium sulfide and ketoconazole shampoos are effective for tinea versicolor and seborrheic dermatitis. Extensive or recurrent disease may require oral antifungals.
47.4 Dimorphic Fungi
The dimorphic fungi are a distinct group that share a remarkable adaptation: they exist as molds in the environment but transform into yeasts (or yeast-like forms) at body temperature. This “mold in the cold, yeast in the heat” pattern explains their pathogenesis-you inhale mold spores from the environment, and they transform into yeast forms that evade host defenses.
Unlike the opportunistic fungi (Aspergillus, Candida, Cryptococcus), the dimorphic fungi are primary pathogens-they can cause disease in immunocompetent people. However, severe or disseminated disease is more common in the immunocompromised.
Each dimorphic fungus is endemic to a specific geographic region, defined by the environmental conditions where the mold form lives. Geographic history is therefore essential when considering these diagnoses.
Histoplasma capsulatum
Histoplasma is the most common endemic mycosis in the US. Understanding its ecology, pathogenesis, and the spectrum of disease it causes is essential.
Ecology and transmission: Histoplasma thrives in soil enriched with nitrogen from bird or bat droppings. The Ohio and Mississippi River valleys are the endemic region-caves with bat guano, old chicken coops, and areas under bird-roosting sites are high-risk. People become infected by inhaling microconidia (mold spores) during activities that disturb contaminated soil.
Pathogenesis explains the clinical syndrome: Inhaled spores convert to yeast in the lungs. These small yeasts (2-4 μm) are engulfed by alveolar macrophages but survive intracellularly-like Mycobacterium tuberculosis, Histoplasma is a facultative intracellular pathogen. The yeasts spread via lymphatics to hilar lymph nodes and can disseminate hematogenously to reticuloendothelial organs (liver, spleen, bone marrow, adrenals).
In immunocompetent people, cell-mediated immunity controls the infection within a few weeks, often leaving granulomas and calcified lymph nodes visible on chest imaging (the “histoplasmoma”). In the immunocompromised-especially AIDS patients with CD4 counts below 150-disseminated disease occurs.
Clinical syndromes:
Acute pulmonary histoplasmosis presents like a flu-like illness-fever, cough, chest pain, fatigue-that resolves spontaneously in most immunocompetent people. Heavy exposure (e.g., cleaning a chicken coop) can cause acute respiratory distress syndrome even in healthy people.
Chronic pulmonary histoplasmosis occurs in patients with underlying lung disease (COPD, emphysema). The presentation mimics tuberculosis-upper lobe cavitary disease with weight loss, cough, and hemoptysis.
Disseminated histoplasmosis in AIDS patients presents with fever, weight loss, hepatosplenomegaly, and pancytopenia (bone marrow involvement). Skin lesions, oral ulcers, and adrenal involvement (causing hypotension) are common.
Diagnosis: The Histoplasma antigen test (urine and serum) is highly sensitive for disseminated disease and useful for monitoring response to therapy. It cross-reacts with Blastomyces, limiting specificity. Histopathology shows the characteristic small intracellular yeasts within macrophages. Culture is definitive but takes weeks and requires BSL-3 precautions because the mold form is highly infectious.

Treatment: Itraconazole for mild to moderate disease. Amphotericin B for severe or disseminated disease, followed by itraconazole for maintenance.
Blastomyces dermatitidis
Blastomycosis is endemic to the same general region as histoplasmosis (Ohio/Mississippi River valleys, Great Lakes region, southeastern US), but the specific ecologic niche is different-moist soil near waterways.
The characteristic yeast: Blastomyces in tissue is distinctive-large (8-15 μm, much larger than Histoplasma), with a thick, refractile double-contoured cell wall and broad-based budding. The mother-daughter connection is as wide as the daughter cell is large, creating a “figure-8” appearance. This is pathognomonic and can be seen on wet mount of sputum or pus, or on histopathology.

Clinical syndromes: Unlike Histoplasma, Blastomyces commonly causes symptomatic disease even in immunocompetent hosts.
Pulmonary blastomycosis presents as pneumonia, but imaging can show masses that mimic lung cancer, or infiltrates that mimic tuberculosis or bacterial pneumonia. The diagnosis is often delayed because Blastomyces isn’t considered.
Cutaneous blastomycosis produces distinctive verrucous (warty) skin lesions with raised, irregular borders that can look like squamous cell carcinoma. Skin involvement usually represents dissemination from a pulmonary focus.
Other disseminated disease affects bone (osteomyelitis, often vertebral) and the genitourinary system (prostate, epididymis).
Diagnosis: The large, broad-based budding yeast is so distinctive that direct examination of clinical specimens (sputum, pus from skin lesions) can provide a rapid presumptive diagnosis. Antigen testing is available but cross-reacts with Histoplasma. Culture confirms.
Coccidioides immitis/posadasii
Coccidioidomycosis-“Valley fever”-is endemic to the desert Southwest (Arizona, California’s Central Valley, Nevada, Utah, New Mexico) and northern Mexico. The fungus lives in desert soil and is dispersed by wind, dust storms, and earthquakes.
A unique tissue form: Unlike the other dimorphic fungi, Coccidioides doesn’t form budding yeast in tissue. Instead, it forms spherules-large round structures (20-100 μm) filled with endospores. When mature, spherules rupture and release endospores, which each develop into new spherules. This is pathognomonic on histopathology.
Clinical spectrum: The majority (60%) of infections are asymptomatic or cause only mild flu-like illness. Of those who become symptomatic, most have acute pulmonary coccidioidomycosis-pneumonia often accompanied by erythema nodosum (painful red nodules on the shins) and arthralgias. This combination of pneumonia + erythema nodosum + arthralgias is called “Valley fever” and is virtually diagnostic in endemic areas.
Chronic pulmonary coccidioidomycosis presents as cavitary lung disease, similar to TB.
Disseminated disease occurs in a minority but is life-threatening. The meninges have particular tropism-coccidioidal meningitis presents as chronic basilar meningitis requiring lifelong suppressive therapy. Certain populations have higher dissemination risk: African Americans, Filipinos, pregnant women (especially third trimester), and immunocompromised patients.
Diagnosis: Serology is the primary diagnostic tool. IgM appears early; IgG correlates with disease burden and is useful for monitoring. Histopathology showing spherules with endospores is diagnostic. Culture requires BSL-3 precautions-the mold form produces highly infectious arthroconidia.
Treatment: Many patients with primary pulmonary disease don’t require antifungal treatment. Fluconazole is preferred for symptomatic disease. Severe disease requires amphotericin B. Coccidioidal meningitis requires lifelong fluconazole-it’s not curable, only suppressible.
Paracoccidioides brasiliensis
Endemic to South America (Brazil, Colombia, Venezuela). Causes paracoccidioidomycosis, the most common systemic mycosis in Latin America.
Characteristic morphology: Large yeast (10-60 μm) with multiple buds arranged around the mother cell-the “captain’s wheel” or “ship’s wheel” appearance. Pathognomonic.
Clinical syndromes: - Acute/subacute (juvenile) form: Disseminated disease with lymphadenopathy, hepatosplenomegaly; worse prognosis - Chronic (adult) form: Pulmonary disease with progression to “mulberry-like” oral/nasal ulcers; most common presentation
Treatment: Itraconazole for mild-moderate; amphotericin B for severe disease
Sporothrix schenckii
Sporotrichosis is different from the other endemic mycoses-it’s not acquired by inhalation but by traumatic inoculation. The organism lives on plants (especially sphagnum moss, rose thorns, hay) and in soil worldwide.
The classic presentation: A gardener or florist pricks their finger on a thorn. Days to weeks later, a papule appears at the inoculation site. Over the following weeks, new nodules appear along the lymphatic channels draining the area (sporotrichoid spread). This chain of nodules ascending the arm is classic for sporotrichosis.
Pulmonary sporotrichosis occurs when spores are inhaled, typically in alcoholics. Disseminated disease occurs in the immunocompromised.
Morphology: In tissue, Sporothrix appears as small, cigar-shaped yeasts. The “asteroid body”-a yeast surrounded by eosinophilic Splendore-Hoeppli material-is characteristic but not always present.
Treatment: Itraconazole is effective for cutaneous and lymphocutaneous disease. Amphotericin B for severe or disseminated cases.
Chapter 48: Parasitology
Parasitology covers protozoa (single-celled eukaryotes) and helminths (worms). These organisms have complex life cycles that explain their epidemiology, clinical presentations, and diagnostic approaches.
48.1 Protozoa
Blood and Tissue Protozoa
Plasmodium (Malaria)-the global killer
Malaria kills hundreds of thousands of people annually, primarily children in sub-Saharan Africa. Understanding the life cycle explains everything-the clinical features, the species differences, and why treatment is complex.
The life cycle drives the disease: An infected Anopheles mosquito injects sporozoites during a blood meal. Sporozoites travel to the liver, invade hepatocytes, and multiply (exoerythrocytic schizogony). After 1-2 weeks, the liver cells rupture, releasing thousands of merozoites into the bloodstream. Merozoites invade red blood cells, multiply (erythrocytic schizogony), rupture the cells, and invade new RBCs. This cycle repeats every 48 hours (P. falciparum, P. vivax, P. ovale) or 72 hours (P. malariae).
The synchronized rupture of infected RBCs causes the classic cyclic fever-every 2 days for tertian malaria (48-hour cycle), every 3 days for quartan malaria (72-hour cycle). In practice, periodicity is often obscured, especially in P. falciparum infection.
P. vivax and P. ovale have a twist: Some liver-stage parasites become dormant (hypnozoites) rather than immediately replicating. These can reactivate months to years later, causing relapses. Primaquine is the only drug that kills hypnozoites-it’s required for “radical cure” of P. vivax and P. ovale infections. Critically, primaquine causes hemolysis in G6PD-deficient patients, so G6PD testing is mandatory before treatment.
P. falciparum-why it kills: P. falciparum is the most dangerous species for several reasons:
It can infect RBCs of any age (other species are restricted to young or old RBCs), leading to higher parasitemia. Infected RBCs express surface proteins (PfEMP1) that bind to endothelium (sequestration), causing microvascular obstruction in brain (cerebral malaria), lungs (ARDS), and kidneys. This sequestration also means that peripheral blood parasitemia underestimates total body parasite burden-you may see only ring stages because mature forms are sequestered. Cerebral malaria (coma, seizures), severe anemia, hypoglycemia, lactic acidosis, and respiratory distress can all be fatal.
Microscopic diagnosis-the gold standard: Thick and thin blood smears examined by an experienced microscopist remain the diagnostic standard.
The thick smear concentrates parasites by lysing RBCs, increasing sensitivity-use it for detection and quantifying parasitemia. The thin smear preserves RBC morphology-use it for species identification.
Species-specific features: P. falciparum shows multiple rings per RBC, “appliqué” forms (parasites at edge of cell), banana-shaped gametocytes, and only rings in peripheral blood (mature stages sequestered). Infected RBCs are normal size. P. vivax shows enlarged RBCs with Schüffner’s dots (stippling) and large ameboid trophozoites. P. ovale shows enlarged, oval RBCs with fimbriated (ragged) edges. P. malariae shows “band form” trophozoites and rosette schizonts.

Rapid diagnostic tests (RDTs) detecting parasite antigens and PCR are useful adjuncts, but microscopy remains essential for quantifying parasitemia and monitoring treatment response.
Treatment principles: Artemisinin-combination therapy (ACT) is the global standard for uncomplicated malaria-artemisinins rapidly clear parasites, and the partner drug prevents resistance. Severe malaria requires IV artesunate, which is superior to quinine. Chloroquine-sensitive areas are increasingly rare. Remember primaquine for radical cure of P. vivax/ovale (after confirming G6PD status).
Babesia-malaria’s tick-borne mimic
Babesia microti is transmitted by the same tick (Ixodes scapularis) that transmits Lyme disease and anaplasmosis in the northeastern US. Like malaria parasites, Babesia infects red blood cells.
Clinical features and who’s at risk: In healthy people, babesiosis may be asymptomatic or cause a mild flu-like illness with fever and hemolytic anemia. In asplenic patients or the elderly, babesiosis can be severe or fatal-massive hemolysis, high-grade parasitemia, DIC, and multi-organ failure. The spleen is critical for clearing infected RBCs; without it, parasitemia spirals out of control.
Distinguishing from malaria microscopically: Babesia also appears as intraerythrocytic ring forms, and patients returning from endemic areas (both Babesia and malaria endemic areas exist) require careful differentiation. Key distinctions: Babesia produces no pigment (hemozoin)-malaria parasites produce brown-black pigment from hemoglobin digestion. The pathognomonic finding for Babesia is the “Maltese cross” or tetrad-four merozoites arranged in a cross pattern within a single RBC. Babesia also shows extracellular parasites (not seen in malaria).
Treatment: Atovaquone plus azithromycin for mild-moderate disease. Quinine plus clindamycin for severe disease. Exchange transfusion may be needed for high parasitemia (>10%).
Toxoplasma gondii
Toxoplasma is remarkable for causing three completely different clinical syndromes depending on the host’s immune status and the timing of infection.
The cat connection: Cats are the definitive host-Toxoplasma sexually reproduces only in the feline intestine, releasing oocysts in cat feces. Humans become infected by ingesting oocysts (from cat litter, contaminated soil, or unwashed produce) or tissue cysts (from undercooked meat, especially pork and lamb). Once infected, humans harbor tissue cysts for life, typically without symptoms.
Three faces of toxoplasmosis: In immunocompetent adults, primary infection is usually asymptomatic or causes mild, self-limited lymphadenopathy that may mimic mononucleosis. No treatment is needed.
In AIDS patients with CD4 counts below 100, reactivation of latent infection causes toxoplasmic encephalitis-the most common opportunistic CNS infection in AIDS. Patients present with focal neurological deficits, seizures, or altered mental status. Brain imaging shows multiple ring-enhancing lesions, typically in the basal ganglia. The major differential diagnosis is primary CNS lymphoma, which also causes ring-enhancing lesions in AIDS. Empiric treatment for toxoplasmosis with clinical and radiographic improvement helps distinguish the two.
In pregnancy, primary maternal infection can cross the placenta and cause congenital toxoplasmosis. The classic triad is chorioretinitis, hydrocephalus, and intracranial calcifications, but outcomes vary based on gestational age at infection. First-trimester infection is more likely to cause severe disease; third-trimester infection is more likely to be transmitted but causes milder disease.
Diagnosis: Serology is the mainstay for immunocompetent patients-IgG indicates exposure (which most adults have), while IgM suggests recent infection. In AIDS patients with encephalitis, positive IgG plus compatible imaging is presumptive; PCR of CSF confirms but is insensitive. In pregnancy, amniocentesis with PCR can detect fetal infection.
Treatment: The combination of pyrimethamine plus sulfadiazine targets folic acid synthesis in the parasite. Leucovorin (folinic acid) prevents pyrimethamine’s myelosuppressive effects on the host.
Trypanosoma brucei-African Sleeping Sickness
Two subspecies cause human disease: T. b. gambiense (West/Central Africa, chronic disease) and T. b. rhodesiense (East Africa, acute disease).
Transmission: Tsetse fly bite injects trypomastigotes (metacyclic form)
Pathogenesis: Trypanosomes evade immunity through antigenic variation-constantly changing their surface glycoprotein coat (VSG), staying ahead of the immune response.
Clinical stages: 1. Hemolymphatic stage: Chancre at bite site, fever, lymphadenopathy (Winterbottom’s sign = posterior cervical nodes) 2. Meningoencephalitic stage: CNS invasion → daytime somnolence, personality changes, eventually coma and death
Diagnosis: Trypomastigotes on blood smear; CSF exam determines stage (presence of trypanosomes and elevated WBC = stage 2)
Treatment varies by species and stage: - Stage 1 T.b. gambiense: Pentamidine - Stage 1 T.b. rhodesiense: Suramin - Stage 2 T.b. gambiense: NECT (nifurtimox-eflornithine combination) - Stage 2 T.b. rhodesiense: Melarsoprol (toxic, but only option)
Trypanosoma cruzi-Chagas Disease (American Trypanosomiasis)
Endemic in Latin America; increasingly recognized in US blood supply.
Transmission: Triatomine bug (“kissing bug”) defecates while feeding; parasites in feces enter through bite wound or mucous membranes. Also transmitted via blood transfusion, organ transplant, and congenitally.
Life cycle: Trypomastigotes in blood; amastigotes replicate intracellularly (in cardiac and GI smooth muscle)
Clinical phases: 1. Acute phase: Often in children; chagoma (indurated lesion) at entry site, Romaña sign (unilateral periorbital edema if conjunctival entry), fever, hepatosplenomegaly 2. Indeterminate phase: Asymptomatic, positive serology (10-30 years) 3. Chronic phase: Cardiomyopathy (dilated, arrhythmias, heart block, apical aneurysm) and megasyndromes (megaesophagus, megacolon from destruction of myenteric plexus)
Diagnosis: Acute-trypomastigotes on blood smear; Chronic-serology (parasitemia too low)
Treatment: Benznidazole or nifurtimox (most effective in acute phase); chronic cardiac disease is largely irreversible
Leishmania species-Sand Fly-Transmitted Disease
Transmitted by sandfly bite; parasites replicate as amastigotes within macrophages.
Clinical forms:
The clinical syndrome depends on the species. Visceral leishmaniasis (kala-azar), caused by L. donovani and L. infantum, is the most serious. Parasites disseminate to liver, spleen, and bone marrow. Patients develop fever, massive hepatosplenomegaly, and pancytopenia (from bone marrow infiltration). Hyperpigmentation of the skin gives the disease its Hindi name (kala-azar means “black fever”). Without treatment, visceral leishmaniasis is fatal.
Cutaneous leishmaniasis (Old World caused by L. tropica and L. major, New World by L. mexicana complex) remains localized to the skin. An ulcerating lesion develops at the sandfly bite site-typically a painless nodule that enlarges and ulcerates over weeks. Lesions eventually self-heal but leave disfiguring scars.
Mucocutaneous leishmaniasis, caused by L. braziliensis in the Americas, is the most disfiguring form. Months to years after an initial skin lesion heals, the parasite reactivates and causes destructive lesions of the nose, mouth, and pharynx, leading to facial disfigurement.
Diagnosis requires demonstrating the parasite. For visceral disease, bone marrow or splenic aspirates show amastigotes within macrophages. For cutaneous disease, skin biopsy or scraping from the lesion edge reveals amastigotes.
Treatment varies by syndrome. Visceral leishmaniasis requires systemic therapy-liposomal amphotericin B is now preferred. Cutaneous leishmaniasis may be treated locally or systemically depending on severity and species. Pentavalent antimonials (sodium stibogluconate) were long the mainstay but have significant toxicity.
Naegleria fowleri-Primary Amebic Meningoencephalitis
Naegleria fowleri is a free-living ameba that causes one of the most rapidly fatal infections known to medicine. Understanding the unusual route of infection explains how to suspect the diagnosis.
This organism lives in warm freshwater-lakes, ponds, hot springs, and inadequately chlorinated swimming pools or drinking water. During summer months when water warms, Naegleria thrives. Unlike other infections acquired from water, Naegleria doesn’t enter through ingestion-it enters through the nose.
When someone dives or swims in contaminated water, forceful entry of water into the nasal passages allows Naegleria trophozoites to contact the olfactory mucosa. The organism invades through the cribriform plate along the olfactory nerves and reaches the brain directly. This anatomic route explains why the infection causes rapid, destructive meningoencephalitis.
The clinical presentation is unmistakable once you think of it: a previously healthy young person (typically a child or young adult) swims in warm freshwater, then 1-9 days later develops severe headache, fever, nausea, and vomiting progressing rapidly to altered mental status, seizures, and death. The course from symptom onset to death is usually less than a week.
CSF shows purulent meningitis (neutrophilic pleocytosis, elevated protein, low glucose)-but motile amebae may be visible if fresh, warm CSF is examined immediately. This is the key to diagnosis: if Naegleria is suspected, warn the laboratory to examine CSF immediately before organisms die.
Treatment with amphotericin B plus miltefosine has led to rare survivals, but mortality exceeds 97% even with aggressive therapy. The lesson is prevention: avoid warm freshwater exposure, especially in late summer, and use nose clips if exposure is unavoidable.
Trichomonas vaginalis-The STI Protozoan
Trichomoniasis is the most common curable sexually transmitted infection worldwide, affecting an estimated 150 million people annually. Though not life-threatening, it causes significant morbidity and increases susceptibility to other STIs including HIV.
Trichomonas vaginalis is a flagellated protozoan that exists only as a trophozoite-there’s no cyst form. This means it can’t survive long outside the human body and requires direct sexual contact for transmission. The organism infects squamous epithelium of the genitourinary tract.
In women, trichomoniasis causes vaginitis with a characteristic frothy, yellow-green, malodorous vaginal discharge. The odor is often described as fishy. Vulvovaginal irritation, dysuria, and dyspareunia occur. On examination, the cervix may show punctate hemorrhages-the “strawberry cervix”-though this is seen in only about 2% of cases. Vaginal pH is elevated above 4.5.
In men, the infection is usually asymptomatic, though some develop urethritis with discharge. The asymptomatic male partner serves as a reservoir for reinfection if not treated simultaneously.
Diagnosis can be made by wet mount examination of vaginal secretions-the motile trophozoites have a characteristic jerky, “tumbling” motility from their flagella. However, wet mount sensitivity is only 60-70%. Nucleic acid amplification testing (NAAT) is much more sensitive and is now the preferred diagnostic method.
Treatment with metronidazole or tinidazole is highly effective. Both sexual partners must be treated simultaneously to prevent reinfection.
Intestinal Protozoa
Giardia lamblia-the backpacker’s nemesis
Giardia is the most common intestinal parasite in the US. Despite its simple biology-it attaches to the intestinal epithelium but doesn’t invade-it causes significant morbidity.
Transmission and epidemiology: Giardia is transmitted by the fecal-oral route, primarily through contaminated water. The cysts are remarkably hardy, surviving in cold water for months and resisting chlorination at standard concentrations. Mountain streams contaminated by beaver feces (hence “beaver fever” as well as “backpacker’s diarrhea”) are a classic source. Daycare centers (fecal-oral spread among children) are another common setting.
Pathogenesis without invasion: Giardia trophozoites attach to the brush border of the small intestine using a ventral sucking disk but don’t invade the epithelium. The mechanism of diarrhea is not fully understood but involves villous blunting and disaccharidase deficiency, leading to malabsorption.
Clinical presentation: After an incubation period of 1-2 weeks, patients develop watery, foul-smelling diarrhea, bloating, flatulence, and abdominal cramps. Steatorrhea (fatty stools) occurs from fat malabsorption. Unlike invasive diarrheas, there’s no fever or blood in the stool. Symptoms can persist for weeks and become chronic if untreated, causing weight loss and nutritional deficiencies.
Morphology: The trophozoite is unmistakable-pear-shaped with two nuclei giving it a face-like appearance (“owl eyes” or “monkey face”), four pairs of flagella, and a ventral sucking disk. Cysts are oval with four nuclei.
Diagnosis: Traditional stool O&P can identify cysts, but shedding is intermittent, requiring multiple samples. Giardia antigen tests (EIA, immunofluorescence) are more sensitive and now standard. PCR is available in multiplex panels.
Treatment: Metronidazole or tinidazole are highly effective.
Entamoeba histolytica-invasive amebiasis
Unlike Giardia, Entamoeba histolytica is a tissue-invasive pathogen that can cause severe disease.
The critical distinction from nonpathogenic amebae: E. histolytica is morphologically identical to E. dispar, which is 10 times more common and completely harmless. Microscopy cannot distinguish them-you must use antigen testing or PCR that specifically identifies E. histolytica. This distinction is critical because E. histolytica requires treatment while E. dispar does not.
Pathogenesis of invasion: E. histolytica trophozoites invade the colonic epithelium using a combination of contact-dependent killing (via amebapore protein) and proteolytic enzymes. The parasite literally eats its way into the colonic wall, creating characteristic flask-shaped ulcers with a narrow neck at the mucosa and wider base in the submucosa.
Clinical syndromes: Amebic colitis presents with bloody diarrhea (dysentery), abdominal pain, and tenesmus. Unlike bacterial dysentery, fever is often absent.
Amebic liver abscess occurs when trophozoites invade blood vessels and travel via the portal circulation to the liver. Patients present with right upper quadrant pain, fever, and hepatomegaly-sometimes without any preceding diarrhea. Imaging shows a liver abscess, typically in the right lobe. The classic description of the aspirated pus is “anchovy paste”-brown, odorless (because it’s sterile-no bacteria, just necrotic hepatocytes and some amebae).
Morphology: The key microscopic finding is trophozoites with ingested red blood cells-this indicates invasive disease and is essentially pathognomonic for E. histolytica. Cysts have four nuclei when mature.
Diagnosis: Stool antigen testing or PCR specifically for E. histolytica (not just “E. histolytica/dispar complex”). Serology is positive in >90% of liver abscess cases. Microscopy showing trophozoites with ingested RBCs is diagnostic but insensitive.
Treatment requires two drugs: Metronidazole kills tissue trophozoites but doesn’t reliably eliminate cysts in the gut lumen. Follow metronidazole with a luminal agent (paromomycin or iodoquinol) to eliminate the intestinal reservoir and prevent relapse or transmission.
Cryptosporidium-the small spore with big consequences
Cryptosporidium is important because of its severity in AIDS patients and its resistance to chlorine disinfection.
A unique apicomplexan: Cryptosporidium completes its entire life cycle on the surface of intestinal epithelial cells. The oocysts are small (4-6 μm), immediately infectious when shed (no environmental maturation needed), and resistant to chlorine at standard water treatment levels. Outbreaks have occurred from contaminated municipal water supplies.
Disease depends on immune status: In immunocompetent people, Cryptosporidium causes self-limited watery diarrhea lasting 1-2 weeks. In AIDS patients with CD4 counts below 100, the infection is devastating-profuse, cholera-like watery diarrhea (liters per day) that becomes chronic and causes wasting, dehydration, and death. The organism can also infect the biliary tract, causing cholangitis.
Diagnosis: The oocysts are small but can be identified on modified acid-fast stain of stool-they appear as small (4-5 μm) red spheres against a blue-green background. This staining property distinguishes Cryptosporidium from other organisms. Antigen detection and PCR are more sensitive.
Treatment limitations: Nitazoxanide is modestly effective in immunocompetent patients but doesn’t work well in AIDS. The only effective treatment for AIDS-related cryptosporidiosis is immune reconstitution with antiretroviral therapy-raising the CD4 count allows the patient to clear the infection.
48.2 Helminths
Helminths are multicellular parasitic worms-much more complex than protozoa, with sophisticated life cycles often involving multiple hosts. Understanding these life cycles explains the clinical presentations, geographic distributions, and diagnostic approaches.
Nematodes (Roundworms)
Nematodes are round, unsegmented worms. They can be divided into those that primarily infect the intestine and those that primarily infect tissues.
Ascaris lumbricoides-the giant roundworm: Ascaris is the largest intestinal nematode, with adult worms reaching 15-35 cm. It infects over a billion people worldwide, primarily in areas with poor sanitation.
The life cycle explains the clinical syndromes. Eggs are ingested from contaminated soil or produce. Larvae hatch in the intestine, penetrate the intestinal wall, migrate through the liver to the lungs, are coughed up and swallowed, and mature to adults in the small intestine. This pulmonary migration causes Löffler syndrome-transient pulmonary infiltrates with peripheral eosinophilia, occurring 1-2 weeks after infection when larvae are in the lungs.
In heavy infections, adult worms can cause intestinal obstruction (a mass of tangled worms), biliary obstruction (worms migrating into the bile duct), or pancreatitis (worms migrating into the pancreatic duct). Diagnosis is straightforward: the characteristic eggs are visible on stool examination, and sometimes patients pass adult worms.
Enterobius vermicularis-pinworm: Pinworm is the most common helminth in the US, primarily affecting children. The key feature is its life cycle: adult females migrate out of the anus at night to deposit eggs on the perianal skin. This causes intense perianal itching, and scratching deposits eggs under fingernails, allowing auto-infection and transmission.
Because eggs are deposited outside the intestine, standard stool O&P often misses the diagnosis. The Scotch tape test-pressing clear tape to the perianal area in the morning before bathing, then examining microscopically-is the diagnostic method of choice.
Hookworm (Necator americanus, Ancylostoma duodenale)-the cause of anemia: Hookworm infection was once endemic in the rural American South. The larvae live in soil and actively penetrate skin (usually bare feet). They migrate to the lungs, are coughed up and swallowed, and attach to the intestinal mucosa.
The critical point is that hookworms feed on blood. They attach to the intestinal wall and ingest blood continuously. In heavy infections, the blood loss causes iron deficiency anemia-the major clinical manifestation. In endemic areas, hookworm is a leading cause of iron deficiency.
Strongyloides stercoralis-the hyperinfection threat: Strongyloides is unique among helminths because it can complete its entire life cycle within a single human host (autoinfection). Larvae in the intestine can penetrate the intestinal wall or perianal skin and re-infect the host without ever leaving the body. In immunocompetent people, this autoinfection is kept in check.
The danger comes with immunosuppression, particularly corticosteroid therapy. Autoinfection accelerates uncontrollably, producing hyperinfection syndrome-millions of larvae disseminating throughout the body, penetrating the gut wall and carrying intestinal bacteria into the bloodstream. Patients develop gram-negative sepsis and meningitis, respiratory failure, and multi-organ failure. Mortality exceeds 70%.
This is why screening for Strongyloides before starting corticosteroids is essential in anyone from an endemic area. Diagnosis is challenging because larvae (not eggs) are shed intermittently in stool. Serology is more sensitive.
Trichinella spiralis-from undercooked pork: Trichinella is acquired by eating undercooked meat containing encysted larvae (classically pork, but also wild game). Larvae are released in the stomach, mature in the intestine, and produce larvae that migrate through blood to striated muscle, where they encyst.
The clinical syndrome reflects this migration: initial gastrointestinal symptoms, then muscle pain (as larvae invade muscle), periorbital edema (larvae have tropism for extraocular muscles), and eosinophilia. Diagnosis is by serology; muscle biopsy shows encysted larvae.
Tissue Nematodes
Unlike the intestinal nematodes, tissue nematodes complete their development in tissues other than the GI tract. These filarial worms are transmitted by arthropod vectors, and their adult worms live for years in various tissue compartments-lymphatics, subcutaneous tissue, or the eye. Disease manifestations result from both the worms themselves and the host’s inflammatory response.
Onchocerca volvulus-River Blindness
Onchocerciasis is a leading infectious cause of blindness, affecting millions in sub-Saharan Africa and parts of Central and South America. The name “river blindness” reflects the ecology: the blackfly vector (Simulium) breeds in fast-flowing rivers, and villages near these waterways have the highest rates of blindness.
The life cycle explains the geography and pathology: Blackflies deposit larvae when they bite. The larvae mature into adult worms that live in subcutaneous nodules, where they can survive for over a decade. The adults produce millions of microfilariae (larval offspring) that migrate through the skin and, critically, into the eyes.
Skin disease (onchodermatitis) results from the inflammatory response to microfilariae. Patients experience intense itching-so severe it can be debilitating. Chronic inflammation leads to skin changes: thickening, depigmentation (“leopard skin”), and premature aging (“sowda”). The skin may feel like sandpaper from the chronic scratching.
Blindness develops when microfilariae invade the cornea and other ocular structures. Dead microfilariae trigger inflammation that damages the cornea (sclerosing keratitis), iris, and retina. The blindness is irreversible.
Diagnosis relies on identifying microfilariae in skin snips-small biopsies incubated in saline, which allows the microfilariae to emerge and be visualized microscopically.
Treatment with ivermectin kills microfilariae and is given repeatedly over years to reduce the microfilarial burden. Ivermectin doesn’t kill adult worms, which continue producing microfilariae-hence the need for repeated treatment. Mass drug administration programs have dramatically reduced onchocerciasis in endemic regions.
Wuchereria bancrofti-Lymphatic Filariasis (Elephantiasis)
Wuchereria bancrofti causes lymphatic filariasis, a disfiguring disease affecting over 100 million people in tropical regions. The clinical hallmark-elephantiasis-results from years of lymphatic damage.
The lymphatic connection: Adult worms live in lymphatic vessels, where they cause inflammation, fibrosis, and obstruction. The lymphatic system normally drains interstitial fluid; when it’s obstructed, fluid accumulates, causing lymphedema. Over years of repeated infection and inflammation, the edema becomes permanent, and the affected limbs (or genitals, particularly the scrotum) become massively enlarged, with thickened, hardened skin resembling elephant hide.
Acute episodes of lymphangitis and lymphadenitis punctuate the chronic course, often triggered by bacterial superinfection of the damaged lymphatics.
A diagnostic quirk-nocturnal periodicity: Microfilariae of W. bancrofti circulate in peripheral blood primarily at night, matching the feeding habits of the mosquito vector. Blood samples for diagnosis must be collected at night (around midnight) to maximize sensitivity.
Treatment and prevention: Diethylcarbamazine kills both adult worms and microfilariae. Mass drug administration programs combining ivermectin, albendazole, and DEC are interrupting transmission in endemic areas. For established elephantiasis, treatment focuses on preventing progression through hygiene, exercise, and control of secondary infections.
Loa loa-The African Eye Worm
Loa loa is found in the rainforests of Central and West Africa. It’s the only filarial infection where you might actually see the worm-adult worms sometimes migrate across the conjunctiva, creating the alarming but diagnostic finding of a worm visible in the eye.
Clinical features reflect the adults’ wandering lifestyle. The worms migrate through subcutaneous tissues, causing localized areas of angioedema called Calabar swellings. These swellings appear suddenly, last days to weeks, then resolve-only to appear elsewhere as the worm moves on.
Diurnal periodicity: Unlike W. bancrofti, Loa loa microfilariae circulate during the day, matching the day-biting habits of the deer fly vector. Blood samples should be collected during daytime hours.
Treatment caution: Patients with high microfilarial loads treated with DEC or ivermectin can develop fatal encephalopathy from massive microfilarial death. Microfilarial counts must be checked before treatment.
Dracunculus medinensis-The Guinea Worm
Guinea worm disease is on the verge of eradication-a remarkable public health achievement accomplished without vaccines or drugs, purely through behavior change and water treatment.
The life cycle is elegant and horrifying: Humans become infected by drinking water containing copepods (tiny crustaceans) harboring Dracunculus larvae. The larvae mature over a year into adult worms-females can reach 1 meter in length. When ready to release larvae, the female migrates to the skin, usually on the leg or foot, and creates an intensely painful blister. When the person seeks relief by immersing the affected limb in water, the worm emerges and releases thousands of larvae, completing the cycle.
Traditional treatment involves slowly winding the emerging worm around a stick, a few centimeters per day over several weeks. Pulling too quickly breaks the worm, causing severe inflammation and bacterial superinfection. This ancient treatment method may be the origin of the caduceus, the serpent-entwined rod symbolizing medicine.
Eradication efforts have reduced cases from millions annually to fewer than 20 by 2020. The strategy is simple: filter drinking water through cloth to remove copepods. Community education and provision of filter cloths has accomplished what no pharmaceutical intervention could.
Toxocara canis/cati-Visceral and Ocular Larva Migrans
Toxocara are roundworms of dogs (T. canis) and cats (T. cati). In their natural hosts, they complete a normal intestinal nematode life cycle. In humans-accidental hosts-the larvae cannot complete development. Instead, they wander through tissues, unable to reach the intestine, causing damage wherever they go.
How infection occurs: Dogs and cats pass Toxocara eggs in their feces. Eggs mature in soil and can remain infectious for years. Children playing in sandboxes or yards contaminated by pet feces ingest eggs from dirty hands. The eggs hatch, and larvae penetrate the intestinal wall, but instead of migrating to the lungs and back to the intestine (as they would in dogs), they wander aimlessly through tissues.
Visceral larva migrans occurs when larvae migrate through the liver, lungs, and other organs. Young children present with fever, hepatomegaly, pulmonary infiltrates, and-characteristically-extreme eosinophilia. The eosinophilia is often the first clue to diagnosis.
Ocular larva migrans occurs when a larva lodges in the eye. Older children typically present with unilateral visual loss. The inflammatory mass created by the larva can mimic retinoblastoma, and many eyes have been enucleated unnecessarily before the parasitic etiology was recognized. Whenever a child presents with a unilateral retinal mass, Toxocara serology should be checked before assuming malignancy.
Cestodes (Tapeworms)
Tapeworms are flat, segmented worms. Adults live in the intestine, absorbing nutrients through their body wall. Understanding the difference between infection with the adult worm versus infection with the larval stage is critical.
Taenia solium-the pork tapeworm with two faces: Taenia solium causes two completely different diseases depending on what life stage you ingest.
Eating undercooked pork containing cysticerci (larval cysts) leads to intestinal infection with the adult tapeworm-a benign condition causing minimal symptoms. The adult worm lives in the intestine, and you pass eggs in your stool.
Eating eggs (from contaminated food or hands, or through auto-infection) is dangerous. The eggs hatch, and larvae penetrate the intestinal wall and migrate throughout the body, encysting in tissues-the same thing that happens in pigs. In humans, cysts in the brain (neurocysticercosis) cause seizures, the most common parasitic cause of seizures worldwide. Imaging shows ring-enhancing lesions (live cysts) or calcifications (dead cysts).
Taenia saginata-the beef tapeworm: Unlike T. solium, T. saginata does not cause cysticercosis in humans. Eating undercooked beef containing cysticerci causes only intestinal tapeworm infection.
Diphyllobothrium latum-the fish tapeworm: This tapeworm, acquired from raw freshwater fish, is enormous-up to 10 meters. Its unique clinical feature is vitamin B12 deficiency. The worm has high affinity for B12 and absorbs it from the host’s intestine, competing with the host. Megaloblastic anemia results.
Echinococcus granulosus-hydatid disease: Humans are accidental intermediate hosts in a cycle that normally involves dogs (definitive host) and sheep (intermediate host). Ingesting eggs from dog feces leads to larval cysts (hydatid cysts) in liver or lung.
These cysts can grow large and cause problems by mass effect. The critical management point: do not aspirate without proper precautions. Cyst fluid contains protoscolices and is highly antigenic. Rupture can cause anaphylaxis and dissemination of daughter cysts.
Trematodes (Flukes)
Flukes are flat, leaf-shaped worms. All require snail intermediate hosts, which explains their geographic distribution (where the appropriate snails exist).
Schistosoma-blood flukes with different addresses: Schistosoma species are unique among flukes because adults live in blood vessels, not the GI tract. The location of adult worms determines the clinical syndrome.
Infection occurs when cercariae (larvae released by snails) penetrate skin during freshwater exposure. Adults migrate to specific vascular beds depending on species:
S. mansoni and S. japonicum adults live in mesenteric veins. Eggs deposited in the intestinal wall pass into stool-but eggs that don’t escape get swept to the liver via portal circulation. Accumulated eggs cause granulomatous inflammation and eventually periportal fibrosis (pipestem fibrosis), leading to portal hypertension with splenomegaly and esophageal varices.
S. haematobium adults live in vesical veins around the bladder. Eggs deposited in the bladder wall cause hematuria (often the presenting symptom) and chronic inflammation. Critically, chronic S. haematobium infection causes squamous cell carcinoma of the bladder-a major cause of bladder cancer in endemic areas (Egypt, sub-Saharan Africa).
Liver flukes and cancer risk: Clonorchis sinensis and Opisthorchis species are acquired from eating raw freshwater fish. Adults live in bile ducts and cause chronic inflammation. The major concern is that chronic infection significantly increases the risk of cholangiocarcinoma.
Diagnosis and treatment: Stool examination reveals characteristic eggs for intestinal flukes; urine examination for S. haematobium. Praziquantel is effective against all flukes and cestodes.
48.3 Ectoparasites
Ectoparasites live on or in the skin surface rather than inside the body. They cause disease directly through their feeding and burrowing activities, and indirectly by serving as vectors for other pathogens. Though often considered nuisances rather than serious medical conditions, ectoparasites cause substantial morbidity and, in the case of body lice, can transmit life-threatening infections.
Sarcoptes scabiei (Scabies)
Scabies is caused by a mite so small it’s nearly invisible to the naked eye, yet an infestation produces intense, maddening itch that’s among the most distressing symptoms in medicine. The condition has afflicted humans throughout recorded history and remains common worldwide.
The mite’s lifestyle creates the symptoms: The female Sarcoptes scabiei mite burrows into the stratum corneum (the outermost layer of skin), creating tunnels where she lays eggs. The mites themselves, their eggs, and their fecal pellets (scybala) are all highly antigenic. After initial infestation, it takes 4-6 weeks for sensitization to develop-this is why first-time infestations often aren’t itchy until weeks after exposure. With re-infestation, the immune system reacts immediately.
The itch is predominantly allergic, which explains several features: itching is worst at night (when the skin is warm and mites are most active), it’s out of proportion to the number of mites (a typical infestation involves only 10-15 mites), and it persists for weeks after successful treatment (until the antigenic material clears).
Distribution provides diagnostic clues: Mites prefer thin skin-the interdigital web spaces of the fingers, the wrists, the elbows, the axillae, the waistline, and the genitalia. In adults, the head and neck are typically spared (except in infants and immunocompromised patients). Finding linear burrows or papules in these characteristic locations should prompt consideration of scabies.
Crusted (Norwegian) scabies is a hyperinfestation occurring in immunocompromised patients or those unable to scratch (due to paralysis or dementia). Instead of a dozen mites, these patients harbor millions. The clinical picture is dramatically different: thick, crusted, hyperkeratotic plaques rather than subtle papules and burrows. Crusted scabies is extraordinarily contagious and has caused hospital and nursing home outbreaks.
Diagnosis is confirmed by skin scraping: mineral oil is applied to a burrow or papule, the area is scraped with a blade, and the material is examined microscopically for mites, eggs, or fecal pellets. In practice, scabies is often diagnosed clinically and treated empirically.
Treatment: Permethrin 5% cream applied from neck to toes, left on overnight, is first-line. All household members and close contacts must be treated simultaneously, and bedding and clothing should be washed in hot water. Oral ivermectin is an alternative, particularly useful for crusted scabies and institutional outbreaks. The itch may persist for weeks after successful treatment due to ongoing allergic response to dead mites and debris.
Lice (Pediculosis)
Three species of lice infest humans, each adapted to a specific body region. They’re obligate human parasites-they can’t survive long away from the human body, and they don’t infest other animals.
Pediculus humanus capitis (head louse) infests the scalp, primarily affecting school-age children. The lice live on the scalp, feeding on blood multiple times daily. Females cement their eggs (nits) to hair shafts near the scalp. Nits appear as tiny white or yellow-brown specks firmly attached to hairs-they can’t be brushed off like dandruff. Itching and secondary bacterial infection from scratching are the main symptoms. Though common and distressing to parents, head lice don’t transmit disease.
Pediculus humanus corporis (body louse) lives in clothing, visiting the skin only to feed. Unlike head lice, body lice are medically significant vectors, transmitting epidemic typhus (Rickettsia prowazekii), trench fever (Bartonella quintana), and relapsing fever (Borrelia recurrentis). Body louse infestation is associated with poverty, homelessness, and conditions where people can’t change or wash clothing-refugee camps, wars, and disasters. Control requires not just treatment of the person but washing or discarding infested clothing.
Phthirus pubis (pubic louse, “crabs”) infests coarse hair, primarily pubic hair but also eyelashes, eyebrows, and axillary hair. It’s transmitted through sexual contact and is considered an STI. The broad, crab-shaped body is distinctive under magnification.
Treatment for all lice involves topical pediculicides (permethrin, pyrethrins, or malathion) and mechanical removal of nits with a fine-toothed comb. Resistance to permethrin is increasing, making alternatives like ivermectin increasingly important. Close contacts must be treated, and attention to fomites (hats, combs, bedding) helps prevent reinfestation.
Chapter 49: Virology
Viruses are obligate intracellular parasites-they can’t replicate on their own and must commandeer host cell machinery. Understanding viral biology helps you understand disease patterns and treatment options.
49.1 DNA Viruses
Herpesviruses: Latency Defines the Family
The herpesviruses share a defining characteristic: after primary infection, they establish lifelong latent infection. The virus persists in specific cell types, reactivating periodically to cause recurrent disease. There are eight human herpesviruses, and understanding where each hides and what it does when it awakens is the key to mastering this family.
HSV-1 and HSV-2 both cause vesicular lesions, but HSV-1 classically affects the orolabial area while HSV-2 classically affects the genital area (though either can infect either site). After primary infection, the viruses travel up sensory nerves and establish latency in ganglia-trigeminal ganglia for oral infection, sacral ganglia for genital infection. Reactivation produces the recurrent “cold sores” or genital outbreaks patients experience for life. HSV-1 also causes herpes keratitis (corneal infection that can lead to blindness) and is the most common cause of sporadic encephalitis in adults-a devastating infection that is treatable if recognized and treated promptly with IV acyclovir.
Varicella-zoster virus (VZV) causes chickenpox (varicella) in primary infection-a generalized vesicular rash that appears in crops. The virus then establishes latency in dorsal root ganglia throughout the spine. Decades later, reactivation produces shingles (zoster)-a painful vesicular rash in a dermatomal distribution, limited to the distribution of one sensory nerve. Post-herpetic neuralgia-chronic pain persisting after the rash heals-is a common and debilitating complication.
Epstein-Barr virus (EBV) infects B lymphocytes and causes infectious mononucleosis-fever, pharyngitis, lymphadenopathy, and the reactive T cells called “atypical lymphocytes.” EBV establishes latency in B cells. In immunocompromised patients, EBV-driven B cell proliferation can cause post-transplant lymphoproliferative disorder (PTLD) or lymphoma. EBV is also associated with nasopharyngeal carcinoma and Burkitt lymphoma.
Cytomegalovirus (CMV) is usually asymptomatic in immunocompetent people or causes a mononucleosis-like syndrome. It establishes latency in monocytes and lymphocytes. In immunocompromised patients-AIDS, transplant recipients-CMV reactivation causes retinitis (can cause blindness), colitis, esophagitis, and pneumonitis. Congenital CMV (the most common congenital infection) can cause hearing loss, microcephaly, and developmental delay.
HHV-6 causes roseola (exanthem subitum) in infants-high fever for several days, then a rash as the fever breaks. It establishes latency in T cells and can reactivate in transplant patients, causing encephalitis.
HHV-8 (Kaposi sarcoma-associated herpesvirus) causes Kaposi sarcoma, an angioproliferative tumor classically seen in AIDS patients as purple skin lesions.
HSV and VZV diagnostic tests: PCR is the most sensitive method for detecting HSV in CSF (for encephalitis) and for typing genital lesions. Direct fluorescent antibody (DFA) and Tzanck smear are less sensitive but faster. The Tzanck smear-scraping the base of a vesicle, staining with Wright or Giemsa, and looking for multinucleated giant cells-can confirm herpesvirus infection but cannot distinguish HSV from VZV. Viral culture demonstrates characteristic cytopathic effect. Type-specific serology (IgG to HSV-1 or HSV-2) is useful for determining prior exposure but not for diagnosing acute lesions.
EBV and infectious mononucleosis diagnosis: The classic triad is fever, pharyngitis, and lymphadenopathy-but what makes the diagnosis is the peripheral blood smear. Atypical lymphocytes are reactive CD8+ T cells responding to EBV-infected B cells. They’re large with abundant basophilic cytoplasm that seems to hug adjacent red cells. The heterophile antibody test (Monospot) detects antibodies that agglutinate sheep or horse red cells-a curious phenomenon caused by polyclonal B cell activation. It’s positive in about 85% of cases but may be negative early in illness or in young children. EBV-specific serology provides definitive diagnosis: VCA-IgM indicates acute infection, VCA-IgG indicates past exposure, and EBNA (Epstein-Barr nuclear antigen) antibodies develop late and indicate past infection.
CMV diagnosis depends on the clinical context: In transplant patients, quantitative PCR (viral load) is the standard for monitoring-rising viral load triggers preemptive therapy. The pp65 antigenemia assay detects CMV protein in peripheral blood leukocytes and was widely used before PCR became standard. Histopathology showing the characteristic “owl’s eye” inclusions-large cells with both nuclear and cytoplasmic inclusions-is diagnostic in tissue specimens.
Hepatitis B Virus (HBV)
Hepadnavirus (DNA virus that replicates via reverse transcriptase)
Serology interpretation:
| Marker | Acute Infection | Chronic Infection | Resolved | Vaccinated |
|---|---|---|---|---|
| HBsAg | + | + | - | - |
| Anti-HBs | - | - | + | + |
| Anti-HBc IgM | + | - | - | - |
| Anti-HBc total | + | + | + | - |
| HBeAg | + (early) | ± | - | - |
| HBV DNA | + | + | - | - |
Window period: HBsAg negative, anti-HBs not yet positive, but anti-HBc IgM positive
Other DNA Viruses
Adenovirus-The Cause of Many Common Syndromes
Adenoviruses are non-enveloped DNA viruses that cause a wide variety of clinical syndromes, from trivial upper respiratory infections to life-threatening pneumonia. Over 50 serotypes exist, and different serotypes have tropism for different tissues, explaining the clinical diversity.
Respiratory disease is the most common manifestation. Adenovirus causes pharyngitis, often with conjunctivitis (pharyngoconjunctival fever), and can cause severe pneumonia, particularly in military recruits and immunocompromised patients. Military training environments-crowded barracks with exhausted recruits-historically saw significant adenovirus outbreaks, leading to development of a military adenovirus vaccine.
Conjunctivitis can occur with or without respiratory symptoms. Epidemic keratoconjunctivitis (EKC), caused by serotypes 8, 19, and 37, is highly contagious and can spread through ophthalmology clinics via contaminated equipment or hands. “Swimming pool conjunctivitis” is another classic association.
Gastroenteritis caused by enteric adenoviruses (particularly serotypes 40 and 41) is the second most common viral cause of childhood diarrhea after rotavirus.
The non-enveloped structure of adenoviruses makes them resistant to environmental conditions and gastric acid, contributing to their transmissibility and ability to cause GI disease.
Parvovirus B19-The Red Cell Specialist
Parvovirus B19 is a small, non-enveloped, single-stranded DNA virus with a remarkably specific tropism: it infects and destroys erythroid progenitor cells. This tropism explains all of its clinical manifestations.
Pathogenesis: Parvovirus B19 binds to the P antigen (globoside) on red blood cell precursors in the bone marrow. The virus replicates in these cells and kills them as new virions are released. In normal individuals with healthy bone marrow, this destruction causes a temporary halt in red cell production, but the long lifespan of circulating RBCs (120 days) means this goes unnoticed-the marrow recovers before anemia develops.
Erythema infectiosum (fifth disease) is the classic childhood illness-a mild febrile illness followed by the “slapped cheek” rash (bright red erythema of the cheeks) and then a lacy, reticular rash on the trunk and extremities. The rash represents the immune response to the virus and appears as viremia clears; by the time the rash appears, the child is no longer contagious.
Aplastic crisis occurs when parvovirus B19 infects someone with underlying hemolytic anemia (sickle cell disease, hereditary spherocytosis, thalassemia). These patients depend on accelerated red cell production to compensate for their shortened RBC lifespan. When parvovirus halts erythropoiesis, their hemoglobin plummets precipitously-a potentially life-threatening aplastic crisis requiring transfusion.
Hydrops fetalis occurs when a seronegative pregnant woman is infected during pregnancy. The fetus lacks immunity and cannot clear the virus. Massive destruction of fetal red cell precursors causes severe fetal anemia, leading to high-output heart failure, ascites, and hydrops. In severe cases, fetal death results. Intrauterine transfusion can be life-saving.
Chronic anemia in immunocompromised patients occurs because they cannot mount the antibody response needed to clear the virus. Persistent infection causes ongoing red cell aplasia and severe, chronic anemia. Treatment with intravenous immunoglobulin (IVIG) provides antibodies that clear the infection.
Human Papillomavirus (HPV)-Warts and Cancer
HPV is a diverse family of over 200 genotypes that infect cutaneous and mucosal squamous epithelium. The clinical significance varies dramatically by type: some cause benign warts, while others cause cancer. Understanding the molecular basis of HPV-driven carcinogenesis explains why vaccines targeting high-risk types are so important.
Low-risk types (6 and 11) cause genital warts (condyloma acuminata)-exophytic, cauliflower-like lesions on the anogenital epithelium. These types do not cause cancer but cause significant morbidity. They can also cause laryngeal papillomatosis when transmitted to neonates during delivery.
High-risk types (especially 16 and 18) are oncogenic. These types are responsible for the vast majority of cervical cancers, a substantial proportion of oropharyngeal (tonsil, base of tongue) cancers, and anal cancers. The mechanism of carcinogenesis involves two viral oncoproteins:
E6 protein binds to and promotes degradation of p53, the tumor suppressor that normally arrests the cell cycle when DNA damage is detected. Without p53, damaged cells continue to proliferate.
E7 protein inactivates the retinoblastoma protein (Rb), which normally prevents cells from entering S phase inappropriately. With Rb inactivated, cells divide uncontrollably.
Together, E6 and E7 override the two major tumor suppressor pathways, allowing accumulation of mutations and progression to cancer over years to decades of persistent infection.
The vaccine targets the capsid proteins of high-risk types (16, 18, and others in the 9-valent vaccine) and low-risk types (6, 11). By preventing infection with these types, the vaccine prevents the cancers and warts they cause-one of the few vaccines that prevents cancer.
JC Virus-The Demyelinating Polyomavirus
JC virus (named for the initials of the patient from whom it was first isolated) is a polyomavirus that infects most people asymptomatically in childhood and establishes latent infection in the kidneys. In profoundly immunocompromised patients-particularly those with AIDS or on certain immunosuppressive therapies like natalizumab (for multiple sclerosis)-the virus can reactivate and cause progressive multifocal leukoencephalopathy (PML).
PML pathogenesis: JC virus reactivates and travels to the central nervous system, where it infects oligodendrocytes-the cells that produce myelin. As the virus replicates and kills oligodendrocytes, multifocal areas of demyelination appear throughout the brain. The clinical presentation is subacute neurological decline with cognitive impairment, visual disturbances, weakness, and ataxia. MRI shows characteristic non-enhancing white matter lesions.
PML is almost always fatal without immune reconstitution. In AIDS patients, antiretroviral therapy can restore immunity and allow the patient to control the infection. In patients on immunosuppressive therapy, discontinuing the offending agent is essential.
BK Virus-The Kidney Transplant Threat
BK virus is another polyomavirus that establishes latent infection in the urinary tract after childhood acquisition. Like JC virus, it causes disease primarily in immunocompromised patients-specifically, kidney transplant recipients.
BK nephropathy occurs when immunosuppression allows BK virus reactivation in the transplanted kidney. The virus infects tubular epithelial cells, causing inflammation, tubular injury, and potentially graft loss if not recognized and managed. Diagnosis relies on detecting BK virus in blood or urine by PCR; quantitative viral loads guide management. Treatment involves reducing immunosuppression-a delicate balance between controlling the virus and preventing rejection.
TORCH Infections: Congenital Infection Overview
TORCH (or TORCHES) is the classic mnemonic for pathogens causing congenital infection. These infections can have devastating consequences for the fetus and newborn.
| Pathogen | Classic Features | Diagnosis |
|---|---|---|
| Toxoplasma | Intracranial calcifications (diffuse), chorioretinitis, hydrocephalus | Serology, PCR |
| Other (Syphilis, VZV, Parvovirus B19) | Syphilis: snuffles, rash, bone abnormalities; Parvovirus: hydrops fetalis | Serology |
| Rubella | Cataracts, congenital heart defects (PDA), sensorineural deafness, “blueberry muffin” rash | Serology (IgM) |
| CMV | Periventricular calcifications, sensorineural hearing loss, microcephaly | Urine PCR (shell vial culture) |
| HSV | Skin vesicles, encephalitis, disseminated disease; often acquired during delivery | PCR, culture |
| EBV | Rare congenital infection | - |
| Syphilis | See “Other” above | RPR/VDRL, FTA-ABS |
Key distinguishing feature: Toxoplasma causes diffuse/scattered intracranial calcifications; CMV causes periventricular calcifications. This is a classic boards distinction.
CMV is the most common congenital infection and the leading infectious cause of sensorineural hearing loss in children.
49.2 RNA Viruses
Paramyxoviruses: Respiratory Viruses with Fusion
The paramyxoviruses are large, enveloped, negative-sense RNA viruses that share a key feature: a fusion protein that allows them to spread directly from cell to cell, creating multinucleated giant cells (syncytia). This cell-to-cell spread helps them evade antibodies in the extracellular space.
Measles (Rubeola)-One of the Most Contagious Diseases
Measles is extraordinarily contagious-an infected person can transmit the virus to 90% of susceptible contacts. Before vaccination, virtually everyone was infected in childhood. The virus spreads via respiratory droplets and aerosols, initially infecting respiratory epithelium and then spreading to lymphoid tissue. Viremia disseminates the virus to skin, respiratory tract, and other organs.
The clinical course is predictable and distinctive: After a 10-14 day incubation period, prodromal illness begins with the “4 Cs”-Cough, Coryza (runny nose), Conjunctivitis, and Koplik spots. Koplik spots are pathognomonic: tiny white spots on an erythematous base, appearing on the buccal mucosa opposite the molars. They look like “grains of salt on a red background” and appear 1-2 days before the rash.
The rash emerges as the fever peaks, starting on the face and spreading downward (cephalocaudal) over 3-4 days. It’s maculopapular, eventually becoming confluent. As the rash spreads downward, it begins fading on the face. The rash represents immune-mediated clearing of infected cells-immunocompromised patients may have no rash yet severe, disseminated infection.
Complications explain why measles matters: In developed countries with good nutrition, most cases resolve uneventfully. But complications can be devastating. Pneumonia-primary viral or secondary bacterial-is the most common cause of death. Encephalitis occurs in about 1 in 1000 cases. Most terrifying is subacute sclerosing panencephalitis (SSPE), a progressive, fatal neurodegenerative disease that appears 7-10 years after measles infection, caused by persistence of defective virus in the brain.
Vitamin A supplementation reduces measles complications and mortality, particularly in malnourished children. This is one of the most effective and cheapest interventions in global health.
Mumps-The Swollen Gland Virus
Mumps was once a childhood rite of passage; vaccination has made it rare. The virus infects the upper respiratory tract, spreads via viremia, and has particular tropism for glandular and nervous tissue.
Parotitis is the hallmark: Painful swelling of the parotid glands, bilateral in about 70% of cases, gives patients the classic “chipmunk cheeks” appearance. The swelling obscures the angle of the jaw. The parotid duct opening (Stensen’s duct) may be red and edematous.
Orchitis is the feared complication in adult males: In post-pubertal males, mumps virus can infect the testes, causing painful swelling, usually unilateral. The testis becomes edematous within a confined capsule (the tunica albuginea), leading to pressure necrosis. Although orchitis causes testicular atrophy in about 50% of affected testes, sterility is rare because it’s usually unilateral and the contralateral testis compensates.
Aseptic meningitis occurs commonly but is usually benign. Pancreatitis and oophoritis are less common complications.
Parainfluenza-The Croup Virus
Parainfluenza viruses are the most common cause of croup (laryngotracheobronchitis), a distinctive syndrome seen in children 6 months to 3 years old. The subglottic area-just below the vocal cords-is the narrowest part of a child’s airway. When parainfluenza infection causes inflammation and edema here, the airway narrows further, causing the classic symptoms: inspiratory stridor (the high-pitched sound of air passing through a narrowed extrathoracic airway), a “barking” cough (compared to a seal’s bark), and hoarseness.
The X-ray shows the “steeple sign”-the normally squared-off subglottic area appears tapered, like a church steeple, due to edema. Treatment involves corticosteroids (to reduce inflammation) and nebulized epinephrine (to cause vasoconstriction and reduce edema) in moderate-severe cases.
RSV (Respiratory Syncytial Virus) is the leading cause of lower respiratory tract infection in infants, particularly bronchiolitis (infection of the small airways). RSV causes epidemics every winter. In most children, it causes cold-like symptoms, but in young infants-especially premature infants-it can cause severe disease requiring hospitalization. Palivizumab, a monoclonal antibody against RSV, is given prophylactically to high-risk infants during RSV season.
Rabies Virus (Rhabdovirus)-The Fatal Encephalitis
Rabies is almost unique among infectious diseases: once symptoms appear, it’s essentially 100% fatal. Fewer than 20 people have ever survived symptomatic rabies. This makes prevention-through animal control, vaccination, and post-exposure prophylaxis-absolutely critical.
The virus is a bullet-shaped, enveloped, negative-sense RNA virus. In the United States, bats are now the primary source (often from unrecognized bites during sleep). Globally, dog bites remain the dominant mode of transmission.
Pathogenesis explains the long incubation and fatal outcome: After a bite, the virus replicates locally in muscle tissue, then enters peripheral nerves. It travels retrograde along axons toward the central nervous system-a process that can take weeks to months depending on the bite’s distance from the brain. Once the virus reaches the CNS, it replicates explosively in neurons, particularly in the limbic system, hippocampus, and brainstem. By the time symptoms appear, the brain is extensively infected.
The clinical course is harrowing: The prodrome begins with paresthesias or pain at the bite site (often the first clue)-this reflects viral replication in dorsal root ganglia. Fever, malaise, and anxiety develop.
Furious rabies (80% of cases) is the classic form. Patients become agitated, confused, and hyperactive. The pathognomonic symptom is hydrophobia-painful spasms of the pharynx and diaphragm triggered by attempts to swallow, or even by the sight or sound of water. Aerophobia (spasms triggered by drafts of air) is similar. Hypersalivation is prominent; the combination of hypersalivation and inability to swallow produces the “foaming at the mouth” image. Periods of lucidity alternate with periods of agitation.
Paralytic rabies (20% of cases) presents as ascending paralysis mimicking Guillain-Barré syndrome-a diagnostic pitfall.
Both forms progress to coma and death, usually from respiratory failure, within 2 weeks of symptom onset.
Negri bodies-eosinophilic cytoplasmic inclusions in neurons, particularly in the hippocampus and cerebellum-are pathognomonic on histopathology.
Post-exposure prophylaxis is life-saving: The long incubation period provides a window for intervention. Wound cleaning with soap and water is critical-physical removal of virus reduces inoculum. Rabies immunoglobulin (RIG) provides immediate passive immunity and should be infiltrated around the wound. The rabies vaccine induces active immunity over subsequent weeks. Given promptly and correctly, PEP is virtually 100% effective.
Pre-exposure vaccination is recommended for high-risk groups: veterinarians, animal handlers, laboratory workers, cave explorers (bat exposure), and travelers to endemic areas where dog rabies is common and access to PEP might be limited.
Influenza
Influenza is an orthomyxovirus with a segmented RNA genome-a feature that enables the genetic reassortment responsible for pandemic emergence. The virus causes annual epidemics and occasional pandemics with massive global impact. Understanding how influenza’s virulence factors work at the molecular level explains its pathogenesis, transmission, and treatment.
The Two Key Surface Glycoproteins-How They Function
Two surface glycoproteins-hemagglutinin (HA) and neuraminidase (NA)-are not just immunologic targets; they are the functional machinery that allows the virus to infect cells, replicate, and spread. Understanding their mechanisms is essential.
Hemagglutinin (HA)-The Key to Entry: Hemagglutinin is a trimeric spike protein that mediates two critical steps in infection. First, HA binds to sialic acid (neuraminic acid) residues on the surface of respiratory epithelial cells. This receptor-binding function initiates infection-without it, the virus cannot attach to target cells. The specific sialic acid linkage matters: human influenza viruses preferentially bind α-2,6-linked sialic acid (found predominantly in human upper respiratory tract), while avian influenza viruses prefer α-2,3 linkages (found in avian intestinal and respiratory epithelia and in human lower respiratory tract). This receptor specificity determines species tropism and transmission efficiency.
Second, after the virus is internalized by endocytosis, HA mediates membrane fusion. As the endosome acidifies, HA undergoes a dramatic conformational change that exposes a fusion peptide, which inserts into the endosomal membrane and pulls the viral and cellular membranes together. This releases the viral genome into the cytoplasm. The HA must be cleaved by host proteases into HA1 and HA2 subunits for this fusion mechanism to work-this cleavage requirement is another determinant of virulence. Highly pathogenic avian influenza strains (like H5N1) have polybasic cleavage sites that can be cleaved by ubiquitous proteases, allowing systemic infection; low-pathogenic strains require trypsin-like proteases found only in the respiratory tract, limiting infection to the airways.
Neuraminidase (NA)-The Key to Release and Spread: Neuraminidase is a tetrameric enzyme that cleaves sialic acid residues. Its function becomes critical at the end of the viral life cycle. Newly synthesized viral particles bud from the infected cell’s surface, but HA on these new virions immediately binds back to sialic acid on the same cell surface-the virus essentially sticks to itself. Neuraminidase solves this problem by cleaving the sialic acid residues, releasing new virions to spread and infect more cells.
Neuraminidase also helps the virus penetrate respiratory mucus (which is rich in sialic acid-containing glycoproteins) to reach epithelial cells. Without functional NA, newly formed virions clump together on the cell surface and cannot disseminate. This is exactly why neuraminidase inhibitors (oseltamivir, zanamivir) are effective antivirals-by blocking NA activity, they prevent viral release and spread, limiting the infection if given early enough (within 48 hours, before the infection is too established).
How Influenza Causes Disease: The pathogenesis of influenza involves direct viral damage and immunopathology. The virus infects and kills ciliated respiratory epithelial cells, disrupting the mucociliary escalator that normally clears pathogens and debris. This denudation of the respiratory epithelium creates susceptibility to secondary bacterial pneumonia-historically the major cause of death in influenza pandemics. The host immune response-pro-inflammatory cytokines including IL-6, TNF-α, and interferons-causes the systemic symptoms of fever, myalgia, and malaise. In severe cases, a dysregulated “cytokine storm” contributes to acute respiratory distress syndrome (ARDS).
Antigenic Variation-Why Influenza Keeps Coming Back
Antigenic drift refers to the accumulation of point mutations in HA and NA genes over time. These gradual changes, concentrated in the antigenic sites that antibodies recognize, allow the virus to escape immunity generated by prior infection or vaccination. Because HA and NA are RNA polymerase products made by an error-prone enzyme (lacking proofreading), mutations occur constantly. This is why we need new flu vaccines each year-last year’s vaccine induces antibodies to last year’s HA and NA epitopes, which may no longer match this year’s circulating strains.
Antigenic shift is a sudden, major change in HA or NA, creating a novel subtype to which the population has no immunity. This occurs through reassortment-when two different influenza strains infect the same cell, their segmented genomes (8 separate RNA segments) can be packaged into progeny virions in new combinations. Pigs serve as “mixing vessels” because they can be infected by both avian and human strains, and their respiratory epithelium contains both α-2,3 and α-2,6-linked sialic acids. When a human virus and an avian virus co-infect a pig, reassortment can generate a virus with avian HA (to which humans have no immunity) but human-adapted internal genes (allowing efficient human-to-human transmission). The 1918 pandemic (H1N1), the 1957 pandemic (H2N2), and the 1968 pandemic (H3N2) all resulted from antigenic shift. The 2009 H1N1 “swine flu” pandemic arose through reassortment of avian, swine, and human influenza strains.
Types of Influenza Virus: Influenza A infects multiple species (humans, birds, pigs, horses) and is the only type that causes pandemics, because only influenza A has the animal reservoirs that allow antigenic shift. It’s classified by HA and NA subtypes (18 HA subtypes, 11 NA subtypes exist in birds). Influenza B infects only humans and seals, undergoes only antigenic drift, and causes seasonal epidemics but not pandemics. Influenza C causes mild respiratory illness and is clinically less important.
Diagnosis and treatment: Rapid antigen tests provide quick results but have limited sensitivity (50-70%). PCR-based assays are now the diagnostic standard, with excellent sensitivity and the ability to type and subtype the virus. Treatment with neuraminidase inhibitors (oseltamivir, zanamivir, peramivir) works by the mechanism described above-blocking viral release. Baloxavir is a newer agent that inhibits the cap-dependent endonuclease required for viral mRNA synthesis. Treatment must be started within 48 hours of symptom onset to provide meaningful benefit-by then, viral replication is waning and the immune response is already established. Annual vaccination remains the primary prevention strategy, with vaccine strains selected based on surveillance predictions of which strains will circulate.
HIV
HIV is a retrovirus-it carries its genome as RNA but uses reverse transcriptase to create a DNA copy that integrates into the host genome. Understanding the molecular mechanisms of how HIV enters cells, how it destroys the immune system, and why it establishes an incurable latent reservoir is essential for understanding the disease and its treatment.
The Viral Structure and Key Proteins
HIV is an enveloped virus with a lipid membrane derived from the host cell. Embedded in this envelope are the spike proteins (gp120 and gp41) that mediate entry. Inside the virion is a cone-shaped capsid containing two copies of the RNA genome along with the enzymes reverse transcriptase, integrase, and protease-each a critical drug target.
How HIV Enters Cells-The Molecular Dance of Infection
HIV entry is a multi-step process requiring interaction with two receptors, and understanding these steps explains both viral tropism and drug development.
Step 1: gp120 binds CD4. The viral envelope protein gp120 recognizes and binds to the CD4 receptor on the surface of T helper cells, macrophages, and dendritic cells. CD4 is normally used by these cells to interact with MHC class II molecules during antigen presentation-HIV essentially hijacks this immune recognition molecule. The gp120-CD4 binding triggers a conformational change in gp120 that exposes a previously hidden region called the V3 loop.
Step 2: Coreceptor binding. The conformationally changed gp120 now binds to a coreceptor-either CCR5 or CXCR4. These are chemokine receptors that normally guide immune cell migration. R5-tropic viruses (using CCR5) predominate during early infection and are the variants typically transmitted. X4-tropic viruses (using CXCR4) emerge later in infection and are associated with more rapid CD4 decline. Some viruses are dual-tropic. This coreceptor requirement explains why people homozygous for the CCR5-Δ32 deletion mutation are highly resistant to HIV infection-without CCR5, R5-tropic viruses cannot enter their cells. Maraviroc, a CCR5 antagonist, exploits this by blocking the coreceptor.
Step 3: gp41-mediated fusion. Coreceptor binding triggers another conformational change, now in gp41. This protein contains a fusion peptide that inserts into the host cell membrane. gp41 then folds back on itself, pulling the viral and cellular membranes together until they fuse, releasing the viral core into the cytoplasm. Enfuvirtide is a fusion inhibitor that blocks this step.
Why CD4 Cells Die-Multiple Mechanisms of Destruction
The progressive loss of CD4+ T cells is the hallmark of HIV disease, but the mechanisms are more complex than simple viral killing.
Direct viral cytopathic effect: When HIV replicates in a CD4+ T cell, viral budding from the cell membrane can be directly cytotoxic. High levels of intracellular viral proteins can trigger apoptosis. Accumulation of unintegrated viral DNA can activate DNA damage responses.
Immune-mediated killing: Many infected cells are killed by the host’s own immune response. CD8+ cytotoxic T lymphocytes recognize viral peptides presented on MHC class I molecules and kill infected cells. This is actually protective early in infection but contributes to CD4 loss over time. Antibody-dependent cellular cytotoxicity (ADCC) also destroys infected cells.
Bystander killing: The majority of CD4+ T cells that die during HIV infection may not be productively infected. Chronic immune activation leads to exhaustion and apoptosis of uninfected cells. Pyroptosis-an inflammatory form of cell death triggered by incomplete viral infection of resting CD4 cells-may be a major mechanism. When HIV enters a resting CD4 cell but cannot complete reverse transcription, the accumulated cytoplasmic DNA triggers inflammasome activation, caspase-1 activation, and pyroptosis, which releases inflammatory cytokines that activate and draw in more CD4 cells to be infected.
The Latent Reservoir-Why HIV Cannot Be Cured
Here is the central tragedy of HIV biology: the virus integrates its DNA into the host genome, and once integrated, it becomes part of the cell’s genetic material. In activated CD4 cells that are actively dividing, the virus replicates and the cell dies. But if an infected cell transitions to a resting memory state before being killed, the viral DNA goes dormant along with the cell’s transcription machinery. This creates a latent reservoir-long-lived memory CD4+ T cells harboring silent but replication-competent HIV provirus.
These latently infected cells persist for decades. They are invisible to the immune system because they don’t express viral proteins. They are invisible to antiretroviral drugs because they aren’t replicating. When the cell is reactivated years later, the virus can emerge. This reservoir is established within days of infection-even patients treated during acute infection retain a latent reservoir-and it is the fundamental barrier to cure.
The Diagnostic Algorithm
HIV diagnosis uses fourth-generation testing as the first step. The fourth-generation HIV-1/2 antigen/antibody combination assay detects both HIV antibodies and p24 antigen (a capsid protein released early in infection). This combination narrows the window period-the time between infection and detectable test positivity-to about 2-3 weeks, compared to 3-4 weeks for antibody-only tests.
If the screening test is positive, an HIV-1/2 antibody differentiation immunoassay follows. This confirms the result and distinguishes HIV-1 (the predominant type worldwide) from HIV-2 (mainly in West Africa, more indolent course, less responsive to certain antiretrovirals).
If the differentiation assay is negative or indeterminate but screening was positive, HIV-1 RNA testing (viral load) is performed. This detects acute HIV infection-the period when antibodies haven’t yet developed but p24 antigen is present and the patient is highly infectious.
CD4 Count-The Measure of Immune Damage
HIV infects CD4+ T cells, and progressive CD4 depletion defines disease progression. In untreated infection, after an initial rapid decline during acute infection (when viral loads peak), the immune system partially contains the virus and CD4 counts plateau. This is followed by years of gradual decline at roughly 50-80 cells/μL per year. When the CD4 count falls below 200 cells/μL, the risk of opportunistic infections rises dramatically, and AIDS is defined.
HIV Opportunistic Infections by CD4 Threshold:
| CD4 Count | Opportunistic Infections | Prophylaxis |
|---|---|---|
| <500 | Kaposi sarcoma, TB reactivation | - |
| <200 | PCP (Pneumocystis), Candida esophagitis, Cryptococcus | TMP-SMX |
| <150 | Histoplasma, Coccidioides (disseminated) | - |
| <100 | Toxoplasma encephalitis, Cryptosporidium | TMP-SMX (also covers Toxo) |
| <50 | MAC (Mycobacterium avium complex), CMV retinitis, CNS lymphoma, PML | Azithromycin (MAC) |
AIDS-defining illnesses (occurs at any CD4, but defines AIDS): - PCP, Kaposi sarcoma, CMV disease, Cryptococcal meningitis - Esophageal candidiasis, CNS lymphoma, Toxoplasma encephalitis - Mycobacterial disease (TB, MAC), PML, Cryptosporidium/Isospora >1 month - HIV encephalopathy, wasting syndrome, invasive cervical cancer
Viral Load-The Measure of Viral Activity
HIV-1 RNA (viral load) measures the amount of virus in blood. It’s used to diagnose acute infection (before antibodies develop), monitor treatment response, and assess adherence and resistance. The goal of treatment is undetectable viral load (<20-50 copies/mL, depending on assay). The “set point” viral load-the level several months after acute infection, once equilibrium is reached-predicts the rate of disease progression.
Antiretroviral Therapy-Attacking the Viral Life Cycle
Understanding how each drug class works requires understanding the viral replication steps:
Entry inhibitors block the steps described above: maraviroc blocks CCR5 coreceptor binding; enfuvirtide blocks gp41-mediated fusion.
NRTIs (nucleoside/nucleotide reverse transcriptase inhibitors) are nucleoside analogs that are incorporated into the growing DNA chain during reverse transcription and cause chain termination because they lack the 3’-hydroxyl group needed for the next phosphodiester bond.
NNRTIs (non-nucleoside reverse transcriptase inhibitors) bind directly to reverse transcriptase at a site away from the active site, causing conformational changes that inhibit enzyme function.
Integrase inhibitors block the integration of viral DNA into the host genome-a critical step for establishing both productive and latent infection. These are now first-line therapy due to excellent efficacy and tolerability.
Protease inhibitors block the viral protease that cleaves polyprotein precursors into functional proteins during viral maturation. Without this cleavage, virions bud but are non-infectious.
Combination therapy with drugs from multiple classes-typically two NRTIs plus an integrase inhibitor-achieves viral suppression, prevents resistance emergence, and has transformed HIV from a fatal illness to a manageable chronic condition.
Hepatitis C Virus (HCV)
Hepatitis C is a flavivirus that has achieved something remarkable in modern medicine: it went from untreatable to curable within a few decades. The development of direct-acting antivirals (DAAs) transformed HCV from a leading cause of liver transplantation to an infection that can be cured in 8-12 weeks with oral therapy.
The natural history explains why treatment matters: Unlike hepatitis A and B, most people infected with HCV don’t clear the virus-75-85% develop chronic infection. Over decades, chronic HCV causes progressive liver fibrosis, eventually leading to cirrhosis in 15-30% of patients. Cirrhotic patients face the risks of liver failure and hepatocellular carcinoma. This slow progression explains why many people live with HCV for years without symptoms, only to present with advanced liver disease.
Diagnosis uses a two-step approach: Anti-HCV antibody indicates exposure-the antibody persists even after the virus clears (either spontaneously or with treatment). A positive antibody test must be followed by HCV RNA testing to determine if the patient has current infection. If RNA is detectable, the patient has active infection and should be treated. Genotyping guides treatment selection, though pan-genotypic regimens have simplified this.
Treatment has been revolutionized: DAAs target specific viral proteins (protease, polymerase, NS5A) and achieve sustained virologic response (cure) rates exceeding 95% with 8-12 weeks of oral therapy. The medications are well-tolerated and effective across all genotypes. The barrier to treatment is now primarily cost and access, not efficacy.
Other RNA Viruses
Rubella (German Measles)-Togaviridae
Rubella must not be confused with rubeola (measles)-they’re completely different viruses causing different diseases, though both produce a rash. In children and adults, rubella is trivial. In fetuses, it’s devastating. This dichotomy explains why rubella vaccination is such a public health priority.
In children and adults, rubella causes mild illness: low-grade fever, malaise, and a fine maculopapular rash that starts on the face and spreads downward, lasting about 3 days (hence the old name “three-day measles”). The distinctive feature is lymphadenopathy, particularly involving posterior auricular and suboccipital nodes-finding these nodes in a patient with a viral exanthem should make you think of rubella. Arthralgias and arthritis are common in adult women.
Congenital rubella syndrome is the catastrophe: When rubella infects a pregnant woman, particularly in the first trimester, the consequences for the fetus are severe. Transmission rates approach 90% in early pregnancy, and the classic triad of cataracts, congenital heart defects (patent ductus arteriosus, pulmonary stenosis), and sensorineural deafness may develop. Other manifestations include “blueberry muffin” rash (purpuric lesions reflecting extramedullary hematopoiesis), microcephaly, and intellectual disability. The tragedy is that this is entirely preventable through vaccination.
The MMR vaccine (measles, mumps, rubella) uses live attenuated virus and is contraindicated in pregnancy. Women of childbearing age should have immunity confirmed before pregnancy.
Rotavirus-Reoviridae
Rotavirus was once the leading cause of severe childhood diarrhea worldwide, responsible for hundreds of thousands of deaths annually, primarily in developing countries. The introduction of rotavirus vaccines has dramatically reduced this burden-one of the great public health achievements of the 21st century.
The virus is a double-stranded RNA virus with a characteristic wheel-like appearance on electron microscopy (hence “rota”). It’s non-enveloped, making it resistant to environmental conditions and difficult to inactivate.
The disease hits young children hardest: Rotavirus causes severe watery diarrhea and vomiting in children under 5, with peak incidence at 6-24 months. The illness lasts about a week, and the main danger is dehydration-in settings without access to rehydration therapy, this can be fatal. In temperate climates, rotavirus has a striking winter seasonality.
Vaccination has transformed rotavirus epidemiology: The oral rotavirus vaccines (Rotarix, RotaTeq) are given in infancy. Since their introduction, hospitalizations for rotavirus gastroenteritis have declined by over 80% in vaccinated populations. The vaccines are live attenuated and carry a small risk of intussusception, but the benefits far outweigh this risk.
Norovirus-Caliciviridae
Norovirus is the most common cause of acute viral gastroenteritis across all age groups and is notorious for causing explosive outbreaks in closed settings-cruise ships, nursing homes, hospitals, schools, and restaurants. The virus combines several features that make it extraordinarily contagious.
What makes norovirus so transmissible: The infectious dose is tiny-fewer than 100 viral particles can cause illness. The virus is shed in enormous quantities in stool and vomit. It’s non-enveloped, so it resists environmental inactivation and survives on surfaces for days. It can be transmitted by aerosolized vomitus. And people remain contagious for days after symptoms resolve.
The clinical picture is dramatic but brief: Onset is sudden-within 12-48 hours of exposure, patients develop projectile vomiting, watery diarrhea, abdominal cramps, and sometimes low-grade fever. The illness is miserable but self-limited, typically resolving in 24-72 hours. In healthy adults, it’s a bad couple of days. In the elderly or debilitated, dehydration can be dangerous.
Outbreak control is challenging: The combination of low infectious dose, environmental persistence, and continued shedding makes norovirus outbreaks difficult to control. Hand hygiene must include washing with soap and water-alcohol-based sanitizers are less effective against non-enveloped viruses. Environmental disinfection with bleach is necessary. In healthcare settings, cohorting patients and excluding symptomatic staff are essential.
Flaviviruses-Mosquito-Borne Disease
The flaviviruses are a family of enveloped, positive-sense RNA viruses transmitted by mosquitoes, causing some of the most important tropical infections. The name comes from yellow fever (flavus is Latin for yellow), the prototype of the family.
Dengue fever affects hundreds of millions of people annually in tropical and subtropical regions. Aedes mosquitoes (the same genus that transmits Zika and chikungunya) are the vectors. Primary infection causes “breakbone fever”-high fever, severe headache, retro-orbital pain, and myalgias/arthralgias so severe they feel like bones breaking. Most patients recover completely.
The danger comes with secondary infection by a different dengue serotype (there are four). Antibodies from the first infection don’t neutralize the new serotype-instead, they enhance viral uptake into cells, a phenomenon called antibody-dependent enhancement. The result can be dengue hemorrhagic fever or dengue shock syndrome, with plasma leakage, hemorrhage, and potentially fatal shock.
Yellow fever remains endemic in sub-Saharan Africa and South America despite the existence of an excellent vaccine. The virus causes hepatotropic disease-severe cases progress to jaundice (hence “yellow”), hemorrhage, and the classic “black vomit” (hematemesis with altered blood). Mortality in severe cases is 20-50%. The live attenuated vaccine provides lifelong immunity and is required for travel to endemic areas.
West Nile virus reached the United States in 1999 and has since spread across the country, transmitted by Culex mosquitoes. Most infections are asymptomatic. About 20% cause a flu-like illness. Less than 1% develop neuroinvasive disease-meningitis or encephalitis-but this can be severe, particularly in the elderly. Acute flaccid paralysis resembling polio can occur.
Zika virus gained global attention in 2015-2016 when the epidemic in Brazil revealed its ability to cause congenital Zika syndrome. In adults, infection is usually mild or asymptomatic-low-grade fever, rash, conjunctivitis, arthralgias. But when pregnant women are infected, the virus can cause devastating fetal brain damage, including microcephaly and other neurologic abnormalities. Zika can also be sexually transmitted, unlike most arboviruses.
Togaviruses-Alphavirus Encephalitides
Several alphaviruses cause encephalitis in the Americas, named for the equine hosts that amplify the viruses (horses, like humans, are dead-end hosts-they don’t transmit to mosquitoes efficiently).
Eastern equine encephalitis (EEE) is the most severe, with mortality rates around 30% and frequent neurologic sequelae in survivors. It’s found in the eastern United States and is fortunately rare because the mosquito vectors don’t commonly bite humans. Western equine encephalitis (WEE) and Venezuelan equine encephalitis (VEE) are less severe.
Chikungunya, also an alphavirus, has become globally important. It causes acute febrile illness with severe polyarthralgias-the joint pain is so characteristic that the name comes from a Tanzanian word meaning “to walk bent over.” Unlike dengue, chikungunya arthritis can persist for months to years in some patients.
Filoviruses-Ebola and Marburg
The filoviruses are among the most feared pathogens-their filamentous shape, high mortality, and dramatic hemorrhagic manifestations captured public attention during the 2014-2016 West African Ebola epidemic.
Ebola and Marburg viruses are enveloped, negative-sense RNA viruses transmitted through contact with infected body fluids. In African outbreaks, transmission chains involve contact with sick family members, burial practices that involve touching corpses, and healthcare workers who lack adequate personal protective equipment. The viruses are not airborne transmitted.
The clinical course begins with nonspecific symptoms-fever, myalgia, headache-progressing to severe gastrointestinal symptoms with diarrhea and vomiting. Hemorrhagic manifestations (bleeding from multiple sites) occur late in the course and are not as universal as popular media suggests. Multi-organ failure and shock cause death; mortality varies by outbreak and viral strain but has ranged from 25% to 90%.
Treatment has improved dramatically. Supportive care-aggressive fluid resuscitation and electrolyte management-improves survival. Monoclonal antibody therapies (Inmazeb for Ebola) have shown mortality benefit and are now standard of care when available. Vaccines against Ebola are now approved.
Bunyaviruses-Hantavirus and Others
Hantaviruses are transmitted not by arthropods but by rodents. Humans become infected by inhaling aerosolized rodent urine, feces, or saliva-classically when cleaning out cabins or sheds with rodent infestations. There is no person-to-person transmission.
In the Americas, hantaviruses cause hantavirus pulmonary syndrome (HPS). After a prodromal illness with fever and myalgias, patients rapidly develop pulmonary edema and respiratory failure from capillary leak. The mortality rate exceeds 30%. Treatment is supportive; ECMO may be life-saving for severe cases.
Old World hantaviruses (in Europe and Asia) cause hemorrhagic fever with renal syndrome (HFRS)-a different clinical picture with acute kidney injury rather than pulmonary involvement.
California encephalitis virus (La Crosse virus) is a mosquito-borne bunyavirus causing encephalitis, predominantly in children, in the midwestern and eastern United States.
Arenaviruses-Rodent-Borne Viruses
Arenaviruses are rodent-borne viruses with distinctive appearance on electron microscopy-grainy particles from incorporated ribosomes (arena is Latin for sand).
Lymphocytic choriomeningitis virus (LCMV) is carried by the common house mouse and transmitted through contact with mouse urine, feces, or saliva. In immunocompetent adults, it causes a biphasic illness: initial flu-like symptoms followed by aseptic meningitis. Most cases resolve completely. However, LCMV infection during pregnancy can cause congenital infection with severe neurologic damage, mimicking TORCH infections. In immunocompromised patients (particularly transplant recipients who received organs from infected donors), LCMV can cause fatal disease.
Lassa fever is a severe hemorrhagic fever caused by Lassa virus, endemic to West Africa. It’s a significant cause of morbidity in endemic areas and has caused importation scares when infected travelers reach other countries.
Poxviruses-The Largest and Most Complex Viruses
Poxviruses are extraordinary in virology-they’re the largest viruses known, visible under light microscopy, and they possess a complexity that approaches that of small bacteria. They’re large enough to carry genes for their own DNA replication machinery, which is why they uniquely replicate entirely in the cytoplasm rather than requiring access to the nucleus like all other DNA viruses. This cytoplasmic replication creates the characteristic cytoplasmic inclusions seen on histopathology.
Smallpox (Variola Virus)
Smallpox holds a unique place in medical history as the only human infectious disease to be deliberately eradicated through vaccination-a campaign completed in 1980. The disease was devastating: mortality was 20-30% in unvaccinated populations, and survivors were often disfigured by scarring. Understanding its pathophysiology remains important because of the bioterrorism threat.
Pathogenesis: Variola virus was transmitted by respiratory droplets and aerosols. After inhalation, the virus replicated in the upper respiratory tract, then spread to regional lymph nodes. Primary viremia seeded the reticuloendothelial system (spleen, liver, bone marrow), where massive replication occurred. Secondary viremia then disseminated the virus to the skin and mucous membranes, producing the characteristic rash.
The rash was distinctive: lesions evolved synchronously through stages (macule → papule → vesicle → pustule → crust), so at any given time, all lesions were at the same stage. This synchronous evolution distinguishes smallpox from chickenpox, where lesions appear in successive crops and exist in multiple stages simultaneously. The “centrifugal” distribution-denser on the face and extremities than on the trunk-was also characteristic.
Guarnieri bodies are the cytoplasmic inclusions seen in poxvirus-infected cells-aggregates of viral replication machinery (viral factories) within the cytoplasm.
Bioterrorism concern: Smallpox is classified as a Category A bioterrorism agent because of its transmissibility, high mortality in an unvaccinated population, and potential for public panic. Routine vaccination ended in the 1970s, leaving most of the world’s population susceptible. The Strategic National Stockpile maintains enough vaccine for emergency response.
Molluscum Contagiosum
Molluscum contagiosum virus causes a benign skin infection that contrasts starkly with the severity of smallpox-a reminder of how diverse poxvirus pathogenicity can be.
Pathogenesis: Molluscum spreads through direct skin contact and causes highly localized infection of the epidermis. The virus infects keratinocytes and induces them to proliferate, creating the characteristic lesion: a dome-shaped, waxy papule with a central umbilication (dimple). This umbilicated center contains the viral-laden central core. The virus produces proteins that interfere with interferon signaling and antigen presentation, allowing it to evade local immunity and persist for months.
Clinical patterns: In immunocompetent children, molluscum is a common, self-limited infection acquired by skin contact. Lesions resolve spontaneously over 6-12 months as cellular immunity eventually clears the infection. In adults, molluscum is often sexually transmitted, with genital distribution. In AIDS patients with advanced immunosuppression, molluscum can be extensive and disfiguring, with hundreds of large lesions-this extensive pattern can be an AIDS-presenting illness.
Henderson-Patterson bodies (also called molluscum bodies) are the diagnostic histopathologic finding: large, eosinophilic, intracytoplasmic inclusions that push the nucleus to the periphery of the cell. They represent viral inclusion bodies filled with maturing virions.
Treatment is not mandatory since lesions self-resolve, but can include curettage, cryotherapy, or topical agents to hasten clearance.
Chapter 50: Antimicrobial Susceptibility Testing and Resistance
Understanding antimicrobial resistance requires knowing both how we test for it (susceptibility testing) and the mechanisms by which bacteria become resistant. Both are essential for the clinical pathologist.
Quick Reference: Antibiotic Spectrum of Activity
| Antibiotic Class | Gram-Positive | Gram-Negative | Anaerobes | Key Notes |
|---|---|---|---|---|
| Penicillin | Strep, Enterococcus | No | Some (oral) | Not Staph (penicillinase) |
| Ampicillin | Same + Listeria | H. flu, E. coli (some) | Better | HACEK organisms |
| Penicillinase-resistant PCN (nafcillin, oxacillin) | MSSA only | No | No | Not MRSA |
| Anti-pseudomonal PCN (piperacillin) | Yes | Yes including Pseudomonas | Yes | Usually with β-lactamase inhibitor |
| 1st gen cephalosporin (cefazolin) | MSSA, Strep | E. coli, Klebsiella, Proteus | No | Surgical prophylaxis |
| 2nd gen cephalosporin (cefuroxime) | Yes | Better GN coverage | Some | Variable |
| 3rd gen cephalosporin (ceftriaxone) | Yes (not Enterococcus) | Excellent | No | Meningitis, gonorrhea |
| Anti-pseudomonal ceph (ceftazidime, cefepime) | Less GP | Pseudomonas | No | Neutropenic fever |
| Carbapenems (meropenem, imipenem) | Yes (not MRSA) | Yes including ESBL | Yes | Broadest β-lactam |
| Aztreonam | No | Yes including Pseudomonas | No | Safe in PCN allergy |
| Vancomycin | MRSA, Enterococcus | No | Some Clostridium | Not VRE |
| Linezolid | MRSA, VRE | No | Yes | Myelosuppression |
| Daptomycin | MRSA, VRE | No | No | Inactivated by surfactant (not for pneumonia) |
| Fluoroquinolones (cipro, levo, moxi) | Variable | Excellent | Moxi only | Cipro: best Pseudomonas |
| Aminoglycosides | Only synergy | Yes | No | Nephrotoxicity, ototoxicity |
| Macrolides (azithro) | Yes | H. flu, atypicals | No | Atypical pneumonia |
| Tetracyclines (doxy) | MRSA (some) | Yes | Yes | Tick-borne diseases |
| TMP-SMX | MRSA (CA-MRSA) | Yes | No | PCP prophylaxis |
| Metronidazole | No | No | Excellent | C. diff, abscesses |
| Clindamycin | Yes | No | Excellent | Inducible resistance in Staph |
Key patterns to remember: - Enterococcus is intrinsically resistant to cephalosporins and aztreonam - Listeria is intrinsically resistant to cephalosporins (use ampicillin) - Atypical organisms (Mycoplasma, Chlamydia, Legionella) require intracellular-penetrating agents (macrolides, fluoroquinolones, tetracyclines) - Pseudomonas requires anti-pseudomonal agents (ceftazidime, cefepime, piperacillin-tazobactam, carbapenems, ciprofloxacin, aminoglycosides)
50.1 Susceptibility Testing Methods
The fundamental question in susceptibility testing is: will this antibiotic, at achievable concentrations in the patient, inhibit this organism? The answer comes from determining the minimum inhibitory concentration (MIC)-the lowest antibiotic concentration that prevents visible bacterial growth.
Broth microdilution is the reference method. Serial two-fold dilutions of antibiotic are prepared in broth in a microtiter plate. Bacteria are inoculated, and after incubation, the wells are examined for turbidity. The MIC is the lowest concentration with no visible growth. This method is precise but labor-intensive.
Disk diffusion (Kirby-Bauer) is simpler. An antibiotic-impregnated disk is placed on an agar plate inoculated with bacteria. Antibiotic diffuses out, creating a concentration gradient. Bacteria grow where the concentration is below the MIC, creating a zone of inhibition around the disk. Zone diameter correlates inversely with MIC-larger zones mean lower MICs (more susceptible).
E-test combines principles of both methods. A strip with a continuous antibiotic gradient is placed on an inoculated plate. The elliptical zone of inhibition intersects the strip at the MIC, which is read directly from the scale on the strip.
Interpretation requires comparing the MIC (or zone diameter) to established breakpoints. Breakpoints define “susceptible” (standard dosing should work), “intermediate” (higher dosing or specific sites may work), and “resistant” (unlikely to work). Breakpoints are set by organizations like CLSI and EUCAST based on pharmacokinetic/pharmacodynamic data and clinical outcomes.
50.2 Mechanisms of Resistance
Bacteria have evolved five main strategies to resist antibiotics. Understanding these mechanisms helps you predict cross-resistance and choose alternative agents.
Enzymatic inactivation: The bacteria produce enzymes that destroy or modify the antibiotic. Beta-lactamases hydrolyze the beta-lactam ring, inactivating penicillins and cephalosporins. Aminoglycoside-modifying enzymes add chemical groups to aminoglycosides, preventing ribosome binding.
Target modification: The bacteria alter the antibiotic’s target so it no longer binds. MRSA produces an altered penicillin-binding protein (PBP2a, encoded by mecA) that has low affinity for beta-lactams. Vancomycin-resistant enterococci alter the D-Ala-D-Ala terminus of peptidoglycan precursors to D-Ala-D-Lac, preventing vancomycin binding.
Decreased permeability: Bacteria can exclude antibiotics by reducing uptake. Gram-negative bacteria can lose or alter outer membrane porins, preventing antibiotic entry. This often contributes to carbapenem resistance.
Efflux pumps: Active transport systems pump antibiotics out of the cell faster than they can accumulate. Efflux pumps contribute to resistance to tetracyclines, fluoroquinolones, and multiple other drug classes.
Target bypass: The bacteria acquire a new pathway that circumvents the blocked target. Vancomycin resistance genes (vanA, vanB) encode enzymes that produce altered peptidoglycan precursors that vancomycin can’t bind.
50.3 Clinically Important Resistance Phenotypes
MRSA (Methicillin-resistant Staphylococcus aureus): The mecA gene encodes PBP2a, which has low affinity for all beta-lactams. MRSA is resistant to all penicillins, cephalosporins, and carbapenems-no beta-lactam is effective. Treatment options include vancomycin, daptomycin, linezolid, and sometimes TMP-SMX or doxycycline for non-severe infections.
ESBL (Extended-spectrum beta-lactamases): These enzymes hydrolyze penicillins AND extended-spectrum cephalosporins (ceftriaxone, ceftazidime, cefepime), but are inhibited by beta-lactamase inhibitors and don’t efficiently hydrolyze carbapenems. Carbapenems are the treatment of choice for serious ESBL infections.
AmpC beta-lactamases: Unlike ESBLs, AmpC enzymes are NOT inhibited by clavulanate. They’re chromosomally encoded and inducible in the “SPACE” organisms (Serratia, Pseudomonas, Acinetobacter, Citrobacter, Enterobacter). A dangerous scenario: the organism tests susceptible to a third-generation cephalosporin, but during treatment, AmpC is induced and the organism becomes resistant. Carbapenems or cefepime (stable to AmpC) are safer choices.
Carbapenemases: These are the most concerning beta-lactamases because they hydrolyze carbapenems-our “last-line” beta-lactams. KPC (Klebsiella pneumoniae carbapenemase) is most common in the US. NDM, VIM, and IMP are metallo-beta-lactamases, important because they’re NOT inhibited by avibactam (so ceftazidime-avibactam fails). Treatment options are severely limited-often polymyxins, tigecycline, or newer agents.
VRE (Vancomycin-resistant enterococci): vanA confers high-level resistance to both vancomycin and teicoplanin; vanB confers resistance to vancomycin only. Both are transferable on mobile genetic elements, raising the nightmare scenario of transfer to S. aureus (VRSA, which has occurred rarely). Treatment options include linezolid, daptomycin, and tigecycline.
This completes Part IV: Medical Microbiology.
PART V: LABORATORY MANAGEMENT AND INFORMATICS
Chapter 51: Laboratory Statistics and Diagnostic Test Evaluation
Understanding basic statistics is essential for interpreting test results, evaluating new methods, and understanding the limitations of diagnostic tests. This chapter covers the statistical concepts most relevant to clinical laboratory practice.
Test Performance Characteristics
Every diagnostic test has inherent performance characteristics that determine its clinical utility. Understanding these concepts allows you to interpret results appropriately and communicate their meaning to clinicians.
The 2×2 Table: Foundation of Test Evaluation
All test performance metrics derive from a simple 2×2 contingency table comparing test results to a reference (“gold”) standard:
| Disease Present | Disease Absent | |
|---|---|---|
| Test Positive | True Positive (TP) | False Positive (FP) |
| Test Negative | False Negative (FN) | True Negative (TN) |
From this table, we calculate all the key metrics:
Sensitivity and Specificity
Sensitivity = TP / (TP + FN) = Proportion of diseased patients who test positive
- Answers: “If you have the disease, what’s the probability the test is positive?”
- A sensitive test has few false negatives
- High sensitivity is good for ruling OUT disease (mnemonic: SnNout - Sensitive test, Negative result, rules Out)
- Example: HIV screening tests are designed for high sensitivity (>99.5%) to avoid missing infected individuals
Specificity = TN / (TN + FP) = Proportion of non-diseased patients who test negative
- Answers: “If you don’t have the disease, what’s the probability the test is negative?”
- A specific test has few false positives
- High specificity is good for ruling IN disease (mnemonic: SpPin - Specific test, Positive result, rules In)
- Example: HIV confirmatory tests have high specificity to avoid false positive diagnoses
The tradeoff: Sensitivity and specificity are inversely related. Lowering a cutoff increases sensitivity but decreases specificity (more false positives); raising it does the opposite.
Predictive Values: What Clinicians Really Want to Know
Sensitivity and specificity are intrinsic properties of the test. But clinicians ask a different question: “My patient tested positive-what’s the probability they actually have the disease?”
Positive Predictive Value (PPV) = TP / (TP + FP)
- Answers: “Given a positive test, what’s the probability of disease?”
- Depends on disease prevalence in the population tested
Negative Predictive Value (NPV) = TN / (TN + FN)
- Answers: “Given a negative test, what’s the probability of no disease?”
- Also depends on prevalence
The critical point: PPV and NPV change with prevalence, even when sensitivity and specificity are fixed.
How Prevalence Affects Predictive Value
Consider a test with 95% sensitivity and 95% specificity. What happens to PPV at different prevalences?
| Prevalence | PPV | NPV |
|---|---|---|
| 50% | 95% | 95% |
| 10% | 68% | 99% |
| 1% | 16% | 99.9% |
| 0.1% | 2% | 99.99% |
The lesson: In low-prevalence populations, even highly specific tests generate many false positives. A positive screening test in a low-risk patient is likely to be a false positive-this is why confirmatory testing is essential.
Clinical example: A patient with no risk factors for HIV has a positive screening test. Given the low pre-test probability (prevalence in this population ~0.1%), the PPV is only a few percent. The result must be confirmed before diagnosis.
Likelihood Ratios
Likelihood ratios (LRs) express how much a test result changes the odds of disease. They combine sensitivity and specificity into a single metric and are independent of prevalence.
Positive Likelihood Ratio (LR+) = Sensitivity / (1 - Specificity)
- How many times more likely is a positive result in someone with disease vs. without?
- LR+ > 10 is very useful for ruling in disease
- LR+ of 1 provides no diagnostic information
Negative Likelihood Ratio (LR-) = (1 - Sensitivity) / Specificity
- How many times less likely is a negative result in someone with disease vs. without?
- LR- < 0.1 is very useful for ruling out disease
- LR- of 1 provides no diagnostic information
Using likelihood ratios with pre-test probability:
Post-test odds = Pre-test odds × Likelihood ratio
Where odds = probability / (1 - probability)
Or use a Fagan nomogram: Draw a line from pre-test probability through LR to find post-test probability.
ROC Curves
A Receiver Operating Characteristic (ROC) curve plots sensitivity (y-axis) vs. 1-specificity (x-axis) at all possible cutoff values.
Interpreting ROC curves: - Perfect test: Curve passes through upper left corner (100% sensitivity and 100% specificity achievable) - Useless test: Diagonal line from lower left to upper right (no better than chance) - Better tests: Curves closer to upper left corner
Area Under the Curve (AUC): - Ranges from 0.5 (no discrimination) to 1.0 (perfect discrimination) - AUC = 0.7-0.8: Fair discrimination - AUC = 0.8-0.9: Good discrimination - AUC > 0.9: Excellent discrimination
Clinical use: ROC curves help determine the optimal cutoff for a test, balancing sensitivity and specificity based on clinical priorities (e.g., for screening, prioritize sensitivity; for confirmation, prioritize specificity).
Precision and Accuracy
Precision (reproducibility): How close are repeated measurements to each other? - High precision = low random error = low standard deviation - Measured by coefficient of variation: CV = (SD / Mean) × 100%
Accuracy: How close is the measured value to the true value? - Poor accuracy = systematic error (bias) - Assessed by comparison to reference method or certified reference materials
Analogy: Precision is hitting the same spot repeatedly; accuracy is hitting the bullseye. You can be precise but inaccurate (all shots cluster together but miss the target), or accurate but imprecise (shots average on target but scatter widely).
Reference Ranges
How reference ranges are established: 1. Select healthy reference population (at least 120 individuals) 2. Exclude individuals with conditions affecting the analyte 3. Measure the analyte in all subjects 4. Calculate the central 95% of values (2.5th to 97.5th percentiles)
Non-parametric method (preferred): Simply take the 2.5th and 97.5th percentile values. Doesn’t assume normal distribution.
Parametric method: Mean ± 2 SD. Only valid if data are normally distributed.
Implications: - By definition, 5% of healthy people fall outside the “normal” range - The more tests you order, the higher the probability of at least one “abnormal” result in a healthy person - With 20 independent tests: 1 - (0.95)^20 = 64% chance of at least one abnormal value
Method Comparison and Validation
Correlation and Regression
When validating a new method against an established one:
Correlation coefficient (r): Measures strength of linear relationship (-1 to +1) - r > 0.95 generally acceptable - BUT correlation doesn’t assess bias
Linear regression: y = mx + b - m (slope) should be close to 1.0 - b (y-intercept) should be close to 0 - Slope ≠ 1 indicates proportional bias - Intercept ≠ 0 indicates constant bias
Deming regression: Better than ordinary least-squares regression when both methods have error (which is always true for laboratory methods).
Bland-Altman Analysis
Bland-Altman (difference) plots are superior to correlation for method comparison: - X-axis: Average of the two methods - Y-axis: Difference between the methods - Horizontal lines show mean difference (bias) and limits of agreement (±1.96 SD)
What it shows: - Systematic bias: Mean difference not equal to zero - Proportional bias: Difference changes with concentration (sloped pattern) - Outliers: Points outside limits of agreement - Heteroscedasticity: Spread changes with concentration
Common Laboratory Calculations
Anion Gap
Anion Gap = Na - (Cl + HCO3)
Normal: 8-12 mEq/L (varies by method)
Elevated anion gap: Unmeasured anions present - Mnemonic: MUDPILES (Methanol, Uremia, DKA, Propylene glycol, Isoniazid/Iron, Lactic acidosis, Ethylene glycol, Salicylates)
Correction for albumin: For every 1 g/dL decrease in albumin below 4, add 2.5 to the expected anion gap (albumin is an unmeasured anion).
Osmolal Gap
Calculated osmolality = 2(Na) + Glucose/18 + BUN/2.8
Osmolal gap = Measured osmolality - Calculated osmolality
Normal: <10 mOsm/kg
Elevated osmolal gap: Unmeasured osmoles present (toxic alcohols-methanol, ethylene glycol, isopropanol)
Corrected Calcium
For hypoalbuminemia: Corrected Ca = Measured Ca + 0.8 × (4 - Albumin)
Or measure ionized calcium directly (preferred in critical illness).
LDL Cholesterol (Friedewald Equation)
LDL = Total Cholesterol - HDL - (Triglycerides / 5)
Not valid if: Triglycerides >400 mg/dL, non-fasting sample, or type III hyperlipoproteinemia
Creatinine Clearance (Cockcroft-Gault)
CrCl = [(140 - age) × weight (kg)] / [72 × serum creatinine]
Multiply by 0.85 for women.
Note: This estimates creatinine clearance, not GFR. eGFR equations (CKD-EPI, MDRD) are now preferred for most purposes.
Reticulocyte Production Index
RPI = Reticulocyte % × (Patient Hct / Normal Hct) × (1 / Maturation factor)
Maturation factor: 1.0 (Hct 45%), 1.5 (Hct 35%), 2.0 (Hct 25%), 2.5 (Hct 15%)
RPI >2-3 indicates adequate marrow response to anemia; RPI <2 indicates inadequate response (hypoproliferative anemia).
Chapter 52: Quality Management Systems
51.1 The Quality Management Framework
Quality in the clinical laboratory encompasses everything from test ordering to result reporting and interpretation. A quality management system (QMS) provides the organizational structure, processes, and resources needed to achieve quality objectives.
Key components of a laboratory QMS: - Document control and records management - Personnel qualifications and competency assessment - Equipment management - Process control (including QC) - Nonconformance management and corrective action - Internal audits - Continuous quality improvement
51.2 Pre-analytical, Analytical, and Post-analytical Phases
Laboratory errors can occur at any phase of the testing process:
Pre-analytical phase (~60-70% of errors): - Test ordering (appropriate test selection) - Patient preparation - Specimen collection (identification, technique) - Specimen transport and handling - Specimen processing
Analytical phase (~10-15% of errors): - Instrument malfunction - Reagent problems - Calibration issues - QC failures
Post-analytical phase (~20-25% of errors): - Result transcription/entry - Result interpretation - Critical value notification - Report delivery
Total testing process recognizes that laboratory quality extends from the clinical question through to the clinical action taken on results.
51.3 Internal Quality Control
Quality control is the safety net that catches analytical errors before they harm patients. The concept is simple: if you analyze a sample with a known value and get the expected result, you have evidence that the test system is working properly. If the control result is wrong, something is wrong with the test system, and patient results from that run cannot be trusted.
The Logic of Control Materials
Control materials are samples with known analyte concentrations that behave like patient samples. When you run a control alongside patient samples, it goes through the exact same analytical process. If the instrument correctly measures the control, it’s presumably correctly measuring the patients.
Good control materials share the matrix (the fluid composition) of patient samples. A control dissolved in water might behave differently than one in a protein-rich serum matrix. Controls should cover the clinically important range-a normal level control and an abnormal level control ensure the test works across the decision-making range.
Many laboratories use two or three levels of controls, run at the beginning of each shift or each day of testing. This seems like a lot of effort, but consider the alternative: without QC, you might not discover a problem until clinicians notice that results don’t match clinical findings-by which time hundreds of erroneous results may have been reported.
Understanding Statistical Process Control
Laboratory QC applies statistical process control principles developed in manufacturing. The fundamental insight is that even when a test is working properly, results vary slightly from measurement to measurement due to random factors. This variation follows a predictable pattern-the normal (Gaussian) distribution.
When you establish QC ranges, you analyze the control material many times (at least 20 runs over 20 days) to determine the mean and standard deviation of that variation. In a normal distribution, about 68% of values fall within 1 SD of the mean, 95% within 2 SD, and 99.7% within 3 SD.
This means that even when everything is working correctly, you expect about 5% of control values to exceed 2 SD by chance alone. If you reject every run where a control exceeds 2 SD, you’ll reject many perfectly good runs-a problem called “false rejection.” But if you’re too permissive, you’ll miss true errors.
The Westgard Rules: Balancing Sensitivity and Specificity
The Westgard multi-rule QC system solves this problem by using multiple rules together. A single control exceeding 2 SD (the “1:2s rule”) is just a warning that triggers closer inspection-it’s not grounds for rejection because it could easily be chance. But patterns that are unlikely to occur by chance signal true problems.
The 1:3s rule rejects when a single control exceeds 3 SD. By chance, this should happen only 0.3% of the time. When it does happen, something is almost certainly wrong.
The 2:2s rule rejects when two consecutive controls exceed 2 SD in the same direction. While a single value exceeding 2 SD is common (5% chance), two consecutive values both exceeding 2 SD on the same side has only a 0.25% probability by chance. This pattern suggests a systematic error-the test has shifted away from the true value.
The R:4s rule (“range” rule) rejects when one control exceeds +2 SD and another exceeds -2 SD in the same run. This spread-a range of more than 4 SD-indicates excessive random error, such as a pipetting problem or an unstable reagent.
The 4:1s and 10x rules detect trends and shifts. Four consecutive values on the same side of the mean (even if within 1 SD) or ten consecutive values on the same side suggests the method is drifting. Catch it early before it becomes a larger problem.
Random Errors vs. Systematic Errors
Understanding error types helps you troubleshoot QC failures.
Random errors are unpredictable-a bubble in a pipette, electrical interference, a scratched cuvette. They increase imprecision (results scatter more widely) but don’t consistently push results in one direction. The R:4s rule catches large random errors.
Systematic errors consistently shift results in one direction-an incorrectly prepared calibrator, a deteriorating reagent, or a temperature drift. They cause bias (results are consistently too high or too low). The 2:2s, 4:1s, and 10x rules catch systematic errors.
When QC fails, think about which rules were violated to guide your investigation. A 1:3s violation could be random (try repeating the control), while a 2:2s violation suggests you need to look for systematic causes like reagent problems or calibration drift.
51.4 External Quality Assessment (Proficiency Testing)
Proficiency testing (PT) evaluates laboratory performance by comparing results on unknown samples to peer laboratories and/or reference values.
CLIA requirements: - Participation in approved PT program for each regulated analyte - Analysis must be performed by routine methods and personnel - Results cannot be shared with other laboratories during testing - Unsatisfactory performance requires root cause analysis and corrective action - Two consecutive or two of three consecutive failures = unsuccessful
Benefits of PT: - Identifies systematic bias - Provides peer comparison - Detects method-specific problems - Required for regulatory compliance
51.5 Six Sigma in the Laboratory
Six Sigma is a data-driven quality improvement methodology that measures process performance in terms of defects per million opportunities.
Sigma metric: Number of standard deviations between the process mean and the nearest specification limit
Sigma calculation for laboratory tests: σ = (TEa - |Bias|) / CV
Where: - TEa = Total allowable error (from CLIA or biological variation) - Bias = Systematic error (difference from true value) - CV = Coefficient of variation (imprecision)
Interpretation: - 6σ: World-class (3.4 defects per million) - 5σ: Excellent - 4σ: Good (industry standard for most labs) - 3σ: Marginal (minimum acceptable) - <3σ: Unacceptable
Higher sigma allows less frequent QC; lower sigma requires more frequent QC monitoring.
51.6 Lean Methodology
Lean focuses on eliminating waste and improving efficiency.
The eight wastes (DOWNTIME): - Defects: Errors requiring rework - Overproduction: Doing more than needed - Waiting: Idle time - Non-utilized talent: Underusing staff skills - Transportation: Unnecessary movement of materials - Inventory: Excess stock - Motion: Unnecessary movement of people - Extra-processing: Doing more than required
5S methodology: - Sort: Remove unnecessary items - Set in order: Organize remaining items - Shine: Clean workspace - Standardize: Create consistent processes - Sustain: Maintain improvements
Value stream mapping: Analyzes process flow to identify waste and bottlenecks
Chapter 53: Regulations and Accreditation
52.1 CLIA (Clinical Laboratory Improvement Amendments)
CLIA regulates all laboratory testing performed on human specimens in the United States (with limited exceptions for forensics and research).
Test categorization by complexity:
| Category | Characteristics | QC Requirements | Personnel |
|---|---|---|---|
| Waived | Simple, minimal risk | Manufacturer instructions | Minimal requirements |
| Moderate complexity | Most routine tests | 2 levels/day of testing | High school diploma; training |
| High complexity | Complex tests, significant expertise needed | 2 levels/day of testing | Associate degree; specialized training |
Key CLIA requirements: - Certificate (waived, PPM, accreditation, or compliance) - Patient test management (positive identification, result reporting) - Quality control - Quality assessment - Proficiency testing - Personnel qualifications and competency - Procedure manual
Personnel qualifications:
| Role | High Complexity | Moderate Complexity |
|---|---|---|
| Laboratory Director | MD/DO + board certification, or PhD + training | Same, or lower with experience |
| Technical Supervisor | Bachelor’s + 2 years experience | Bachelor’s + 2 years, or MLT + 4 years |
| General Supervisor | Bachelor’s + 1 year | Associate’s + 2 years, or high school + 4 years |
| Testing Personnel | High school + training | High school + training |
52.2 Accreditation Organizations
CAP (College of American Pathologists): - Voluntary accreditation - Deemed status for CLIA compliance - Biennial inspection by peer laboratories - Standards often exceed CLIA requirements - Emphasis on quality management systems
The Joint Commission (TJC): - Accredits hospitals (including laboratories) - Focuses on patient safety - Sentinel event reporting
AABB (for transfusion services): - Voluntary accreditation for blood banks and transfusion services - Standards for blood collection, processing, and transfusion
52.3 Other Regulatory Requirements
FDA (Food and Drug Administration): - Regulates in vitro diagnostic devices (IVDs) - Pre-market approval (PMA) or 510(k) clearance for commercial tests - Laboratory-developed tests (LDTs): Historically under enforcement discretion; evolving regulation
OSHA (Occupational Safety and Health Administration): - Bloodborne Pathogen Standard (29 CFR 1910.1030) - Exposure control plan - Universal/standard precautions - Personal protective equipment - Hepatitis B vaccination - Post-exposure evaluation - Chemical Hygiene Plan - Hazard Communication Standard (chemical labeling, SDS)
HIPAA (Health Insurance Portability and Accountability Act): - Privacy Rule: Protects patient health information - Security Rule: Electronic data protection - Minimum necessary standard - Patient rights to access records - Breach notification requirements
52.4 Laboratory Inspection and Compliance
Preparing for inspection: - Document control current - Policies and procedures up to date - Personnel files complete (qualifications, competency) - QC and QA records organized - Proficiency testing records available - Equipment maintenance logs current - Problem logs and corrective actions documented
Common deficiencies: - Incomplete personnel competency documentation - QC not performed or documented properly - Procedures not followed or not updated - Specimen labeling issues - Critical value notification not documented
Chapter 54: Laboratory Operations
53.1 Test Utilization Management
Appropriate test utilization ensures the right test is ordered for the right patient at the right time.
Overutilization problems: - Increased costs - Patient harm from unnecessary follow-up - Downstream imaging and procedures - Anxiety from false positives
Underutilization problems: - Missed diagnoses - Delayed treatment - Increased morbidity
Utilization management strategies: - Clinical decision support (alerts, order guidance) - Reflex and cascade testing protocols - Test menus designed for clinical relevance - Education and feedback to clinicians - Hard stops for inappropriate orders
53.2 Turnaround Time (TAT)
TAT is the interval from specimen collection (or order) to result availability.
Components: - Order to collection - Collection to receipt in lab - Receipt to testing - Testing to result validation - Result to clinician notification
Monitoring and improvement: - Define TAT targets based on clinical needs (STAT vs. routine) - Track TAT metrics (median, outliers) - Identify bottlenecks through workflow analysis - Implement process improvements
53.3 Critical Values
Critical values are results that require immediate communication because they represent life-threatening conditions.
Elements of a critical value program: - Defined list of critical values (specific to institution and patient population) - Notification procedures (who, how, when) - Time limits (typically 30-60 minutes) - Read-back verification - Documentation of notification (date, time, person notified, person calling) - Monitoring and escalation procedures
53.4 Reference Laboratory Management
Selecting a reference laboratory: - Test menu and methodology - Turnaround time - Quality indicators (accreditation, PT performance) - Cost - Specimen requirements - Customer service
Managing send-out testing: - Specimen preparation protocols - Tracking systems - Result verification and entry - Communication of critical values
53.5 Cost Analysis and Financial Management
Cost components: - Direct costs: Reagents, supplies, labor directly involved in testing - Indirect costs: Overhead (facilities, administration, utilities)
Cost per test = (Direct costs + Indirect costs) / Number of tests
Productivity metrics: - Tests per FTE (full-time equivalent) - Cost per test - Revenue vs. expense ratios
Strategies for cost reduction: - Consolidation of testing - Automation - Eliminating unnecessary tests - Negotiating contracts - Reducing waste
Chapter 55: Laboratory Information Systems
The Laboratory Information System (LIS) is the digital backbone of the modern laboratory. Every order, every specimen, every result, every billing transaction flows through this system. Understanding LIS concepts matters because the integrity of patient care depends on accurate, timely data flow.
54.1 The LIS as the Laboratory’s Central Nervous System
The LIS manages the complete lifecycle of laboratory testing. When a clinician orders a test, that order must reach the laboratory. When the specimen arrives, it must be logged, tracked, and matched to the order. When the analyzer produces a result, that result must be captured, validated, and reported back to the clinician. Every step must be documented, traceable, and secure.
The core functions reflect this lifecycle: order management (receiving and processing test requests), specimen tracking (knowing where every tube is at every moment), result management (capturing, reviewing, and reporting results), and quality management (monitoring QC, tracking errors, generating reports for regulatory compliance).
54.2 Interfaces: Making Systems Talk to Each Other
Healthcare is plagued by disconnected information systems. The LIS must communicate with the hospital’s electronic medical record (EMR), with analyzers on the bench, with billing systems, and potentially with public health registries. This communication happens through interfaces-electronic connections that pass data between systems.
HL7 (Health Level Seven) is the standard messaging format that makes this communication possible. HL7 messages are structured text strings that contain segments of information. When you order a test in the EMR, an ORM (Order Message) is sent to the LIS. When the result is ready, an ORU (Observation Result) message returns it to the EMR. When a patient is admitted or discharged, ADT (Admit/Discharge/Transfer) messages update the patient’s location and status.
The critical concept is that interfaces can fail. Messages can be lost, duplicated, or corrupted. A bidirectional interface (where data flows both ways) is more useful but more complex than a unidirectional interface. Interface validation-ensuring that what goes in one end comes out the other correctly-is essential when setting up new connections.
54.3 Middleware and Auto-verification
Between the analyzer and the LIS sits middleware-software that applies rules to results before they reach the LIS. This layer enables auto-verification, one of the most important efficiency tools in the modern laboratory.
The concept behind auto-verification is simple: most results are normal or unremarkably abnormal and don’t require a technologist’s interpretation. By defining rules that identify which results can be released automatically, you free technologists to focus on the results that need human judgment.
Auto-verification rules typically check: Is the result within the reportable range? Is QC acceptable? Are there instrument flags suggesting a problem (clot, hemolysis, bubble)? Does this result make sense given the patient’s previous results (delta check)? Are there conflicting results that need resolution?
When all rules pass, the result is released without human review. When any rule fails, the result is held for technologist review. The key is that auto-verification must be validated-you must prove that the rules correctly identify which results can be safely released-and continuously monitored.
54.4 Data Integrity and Security
Laboratory data is medical data, subject to HIPAA and other regulations. The principles that govern data integrity apply: every change must be traceable (audit trails), access must be limited to those with a need (role-based permissions), data must be protected from loss (backup and disaster recovery), and systems must be protected from attack (cybersecurity).
Cybersecurity has become increasingly critical as healthcare has become a target for ransomware and data theft. Laboratory systems, often running older software, can be vulnerable. Defense in depth-multiple layers of protection including firewalls, encryption, access controls, and staff training-is essential.
Chapter 56: Patient Safety in the Laboratory
Most laboratory errors don’t occur during analysis-they occur before the specimen reaches the analyzer (pre-analytical) or after the result leaves it (post-analytical). Patient safety in the laboratory means understanding where errors happen and building systems to prevent them.
55.1 Specimen Identification: The Most Dangerous Error
A mislabeled specimen is perhaps the most dangerous error in laboratory medicine. If blood from Patient A is labeled as Patient B, the results will be attributed to the wrong patient. Patient A might receive treatment based on someone else’s values. Patient B might not receive treatment they need. In transfusion medicine, this error can be fatal-give Patient A blood matched to Patient B’s type and you may cause a fatal hemolytic reaction.
The solution is rigorous identification procedures at the point of collection. The standard requires two patient identifiers-typically name and date of birth, or name and medical record number. Identification must be confirmed with the patient directly (not from a wristband alone, which could be on the wrong patient). Labeling must occur at the bedside, immediately after collection, before the phlebotomist leaves the patient.
Technology helps. Barcoding systems that require scanning patient wristbands and specimen labels reduce transcription errors. Positive patient identification systems that require biometric or photographic confirmation add additional safety. But technology doesn’t replace the fundamental principle: verify identity before you draw, label before you leave.
55.2 Error Reporting and Root Cause Analysis
Errors will happen despite our best efforts. The question is whether we learn from them or repeat them. A culture of safety requires a non-punitive approach to error reporting-staff must feel safe reporting mistakes without fear of punishment, or errors will be hidden rather than addressed.
When errors occur, root cause analysis (RCA) identifies the underlying system failures. The goal is to ask “why” repeatedly until you reach a root cause that, if corrected, would prevent recurrence. A technologist entering a result incorrectly is not the root cause-you must ask why the error occurred. Was the interface confusing? Was the technologist distracted by a system that generates too many alerts? Was staffing inadequate?
Tools like the fishbone (Ishikawa) diagram organize potential causes into categories: equipment, process, people, materials, environment, management. The “5 Whys” technique involves asking “why” successively until you reach a root cause. The output of RCA is corrective action-a system change that addresses the root cause. - Failure mode and effects analysis (FMEA)
55.3 Hemolysis and Interference
Pre-analytical hemolysis is a major source of rejected specimens and spurious results.
Causes: - Traumatic venipuncture - Improper needle gauge - Mixing too vigorously - Expired tubes - Improper transport (temperature extremes, pneumatic tube trauma)
Detection: Hemolysis index on modern analyzers (spectrophotometric detection)
Management: - Reject specimens exceeding hemolysis threshold for affected tests - Report with appropriate comments if result provided - Investigate root causes if hemolysis rates are high
Chapter 57: Point-of-Care Testing
Point-of-care testing (POCT), also called bedside testing or near-patient testing, moves laboratory analysis from the central laboratory to the patient’s location. It trades some analytical precision for immediate results that can drive faster clinical decisions.
56.1 Why POCT Matters
The fundamental value of POCT is turnaround time. A glucose result available in 30 seconds at the bedside is more useful for titrating an insulin drip than a more precise result available in 30 minutes from the central lab. The clinical decision can be made immediately, while the patient is still in front of the clinician.
POCT is most valuable when rapid results change management and when waiting for central lab results would harm the patient. Classic applications include:
Glucose monitoring: Insulin dosing decisions can’t wait for central lab turnaround. Bedside glucometers provide immediate results, though with wider analytical variation than central lab instruments.
Blood gases and electrolytes: In critically ill patients, acid-base status and electrolyte abnormalities require immediate intervention. Devices like the i-STAT bring blood gas analysis to the bedside or the operating room.
Cardiac biomarkers: In chest pain evaluation, rapid troponin results accelerate the decision to treat or discharge. Point-of-care troponin assays are increasingly used in emergency departments.
Coagulation testing: INR monitoring in anticoagulation clinics and ACT (activated clotting time) monitoring during cardiac surgery require immediate results to guide therapy.
Infectious disease: Rapid strep tests, influenza tests, and COVID-19 antigen tests provide immediate answers that guide treatment and isolation decisions.
56.2 The Quality Challenge
POCT presents unique quality management challenges. When testing moves from the controlled central lab environment to clinical areas, many things can go wrong:
Operator variability: Central lab testing is performed by trained medical laboratory scientists. POCT is often performed by nurses, respiratory therapists, or physicians with variable training and experience. Competency assessment and ongoing training are essential.
Environmental factors: Central labs are climate-controlled. POCT devices may be exposed to temperature extremes, humidity, vibration, and other environmental stresses. Devices must be validated for the conditions where they’ll be used.
Quality control: Central labs run QC materials at defined intervals with rigorous documentation. POCT QC is often less structured. Establishing and enforcing QC schedules across dispersed testing sites is challenging.
Documentation: Every result needs to be associated with the correct patient. Without the structured workflow of the central lab, patient identification errors are more common. Interface with the electronic medical record is critical.
56.3 Regulatory Requirements
POCT is regulated just like central laboratory testing. Under CLIA (Clinical Laboratory Improvement Amendments), each POCT site is either included under the hospital’s main laboratory certificate or has its own certificate. The complexity of the test determines the regulatory requirements:
Waived tests: Simple tests approved by FDA for home use or with minimal risk of error. Examples include urine dipsticks, fecal occult blood tests, and simple glucose meters. Quality requirements are minimal, but the laboratory must still follow manufacturer instructions and document testing.
Moderate complexity tests: Most POCT falls here. Requires documented training, competency assessment, quality control, and proficiency testing. Examples include i-STAT analyzers and most rapid infectious disease tests.
High complexity tests: Rarely performed as POCT. Requires extensive quality systems similar to central laboratory.
56.4 Glucose Meter Limitations
Glucose meters deserve special attention because they’re ubiquitous, their results directly drive insulin dosing, and they have important limitations:
Hematocrit effects: Most glucose meters measure glucose in whole blood but report a “plasma equivalent” value. The conversion assumes normal hematocrit. In severely anemic patients, glucose readings may be falsely high; in polycythemic patients, falsely low.
Oxygen effects: Some glucose oxidase-based meters are affected by oxygen tension. In patients on supplemental oxygen or with severe hypoxia, results may be inaccurate.
Interfering substances: Various medications and conditions can interfere with specific glucose meter technologies. Maltose in some IV immunoglobulin products can cause falsely elevated readings with certain meters.
Critically ill patients: Multiple factors in critically ill patients (hypotension, edema, medications) can affect glucose meter accuracy. Many hospitals mandate central lab glucose confirmation for critically ill patients.
PART VI: MOLECULAR PATHOLOGY
Molecular pathology represents the application of molecular biology techniques to the diagnosis and management of disease. It has transformed medicine by enabling detection of genetic mutations, infectious agents, and molecular markers with unprecedented sensitivity and specificity. Understanding these techniques-how they work, their strengths, and their limitations-is essential for interpreting results and knowing when to order them.
Chapter 58: Molecular Biology Fundamentals
Before understanding molecular diagnostic tests, you must understand the molecules being tested. The central insight of molecular biology is that genetic information flows from DNA to RNA to protein, and disruptions at any level can cause disease.
57.1 Nucleic Acid Structure: The Information Molecules
DNA: The Archive
DNA (deoxyribonucleic acid) is the hereditary material-the stable repository of genetic information. Its structure explains its function.
The double helix: DNA consists of two strands wound around each other, held together by hydrogen bonds between complementary base pairs. This structure provides redundancy-damage to one strand can be repaired using the other as a template.
Chemical structure: Each strand is a polymer of nucleotides. Each nucleotide contains: - A deoxyribose sugar (the five-carbon sugar missing an oxygen at the 2’ position) - A phosphate group (linking nucleotides together via phosphodiester bonds) - A nitrogenous base (carrying the genetic information)
The four bases and base pairing: - Purines (two rings): Adenine (A) and Guanine (G) - Pyrimidines (one ring): Cytosine (C) and Thymine (T) - A always pairs with T (2 hydrogen bonds) - G always pairs with C (3 hydrogen bonds)
The G-C pairing is stronger than A-T pairing because of the extra hydrogen bond. This has practical implications: DNA regions rich in G-C have higher melting temperatures and are harder to denature.
Directionality: DNA strands have chemical polarity. The 5’ end has a free phosphate; the 3’ end has a free hydroxyl. The two strands run antiparallel (one 5’→3’, the other 3’→5’). This directionality is critical because enzymes that synthesize nucleic acids (polymerases) work only in the 5’ to 3’ direction.
The human genome: About 3 billion base pairs, organized into 23 pairs of chromosomes. Only ~1.5% encodes proteins (exons); the rest includes regulatory regions, introns, repetitive elements, and sequences of unknown function.
RNA: The Working Copy
RNA (ribonucleic acid) differs from DNA in three key ways: 1. Ribose instead of deoxyribose: The extra 2’ hydroxyl makes RNA less stable (susceptible to hydrolysis) 2. Uracil instead of thymine: U pairs with A instead of T 3. Usually single-stranded: Can fold into complex secondary structures
Types of RNA:
Messenger RNA (mRNA): Carries the genetic code from DNA to ribosomes for protein synthesis. In eukaryotes, mature mRNA has a 5’ cap (protects from degradation), a 3’ poly-A tail (stabilizes the molecule), and no introns (removed by splicing).
Transfer RNA (tRNA): Carries amino acids to the ribosome. Each tRNA has an anticodon that recognizes a specific codon on mRNA.
Ribosomal RNA (rRNA): Structural and catalytic component of ribosomes. rRNA genes are highly conserved, making them excellent targets for identifying organisms (16S rRNA in bacteria).
MicroRNA (miRNA): Small (~22 nucleotides) regulatory RNAs that silence gene expression by binding to complementary mRNA sequences.
57.2 The Central Dogma: Information Flow
The central dogma of molecular biology describes how genetic information flows:
DNA → DNA (Replication): The genome is copied before cell division
DNA → RNA (Transcription): Genes are copied into RNA
RNA → Protein (Translation): The genetic code is translated into amino acid sequence
Understanding each step is essential because molecular tests target different steps.
Replication: Copying the Genome
Before a cell divides, it must copy its entire genome. This process is remarkably accurate-only about 1 error per billion nucleotides copied.
Key features: - Semi-conservative: Each daughter double helix contains one original strand and one newly synthesized strand - DNA polymerase synthesizes 5’ to 3’: The enzyme adds nucleotides to the 3’ end of a growing strand - Requires a primer: DNA polymerase cannot start synthesis de novo; it needs a short RNA primer - Proofreading: DNA polymerase has 3’ to 5’ exonuclease activity to correct errors
Clinical relevance: Many chemotherapy drugs target replication (antimetabolites, topoisomerase inhibitors). Understanding replication also explains how mutations occur-replication errors that escape proofreading.
Transcription: Making RNA from DNA
Gene expression begins with transcription-copying a gene into RNA.
The process: 1. RNA polymerase binds to the promoter region upstream of the gene 2. The enzyme unwinds DNA and reads the template strand 3’ to 5’ 3. RNA is synthesized 5’ to 3’, complementary to the template (identical to the coding strand, except U replaces T) 4. Transcription continues until a termination signal
In eukaryotes, the primary transcript (pre-mRNA) must be processed: - 5’ capping: A modified guanine is added to protect from degradation - 3’ polyadenylation: A poly-A tail (100-250 adenines) is added - Splicing: Introns are removed, and exons are joined together
Alternative splicing allows one gene to produce multiple proteins by including different combinations of exons. This explains why humans have ~20,000 genes but many more proteins.
Translation: Making Protein from mRNA
The ribosome reads mRNA in triplet codons, each specifying an amino acid.
The genetic code: - 64 codons (4³ = 64 combinations of 3 nucleotides) - 61 sense codons (specify amino acids) - 3 stop codons (UAA, UAG, UGA-terminate translation) - AUG is the start codon (also codes for methionine)
Degeneracy: The code is degenerate-most amino acids are specified by multiple codons (e.g., leucine has 6 codons). This provides some protection against mutations-a change in the third position of a codon often doesn’t change the amino acid (wobble position).
57.3 Mutations: When the Code Changes
Mutations are changes in the DNA sequence. They can be inherited (germline, present in every cell) or acquired (somatic, present only in certain cells like a tumor).
Point Mutations (Single Nucleotide Variants)
A change in a single base pair.
Silent (synonymous) mutations: The new codon specifies the same amino acid. No protein change. Often occurs at the wobble position. - Example: CGA → CGG (both code for arginine)
Missense mutations: The new codon specifies a different amino acid. Effect depends on how critical that amino acid is. - Conservative: New amino acid has similar properties (may have little effect) - Non-conservative: New amino acid has different properties (often pathogenic) - Example: HbS mutation (sickle cell)-GAG → GTG changes glutamic acid to valine
Nonsense mutations: The new codon is a stop codon. Translation terminates prematurely, usually producing a nonfunctional truncated protein. - Example: CGA (arginine) → TGA (stop)
Insertions and Deletions (Indels)
Nucleotides added to or removed from the sequence.
Frameshift mutations: When the number of nucleotides inserted or deleted is NOT a multiple of 3, the reading frame shifts. Every codon downstream is wrong, usually leading to a premature stop codon. Almost always loss-of-function.
In-frame mutations: When 3 (or a multiple of 3) nucleotides are added or deleted, the reading frame is preserved. One or more amino acids are added or removed. May or may not be pathogenic depending on the location. - Example: The ΔF508 mutation in CFTR (cystic fibrosis) is an in-frame deletion of 3 nucleotides, removing a single phenylalanine-but this is pathogenic because the phenylalanine is essential for protein folding.
Splice Site Mutations
Mutations at intron-exon boundaries disrupt normal splicing. Consequences include: - Exon skipping (exon is left out) - Intron retention (intron is included) - Cryptic splice site activation (nearby sequence is used instead)
The result is usually an abnormal mRNA that produces a nonfunctional protein.
Large-Scale Mutations
Deletions and duplications: Loss or gain of large DNA segments (exons, entire genes, or chromosomal regions). Detected by techniques that measure copy number (MLPA, arrays, read depth in NGS).
Translocations: Two chromosomes exchange segments. Can create oncogenic fusion genes (BCR-ABL1 in CML, PML-RARA in APL).
Inversions: A chromosomal segment is reversed. May disrupt genes at the breakpoints.
57.4 Nomenclature: Speaking the Language
Standardized nomenclature (HGVS - Human Genome Variation Society) ensures mutations are described unambiguously.
Sequence type prefixes: - g. = genomic (chromosomal position) - c. = coding DNA (position relative to translation start) - p. = protein (amino acid position) - r. = RNA
Common notations: - c.123A>G: Substitution of A to G at position 123 of the coding sequence - c.123_124delAT: Deletion of AT at positions 123-124 - c.123_124insGGG: Insertion of GGG between positions 123 and 124 - c.123+1G>A: Substitution in the first nucleotide of an intron (+1 is first intronic position after the exon) - p.Glu123Val or p.E123V: Glutamic acid to valine at protein position 123 - p.Glu123*: Glutamic acid to stop codon (nonsense) - p.Glu123fs: Frameshift starting at position 123
Understanding this nomenclature is essential for interpreting molecular pathology reports.
Chapter 59: Molecular Techniques
The power of molecular diagnostics lies in its techniques-methods that can detect single copies of DNA, identify specific mutations, and characterize entire genomes. Understanding how these techniques work allows you to appreciate their capabilities and limitations.
58.1 Nucleic Acid Extraction: Getting the Material
Every molecular test begins with extracting nucleic acid from the clinical specimen. The quality of the extraction determines the quality of the test.
Specimen Types and Their Challenges
Blood: The most common source for constitutional (germline) testing. EDTA is the preferred anticoagulant (heparin inhibits PCR). DNA is extracted from white blood cells (RBCs lack nuclei). For RNA testing, cells must be processed quickly or stabilized (PAXgene tubes) because RNA degrades rapidly.
Fresh/frozen tissue: Provides high-quality DNA and RNA. Best for research and molecular profiling.
Formalin-fixed, paraffin-embedded (FFPE) tissue: The standard for surgical pathology, but problematic for molecular testing. Formalin causes: - Cross-linking between DNA strands and between DNA and proteins - Fragmentation (average fragment size 200-300 bp) - Cytosine deamination (creates artifactual C→T changes)
Modern molecular tests are increasingly designed to work with degraded FFPE DNA, but results should be interpreted cautiously.
Body fluids: CSF, pleural fluid, urine. Cell-free DNA (cfDNA) in plasma is now used for liquid biopsy.
Swabs: Nasopharyngeal, oropharyngeal, cervical. Primary source for infectious disease testing.
Extraction Methods
The goal is to separate nucleic acids from proteins, lipids, and other cellular components.
Organic extraction (phenol-chloroform): The traditional method. Proteins partition into the organic phase; DNA stays in the aqueous phase. Labor-intensive and uses hazardous chemicals, but produces very pure DNA. Now largely replaced by other methods.
Solid-phase extraction (silica columns): The workhorse of modern extraction. Principle: In the presence of chaotropic salts (guanidinium), DNA binds to silica while proteins and other contaminants wash through. DNA is then eluted in low-salt buffer. Available in spin column or automated formats.
Magnetic bead-based extraction: Similar principle to silica columns, but nucleic acid binds to magnetic beads that are captured by a magnet. Highly automatable and scalable.
Quality Assessment
Purity: Spectrophotometry measures absorbance at 260 nm (nucleic acid) and 280 nm (protein). A260/A280 ratio of ~1.8 for DNA and ~2.0 for RNA indicates good purity. Low ratios suggest protein contamination; high ratios suggest RNA contamination of DNA.
Quantity: Spectrophotometry (less accurate) or fluorometry using DNA-binding dyes (PicoGreen, Qubit). Fluorometry is more accurate, especially for low concentrations.
Integrity: For DNA-visualize on gel or automated electrophoresis (high molecular weight band indicates intact DNA). For RNA-calculate RNA Integrity Number (RIN) based on the ratio of 28S to 18S rRNA peaks. RIN of 7+ is generally acceptable for sensitive applications.
58.2 Polymerase Chain Reaction (PCR): The Foundation
PCR is the single most important technique in molecular diagnostics. It allows selective amplification of a specific DNA sequence, generating millions of copies from a single template molecule.
The Principle: Exponential Amplification
PCR exploits the ability of DNA polymerase to synthesize a complementary strand. By using two primers that flank the region of interest and cycling through temperatures that denature DNA, anneal primers, and extend, you create an exponential chain reaction.
The components: - Template DNA: The sample containing the sequence to be amplified - Primers: Short oligonucleotides (~18-25 bp) that define the boundaries of amplification. One primer binds each strand, flanking the target. - Thermostable DNA polymerase: Usually Taq (from Thermus aquaticus). Survives the denaturation temperature. - dNTPs: The four deoxynucleotides (dATP, dTTP, dGTP, dCTP)-building blocks for new DNA - Buffer: Provides optimal pH and ion concentrations; includes Mg2+ (essential cofactor for polymerase)
The three-step cycle:
Denaturation (~94-98°C): Heat separates the double-stranded DNA into single strands
Annealing (~50-65°C): Temperature is lowered to allow primers to bind (anneal) to their complementary sequences on the template. The annealing temperature depends on primer composition (higher G-C content → higher Tm → higher annealing temperature).
Extension (~72°C): The optimal temperature for Taq polymerase. The enzyme extends from the 3’ end of each primer, synthesizing the complementary strand.
Exponential amplification: After each cycle, the number of target molecules doubles. After n cycles: 2^n copies. After 30 cycles: 2^30 ≈ 1 billion copies. This exponential amplification is both the power and the danger of PCR-contamination is readily amplified.
Reverse Transcription PCR (RT-PCR)
Standard PCR amplifies DNA. To amplify RNA (for gene expression analysis or RNA virus detection), you first convert RNA to complementary DNA (cDNA) using reverse transcriptase.
The process: 1. Reverse transcriptase synthesizes cDNA from an RNA template 2. The cDNA is then amplified by standard PCR
Priming options: - Oligo(dT): Hybridizes to the poly-A tail; converts all mRNA - Random hexamers: Prime throughout; converts all RNA (including non-polyadenylated) - Gene-specific primers: Convert only the target gene
Applications: HIV viral load (HIV RNA genome), SARS-CoV-2 detection (RNA virus), gene expression studies.
Real-Time PCR (Quantitative PCR, qPCR)
Conventional PCR is qualitative-you see a band or you don’t. Real-time PCR monitors amplification as it happens, enabling quantification.
The concept: A fluorescent signal increases as DNA is amplified. By measuring when fluorescence crosses a threshold, you can determine how much template was present initially.
Ct (Cycle threshold): The cycle number at which fluorescence exceeds the threshold. Lower Ct = more starting template (reached threshold sooner). The relationship is logarithmic-each 3.32-cycle difference in Ct represents a 10-fold difference in starting material.
Detection chemistries:
SYBR Green: An intercalating dye that fluoresces when bound to double-stranded DNA. Simple and inexpensive, but non-specific-it detects ANY double-stranded DNA, including primer dimers. Requires melt curve analysis to confirm specificity.
TaqMan probes: A probe with a fluorophore at one end and a quencher at the other. When intact, the quencher suppresses fluorescence. During PCR, Taq polymerase’s 5’→3’ exonuclease activity cleaves the probe, separating fluorophore from quencher and generating signal. Highly specific-signal is generated only if the probe hybridizes to the correct sequence.
Molecular beacons: Hairpin-shaped probes that fluoresce only when bound to target. The hairpin brings fluorophore and quencher together; hybridization opens the hairpin.
Quantification approaches: - Absolute quantification: Compare Ct to a standard curve of known concentrations. Used for viral loads. - Relative quantification: Compare target gene expression to a reference gene (housekeeping gene). Used for gene expression studies.
Digital PCR
The newest evolution of PCR. Instead of measuring fluorescence in real-time, digital PCR partitions the sample into thousands of individual reactions (droplets or chambers). Each partition either has template (positive) or doesn’t (negative). By counting positive and negative partitions, you calculate the absolute number of template molecules using Poisson statistics.
Advantages: - Absolute quantification without a standard curve - More precise than qPCR - Can detect rare variants (1 mutant in 10,000 wild-type)
Applications: Detecting minimal residual disease, monitoring transplant rejection (donor cfDNA), liquid biopsy.
58.3 DNA Sequencing: Reading the Code
Sequencing determines the actual nucleotide sequence of DNA. It’s the definitive way to identify mutations.
Sanger Sequencing: The Gold Standard
Developed by Frederick Sanger in 1977, this method remains important for confirming variants and sequencing small targets.
The principle (chain-termination method):
DNA synthesis requires a 3’ hydroxyl group to form the phosphodiester bond. Dideoxynucleotides (ddNTPs) lack the 3’ hydroxyl-when incorporated, they terminate chain elongation.
The process: 1. Set up a reaction with template DNA, primer, DNA polymerase, normal dNTPs, AND a small amount of ddNTPs (each labeled with a different fluorescent color) 2. During synthesis, each time a ddNTP is incorporated instead of a dNTP, the chain terminates at that position 3. The result is a collection of fragments of all possible lengths, each terminated at a specific base 4. Capillary electrophoresis separates fragments by size 5. A detector reads the fluorescent color of each fragment as it passes, generating a sequence chromatogram
Reading a chromatogram: The tracing shows peaks of different colors, each representing a base. Clean, evenly spaced peaks indicate good sequence quality. Overlapping peaks suggest heterozygosity (germline) or mixed populations (somatic).
Limitations: - One target at a time (low throughput) - Cannot reliably detect variants below ~15-20% allele frequency - Limited read length (~700-900 bp maximum)
Current role: Confirming variants detected by NGS, sequencing single genes, low-throughput applications.
Next-Generation Sequencing (NGS)
NGS (also called massively parallel sequencing) revolutionized genomics by sequencing millions of DNA fragments simultaneously. This enables gene panels, whole exome sequencing, and whole genome sequencing.
The general workflow:
Library preparation: DNA is fragmented (enzymatically or mechanically) to ~150-500 bp. Adapters (short known sequences) are ligated to the fragment ends. Unique identifiers (barcodes/indices) can be added to pool multiple samples.
Clonal amplification: Each fragment is amplified to create a cluster of identical copies. This generates sufficient signal for detection. Methods include:
- Bridge amplification (Illumina): Fragments bind to a flow cell surface and amplify in clusters
- Emulsion PCR (Ion Torrent): Fragments are amplified on beads in water-oil emulsion droplets
Sequencing: Bases are identified as they’re incorporated:
- Illumina (sequencing by synthesis): Fluorescently labeled nucleotides are added one at a time; a camera captures which nucleotide was incorporated at each cluster
- Ion Torrent: Nucleotides are flowed in sequence; incorporation releases H+, causing a pH change detected by a semiconductor chip
Data analysis: Bioinformatics pipelines align reads to a reference genome and identify variants. This is complex and requires significant computational resources.
Key concepts:
Read length: How many bases are sequenced per fragment. Short-read platforms (Illumina, Ion Torrent) produce 75-300 bp reads. Long-read platforms (PacBio, Nanopore) produce 10,000+ bp reads. Longer reads help span repetitive regions and detect structural variants.
Depth of coverage: The number of independent reads covering each base position. Higher depth = higher confidence in variant calls = better detection of low-frequency variants. - 30x: Minimum for germline testing - 500-1000x: Needed for somatic variants at low allele frequencies - Thousands-fold: Needed for liquid biopsy detecting rare circulating tumor DNA
Paired-end sequencing: Sequencing from both ends of a fragment. Helps with alignment and detecting structural variants.
Applications by scope: - Gene panels: Targeted sequencing of selected genes (tens to hundreds). Cost-effective when the clinical question is focused (e.g., hereditary cancer panel, inherited cardiomyopathy panel). - Whole exome sequencing (WES): All protein-coding regions (~1.5% of genome, ~20,000 genes). Useful for undiagnosed genetic diseases. - Whole genome sequencing (WGS): The entire genome. Most comprehensive but most expensive. Detects non-coding variants and structural variants.
NGS Platform Comparison: Understanding the Technologies
Different NGS platforms have distinct characteristics that affect their clinical applications. Understanding these differences helps you interpret results and select appropriate testing.
Illumina (Sequencing by Synthesis with Reversible Terminators)
Illumina dominates the clinical sequencing market because of its high accuracy and throughput. The technology uses fluorescently labeled nucleotides with reversible terminators-after each incorporation event, the fluorescent label is detected and then cleaved, allowing the next nucleotide to be added.
Key characteristics: - Read length: 75-300 bp (short reads) - Error profile: Low overall error rate (~0.1-0.5%); errors are predominantly substitutions, randomly distributed - Throughput: Very high (up to terabases per run on high-end instruments) - Strengths: Excellent for variant detection, gene expression, most clinical applications - Limitations: Short reads struggle with repetitive regions and structural variants; GC-rich regions may have reduced coverage
The short read length means that repetitive regions longer than the read length cannot be spanned, making assembly difficult in these areas. However, for most clinical applications-detecting SNVs, small indels, and known fusion genes-Illumina’s accuracy makes it the platform of choice.
Ion Torrent (Semiconductor Sequencing)
Ion Torrent uses a fundamentally different detection approach: instead of fluorescence, it detects the hydrogen ion released when a nucleotide is incorporated. A semiconductor chip measures the pH change.
Key characteristics: - Read length: 200-400 bp - Error profile: Higher error rate than Illumina (~1%); predominantly indel errors, especially in homopolymer regions (stretches of the same nucleotide, like AAAA or GGGG) - Throughput: Moderate - Strengths: Faster run times, lower instrument cost, good for targeted panels - Limitations: Homopolymer errors are problematic; a stretch of 6 adenines might be called as 5 or 7
The homopolymer issue arises because the system measures the magnitude of pH change to determine how many identical nucleotides were incorporated in a row. Distinguishing 5 from 6 incorporations is inherently imprecise. This makes Ion Torrent less suitable for applications where indel accuracy is critical, but it works well for SNV detection in targeted panels.
Pacific Biosciences (PacBio) - Single Molecule Real-Time (SMRT) Sequencing
PacBio represents a different paradigm: single-molecule sequencing without amplification. A polymerase is fixed at the bottom of a tiny well (zero-mode waveguide), and fluorescently labeled nucleotides are watched in real-time as they’re incorporated.
Key characteristics: - Read length: Very long-10,000 to 100,000+ bp; HiFi mode produces highly accurate 10-20 kb reads - Error profile: Raw reads have high error rate (~10-15%), but errors are random. Circular consensus sequencing (CCS/HiFi) corrects errors by reading the same molecule multiple times, achieving >99.9% accuracy - Throughput: Lower than short-read platforms - Strengths: Resolves repetitive regions, detects structural variants, phases haplotypes, detects methylation directly - Limitations: Higher cost per base, lower throughput
PacBio’s long reads are invaluable for certain applications: assembling genomes de novo, resolving complex structural variants, spanning trinucleotide repeat expansions, and detecting methylation (which alters polymerase kinetics). The ability to read through repetitive regions that confound short-read technologies makes PacBio essential for characterizing certain mutations.
Oxford Nanopore
Nanopore sequencing threads DNA through a protein pore embedded in a membrane. As each nucleotide passes through, it causes a characteristic disruption in ionic current, which is decoded into sequence.
Key characteristics: - Read length: Extremely long-potentially hundreds of kilobases; limited only by DNA fragment length - Error profile: Higher error rate (~5-10% with current chemistry), predominantly indels; rapidly improving - Throughput: Variable depending on device - Strengths: Portability (MinION device is USB-sized), real-time sequencing, ultra-long reads, direct RNA sequencing, methylation detection - Limitations: Higher error rate limits some applications; basecalling is computationally intensive
Nanopore’s portability has enabled sequencing in the field-Ebola outbreak response, International Space Station, and point-of-care settings. The ability to sequence in real-time means results can be obtained within minutes of starting. Direct RNA sequencing (without reverse transcription) preserves RNA modifications that would otherwise be lost.
Choosing the Right Platform
The choice depends on the clinical question:
| Application | Preferred Platform | Rationale |
|---|---|---|
| Variant detection (SNVs, small indels) | Illumina | Highest accuracy |
| Targeted cancer panels | Illumina or Ion Torrent | Good accuracy, established workflows |
| Structural variant detection | PacBio or Nanopore | Long reads span breakpoints |
| Trinucleotide repeat sizing | PacBio | Reads through entire repeat |
| Methylation analysis | PacBio or Nanopore | Direct detection without bisulfite |
| Rapid pathogen identification | Nanopore | Real-time results, portability |
| Whole genome sequencing | Illumina (routine) or PacBio HiFi (comprehensive) | Cost vs. completeness tradeoff |
58.4 Bioinformatics: From Raw Data to Clinical Results
The raw data from sequencing instruments is meaningless without bioinformatics analysis. Understanding the data flow helps you appreciate where errors can occur and what the limitations of testing are.
File Formats: The Language of Sequencing Data
FASTQ: The starting point. FASTQ files contain the raw sequence reads and their quality scores.
Each read has four lines: 1. Sequence identifier (information about the instrument, run, and position) 2. The nucleotide sequence (A, C, G, T, or N for uncertain) 3. A separator line (just a “+”) 4. Quality scores (ASCII-encoded Phred scores)
Quality scores indicate confidence in each base call. A Phred score of 20 means 1% error probability (99% accuracy); 30 means 0.1% error (99.9% accuracy); 40 means 0.01% error (99.99% accuracy). Most clinical applications require Q30 or higher.
SAM/BAM: After reads are aligned to a reference genome, the results are stored in SAM (Sequence Alignment/Map) format. BAM is the compressed binary version.
SAM files contain: - Where each read aligned on the reference genome - The mapping quality (confidence in the alignment) - The CIGAR string (describes how the read aligns-matches, insertions, deletions, soft clips) - Information about paired-end reads
The CIGAR string is particularly important for understanding indels. “50M2I48M” means 50 matches, a 2-base insertion, then 48 more matches.
VCF (Variant Call Format): The final product for clinical interpretation. VCF files list variants found in the sample compared to the reference.
Each variant entry includes: - Chromosome and position - Reference allele and alternate allele(s) - Quality score - Filter status (PASS or reason for filtering) - Additional annotations (read depth, allele frequency, functional impact)
Understanding VCF is essential because this is what variant interpretation software uses. A variant might be filtered out due to low quality, low depth, or strand bias-information captured in the VCF.
BED (Browser Extensible Data): Defines genomic regions. Used to specify which regions were targeted by the assay (important for understanding what was and wasn’t tested).
The Analysis Pipeline
Alignment (Mapping): Reads are aligned to a reference genome to determine where they originated. This step requires sophisticated algorithms because: - Reads may contain errors - The patient’s genome differs from the reference - Repetitive regions can align to multiple locations
Reads that align to multiple locations equally well (multi-mapping reads) are often excluded from analysis, which can cause false-negative results in duplicated regions.
Variant Calling: Algorithms identify positions where the sample differs from the reference.
For germline variants, heterozygous variants should have approximately 50% alternate allele reads, homozygous variants approximately 100%. Significant deviation suggests artifact, mosaicism, or copy number variation.
For somatic variants, the expected allele frequency depends on tumor purity and copy number. A mutation present in 25% of reads might represent a heterozygous mutation in a tumor that’s 50% pure, or a subclonal mutation.
Annotation: Variants are annotated with information needed for interpretation: - Gene and transcript affected - Consequence (missense, nonsense, frameshift, splice site) - Population frequency (gnomAD) - Previous classifications (ClinVar) - In silico predictions (SIFT, PolyPhen, CADD) - COSMIC frequency for somatic variants
Quality Metrics to Understand
When reviewing molecular results, several quality metrics matter:
Depth of coverage: How many reads cover each position. Higher depth = more confidence. Clinical germline testing typically requires 20-30x; somatic testing often requires 500-1000x to detect low-frequency variants.
Uniformity of coverage: Are all targeted regions covered equally? Poor uniformity means some regions may have insufficient coverage for confident variant calling.
On-target rate: What percentage of reads mapped to the targeted regions? Low on-target rates waste sequencing capacity.
Duplicate rate: PCR duplicates (reads that are copies of the same original molecule) don’t provide independent information. Very high duplicate rates suggest starting DNA was limited.
Mapping rate: What percentage of reads could be aligned? Low mapping rates may indicate contamination or severe DNA degradation.
58.5 Hybridization Techniques
Hybridization exploits the complementary base pairing of nucleic acids. A labeled probe with a known sequence will bind (hybridize) to its complementary target sequence.
Southern Blot (DNA)
Detects specific DNA sequences and can assess gene rearrangements, large deletions, or copy number.
The process: 1. Genomic DNA is digested with restriction enzymes (cut at specific sequences) 2. Fragments are separated by gel electrophoresis (by size) 3. DNA is transferred (blotted) to a membrane 4. The membrane is incubated with a labeled probe 5. Probe binds to complementary sequences 6. Detection (autoradiography or chemiluminescence) reveals bands
Applications: Historically used for diagnosing fragile X syndrome (CGG repeat expansion) and detecting clonal immunoglobulin gene rearrangements in lymphomas. Largely replaced by PCR-based methods and FISH, but still used for specific applications.
Northern blot is the same technique applied to RNA (expression analysis). Largely replaced by RT-PCR and RNA-seq.
Fluorescence In Situ Hybridization (FISH)
FISH uses fluorescently labeled probes to visualize specific DNA sequences directly in cells or tissue sections.
The process: 1. Cells are fixed and permeabilized 2. DNA is denatured (separated into single strands) 3. Fluorescent probes are added and hybridize to their targets 4. Excess probe is washed away 5. Visualization by fluorescence microscopy
Probe types: - Centromere probes: Hybridize to repetitive sequences at the centromere; count chromosome number (aneuploidy) - Locus-specific probes: Hybridize to a specific gene region; detect deletions, amplifications, translocations - Whole chromosome paints: Label an entire chromosome; detect complex rearrangements
Applications: - Detecting HER2 amplification in breast cancer (guides therapy) - Identifying the BCR-ABL1 fusion in CML (Philadelphia chromosome) - Detecting ALK rearrangements in lung cancer - Prenatal diagnosis of trisomy 21
Advantages: Works on single cells, preserves tissue architecture, can analyze nondividing cells (interphase FISH).
Limitations: Can only detect what you probe for (not a discovery tool), limited number of probes per sample. 5. Detect
Applications: Large deletions/duplications, trinucleotide repeat expansions
Northern Blot
Same principle for RNA detection.
Fluorescence In Situ Hybridization (FISH)
Detects specific DNA sequences in intact cells or tissue sections.
Principle: - Fluorescent-labeled DNA probes hybridize to target sequences - Visualize under fluorescence microscope - Can detect chromosome number, translocations, deletions, amplifications
Probe types: - Centromere probes: Detect aneuploidy - Locus-specific probes: Detect gene deletions, amplifications, translocations - Whole chromosome paints: Identify chromosomal rearrangements
Applications: - Cancer cytogenetics (BCR-ABL, HER2 amplification) - Prenatal diagnosis (aneuploidy) - Microdeletion syndromes
Microarrays
Principle: Thousands of probes fixed on solid surface; labeled sample hybridizes to complementary probes
Types: - SNP arrays: Genotyping millions of variants; also detects copy number - CGH (Comparative Genomic Hybridization) arrays: Copy number analysis - Expression arrays: Gene expression profiling
58.6 Cytogenetics
Karyotyping
Visualization of metaphase chromosomes arranged by size and banding pattern.
Process: 1. Culture cells (need dividing cells) 2. Arrest in metaphase (colchicine) 3. Hypotonic treatment, fixation, spreading 4. Banding (G-banding most common) 5. Analysis and interpretation
Nomenclature (ISCN): - 46,XX = normal female - 47,XY,+21 = male with trisomy 21 - 46,XX,t(9;22)(q34;q11) = female with Philadelphia chromosome translocation
Resolution: ~5-10 Mb (cannot detect smaller abnormalities)
Applications: Constitutional cytogenetics, hematologic malignancies
Chapter 60: Clinical Applications of Molecular Diagnostics
Molecular diagnostics have transformed clinical medicine across multiple disciplines. Understanding when and how to use these tests-and their limitations-is essential for optimal patient care.
59.1 Infectious Disease Molecular Diagnostics
The Revolution in Microbiology
Traditional microbiology relies on culture-growing organisms to identify and characterize them. Culture remains the gold standard for many infections because it provides a living isolate for susceptibility testing. But culture has significant limitations:
- Time: Many organisms take days to grow; some (mycobacteria) take weeks
- Fastidious organisms: Some pathogens won’t grow on routine media or require special conditions
- Unculturable organisms: Some pathogens cannot be cultured at all (Treponema pallidum, Pneumocystis)
- Prior antibiotics: Treatment may sterilize cultures before collection
- Sensitivity: Low organism loads may not grow
Molecular methods address many of these limitations by detecting pathogen nucleic acids directly.
Syndromic Panels
Multiplex PCR panels can detect many pathogens simultaneously from a single specimen. This “syndromic” approach matches clinical presentation (respiratory illness, diarrhea, meningitis) rather than testing for one pathogen at a time.
Respiratory panels detect 15-20+ pathogens from a nasopharyngeal swab: - Influenza A/B, RSV, SARS-CoV-2, parainfluenza, rhinovirus, adenovirus, human metapneumovirus, coronaviruses - Bacteria: Bordetella pertussis, Mycoplasma pneumoniae, Chlamydophila pneumoniae
These panels provide rapid results (1-2 hours) that guide isolation precautions and treatment decisions. However, detecting a pathogen doesn’t always mean it’s causing current illness-many respiratory viruses can persist or be carried asymptomatically.
Gastrointestinal panels detect common causes of infectious diarrhea: - Bacteria: Salmonella, Shigella, Campylobacter, Shiga toxin-producing E. coli, C. difficile, Yersinia, Vibrio - Viruses: Norovirus, rotavirus, adenovirus - Parasites: Giardia, Cryptosporidium, Entamoeba histolytica
Important consideration: Positive results don’t always indicate the cause of current illness. C. difficile colonization is common; detection alone doesn’t prove disease. Interpretation requires clinical correlation.
Meningitis/encephalitis panels test CSF for multiple pathogens: - Bacteria: S. pneumoniae, N. meningitidis, H. influenzae, E. coli, L. monocytogenes, S. agalactiae - Viruses: HSV-1/2, VZV, enterovirus, CMV, HHV-6, parechovirus - Cryptococcus neoformans
This allows rapid identification in a medical emergency. However, empiric antibiotics should not be withheld pending results.
Antimicrobial Resistance Detection
Molecular tests can detect resistance genes, providing results faster than phenotypic susceptibility testing.
MRSA screening: Detection of mecA (or mecC) gene confirms methicillin resistance in staphylococci. Used for screening before surgery or for infection control.
Carbapenemase genes: Detecting KPC, NDM, VIM, IMP, OXA-48 identifies carbapenem-resistant organisms and guides antibiotic selection and infection control.
TB drug resistance: The Xpert MTB/RIF assay simultaneously detects M. tuberculosis and rifampin resistance (rpoB mutations) in about 2 hours-critical for rapid identification of MDR-TB in endemic areas.
HIV genotypic resistance testing: Sequencing of reverse transcriptase, protease, and integrase genes identifies mutations associated with drug resistance, guiding antiretroviral selection.
59.2 Oncology Molecular Diagnostics
Cancer is fundamentally a genetic disease-caused by mutations that drive uncontrolled proliferation. Understanding the molecular alterations in a patient’s tumor increasingly guides treatment selection. This paradigm of “precision oncology” matches targeted therapies to specific molecular targets.
The Concept of Companion Diagnostics
A companion diagnostic is a test that must be performed before administering a specific therapy. The test identifies patients whose tumors harbor the molecular alteration targeted by the drug. Patients without the alteration won’t benefit (and may be harmed by toxicity without benefit).
EGFR mutations in lung adenocarcinoma
The epidermal growth factor receptor (EGFR) is a tyrosine kinase that drives proliferation when activated. Certain mutations in EGFR (most commonly deletions in exon 19 and the L858R point mutation in exon 21) cause constitutive activation, driving tumor growth.
Tyrosine kinase inhibitors (TKIs) block this signaling: - First-generation: Erlotinib, gefitinib - Third-generation: Osimertinib (also effective against T790M resistance mutation)
Testing is standard of care for all non-squamous lung cancers. EGFR mutations are more common in never-smokers, women, and East Asian patients, but testing should not be limited by demographics.
ALK and ROS1 rearrangements in lung cancer
Chromosomal rearrangements can create oncogenic fusion genes. ALK rearrangements (most commonly EML4-ALK) occur in ~5% of lung adenocarcinomas. ROS1 rearrangements are less common (~1-2%).
Both create constitutively active kinases that can be targeted with specific inhibitors (crizotinib, alectinib, lorlatinib for ALK; crizotinib, entrectinib for ROS1).
Detection methods include FISH (visualizes the rearrangement), IHC (detects overexpressed fusion protein), and NGS (identifies the specific fusion partners).
KRAS mutations and EGFR inhibitor resistance
KRAS is downstream of EGFR in the signaling pathway. If KRAS is mutated and constitutively active, blocking EGFR upstream has no effect-the signal continues through KRAS.
In colorectal cancer, KRAS (and NRAS) mutations predict resistance to anti-EGFR antibodies (cetuximab, panitumumab). Testing for RAS mutations is required before using these drugs.
KRAS was long considered “undruggable,” but sotorasib and adagrasib now target the specific KRAS G12C mutation, common in lung cancer.
BRAF V600E mutations
BRAF is another kinase in the MAPK pathway. The V600E mutation (valine to glutamate at position 600) causes constitutive activation.
In melanoma, BRAF V600 mutations are present in ~50% of cases. BRAF inhibitors (vemurafenib, dabrafenib) combined with MEK inhibitors (trametinib, cobimetinib) produce dramatic responses.
In colorectal cancer, BRAF V600E indicates poor prognosis and different treatment approach (BRAF inhibition alone is ineffective; requires combination with EGFR inhibitor and MEK inhibitor).
BCR-ABL1 in chronic myeloid leukemia
The Philadelphia chromosome-t(9;22)-creates the BCR-ABL1 fusion gene, producing a constitutively active tyrosine kinase that drives CML.
Imatinib (Gleevec), the first successful targeted cancer therapy, inhibits BCR-ABL1. Quantitative PCR monitoring of BCR-ABL1 transcript levels guides treatment: - Major molecular response (MMR): BCR-ABL1 ≤0.1% (3-log reduction) - Deep molecular response: BCR-ABL1 ≤0.01%
Rising BCR-ABL1 levels suggest resistance; mutation analysis identifies the mechanism (point mutations in the ABL kinase domain) and guides selection of alternative TKIs.
Tumor Mutational Burden and Microsatellite Instability
These markers predict response to immune checkpoint inhibitors (anti-PD-1, anti-PD-L1, anti-CTLA-4)-drugs that unleash the immune system against tumors.
Tumor Mutational Burden (TMB): Tumors with many mutations produce many neoantigens-abnormal proteins that the immune system can recognize as foreign. High TMB correlates with response to immunotherapy because there are more targets for immune attack.
TMB is measured by NGS (counting somatic mutations per megabase of coding DNA). Cut-offs vary, but ≥10 mutations/Mb is often considered high TMB.
Microsatellite Instability (MSI): Microsatellites are short repetitive DNA sequences prone to errors during replication. Normally, the mismatch repair (MMR) system corrects these errors. When MMR is defective, errors accumulate, causing MSI.
MSI-high (MSI-H) tumors have thousands of mutations due to MMR deficiency, producing many neoantigens. Pembrolizumab (anti-PD-1) is FDA-approved for any MSI-H solid tumor, regardless of tissue of origin-the first tissue-agnostic cancer drug approval.
MSI testing also screens for Lynch syndrome (hereditary MMR deficiency), which increases risk of colorectal, endometrial, and other cancers.
Testing methods: - PCR-based: Compare microsatellite lengths in tumor vs. normal tissue - IHC: Stain for the four MMR proteins (MLH1, MSH2, MSH6, PMS2). Loss of staining indicates MMR deficiency. - NGS: Can detect MSI computationally from sequencing data
Mutational Signatures: The Fingerprints of Mutagenesis
Every mutagen leaves a characteristic pattern of mutations-a “signature” that reflects its mechanism of action. Analyzing these patterns provides insight into what caused a cancer’s mutations, which has both biological and clinical implications.
The concept: Different mutational processes cause different types of base changes in different sequence contexts. By cataloging these patterns across thousands of tumors, researchers have identified over 60 distinct mutational signatures (designated SBS1, SBS2, etc., for single base substitutions).
Clinically important signatures:
SBS1 (Age-related): C>T mutations at CpG dinucleotides. Results from spontaneous deamination of 5-methylcytosine, which occurs constantly. The number of SBS1 mutations correlates with age at diagnosis. Present in virtually all cancers-it’s the “clock” signature.
SBS4 (Tobacco smoking): Predominantly C>A transversions with a transcriptional strand bias. Caused by tobacco carcinogens like benzo[a]pyrene forming DNA adducts. Strongly associated with lung cancer in smokers. Finding SBS4 in a lung tumor provides molecular evidence of tobacco-related carcinogenesis.
SBS7a/b (Ultraviolet light): C>T mutations at dipyrimidine sequences (CC, CT, TC, TT). UV light causes cyclobutane pyrimidine dimers; if not repaired, these lead to C>T transitions. Dominant signature in melanoma and other skin cancers. Nearly pathognomonic for UV exposure.
SBS2 and SBS13 (APOBEC): C>T and C>G mutations at TpC dinucleotides (where the mutated C is preceded by T). APOBEC enzymes are cytidine deaminases normally involved in antiviral defense; when aberrantly expressed, they deaminate cytosines in single-stranded DNA. Common in breast, bladder, cervical, head/neck cancers. Associated with kataegis-localized hypermutation.
SBS10a/b (POLE proofreading deficiency): C>A and C>T mutations in specific trinucleotide contexts. Mutations in the POLE exonuclease domain disable proofreading during DNA replication. Results in extremely high mutation burden (>100 mutations/Mb). POLE-mutant tumors often respond well to immunotherapy due to high neoantigen load.
SBS6 and SBS15 (Mismatch repair deficiency): Small indels at microsatellites plus C>T at non-CpG sites. Reflects accumulation of replication errors when MMR is deficient. Correlates with MSI-high status.
SBS11 (Temozolomide): C>T mutations, particularly at CpC and CpT contexts. Temozolomide is an alkylating agent used for glioblastoma. Finding SBS11 in a recurrent tumor indicates temozolomide-induced mutagenesis-the treatment contributed to tumor evolution.
Clinical applications of mutational signatures:
Signature analysis can reveal: - Whether a tumor arose from a known environmental exposure (smoking, UV) - Whether MMR or POLE defects are present (immunotherapy implications) - Whether treatment itself contributed to tumor evolution - Potential hereditary predisposition (certain signatures suggest germline defects in DNA repair)
Clonal Hematopoiesis of Indeterminate Potential (CHIP)
CHIP represents a paradigm shift in how we understand the relationship between somatic mutations and disease. It refers to the presence of cancer-associated somatic mutations in blood cells of individuals without hematologic malignancy.
The discovery: When researchers began sequencing tumor DNA from blood samples, they noticed something unexpected-many patients had somatic mutations in genes like DNMT3A, TET2, and ASXL1 in their blood, even when their blood counts were normal and they had no evidence of leukemia or myelodysplasia. These mutations increased dramatically with age: rare before 40, but present in 10-20% of people over 70.
What CHIP represents: A single hematopoietic stem cell acquires a mutation that gives it a proliferative advantage. Over years, this clone expands and comes to represent a substantial fraction of blood cells. The mutations are real somatic mutations in cancer-associated genes, but they haven’t (yet) caused overt malignancy.
The most common CHIP mutations:
DNMT3A: The most frequently mutated gene in CHIP. DNMT3A encodes a DNA methyltransferase involved in epigenetic regulation. Mutations are typically loss-of-function. The R882 hotspot mutation is particularly common. DNMT3A mutations alone rarely progress to malignancy-they create a “pre-leukemic” state that may persist for decades.
TET2: Encodes an enzyme that oxidizes 5-methylcytosine, initiating DNA demethylation. TET2 and DNMT3A have opposing effects on methylation, yet mutations in both promote clonal expansion. TET2 mutations are associated with increased inflammation.
ASXL1: Involved in chromatin remodeling. ASXL1 mutations are more associated with myelodysplastic phenotypes and may carry higher risk of progression.
Other genes: TP53, JAK2, SF3B1, SRSF2, and others. TP53 mutations in CHIP may have higher malignant potential.
Clinical implications of CHIP:
Cancer risk: CHIP mutations increase the risk of developing hematologic malignancy by approximately 10-fold. However, the absolute risk remains low-about 0.5-1% per year. Most people with CHIP will never develop leukemia.
Cardiovascular risk: Surprisingly, CHIP is strongly associated with cardiovascular disease. TET2-mutant macrophages show increased inflammation; DNMT3A and JAK2 mutations also increase cardiovascular risk. This association is independent of traditional risk factors and may explain some “unexplained” cardiovascular events.
Confounding factor in liquid biopsy: This is critically important for cancer testing. When analyzing cell-free DNA from blood (liquid biopsy), mutations from CHIP can be detected and misinterpreted as tumor-derived. A VAF of 2% for a DNMT3A mutation in plasma might be from CHIP, not from a solid tumor. Paired analysis with white blood cell DNA can distinguish CHIP from true circulating tumor DNA.
Therapy-related considerations: Patients with pre-existing CHIP who receive cytotoxic chemotherapy have increased risk of therapy-related myeloid neoplasms. The chemotherapy may select for the resistant clone.
How to interpret CHIP in clinical reports: If NGS testing (especially from blood) reveals mutations in DNMT3A, TET2, ASXL1, or similar genes at variant allele frequencies suggesting clonal origin, consider: - This may represent CHIP, not cancer - The patient has increased (but still low absolute) risk of hematologic malignancy - Hematology referral may be appropriate for monitoring - For liquid biopsy interpretation, these mutations should be excluded as tumor-derived unless confirmed
FLT3 Mutations in Acute Myeloid Leukemia
FLT3 (fms-like tyrosine kinase 3) is a receptor tyrosine kinase expressed on hematopoietic progenitor cells. FLT3 mutations are among the most common genetic alterations in AML and have major prognostic and therapeutic implications.
FLT3-ITD (Internal Tandem Duplication)
The FLT3-ITD mutation is a duplication of a segment within the juxtamembrane domain (exons 14-15). The duplicated segment varies in size (from 3 to over 400 base pairs) but is always in-frame, preserving the reading frame.
Mechanism: The juxtamembrane domain normally acts as an autoinhibitory region, keeping the kinase inactive in the absence of ligand. The ITD disrupts this autoinhibition, causing constitutive kinase activation. The receptor signals continuously, driving proliferation.
Molecular characteristics: - Variable size (affects detection method choice) - Variable insertion site (all within juxtamembrane domain) - Head-to-tail orientation (the duplicated segment is inserted in the same direction as the original) - Often accompanied by loss of wild-type allele or additional ITD alleles
Detection methods: - PCR with capillary electrophoresis: Amplify across the region; ITDs appear as larger fragments. Sensitive to about 1-5% mutant allele. - NGS: Can detect ITDs but alignment is challenging for large insertions; specialized algorithms required - Fragment analysis: Traditional method; still widely used
Clinical significance: - Present in ~25% of AML - Associated with poor prognosis (higher relapse rate, shorter overall survival) - Allelic ratio matters: Higher mutant-to-wild-type ratio confers worse prognosis - Targetable with FLT3 inhibitors (midostaurin, gilteritinib)
FLT3-TKD (Tyrosine Kinase Domain Mutations)
Point mutations in the tyrosine kinase domain, most commonly D835 and I836, also activate FLT3 but by a different mechanism.
Mechanism: These mutations occur in the activation loop of the kinase domain, stabilizing the active conformation. Like ITD, they cause constitutive activation.
Clinical significance: - Present in ~7% of AML - Prognostic significance less clear than ITD (may be less adverse) - Also targetable with FLT3 inhibitors, though response may differ
Therapeutic implications: FLT3 inhibitors have changed AML management: - Midostaurin (first-generation): Added to chemotherapy for newly diagnosed FLT3-mutant AML - Gilteritinib (second-generation): More selective; used for relapsed/refractory FLT3-mutant AML - Resistance mutations can emerge, particularly in the TKD, requiring ongoing monitoring
Testing recommendations: All AML patients should be tested for FLT3 mutations at diagnosis (and at relapse). Results should be available within 24-48 hours if possible, given the impact on treatment decisions. Both ITD and TKD mutations should be assessed.
Liquid Biopsy
Traditional tumor testing requires tissue-obtained by biopsy or surgery. Liquid biopsy analyzes tumor-derived material circulating in blood.
Circulating tumor DNA (ctDNA): Tumor cells release DNA fragments into the bloodstream (through necrosis, apoptosis, or active secretion). This cell-free DNA can be captured and analyzed.
Applications: - Tumor genotyping when tissue is unavailable: Especially useful in lung cancer, where repeat biopsies are difficult - Monitoring treatment response: ctDNA levels reflect tumor burden; decrease indicates response - Detecting resistance mutations: Rising ctDNA or new mutations signal disease progression - Minimal residual disease (MRD): Detecting ctDNA after apparently complete treatment identifies patients at high relapse risk
Challenges: ctDNA is a tiny fraction of total cell-free DNA, especially with low tumor burden or after treatment. Highly sensitive methods (often requiring tumor-specific panels) are needed.
Circulating tumor cells (CTCs): Intact tumor cells circulating in blood. Rarer than ctDNA and technically challenging to capture, but provide living cells for additional characterization.
59.3 Inherited Disease Testing
Molecular diagnostics play multiple roles in inherited disease: confirming clinical diagnoses, identifying carriers, enabling prenatal diagnosis, and increasingly, predicting disease before symptoms appear.
Testing Strategies
Single-gene testing: When clinical findings point to a specific disorder, test that gene. Most cost-effective when the diagnosis is clear.
Gene panels: When multiple genes cause similar phenotypes (e.g., hereditary cardiomyopathy, inherited cancer syndromes), test all relevant genes simultaneously.
Exome/genome sequencing: When the clinical presentation is nonspecific or previous testing was negative, comprehensive sequencing may identify unexpected diagnoses.
Classic Single-Gene Disorders
Cystic Fibrosis (CFTR gene)
CF is caused by mutations in CFTR, which encodes a chloride channel. Over 2,000 mutations have been identified, but a relatively small number account for most cases.
Testing approaches: - Screening panels: ACMG recommends a panel of 23 common mutations, detecting ~90% of carriers in Northern European populations (less in other populations) - Expanded panels: Detect more mutations, increasing sensitivity - Full gene sequencing: Detects most mutations but may find variants of uncertain significance - Deletion/duplication analysis: For patients with one mutation and high clinical suspicion
The F508del mutation (deletion of phenylalanine at position 508) accounts for ~70% of CF alleles in Northern Europeans. Newer CFTR modulators (ivacaftor, lumacaftor, tezacaftor, elexacaftor) target specific mutation classes, making genotype increasingly important for treatment selection.
Sickle Cell Disease and Hemoglobinopathies
Sickle cell disease results from homozygosity for HbS (or compound heterozygosity with another β-globin variant like HbC or β-thalassemia).
Testing: - Newborn screening by hemoglobin electrophoresis or HPLC identifies affected infants - Molecular testing confirms the genotype and distinguishes HbSS from Sβ-thalassemia
Huntington Disease (HTT gene)
HD is caused by expansion of a CAG trinucleotide repeat in the HTT gene. Normal alleles have <27 repeats; disease alleles have ≥40 repeats. Intermediate ranges (27-35 and 36-39) have varying penetrance.
This is one of the clearest examples of predictive genetic testing-DNA testing can determine with near certainty whether a person will develop HD decades before symptoms appear. Extensive genetic counseling is essential before testing.
Trinucleotide Repeat Disorders
Multiple diseases are caused by unstable repeats that expand across generations: - HD, spinocerebellar ataxias: CAG repeats → polyglutamine tracts → toxic aggregation - Fragile X syndrome: CGG repeat in FMR1 5’UTR → gene silencing - Myotonic dystrophy: CTG (DM1) or CCTG (DM2) repeats → toxic RNA
Testing requires specialized methods (PCR with repeat-primed PCR, Southern blot) because standard PCR cannot reliably amplify large repeats.
Chromosomal Microarray (CMA)
CMA is now the first-tier test for: - Unexplained intellectual disability/developmental delay - Autism spectrum disorder - Multiple congenital anomalies
How it works: Patient DNA is compared to reference DNA, identifying regions where the patient has more or fewer copies than expected. Detects deletions and duplications (copy number variants, CNVs) across the entire genome.
Advantages over karyotype: - Much higher resolution (~50-100 kb vs. 5-10 Mb) - Detects microdeletion/microduplication syndromes that are invisible on karyotype - Diagnostic yield 15-20% in intellectual disability (vs. ~3% for karyotype)
Limitations: - Cannot detect balanced rearrangements (translocations, inversions)-no copy number change - Cannot reliably detect low-level mosaicism (<15-20%) - May detect variants of uncertain significance - Does not replace karyotype when balanced rearrangement is suspected (family history of multiple miscarriages)
59.4 Pharmacogenomics
Pharmacogenomics applies genetic testing to optimize drug therapy-selecting the right drug at the right dose for each patient based on their genetic makeup. While still emerging, several pharmacogenomic tests have clear clinical utility.
Drug Metabolism: CYP450 Enzymes
The cytochrome P450 enzymes metabolize most drugs. Genetic variants can cause increased or decreased enzyme activity, affecting drug levels and response.
CYP2D6: One of the most polymorphic drug-metabolizing enzymes
Metabolizer phenotypes: - Poor metabolizers (PM): No functional CYP2D6; drug accumulates (toxicity) or prodrug isn’t activated (lack of efficacy) - Intermediate metabolizers (IM): Reduced activity - Normal (extensive) metabolizers (EM): Normal activity - Ultrarapid metabolizers (UM): Multiple copies of active genes; drug cleared too quickly (lack of efficacy) or prodrug over-activated (toxicity)
Clinical examples: - Codeine: Prodrug activated by CYP2D6 to morphine. PMs get no pain relief. UMs may get fatal respiratory depression (deaths reported in children). - Tamoxifen: Prodrug activated to endoxifen. PMs have lower endoxifen levels and potentially reduced breast cancer treatment efficacy. - Antidepressants: Many metabolized by CYP2D6. PMs may need lower doses to avoid toxicity.
CYP2C19: Important for clopidogrel and some psychiatric drugs
Clopidogrel is a prodrug that requires CYP2C19 activation. PMs and IMs have reduced antiplatelet effect, increasing risk of cardiovascular events (especially with coronary stents). Guidelines recommend alternative antiplatelet agents in PMs undergoing percutaneous coronary intervention.
Thiopurine Methyltransferase (TPMT) and Thiopurines
TPMT inactivates thiopurines (azathioprine, 6-mercaptopurine, thioguanine). Patients with low TPMT activity accumulate active metabolites, causing severe, potentially fatal myelosuppression.
Testing before initiating thiopurines is standard of care: - Normal activity: Standard doses - Intermediate activity: Reduce dose by ~50% - Low/absent activity: Use alternative drug or drastically reduced dose
NUDT15 is another enzyme affecting thiopurine toxicity, particularly important in Asian populations.
Dihydropyrimidine Dehydrogenase (DPD) and Fluoropyrimidines
DPD (encoded by DPYD) is the rate-limiting enzyme for degradation of 5-fluorouracil and capecitabine. DPD deficiency causes severe, sometimes fatal toxicity (mucositis, diarrhea, myelosuppression, hand-foot syndrome).
Partial DPD deficiency affects ~3-5% of the population. Complete deficiency is rare but nearly uniformly fatal with standard doses. Pre-treatment testing is increasingly recommended, particularly in Europe.
HLA-Associated Drug Hypersensitivity
Certain HLA alleles are strongly associated with severe drug reactions, likely because the drug or its metabolites bind to specific HLA molecules and trigger T-cell responses.
**HLA-B*57:01 and abacavir hypersensitivity**: Abacavir (an HIV medication) causes a hypersensitivity reaction in ~5-8% of patients, which can be fatal on re-challenge. HLA-B57:01 is present in virtually all cases. Testing before initiation is standard of care; abacavir should not be prescribed to HLA-B57:01-positive patients.
**HLA-B*15:02 and carbamazepine/phenytoin SJS/TEN**: In certain Asian populations (Han Chinese, Thai, Malaysian), HLA-B*15:02 strongly predicts Stevens-Johnson syndrome and toxic epidermal necrolysis from carbamazepine. Testing is recommended in at-risk populations before initiating these medications.
**HLA-A*31:01 and carbamazepine**: Associated with carbamazepine hypersensitivity in European and Japanese populations.
Warfarin Pharmacogenomics
Warfarin dosing is affected by variants in two genes:
CYP2C9: Metabolizes the more potent S-warfarin enantiomer. Variant alleles (2, 3) reduce metabolism, requiring lower doses.
VKORC1: The target of warfarin. Variants affect sensitivity; some alleles require lower doses to achieve the same anticoagulant effect.
Pharmacogenomic dosing algorithms incorporate these variants along with clinical factors (age, weight, interacting medications). Clinical trials have shown modest benefit in reducing time to stable dosing, though widespread implementation remains debated given the availability of direct oral anticoagulants that don’t require monitoring.
59.5 Identity Testing
STR (Short Tandem Repeat) analysis: Standard for identity testing
Applications: - Parentage testing - Forensic identification - Bone marrow engraftment monitoring
Principle: STRs are highly polymorphic repeating units; combination of multiple STR loci creates unique “DNA fingerprint”
59.6 HLA Typing
HLA molecules present antigens to T cells; matching is crucial for transplantation.
Class I: HLA-A, B, C (on all nucleated cells) Class II: HLA-DR, DQ, DP (on antigen-presenting cells)
Testing methods: - Serology: Historical; low resolution - Molecular: PCR-based; various resolution levels - Low resolution: Broad allele groups - High resolution: Specific alleles (needed for stem cell transplant)
Applications: - Solid organ transplant matching - Stem cell donor selection - Disease associations (HLA-B27 and spondyloarthropathies)
Chapter 61: Variant Interpretation and Reporting
Variant interpretation is where the science of sequencing meets clinical medicine. A sequence change means nothing until it is interpreted in the context of human disease. This chapter covers the systematic frameworks used to classify variants-different systems for germline (inherited) and somatic (tumor) variants-and the tools that inform these classifications.
60.1 Germline Variant Classification: The ACMG/AMP Framework
The American College of Medical Genetics and Genomics (ACMG) and the Association for Molecular Pathology (AMP) published joint guidelines in 2015 that standardized germline variant classification. This framework provides a systematic, evidence-based approach to determining whether a variant causes disease.
The Five-Tier Classification System
Variants are classified into five categories based on the weight of evidence:
Pathogenic: The variant causes disease. There is strong evidence supporting a causal role. Clinical action is warranted based on this finding.
Likely Pathogenic: The evidence strongly favors pathogenicity (>90% certainty that the variant causes disease). For clinical purposes, likely pathogenic variants are generally treated the same as pathogenic variants-they guide clinical management.
Variant of Uncertain Significance (VUS): There is insufficient evidence to classify the variant as pathogenic or benign. This is the most challenging category clinically. VUS results should not be used for clinical decision-making, but patients should be informed because classification may change as evidence accumulates.
Likely Benign: The evidence strongly favors a benign interpretation (>90% certainty the variant does not cause disease). Generally not reported on clinical reports.
Benign: The variant does not cause disease. Common polymorphisms fall into this category. Not reported on clinical reports.
The Evidence Framework: Criteria for Classification
The ACMG/AMP guidelines define specific criteria, each weighted by strength of evidence. Criteria supporting pathogenicity are labeled P (pathogenic); those supporting benign interpretation are labeled B.
Pathogenic Criteria (Evidence FOR disease causation):
PVS1 (Pathogenic Very Strong): Null variant in a gene where loss of function (LOF) is a known mechanism of disease.
This is the strongest single piece of evidence for pathogenicity. Null variants include: - Nonsense mutations (create premature stop codon) - Frameshift mutations (shift reading frame, usually causing premature stop) - Canonical splice site mutations (±1 or ±2 positions) - Initiation codon mutations - Single or multi-exon deletions
Critical caveats: PVS1 applies only when: - LOF is an established disease mechanism for that gene (not all genes cause disease through LOF) - The variant is not in the last exon or last 50 bp of the penultimate exon (where truncation may not trigger nonsense-mediated decay) - There are no alternative transcripts that would rescue the mutation
PS1 (Pathogenic Strong): Same amino acid change as a previously established pathogenic variant.
If p.Arg248Trp is established pathogenic, and you find p.Arg248Trp in a new patient, that’s strong evidence. However, if you find a different nucleotide change causing the same amino acid change (e.g., different codon for the same substitution), be cautious about splice effects.
PS2 (Pathogenic Strong): De novo (confirmed) in a patient with disease and no family history.
A new mutation arising in the patient, not inherited from either parent, is strong evidence when the phenotype matches. Requires confirmation of parentage (both parents tested and confirmed as biological parents).
PS3 (Pathogenic Strong): Well-established functional studies show a deleterious effect.
Functional evidence from validated assays showing the variant disrupts protein function. The strength depends on how well the assay models the disease mechanism. Not all published “functional studies” qualify-the assay must be validated and appropriate.
PS4 (Pathogenic Strong): Prevalence in affected individuals is significantly increased compared to controls.
Statistical association with disease in case-control studies. Typically requires odds ratio >5 with confidence interval not including 1.
PM1 (Pathogenic Moderate): Located in a mutational hotspot or well-established functional domain without benign variation.
Variants in critical protein domains (e.g., active site, DNA-binding domain) are more likely to be damaging. This requires that the domain is truly critical and that benign variants don’t occur there.
PM2 (Pathogenic Moderate): Absent from controls (or extremely low frequency if recessive) in population databases.
A rare variant is more likely to be pathogenic than a common one. “Absent” typically means not present in gnomAD or present at frequency well below disease prevalence. Note: ClinGen has recommended downgrading PM2 to supporting level because many rare variants are benign.
PM3 (Pathogenic Moderate): For recessive disorders, detected in trans with a pathogenic variant.
If a patient has a known pathogenic variant on one chromosome and a candidate variant on the other, and they have the recessive disease, that’s evidence the candidate variant is pathogenic. Requires confirmation of phase (trans, not cis).
PM4 (Pathogenic Moderate): Protein length changes due to in-frame deletions/insertions or stop-loss variants.
In-frame changes that alter protein length in a non-repeat region suggest functional impact. Less definitive than frameshift (which is PVS1).
PM5 (Pathogenic Moderate): Novel missense at a residue where a different pathogenic missense has been seen.
If p.Arg248Trp is pathogenic, and you find p.Arg248Gln (different amino acid change at the same position), that’s moderate evidence. The position is clearly important.
PM6 (Pathogenic Moderate): Assumed de novo without confirmation of paternity/maternity.
Like PS2 but without formal parentage confirmation. Weaker evidence.
PP1 (Pathogenic Supporting): Co-segregation with disease in multiple affected family members.
The variant tracks with disease in a family. Strength can be upgraded based on the number of meioses (more informative segregations = stronger evidence).
PP2 (Pathogenic Supporting): Missense in a gene with low rate of benign missense variation where missense is a common mechanism of disease.
Some genes are highly intolerant of missense variation (e.g., genes with Z-score >3 for missense constraint in gnomAD).
PP3 (Pathogenic Supporting): Multiple computational (in silico) predictions support a deleterious effect.
Algorithms predict the variant is damaging. See section on in silico tools below. This is supporting evidence only-computational predictions alone cannot classify a variant.
PP4 (Pathogenic Supporting): Patient’s phenotype or family history is highly specific for a disease with a single genetic etiology.
A classic presentation of a rare monogenic disease increases the prior probability that any variant found in the causative gene is pathogenic.
PP5 (Pathogenic Supporting): Reputable source reports variant as pathogenic.
ClinVar submissions, literature reports. ClinGen has recommended removing PP5/BP6 from active use because they risk circular reasoning.
Benign Criteria (Evidence AGAINST disease causation):
BA1 (Benign Stand-Alone): Allele frequency >5% in any general population database.
A common variant is almost certainly benign for rare Mendelian disease. This single criterion is sufficient to classify as benign.
BS1 (Benign Strong): Allele frequency greater than expected for the disorder.
Frequency is higher than compatible with disease prevalence and penetrance. For a dominant disease with prevalence 1/10,000 and full penetrance, a variant frequency of 1% would be incompatible with causation.
BS2 (Benign Strong): Observed in a healthy adult individual for a fully penetrant dominant condition or in the homozygous state for a recessive condition.
If the variant is found in healthy individuals who should have disease (based on the inheritance pattern and penetrance), it’s likely benign.
BS3 (Benign Strong): Well-established functional studies show no deleterious effect.
The inverse of PS3. Validated functional assays show normal protein function.
BS4 (Benign Strong): Lack of segregation in affected family members.
The variant doesn’t track with disease in a family (affected individuals don’t have it, or unaffected individuals do).
BP1 (Benign Supporting): Missense variant in a gene where only truncating variants cause disease.
Some genes only cause disease through LOF (truncating variants). Missense variants in these genes are less likely to be pathogenic.
BP2 (Benign Supporting): Observed in trans with a pathogenic variant for a dominant disorder, or in cis with a pathogenic variant.
For dominant conditions: if a patient has a known pathogenic variant causing their disease, a second variant in the same gene (in trans) is less likely to also be pathogenic-one pathogenic variant is sufficient.
BP3 (Benign Supporting): In-frame insertion/deletion in a repetitive region without known function.
Changes in non-functional repetitive sequences are less likely to be damaging.
BP4 (Benign Supporting): Multiple computational predictions suggest no impact.
The inverse of PP3. In silico tools predict the variant is benign/tolerated.
BP5 (Benign Supporting): Found in a case with an alternate molecular basis for disease.
If the patient’s disease is explained by a different variant, an additional VUS is less likely to be pathogenic.
BP6 (Benign Supporting): Reputable source reports variant as benign.
BP7 (Benign Supporting): Synonymous variant with no predicted splice impact and not highly conserved.
Combining Criteria: Rules for Classification
The ACMG/AMP guidelines provide rules for combining evidence:
Pathogenic: - 1 Very Strong (PVS1) AND ≥1 Strong (PS1-PS4), OR - 1 Very Strong AND ≥2 Moderate (PM1-PM6), OR - 1 Very Strong AND 1 Moderate AND 1 Supporting (PP1-PP5), OR - 1 Very Strong AND ≥2 Supporting, OR - 2 Strong, OR - 1 Strong AND ≥3 Moderate, OR - 1 Strong AND 2 Moderate AND ≥2 Supporting, OR - 1 Strong AND 1 Moderate AND ≥4 Supporting
Likely Pathogenic: - 1 Very Strong AND 1 Moderate, OR - 1 Strong AND 1-2 Moderate, OR - 1 Strong AND ≥2 Supporting, OR - ≥3 Moderate, OR - 2 Moderate AND ≥2 Supporting, OR - 1 Moderate AND ≥4 Supporting
Benign: - 1 Stand-Alone (BA1), OR - ≥2 Strong (BS1-BS4)
Likely Benign: - 1 Strong AND 1 Supporting, OR - ≥2 Supporting
VUS: Does not meet criteria for pathogenic/likely pathogenic or benign/likely benign
60.2 Somatic Variant Classification: The AMP/ASCO/CAP Tier System
Somatic (tumor) variants require a different classification framework than germline variants. The question isn’t “does this cause an inherited disease?” but rather “what is the clinical significance of this mutation in this cancer?”
The Association for Molecular Pathology (AMP), American Society of Clinical Oncology (ASCO), and College of American Pathologists (CAP) published guidelines in 2017 establishing a four-tier system for classifying somatic variants based on their clinical actionability.
The Four Tiers
Tier I: Variants of Strong Clinical Significance
These variants have established clinical utility-they inform diagnosis, prognosis, or treatment selection based on strong evidence.
Level A Evidence: Variant predicts response or resistance to FDA-approved therapies, or is included in professional guidelines for this tumor type.
Examples: - EGFR L858R or exon 19 deletions in lung adenocarcinoma (predicts response to EGFR TKIs) - BRAF V600E in melanoma (predicts response to BRAF/MEK inhibitors) - BCR-ABL1 in CML (diagnostic and predicts response to TKIs) - KRAS mutations in colorectal cancer (predicts resistance to anti-EGFR antibodies)
Level B Evidence: Variant predicts response to therapy based on well-powered studies with expert consensus, but not yet FDA-approved for this indication.
Examples: - BRAF V600E in colorectal cancer (off-label use of BRAF inhibitors in combination) - NTRK fusions in tumors other than the FDA-approved indications
Tier II: Variants of Potential Clinical Significance
These variants may be clinically significant but have less definitive evidence.
Level C Evidence: FDA-approved therapy for a different tumor type, or investigational therapies with clinical trials available.
Example: A rare kinase fusion identified in a tumor type where it hasn’t been specifically studied, but TKI therapy is available in clinical trials.
Level D Evidence: Preclinical data (in vitro or animal models) or limited case reports suggesting potential significance.
Example: A novel EGFR mutation with in vitro sensitivity data but no clinical experience.
Tier III: Variants of Unknown Significance
The somatic equivalent of VUS. The variant is detected but there is insufficient evidence to determine clinical relevance.
Characteristics: - Not observed at significant frequency in tumor databases (COSMIC) - No published evidence of association with cancer behavior or therapy response - May be a passenger mutation (present in the tumor but not driving its behavior)
Most detected variants fall into this category. They are reported but should not drive clinical decisions.
Tier IV: Benign or Likely Benign Variants
Variants with evidence suggesting they are not oncogenic-likely germline polymorphisms or passenger mutations with no functional consequence.
Characteristics: - Observed at significant allele frequency in general population (gnomAD) - No evidence of association with cancer - Common polymorphisms
These are typically not reported, or reported only to document that testing was performed at that position.
Key Differences from Germline Classification
Context matters: The same variant can have different significance in different tumor types. BRAF V600E is Tier I in melanoma but has different implications in colorectal cancer.
Actionability is central: The somatic tier system focuses on clinical utility-does this variant change what we do for the patient?
Passenger vs. driver: Many somatic mutations are passengers (bystanders that don’t contribute to cancer behavior). The challenge is distinguishing them from drivers.
Allele frequency interpretation differs: In germline testing, we expect 50% (heterozygous) or 100% (homozygous). In tumors, variant allele frequency reflects tumor purity, copy number, and clonal architecture. A 5% VAF might represent a subclonal mutation or a mutation in a low-purity sample.
60.3 In Silico Prediction Tools
Computational (in silico) tools predict the functional impact of variants based on sequence conservation, protein structure, and other features. These predictions provide supporting evidence but are never sufficient alone to classify a variant.
Missense Prediction Tools
SIFT (Sorting Intolerant From Tolerant): Predicts whether an amino acid substitution affects protein function based on sequence homology.
- Score range: 0-1
- Score <0.05: Predicted deleterious (“damaging”)
- Score ≥0.05: Predicted tolerated
- Principle: If an amino acid position is conserved across evolution, substitutions are likely damaging
PolyPhen-2 (Polymorphism Phenotyping v2): Predicts impact using sequence and structure-based features.
- Score range: 0-1
0.85: Probably damaging
- 0.15-0.85: Possibly damaging
- <0.15: Benign
- Principle: Combines conservation with structural features (if known) like proximity to active sites
CADD (Combined Annotation Dependent Depletion): Integrates multiple annotations into a single deleteriousness score.
- Score: Phred-scaled (higher = more deleterious)
- Score ≥20: Top 1% most deleterious (often used as threshold)
- Score ≥30: Top 0.1%
- Principle: Machine learning model trained to distinguish known pathogenic variants from simulated de novo variants
REVEL (Rare Exome Variant Ensemble Learner): Ensemble method combining 13 individual tools, optimized for rare variants.
- Score range: 0-1
- ClinGen-recommended thresholds for use with ACMG criteria:
- Score >0.644: Supporting pathogenic (PP3)
- Score >0.773: Moderate pathogenic
- Score >0.932: Strong pathogenic
- Score <0.290: Supporting benign (BP4)
- Score <0.183: Moderate benign
- Score <0.016: Strong benign
- Principle: Ensemble methods reduce the weaknesses of individual tools
MutationTaster: Predicts disease-causing potential using multiple features including conservation, splice site changes, and protein features.
Splicing Prediction Tools
SpliceAI: Deep learning model that predicts splice alterations from sequence alone.
- Outputs probability scores (0-1) for:
- Donor gain: Creation of new donor site
- Donor loss: Disruption of existing donor site
- Acceptor gain: Creation of new acceptor site
- Acceptor loss: Disruption of existing acceptor site
- Score >0.5: High probability of splice effect
- Score >0.8: Very high confidence
- Principle: Neural network trained on RNA-seq data to recognize splice consequences
MaxEntScan: Calculates the strength of splice sites using maximum entropy modeling.
- Compares wild-type and mutant splice site scores
- Score decrease suggests weakening of splice site
- Principle: Models the consensus sequences at splice junctions
Conservation Scores
PhyloP: Measures conservation at individual nucleotides based on evolutionary rate.
- Positive scores: Conservation (slower evolution than expected)
- Negative scores: Acceleration (faster evolution than expected)
- Score >2: Strong conservation
- Principle: Conserved positions are under purifying selection because they’re functionally important
PhastCons: Predicts probability that a nucleotide belongs to a conserved element.
- Score range: 0-1
- Score >0.9: High probability of conservation
- Principle: Uses hidden Markov model to identify conserved regions
GERP (Genomic Evolutionary Rate Profiling): Measures “rejected substitutions”-the difference between expected and observed mutations.
- Higher scores = more conservation
- Score >2: Often used as threshold for conservation
Best Practices for Using In Silico Tools
Use multiple tools: No single tool is reliable enough alone. Concordance among multiple tools increases confidence.
Understand the limitations: - Tools are trained on known variants, so novel variant types may not be well-predicted - Performance varies by gene and variant type - Missense tools don’t assess splice effects; splice tools don’t assess protein function
Context matters: A variant predicted “benign” by tools but occurring at a known critical residue should be viewed with suspicion. A variant predicted “damaging” but common in the population is likely benign regardless of prediction.
Supporting evidence only: In silico predictions are supporting (PP3/BP4) level evidence in ACMG/AMP framework-they cannot drive classification alone.
60.4 Key Databases for Variant Interpretation
gnomAD (Genome Aggregation Database): The primary resource for population allele frequencies.
- Contains >140,000 exomes and >76,000 genomes
- Provides allele frequencies by population (African, European, East Asian, South Asian, Latino, etc.)
- Critical for applying BA1, BS1, PM2 criteria
- Also provides constraint metrics (pLI, Z-scores) indicating how intolerant a gene is to various mutation types
ClinVar: NIH database of variants and their clinical significance.
- Aggregates interpretations from clinical laboratories
- Shows submitter, assertion criteria, and review status
- Gold star system indicates level of review:
- 1 star: Single submitter
- 2 stars: Multiple submitters with no conflicts
- 3 stars: Expert panel review
- 4 stars: Practice guideline
- Critical for determining prior classifications
COSMIC (Catalogue of Somatic Mutations in Cancer): Database of somatic mutations.
- Records mutations found in tumors with tumor type annotation
- Useful for distinguishing oncogenic drivers from passengers
- Provides frequency data for somatic variants
OMIM (Online Mendelian Inheritance in Man): Database of genes and genetic disorders.
- Describes gene-disease relationships
- Specifies inheritance patterns
- Links to literature
- Essential for understanding what phenotypes are associated with variants in a gene
ClinGen: Clinical Genome Resource.
- Provides expert-curated gene-disease validity assessments
- Publishes variant-specific classifications from Expert Panels
- Develops and refines variant interpretation guidelines
- Dosage sensitivity maps
60.5 Molecular Pathology Report Interpretation
A molecular pathology report should contain all information needed for clinical decision-making while being interpretable by non-geneticist clinicians.
Essential elements:
Patient and specimen information: Demographics, specimen type, collection date, tumor percentage (for oncology).
Test methodology: What technology was used (NGS, Sanger, FISH)? What genes/regions were tested? What is the reportable range? What is the analytical sensitivity (limit of detection)?
Results: Variants detected with complete HGVS nomenclature at both DNA and protein levels. Classification (pathogenic, VUS, etc.). Variant allele frequency for somatic testing.
Interpretation: What do the results mean for this patient? This should translate molecular findings into clinical implications-does this affect diagnosis, prognosis, treatment selection, or testing of family members?
Limitations: What could the test miss? Regions with low coverage, types of variants not detected by the methodology (e.g., large deletions may be missed by NGS), variants of uncertain significance.
Recommendations: Should family members be tested? Is genetic counseling indicated? Are there clinical trial options (for oncology)?
Understanding limitations is crucial: A negative result doesn’t mean no mutations exist-it means none were detected within the test’s technical limitations and in the regions examined. A VUS doesn’t mean the patient doesn’t have a pathogenic variant-it means we can’t yet determine whether this particular variant is disease-causing.